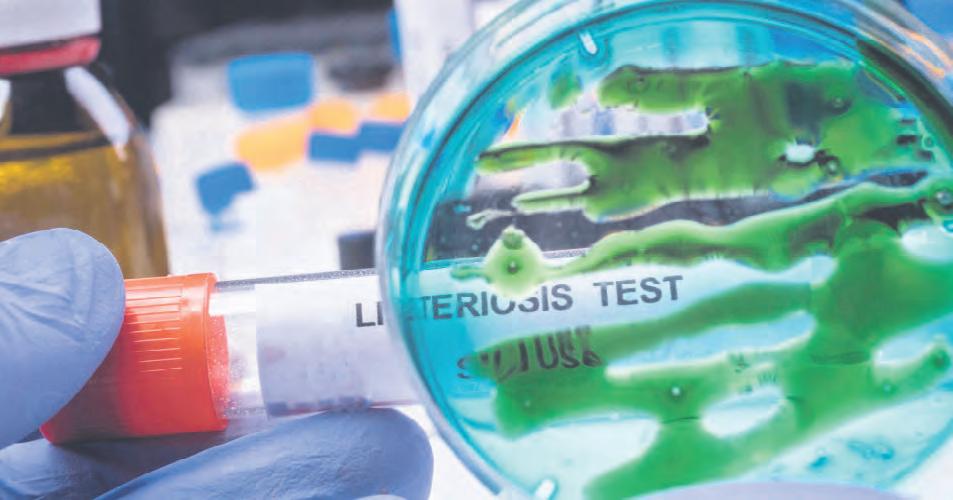

Zagreb










Danas započinje



REZULTATI MEĐIMURSKOG GOSPODARSTVA pokazuju da smo počeli zaostajati za drugima. Optimistični su još samo političari koji to moraju biti.


























































Lidija Miše Jalšovec je bez rukovodećeg iskustva?



![]()








Zagreb













REZULTATI MEĐIMURSKOG GOSPODARSTVA pokazuju da smo počeli zaostajati za drugima. Optimistični su još samo političari koji to moraju biti.


























































Lidija Miše Jalšovec je bez rukovodećeg iskustva?



Od 1. listopada cijene električne energije i plina porasle su za 10 do 15 posto, što dodatno opterećuje kućne budžete u vrijeme kada in�lacija već uvelike utječe na standard građana. Postavlja se pitanje hoće li porast cijene energenata utjecati na svakodnevicu ljudi i hoće li biti primorani








na dodatne mjere štednje. Neki su građani ravnodušni, dok su drugi već počeli prilagođavati svoje potrošačke navike kako bi izdržali rastuće životne troškove. U nastavku saznajte kako Međimurci doživljavaju ovo poskupljenje u našoj anketi Pod vurom.
( Sania Bižupić)
Slavko Novak (Lopa�nec) - Ja plina nemam. Grijem se samo na drva jer mi je ispla�vije. Imam svoje šume i onda mi se to više ispla�, a jedno vrijeme dok je plin išao, bili smo u nekim problemima s poslom i firmom, pa se nismo priključili. Drva imam puno, pa nas povećanje ne zabrinjava, no nije pošteno prema ljudima diza� cijene sada u zimu.
Zrinko Kutnjak (Dragoslavec) - Pro�v povećanja sam, naravno. Grijem se na struju i jedva čekam nove troškove. U odnosu na plin, grijanje strujom je ispla�vije. Moji doma se griju na drva, tako da je to možda ispla�vije, ali ja nemam tu priliku.
Marijana Vidović (Mihovljan) - Ja pojma nemam o povećanju cijena. Moj muž to plaća i ja nemam pojma. Grijemo se na plin, a u ostalo uopće nisam upućena. Ne znam koliko plaćamo struju, vodu ili plin. Mene da netko pita koliko mi plaćamo račune, ne bih znala.
Danijela Cvitković (Čakovec) - Baš se i ne slažem s povećanjem cijena struje i plina jer su plaće ostale iste. Ništa se ne pomiču gore, sve je ostalo isto, a rastu i cijene. Grijemo se na plin i šparamo, pali-gasi. Ne možeš si priuš�� da bi na jednu temperaturu stavio kao nekada.
Josip Vrbanec (Čakovec) - Nije dobro. Onda će svaki čas diza� cijene jer ako sada poskupe, onda neće to bi� samo jedanput, nego više puta. Grijem se na plin i to je najbolja opcija. Ne strahujem previše povećanju cijena.

Njegovo veličanstvo, kralj gljiva, odnosno vrganj, bio je zvijezda Izložbe gljiva u Čakovcu.









Svojom veličinom, a još više opojnim mirisom, nekako se izdvajao od ostalih gljiva. A bilo ih je doista mnogo, od pečurki, sunčanica, bukovača, vrbovača do svima znane zelene pupovke. Gljivari su se doslovno razletjeli na sve strane kako bi Međimurcima prikazali i upoznali ih sa što više predstavnika popularnog šumskog mesa. (vv) NEBITNO JE TKO ĆE BITI NOVI RAVNATELJ, odluke





Piše: Tomislav Novak Napeto jutro u petak. Dva kandidata, Igor Šegović i Nikola Hren, u „slijepoj“ su utrci za mjesto ravnatelja bolnice, a Upravno će vijeće nakon njihovih prezentacija odlučiti koga će izabrati. Najprije će vjerojatno saslušati dosadašnjeg ravnatelja Igora Šegovića o njegovim projektima i viziji vođenja bolnice, a nakon toga će pred tim novim, sada HDZ-ovim Vijećem, nastupiti i njihove stranke sin, Nikola Hren. On sam je bio član Upravnog vijeća sve do srpnja, a kako je pravnik po struci, sve što zna o bolnici mogao je naučiti samo od Šegovića i njegovih oponenata. Ali HDZ druge kadrove niti nema, jer liječnici njihove provenijencije ne žele preuzeti odgovornost ili pak ne žele ostati bez honorarnih angažmana u privatnim klinikama, koje ti zakon priječi kad si ravnatelj. Šegović pak je svojim potezima postao izuzetno popularan ravnatelj. Omiljen Međimurcima jer je otvorio bolnicu građanima te javno komunicirao i ispravljao nedostatke. U prvi mah je to bilo odbojno mnogim bolničkim liječnicima, no ustvari su svi postali zaista popularni. No znate kako se kaže: - Niti jedno dobro djelo ne ostaje nekažnjeno.
Jezične akrobacije kako bolnica ostaje u Čakovcu te je neće nikamo odnijeti, predsjednik Vlade može pokušati ponuditi npr. Ukrajincima. Naime, niti Krim nisu Rusi nikamo odnijeli. Samo su preuzeli upravljanje nad njim. Krim je upravo tamo gdje je i bio, za Andreja Plenkovića to izgleda nije problem
Ali bez obzira tko će od njih postati novi ravnatelj (nekad naše) bolnice, to neće nikako više utjecati na njezin rad, jer je upravljanje bolnicom preuzelo ministarstvo tj. Vlada. Tako će sada u Zagrebu odlučivati od čega će se liječiti Međimurci u Čakovcu, a za što će putovati u druge bolnice.
Ionako se po Zagrebu stalno govori, pa što će vam bolnica, imate je u Varaždinu koji je samo 15 km udaljen. Pri tome im nitko od naših pozvanijih političara nije odbrusio kako je Kotoriba udaljena preko 40 kilometara od Čakovca i da smo najgušće naseljena županija nakon Zagreba. Nitko se ne sjeti niti odvaliti im kako je od bolnice Sveti Duh do bolnice Sestara milosrdnica u Zagrebu udaljenost niti četiri kilometra, a do KB-a Dubrava tek 11 kilometara. Kako će to završiti, stariji ljudi sjećaju se iz bivše države. Prije nego li nam je Franjo Tuđman dao županiju i decentraliziranu vlast, sve su važnije usluge završavale u Varaždinu. To
će se dogoditi. Samo pričekajte. Iako je župan Matija Posavec Ustavnom sudu podnio zahtjev za provjeru ustavnosti takve odluke, ustavni sud se još nije očitovao. Za razliku od recimo svojih hitnih odluka kojima se direktno miješao u izborni proces i utjecao na njega. Naime, vlasnik bolnice je Međimurska županija, a gradili su je Međimurci svojim samodoprinosima, za razliku od većine drugih bolnica koje je drugima gradila država, bilo ova ili prijašnja. No Posavec je zbog svoje situacije s USKOK-om izgubio svoju sjajnu zaštitnu caklinu pa se morao pritajiti, a niti jedan drugi utjecajniji političar ne usudi se javno uzeti u zaštitu vlasništvo naše bolnice.
Ipak, treba mu priznati da je hrabro, ali naivno, na to pokušao ukazati saborski zastupnik Ivica Baksa pitanjem predsjedniku Vlade Andreju Plenkoviću. No bez dovoljno uvježbanih komunikacijskih skilova nije znao zabiti na prazan gol loptom
koju mu je ovaj bacio na volej. Plenković je po običaju izbjegao odgovoriti na postavljeno pitanje, ali je opet podvalio dosjetku: „Pa nećemo vam bolnicu nikamo odnijeti, bolnica će ostati u Čakovcu.” Ideš!? To je fora iz vrtića? Osnovne? Bilo je Međimurje već pod kojekakvom vlašću. Naši stari se ne sjećaju ni da bi nam Mađari bili odnijeli bolnicu. Niti „Jugosloveni“. No velika je razlika uvijek bila upravo u tome tko upravlja njome i tko odlučuje koji će se odjeli razvijati te kako i koga će kadrovirati. Ako npr. netko na silu počne upravljati kućom koja je vaša, koju ste vi izgradili i koju vi �inancirate te odlučivati o svemu što se u njoj događa, kako se to zove? Puno gore nego okupacija. Ali nazvao sam okupacija jer stilski više odgovara. Nije baš vojna, jer za vojnu okupaciju znamo što je. Barem oni koji su odslužili neku vojsku. Ali postoji i okupacija u građanskom pravu, a to je kad preuzmete vlasništvo nad nečim što je napušteno ili ničije. Dobro je sjećati se koji su se političari ponašali kao da je naša bolnica u Čakovcu ničija ili napuštena, kako bi sami preuzeli vlasništvo.














demografija i iseljeništva i Đurđica Slamek, predsjedavajuća kolegija načelnika i gradonačelnika
IVAN ŠIPIĆ, ministar demografije i iseljeništva, na sastanku s kolegija međimurskih načelnika i gradonačelnika
- Ministar nije dao konkretan odgovor na zahtjev (grado)načelnika da država preuzme financiranje plaća svih djelatnika u vrtiću, dok bi općine i gradovi preuzele ostale obveze
Piše:
Božena Malekoci-Oletić
Prije tri mjeseca, točnije 2. srpnja, Kolegij gradonačelnika i načelnika u Međimurskoj županiji prošlo je otkako je Andreju Plenkoviću i ministru znanosti i obrazovanja Radovanu Fuchsu poslan zahtjev za �inanciranje plaća djelatnicima u dječjim vrtićima, kazala je Đurđica Slamek, predsjedavajuća Kolegija međimurskih načelnika i gradonačelnika na sjednici na koju je umjesto odgovora došao došao ministar demogra�ije i useljeništva Ivan Šipić.
U njegovoj pratnji bile su Natalije Havidić, ravnateljica Uprave za upravljanje javnim politikama za demografsku revitalizaciju i useljeništvo, Ivana Perkušić, ravnateljica Uprave za provedbu javnih politika za useljeništvo, Ante Babić, ravnatelj Uprave za provedbu javnih politika za demografsku revitalizaciju te savjetnica Martina Andrijević.
Prijedlog međimurskih načelnika i gradonačelnika ima za cilj osigurati najbolji mogući predškolski odgoj za svu djecu u Hrvatskoj, bez obzira na mjesto prebivališta, stoji u njihovu zahtjevu Vladi.
Na općinama i roditeljima neizdrživi teret troškova - Želimo upozoriti
Ministarstvo na kritičnu








situaciju u sustavu predškolskog odgoja, uzrokovanu nedostatkom adekvatnog �inanciranja od strane države. Zbog toga se gradovi i općine, a posljedično i roditelji djece suočavaju s neizdrživim �inancijskim teretom. Načelnici i gradonačelnici svjesni su da je demografska slika Hrvatske zabrinjavajuća zbog sve manjeg broja rođene djece, stoga već sada općine i gradovi vode niz mjera �inancijske potpore obiteljima.
U pismu su ukazali i na važnost što ranije socijalne integracije Roma i kroz vrtiće, ali najveći teret snosi lokalna samouprava. Zbog velikih izdataka mnoge jedinice lokalne samouprave nemaju dovoljno �iancijskih sredstva zaadekvatne plaće djelatnika dječjih vrtića te druge potrebe, što omogućuje realizaciju bitnih projekata. Smatraju da su sredstva iz državnog proračuna za �iskalnu održivost vrtića nepravedno raspodijeljena i premala i da bi država u potpunosti mora preuzeti �inanciranje plaća svih djelatnika dječjih vrtića, dok bi općine i gradovi preuzele sve ostale obveze, osim izgradnje vrtića, čime bi polazak djece u vrtić bio besplatan. Preuzimanjem �inanciranja plaća svih djelatnika vrtića od strane države, kao što se već �inanciraju plaće nastavnika i profesora, osigurala bi se pravednost i ravnopravnost predškolskog odgoja i obrazovanja s ostalim dijelovima
obrazovnog sustava, te osigurali jednaki uvjeti za svu djecu i ujednačio standard u dječjim vrtićima, ponovila je sadržaj pisma Vladi, Đurđica Slamek, predsjedavajuća Kolegija načelnika i gradonačelnika.
Ervin Vičević, načelnik Općine Selnica, istaknuo je da će za predškolski odgoj u njegovoj općini uskoro trebati čak 18 posto proračuna, što je neodrživo. Nezadovoljan tijekom sastanka na kojemu nisu predložena konkretna rješenja, napustio je sastanak. Nije bio jedini. Anđelko Nagrajsalović, načelnik Općine Sv. Juraj na Bregu, upozorio je i na paralelni problem, nedostatak stručnog kadra, zbog dugog vremena iznimno niskih plaća odgojitelja. Dodao je da �iskalnim izravnanjem općine više kategorije razvijenosti, dobiju onoliko koliko u investicijama, kroz PDV, moraju vratiti državi Nikola Novak, načelnik Općine Nedelišće: - Na natječaje smo prijavili tri vrtića jer nam treba još mnogo mjesta za djecu, a – primjerice – za matičnu ustanovu dobili smo 1,9 milijuna eura iz EU fonda, a treba nam najmanje šest milijuna, koje trebamo osigurati iz vlastitih sredstava. Stanislav Rebernik, načelnik Općine Štrigova upozorio je i na problem privatnih vrtića, koji će se početi gasiti, jer ne mogu konkurirati za natječaje na koje se apliciraju projekti općinskih i gradskih vrtića.

ŽALBA na izbor nove direktorice GKP-a ČAKOM
Lidija Miše
Novoizabrana direktorica GKP-a ČAKOM, Lidija Miše Jalšovec, dipl. oec. iz Čakovca
još nije ni sjela u direktorsku fotelju, a njeno ime već se počelo povlačiti u javnosti.


Sa sjevera iselilo 20.000 ljudi i zbog dvostrukog oporezivanja
Župan Matija Posavec je ministru Šipiću iznio i speci�ičnosti Međimurja kao pogranične županije gdje, te najnoviji demografski nepovoljan trend. - U mnogim sam prilikama apelirao da se što prije riješi pitanje dvostrukog oporezivanje naših građana, što je osobito velik problem u Međimurju. Naši građani, s vremenom su, upravo zbog dvostrukog oporezivanja, počeli s cijelim obiteljima iseljavati u Austriju. Zadnjih godina s hrvatskog sjevera iselilo je 20.000 ljudi. To je alarmantna brojka, osobito u svjetlu činjenice da te ljude nismo morali izgubiti da je bilo malo više sluha na najvišim razinama vlasti, istaknuo je Matija Posavec, spomenuvši i jednosmjensku nastavu u školama kao cilj kojim se doseže i kvalitetniji obiteljski život. - U tom je smislu iznimno važno da u Ministarstvu znanosti i obrazovanja ubrzaju izdavanje suglasnosti za projekte izgradnje, obnove i dogradnje škola, što je nama u Međimurskoj županiji zbog snažne projektne aktivnosti uistinu velik problem, pojasnio je župan, naglasivši da je ulaganje u djecu najjeftiniji, a najučinkovitiji način za napredak društva.
Novu direktoricu, po ponovljenom natječaju, na koji je pristiglo jedanaest prijava, od kojih je pet bilo pravovaljano, jednoglasno je 18. rujna izabrao Nadzorni odbor. Izbor je na svojoj sjednici 26. rujna potvrdila i Skupština Društva GKP-a ČAKOM.
Međutim, na odluku Skupštine žalio se jedan od kandidata koji se za fotelju prvog čovjeka javio u prvom i drugom natječaju. Glavni argument žalbe mu je to što nova direktorica nema potrebne godina iskustva na rukovodećoj poziciji što je bio jedan od uvjeta natječaja.
- Lidija Miše Jalšovec bila nam je najbolja kandidatkinja. Prosto je nevjerovatno da nam je nedostatak njenog iskustva na rukovećoj poziciji promaknuo, doznali smo. Službenog odgovora iz ČAKOM-a još uvijek nema, odnosno postoji li mogućnost žalbe na odluku Skupštine. Je li kandidat prije mogao uložiti žalbu odmah nakon odlike, no u konačnici, službeno nije poznato zbog čega njegova kandidatura nije prošla. Istina, riječ je o kandidatu koji u svom životopisu ima i veliku mrlju i je li to bilo presudno, ne zna se. Ipak, kako stvari stoje, izbor Lidije Miše Jalšovec ne dolazi u pitanje, jedino ako se ona nakon svega ne povuče. Ali o tome u idućem broju za kada se očekuje i odgovor iz ČAKOM-a. (vv)
DAN POLICIJE i svečana akademija
Na svečanoj akademiji povodom Dana policije, koja će se održati u petak 4. listopada, bit će nagrađeni najbolji policajci Međimurske županije. Načelnik Policijske uprave međimurske će uručiti pohvalnice Radovanu Gačalu iz Ureda načelnika, Aniti Šantek i Ines Goričanec iz Službe kriminalističke policije, Dejanu Ignacu iz Policijske postaje Čakovec, Barbari Balenović i Davoru Koširu iz Policijske postaje Mursko Središće, Spomenku Gojseku iz Policijske postaje Prelog te Mariu Levačiću i Nenadu Kosu iz Postaje prometne po-










Glasnogovornik PU međimurske Radovan Gačal primit će pohvalnicu
licije Čakovec. Svi nagrađeni su svojim radom, zalaganjem i ponašanjem ostvarili izvrsne rezultate koji su pozitivno utjecali na sveukupnu kvalitetu rada i ugled policije. (sh)
VODOSTAJ MURE raste kod Murskog Središća
Od
Obilne kiše u čas mogu promijeniti vodostaj Mure i Drave. Mura je u Murskom Središću u noći od srijede na četvrtak od pola noći do sedam ujutro, u svega sedam sati narasla za jedan metar. Vodostaj Mure u 12 sati u četvrtak je bio 332 centimetara. Na 330 centimetara se uvodi pripremno stanje obrane o poplave, a redovne e mjere počinju se provoditi na 380 centimetara. Zbog kiše u Austriji,
procjenjuje se da bi u petak podne vodostaj mogao narasti na 380 centimetara, kazao je gradonačelnik Srpak i dodao da je teško prognozirati vodostaj, jer u ovim klimatskim uvjetima promjene mogu biti nagle i nepredvidive.
Zbog toga je po drugi put odgođena vježba Civilne zaštite na skeli Fusek, jer je povećani vodostaj poplavio pristupni put do skele. (BMO)
Piše: Božena Malekoci-Oletić
Statističarima treba vremena da obrade podatke i kad su rezultati gotovi, s odmakom od devet mjeseci, pogled na poslovne rezultate iz 2023. godine je pogled u prošlost. A prošla godina je statistički gledano za međimursko gospodarstvo bila jako lijepa i pro�itabilna.
Mladen Križaić, predsjednik Gospodarskog vijeća Županijske gospodarske komore, kaže da je prošla godina bila za međimurske poduzetnike najbolja poslovna godina unatrag deset godina.
Ivan Senčar, privatni poduzetnik, sadašnji član, a u nekoliko navrata i predsjednik Gospodarsko-socijalnog vijeća Međimurske županije, ima nešto drugačiji pogled na međimursku poslovnu stvarnost. Ukazao je na paradoks da BDP raste, a bruto nacionalna sreća pada i da je to uzrok odljeva naših radnika preko granice, gdje mogu ostvariti znatno veća primanja.
I dalje se prodajemo za jeftilen
Zvonimir Siladi, županijski vijećnik, svojedobno i predsjednik Skupštine Međimurske županije, dakle, političar regionalnog kalibra, ukazuje na treću stvar koja itekako utječe na gospodarstvo: - Međimurci se ne cijene dovoljno, kaže i argumentira: - To je vidljivo po niskim plaćama u odnosu na druge regije plaćama i to ne samo naših radnika, već i voditelja određenih poslovnih procesa, direktora, ujedno i vlasnika svojih poduzeća.
Kad se stvarala nova gospodarska arhitektura Međimurja, tada su se željeni strani investitori privlačili nuđenjem naše marljive, a jeftine radne snage, uz odličan geopolitički položaj Međimurje, kao bonus jeftinoj radnoj snazi. Takav primjer su poznate green �ield investicije Tubla i HAIX. Kao kad je Calzedonia osnovala Tublu u Čakovcu,

u čast dolaska talijanskog investitora koji je zaposlio naše tekstilne radnice, ulici u kojoj je na livadi niknula nova tvornica, dali su ime Talijanske Republike. Sam premijer, pokojni Račan, nazočio je otvaranju nove tvornice, počastivši lokalne političare i šefove strane investicije zajedničkim gledanjem neke reprezentativne nogometne utakmice u prostoru nove tvornice ne bi li im time dao na značaju.
Toliko o našoj snishodljivosti kojom se snižava cijena našeg rada i naših usluga, kao, time što su naše usluge manje vrijedne.
Međimursko gospodarstvo se s puno muke do 2000. ispetljava iz procesa tranzicije. Tradicionalne nisko akumulativne grane – građevinarstvo i proizvodnju tekstila – počela je potiskivati sve snažnija metalska industrija.



Veliku krizu koja je zahvatila svijet nakon 2008. godine međimurski poduzetnici su iskoristili za veliko čišćenje od svega onoga što je opterećivalo njihovo poslovanje. Krizu su prevladali ubacujući se u dobavne lance na zapadnim razvijenim tržištima. Nažalost, kao konkurentsku prednost nudili su niže cijene, bazirane na jeftinoj, ali kvalitetnoj radnoj snazi.
Poduzetnici su navijali za što brži ulazak Hrvatske u EU, što im je sa sobom donijelo velike bene�ite od otvaranja tržišta za naše proizvode i lakše poslovanje, a pogotovo nakon prelaska s kune na euro.
Međutim, dogodilo se nešto na što poslodavci nisu računali, da će najvitalniji dio domaće radne snage s otvaranjem tržišta pronaći konkurentnije poslodavca na otvorenom europskom tržištu.
Rast plaća u javnom sektoru, gospodarstvo ne može pratiti
- Analizirajući izvješće o rezultatima poslovanja za 2023. godinu dalo bi se zaključiti da je međimursko gospodarstvo jako žilavo i da prolazi sve poteškoće koje se javljaju s vremena na vrijeme. Bez obzira na nedostatak radne snage, pokazalo se da se možemo snaći u svakoj novonastaloj situaciji, kazao je Ivan Senčar.



Zvonimir Siladi, županijski vijećnik: Premalo se cijenimo i to se vidi po malim plaćama, od radnika do direktora

Dodaje: - Vidljivo je da mi malo stagniramo. Kad gledam kao poduzetnik, vidim da su nam dobiti u poslovanju porasle, ali to nije realan rast. Moramo uzeti u obzir i učinak in�lacije. Mi se volimo natjecati s ostalima, ali mene to previše ne muči, kazao je. Moramo uzeti u obzir da je Međimurska županija najsjevernija i da je odavde najlakše otići drugom poslodavcu preko granice. Zašto bi radnik išao raditi u Donji Kraljevec, ako mu je bliže u Ljutomer, a plaća mu je tamo 40, 50 i čak i više posto veća nego ovdje.

BROJKE O REZULTATIMA poslovanja za 2023. godinu ukazuju
Odlazak naših radnika se nadomješta uvozom manje stručnih stranih radnika i pitanje je kako će to utjecati na kvalitetu gospodarstva u narednim godinama
1. MESNA INDUSTRIJA
VAJDA d. d. Čakovec
2. PERUTNINA PTUJ - PIPO d.o.o. Čakovec
3. TEHNIX d.o.o. Donji Kraljevec
4. TUBLA d.o.o. Čakovec
5. LPT d.o.o. Prelog
6. MURAPLAST d.o.o. Kotoriba
7. MEĐIMURJE-PLIN d.o.o. Čakovec
8. HILDING ANDERS d.o.o. Prelog
9. HAIX Obuća d.o.o. Mala Subotica
10. MEĐIMURJE PMP d.o.o. Čakovec
Nastavlja: - U toj šumi lijepih i bajnih podataka ima i onoga što nije u redu, ali ne ovisi sve samo o Međimurju, nego i o potezima koje je napravila Vlada. Neki su jako dobri, a neki neće riješiti probleme, jer stalno grebemo po površini, a ne po uzrocima. A njima već govorimo 20 godina, ali sipamo prijedloge u vjetar, jer smo kao Gospodarsko-socijalno vijeće samo savjetodavno tijelo. Dotaknut ću se nekih nelogičnosti: - Rezultati poslovanja međimurskih poduzetnika su lijepi, ali ljudi odlaze iz Međimurja i to potaknuti ovim stvarima koje vide oko sebe. Ovako dići plaće u javnom sektoru, a već su i prije podignute, to u
realnom sektoru nije moguće postići. Dodao je : - Postavlja se pitanje je li netko izgubio kompas, da u situaciji kad ljudi primaju mirovine od 400 do 500 eura, u javnom sektoru netko sam sebi digne plaću za 2500 eura. Mi poslodavci u realnom sektoru moramo ostvariti dobit da bi nekome podigli plaću pri čemu neke gospodarske grane ni ne ostvaruju dobit.
Kazao je: - Nekad se zgrozim kako dolaze politički nekompetentni ljudi za gospodarstvo. Mogli bi doći učiti od nas, ali nas ne slušaju, kazao je Senčar. Mladen Križaić je optimističniji. Kaže: - Međimursko gospodarstvo je i dalje izvozno orijentirano, što je jako


Mladen Križaić, predsjednik Gospodarskog vijeće Gospodarske komore Međimurske županije: Međimursko gospodarstvo je i dalje izvozno orijen�rano, što je jako važno
važno. Osvrnuvši se na trendove za ovu godinu podsjetio je da rujanske najave iz HNB-a
govore o rastu od BDP-a od 3,6 posto za Hrvatsku i da ako se ostvari i prognoza o rastu plaća od 15 posto u ovoj godini, i padu in�lacije na 3,9 posto, u odnosu na 8,4 posto, koliko je in�lacija iznosila na kraju 2023. godine, po tome bi i 2024. godina trebala biti također uspješna. Na pitanje čije plaće su uključene u taj rast od 15 posto, Križaić je kazao da se u taj rast uračunavaju i one u javnom i realnom sektoru. Zamolili smo ga za komentar o utjecaju in�lacije na povećane brojke u rezultatima poslovanja. Križaić smatra da na rast gospodarstva in�lacija ne bi trebala imati utjecaj, jer su se stabilizirale cijene energenata

da klizimo na ljestvici konkurentnosti
također odraziti na stanje u gospodarstvu.
1. HAIX Obuća d.o.o.
Mala Subo�ca - 1233
2. PERUTNINA PTUJ - PIPO d.o.o. Čakovec - 709
3. TEHNIX d.o.o.
Donji Kraljevec - 568
4. HILDING ANDERS d.o.o. Prelog - 568
5. PROIZVODNJA PG d.o.o. Prelog - 416
ima – pa je onda pravo vrijeme za razmisliti što dalje. Međimurje je pred novim razvojnim ciklusom. Mora skočiti na višu razvojnu stepenicu ili će početi padati. Ako nam je spajanje na gospodarske i �inancijske tokove ulaskom u EU donijelo stabilnost i rast, potpomognuto �inancijskim injekcijama iz fondova EU-a, sada je zadnji vlak za transformaciju gospodarstva na novu razinu, jer se naziru prvi znakovi stagnacije.
Od proljeća mic po mic pada broj zaposlenih, unatoč potražnji za radnicima. Gospodarska struktura nam se presporo mijenja. I dalje po broju zaposlenih prevladavaju zaposleni u prerađivačkoj, industriji, građevinarstvu i trgovini s plaćama malo iznad zakonskog minimuma.
Prosjek popravljaju metalci, koji su se preobrazili u međimurske gospodarske lidere.
Ono što je također uočljivo je da se zadnjih godina dogodila i vlasnička transformacija. Sve je više velikih i značajnih �irmi u Međimurju u čijoj je pozadini strani vlasnički kapital. Nekad značajni domaći poduzetnici, ili su svoje �irme prodali, povukli se s prvih položaja ili su preminuli.
1. LPT d.o.o. Prelog
2. TUBLA d.o.o. Čakovec
3. MURAPLAST d.o.o. Kotoriba
4. TEHNIX d.o.o. Donji Kraljevec
5. HAIX Obuća d.o.o. Mala Subo�ca
godinu obuhvatila je 3792 poduzetnika (obveznika poreza na dobit, bez �inancijskih institucija). Poduzetnici Međimurske županije ostvarili su neto dobit u iznosu od 191,7 milijuna eura, što je 10,2 % više u odnosu na prethodnu poslovnu godinu.
6. CENTROMETAL d.o.o. Macinec
7. EKO MEĐIMURJE d.d. Čakovec
8. HILDING ANDERS d.o.o. Prelog
9. TE-PRO d.o.o. Sv. Mar�n na Muri
10. LTH ALUCAST d.o.o. Čakovec
1. TMT d.o.o. Čakovec
2. LPT d.o.o. Prelog
6. EKO MEĐIMURJE d.d. Čakovec - 393
7. TUBLA d.o.o. Čakovec - 384
8. LPT d.o.o. Prelog - 322
9. MESNA INDUSTRIJA VAJDA d.d. Čakovec - 310
10. MURAPLAST d.o.o. Kotoriba - 288
i porasla je potrošnja. I dok je Križaić optimističan, građani ne vide smirivanje in�lacije kad odu u nabavku živežnih namirnica u trgovinu. Plaće zaposlenih u realnom sektoru gdje radi većina Međimuraca, gotovo 30.000 zaposlenih, ne prate rast plaća zaposlenih u javnom sektoru. S druge
Križaić priznaje da poslodavci imaju određenu dozu zabrinutosti oko gospodarskih kretanja. Uz to, odlazak domaće radno aktivne snage se ne zaustavlja, jer im naši poslodavci ne mogu osigurati rast plaća na način kako one rastu zaposlenima u javnom sektoru.
S druge strane, odlazak naših radnika se nadomješta uvozom manje stručnih stranih radnika i pitanje je kako će i to utjecati na kvalitetu gospodarstva u narednim godinama.
To će zasigurno biti jedno vrijeme uteg našem gospodarstvu, dok se strani radnici koji odluče ostati kod nas ne usavrše, kaže Križaić.
Zadnji vlak za ulazak na višu razinu
Investira se i ulaže onda kad se ima. A ako statistika iz 2023. godine ne laže, onda se Top 10 poduzetnika u Međimurskoj
strane kupovna moć zaposlenih u javnom sektoru diže potrošnju i rast cijena živežnih namirnica, što će se
Strani kapital je pak, ne smijemo smetnuti s uma, ptica selica. Ne razmišlja o utjecaju na regionalnu društveno-socijalnu situaciju. Kad ne ostvaruje zadovoljavajuće pro�ite, seli dalje. Domaćim poduzetnicima okruženim susjedima i prijateljima nije tako lako odseliti pa vode više računa o zajednici u kojoj žive. Sve to se odražava i na demografsku strukturu Međimurske županije. Već sada imamo strane vlasnike koji, da bi održali određenu razinu proizvodnje uz optimalnu zaradu, sve više u naš prostor uvode zapošljavanje stranaca. Samo lani je bilo odobreno preko četiri tisuće radnih dozvola za strance.
Malo statistike o rezultatima međimurskih poduzetnika
Međimurska županija zauzima 10. mjesto rang-liste svih županija prema broju poduzetnika, 8. mjesto prema broju radnika, 10. mjesto prema ukupnim prihodima, 11. mjesto prema dobiti razdoblja, 16. mjesto prema gubitku razdoblja, 10. mjesto prema ostvarenoj neto dobiti, 14. mjesto prema produktivnosti (prihod po radniku), 14. mjesto prema produktivnosti rada – neto dobiti po radniku te 11. mjesto rang-ljestvice prema ekonomičnosti poslovanja.
Analiza �inancijskih rezultata poduzetnika Međimurske županije za 2023.
Prvih deset poduzetnika prema ostvarenom izvozu ostvarilo je 428,8 mil. od prodaje u inozemstvu, što je 40,3 % ukupnog izvoza županije. Od 3,1 milijardi eura prihoda, prodajom proizvoda i usluga na inozemnom tržištu ostvaren je prihod u iznosu od 1,1 milijardi eura, što je 1,1 % manje nego u 2022. godini. Istodobno je na stranim tržištima kupljeno robe u vrijednosti od 547,9 milijuna eura iz čega slijedi da je ostvaren trgovinski su�icit u iznosu od 514,9 milijuna eura.
- Međimurska županija si ne može tepati da je lokomotiva hrvatskog gospodarstva jer je lani zauzimala 10. mjesto rang-liste svih županija prema broju poduzetnika, 8. mjesto prema broju radnika, 10. mjesto prema ukupnim prihodima, 11. mjesto prema dobiti razdoblja, 16. mjesto prema gubitku razdoblja, 10. mjesto prema ostvarenoj neto dobiti, 14. mjesto prema produktivnosti (prihod po radniku), te 11. mjesto rang-ljestvice prema ekonomičnosti poslovanja
Na području Međimurske županije prema kriteriju broja radnika dominantnu ulogu imaju prerađivačka industrija, građevinarstvo i trgovina na veliko i na malo, popravak motornih vozila i motocikala. Najviše radnika, 15.967 ili 53,6 % zaposleno je u
3. PERUTNINA PTUJ - PIPO d.o.o. Čakovec
4. MURAPLAST d.o.o. Kotoriba
5. TVORNICA STOČNE HRANE d.d. Čakovec
6. KOMET d.o.o. Prelog
7. TEHNIX d.o.o. Donji Kraljevec
8. HAIX Obuća d.o.o Mala Subo�ca 9. ŠESTAN-BUSCH d.o.o. Prelog
TE-PRO d.o.o Sv. Mar�n na Muri
Izvor: Fina, Registar godišnjih financijskih izvještaja
prerađivačkoj industriji. U navedenoj djelatnosti ostvarena je prosječna mjesečna neto plaća u iznosu od 1004 eura, što je 10,6 % više nego 2022. godine te 7,8 % više od prosječne plaće županije. Drugu značajnu skupinu čine poduzetnici iz djelatnosti građevinarstva, gdje je bilo zaposleno 4124 radnika ili 13,8 % od ukupnog broja radnika na razini županije. Prosječna mjesečna neto plaća u navedenoj djelatnosti na razini županije obračunata je u iznosu od 794 eura, što je 11,6 % više nego 2022. godine te 14,7 % manje od prosjeka županije.
U trgovina na veliko i na malo i popravak motornih vozila i motocikala bilo je zaposleno 2426 radnika ili 8,1 % od ukupnog broja radnika na razini županije. Radnicima u djelatnosti trgovine na veliko i na malo te popravku motornih vozila i motocikala obračunata je prosječna mjesečna neto plaća u iznosu od 809 eura, što je ispod prosjeka županije za 13,2 %.
Trgovine KRK (7-11 sati)
• Belica, Dr. Ljudevita Gaja 23
• Cirkovljan, Trg sv. Lovre 4
• Čakovec, E. Kvaternika 7 (7-19 sati)
• Čakovec, V. Morandinija 21
• Čakovec, Vukovarska 1
• Črečan 42
• Domašinec, Glavna 164
• Donja Dubrava, Trg Republike 16
• Donji Hrašćan 51
• Donji Vidovec, R. Končara 9
• Držimurec 98
• Gardinovec, Glavna 262
• Gornji Mihaljevec 74a
• Hlapičina 172
• Kotoriba, K. Tomislava 98
• Krištanovec 122
• Križovec 17
• Orehovica, N. Tesle 23
• Pleškovec 30
• Podturen, I. Grčića 6
• Sveta Marija, B. Radića 28
• Sveti Urban 33
• Štefanec, Zrinskih 26
• Vratišinec, Brodec 49
• Zasadbreg 153a NTL trgovine
• Gardinovec 183
• Goričan, Murska 3
• Jurovec 20a
• Mursko Središće, Frankopanska 11
• Novakovec, Glavna 32
• Okrugli Vrh 62b
• Pleškovec 160
• Pušćine, Školska 23
• Sivica, Glavna 45
• Totovec, Čakovečka bb
• Vratišinec, Dr. V. Žganca 53 Ostale trgovine
• KONZUM, Čakovec, Trg Republike 6 (8-13 h)
• KONZUM, Pribislavec (7-13 h)
• LIDL Čakovec, S. Radića 31 (8-14 h)

DRUŠTVO POTROŠAČA MEĐIMURJA www.savjetovaliste.info savjeti@savjetovaliste.info info: 0800/42-00 (svaki radni dan od 09:00 - 13:00 sati)

Knjigovodstvo Cimerman d.o.o. Ljudevita Gaja 9, 40000 ČAKOVEC tel: 040/311-109 • mob: 091/311-1099 fax: 040/314 -183 mail: knjigovodstvo@cimerman.hr
CIMERMAN
POGLED ODOZDO
Nevjerojatan su mi fenomen ljudi koji postanu ministri, a koji, kad stupe na dužnost, uzimaju sebi za pravo da se tek upoznaju sa situacijom. I to ne s unutarnjom organizacijom svog ministarstva, nego s problematikom koju trebaju operativno rješavati, jer oni su izvršna vlast, a ne netko drugi. I onda velikom stvari proglašavaju odlazak na teren da bi saznali što ljudima treba. Špancir ministri. Običan građanin, platiša











poreza, od ministra koji jedan mjesec zaradi koliko obični radnik u godinu dana, očekuje da je ministar na čelo ministarstva došao s brdom rješenja za boljitak svoje zemlje. Ministar Šipić koje je ovaj tjedan došao u Međimurje nije ostavio takav dojam.
Da je demografija gorući problem ove države, građani to znaju ne treba im to tumačiti. Kao ni abecedu biologije da beton i asfalt ne rađaju djecu, nego majke. Žene se može na





Župan Ma�ja Posavec, predsjednik FIJET-a Tijani Haddad, predsjednica Međunarodnog udruženja novinara i pisaca u turizmu Tina Eterović Čubrilo i direktor Turis�čke zajednice Međimurske županije Rudi Grula prilikom dodjele nagrade
MEĐIMURSKA ŽUPANIJA zasjala na svjetskoj turističkoj pozornici
Zlatna jabuka potvrđuje Međimurje kao vodeću održivu turističku destinaciju u Hrvatskoj
Piše: Jelena Tomašić
Na Svjetski dan turizma, 27. rujna, održana je svečana dodjela Zlatne jabuke u atriju Starog grada Zrinskih u Čakovcu. Ova prestižna nagrada, koju dodjeljuje Međunarodna federacija novinara i putopisaca (FIJET), priznaje izvanredna postignuća u turizmu, s posebnim naglaskom na održivost, zaštitu okoliša i očuvanje bioresursa.
Učvršćen status destinacije s oznakom Green Destination Dobitnici Zlatne jabuke moraju ispuniti stroge kriterije, a nagrada služi kao potvrda kvalitete ponude i prepoznatljivosti turističkih destinacija. Ove godine, Međimurska županija ponosno je osvojila Zlatnu jabuku, čime se dodatno učvrstio njen status kao turističke destinacije s oznakom Green Destination. Ovaj status čini je prvim mje-
stom u Hrvatskoj i četvrtim na svijetu sa sličnim priznanjem. Ova nagrada često se opisuje kao „turistički Oscar“ i predstavlja velik uspjeh u izrazito konkurentnom okruženju. Svečanost je privukla brojne uzvanike, među kojima su bili direktor Turističke zajednice Međimurja Rudi Grula, župan Matija Posavec, predsjednica Međunarodnog udruženja novinara i pisaca u turizmu Tina Čubrilo i predsjednik FIJET-a Tijani Haddad. Tijekom večeri, okupljene su zabavljali sopranistica Marija Vidović, izvođač Mirko Švenda Žiga i drugi izvođači. Rudi Grula, direktor Turističke zajednice Međimurja, otvorio je svečanost s toplim pozdravom: - Dopustite mi da vas pozdravim raširenih ruku. Dragi prijatelji, hvala vam što ste se pridružili ovoj večeri. Ova nagrada nije uspjeh jednog čovjeka ili malog tima; to je rezultat suradnje svih nas u turističkom sektoru. Kvaliteta je toliko dobra koliko je čvrst taj
lanac. Njegove riječi oslikavaju zajedništvo i sinergiju koja je potrebna za uspjeh u turizmu.
Župan Matija Posavec naglasio je važnost održivog turizma u razvoju Međimurja: - Ova nagrada od strane međunarodnih novinara svjedoči o našem strateškom pristupu razvoju turizma. Turizam je sveobuhvatan – uključuje kulturu, povijest, gastronomiju i prirodne ljepote. Naš cilj je povezati sve te elemente u jedinstveni brand, kako bismo promovirali cijelu regiju. Župan je također istaknuo da se Međimurje nalazi između dviju rijeka, Mure i Drave, te da ta prirodna pozicija doprinosi bogatoj eno-gastronomiji i očaravajućim prirodnim ljepotama.
Ispunili stroge kriterije u pogledu održivosti i zaštite okoliša
- Svaka naša općina i grad imaju svoju jedinstvenu priču
koju žele ispričati, dodao je, naglašavajući kulturnu raznolikost regije. Za osvajanje Zlatne jabuke, Međimurska županija ispunila je stroge kriterije u pogledu održivosti i zaštite okoliša, što je posebno važno u današnje vrijeme kada se turizam suočava s izazovima.
Ova nagrada predstavlja ne samo priznanje, već i motivaciju za daljnji rad i razvoj turizma u regiji.
Na kraju, Rudi Grula je naglasio da, iako ovo nije prva nagrada za Međimursku županiju, ona je za njega osobno najdraža. - Ova nagrada je rezultat zajedničkog truda svih nas koji smo uključeni u turistički sektor, jer uspjeh se postiže samo kroz čvrstu suradnju i zajedništvo, zaključio je s ponosom.
Ova svečanost stoga nije samo proslava postignuća, već i inspiracija za buduće korake u razvoju održivog turizma u Međimurju.
silu prisiliti da počnu rađati više djece, samo ako se uveze talibanski režim i ženama oduzmu ljudska prava. Svede ih se na rađanje kao da se radi o povećanoj proizvodnji ljudskog kapitala “u interesu države”.
Srećom da trenutačna Hrvatska politički, a ni geografski nije izolirana kao Afganistan, pa bi pokušaji takve nazadnjačke politike odveli još više žena i muškaraca preko granice. Demografska politika
je puno složenija od toga: - Dat ćemo ženama cijelu plaću dok su na porodiljnom dopustu. Kako velikodušno, hvala ministre! Djecu ne rađamo radi naknade, a troškovi njihova uzdržavanja rastu zajedno s djecom.
Veće dijete – veći trošak. Djeca se rađaju iz ljubavi i u današnjem svijetu roditelji ne žele svoju djecu osuditi na siromaštvo, jer bi to bila svjesna društvena i socijalna marginalizacija. Niti pak itko
ima pravo ženama spočitavati sebičnost ili bilo što drugo o tome jesu li, ili nisu rodile, ili jesu li rodile dovoljno djece.
Državna vlast i njezini ministri trebaju prestati s populističkom propagandom i nametanjem krivnje građanima. Njihov je posao donositi efikasne mjere zbog kojih će građani osjetiti boljitak u svojim životima. Ne trebaju građanima ministri-propovjednici, njih će, ako imaju potrebe za njima, pronaći drugdje.


ŽUPANIJSKA GOSPODARSKA komora Čakovec dodijelila Zlatne kune najuspješnijim poduzetnicima u prošloj godini
Piše: Božena Malekoci-Oletić
Hrvatska gospodarska komora svake godine bira najbolje tvrtke ocjenjujući ih po dvadesetak kriterija uspješnosti poslovanja. Najbolje �irme biraju se po kategorijama za male srednje i velike �irme prema broju

zaposlenih. Kriteriji su utvrđeni na nacionalnoj razini, a najbolje �irme biraju se na regionalnoj razini, dok dobitnici Zlatnih kuna na nacionalnoj razini ulaze u nominaciju za nagradu Zlatna kuna na nacionalnoj razini. Preloški Komet je dobitnik ove prestižne gospodarske nagrade u kategoriji velikih tvrtki, a nagradu je dobio četvrti put.
Čime se bave nagrađene firme
Komet je osnovan 1992. i bavi se proizvodnjom transformatorskih kotlova, metalnih konstrukcija, pocinčanih gazišta, strojeva za obradu granita i mramora, cjevovoda, metalnih kalupa, izmjenjivača topline, prigušivača zvuka, iskro-hvatača, rezervoara za gorivo i drugoKomet zapošljava oko 270 radnika. Velika pažnja posvećuje se razvoju, kupovini suvremene opreme i izgradnji proizvodnih objekata, sve u cilju povećanja kvalitete, produktivnosti i plaća radnika.
O.M.T. iz Ivanovca dobitnik je nagrade u kategoriji
srednjih tvrtki, a nagradu je dobio po drugi put. Tvrtka je osnovana 1997. godine, osnivači Ivan Sokač i Stanislav Vadas su ujedno i odgovorne osobe. Tvrtka raspolaže s više od 30 CNC strojeva smještenih u radnom prostoru od 2000 m2 gdje je zaposleno 57 djelatnika. Proizvodni program temelji se na dijelovima za tiskarsku industriju, proizvodnji dijelova građevinskih strojeva, dijelova vlakova i vagona, dijelova rudarskih strojeva i opreme, dijelova strojeva u autoindustriji, dijelova strojeva za proizvodnju guma i slično. Posluju kako na području Hrvatske tako i zemalja Europske unije. Firma Cetitec Čakovca dobitnik je nagrade u kategoriji malih tvrtki. Bavi se računalnim programiranjem specijaliziranim za autoindustriju. U �irmi radi četrdesetak inženjera lociranih što u Zagrebu, što u Čakovcu. Svečanost dodjele održana je u Castellumu u Čakovcu, a dobitnicima ih je uručio Mladen Križaić, predsjednik Gospodarske komore Međimurske županije.



Muraplastu nagrada za najbolju veliku održivu tvrtku u Hrvatskoj
Na svečanosti je javno obznanjeno da je po drugi put nagradu Hrvatske gospodarske komore dobila �irma Muraplast. U sklopu konferencije Hrvatske gospodarske komore (HGK) “Podržimo održivo – Support Sustainability” održana je svečana dodjela nagrada za izvanredna postignuća u ESG praksama. Tvrtke su ocjenji-







vanje na temelju njihovog pristupa okolišu (Environment), društvu (Social) te usvojenim praksama upravljanja (Governance), a drugu godinu zaredom Muraplastu dodijeljena je nagrada za najbolju veliku održivu tvrtku u Hrvatskoj.
Na svečanosti su dodjele nagrada Županijske gospodarske komore Čakovec u Castellumu bili nazočni brojni ugledni poduzetnici, predsjednik Obrtničke komore Dražen Novak, gradonačelnici Ljubomir

Na temelju članka 30. stavak 1. alineja prva i članka 32. stavak 2. Zakona o izvlaštenju i određivanju naknade („Narodne novine“ 74/2014, 69/2017, 98/2019) MEĐIMURSKE VODE d.o.o. objavljuju sljedeći
(PONUDU ZA OSNIVANJE PRAVA SLUŽNOSTI NA ZEMLJIŠTU)
kojim se pozivaju svi vlasnici na sporazumno rješavanje pitanja ustanovljenja služnosti na sljedećim nekretninama:
K.O. SELNICA
KAT.ČEST.BR. ZK.ČEST.BR. KULTURA
POVRŠINA SLUŽNOSTI
6232 6232 k.o. Selnica dvorište, poslovna zgrada 57 m2
K.O. PEKLENICA
KAT.ČEST.BR. ZK.ČEST.BR. KULTURA POVRŠINA SLUŽNOSTI
710 710 k.o. Peklenica kuća, dvorište, oranica, šuma, voćnjak 29 m2
K.O. MURSKO SREDIŠĆE
KAT.ČEST.BR. ZK.ČEST.BR. KULTURA
POVRŠINA SLUŽNOSTI
5709 5709 k.o. Mursko Središće oranica 50 m2
643 643 k.o. Mursko Središće dvorište, parkiralište 75 m2
694/1 694/1 k.o. Mursko Središće dvorište 25 m2
MEĐIMURSKE VODE d.o.o., u suradnji sa Hrvatskim vodama, a u interesu Republike Hrvatske, prilaze realizaciji projekta –AGLOMERACIJA MURSKO SREDIŠĆE (I. ETAPA).
Za projekt izgradnje i rekonstrukcije sustava odvodnje otpadnih voda – aglomeracija
Mursko Središće (I. etapa), na katastarskim česticama u k.o. Mursko Središće, k.o. Peklenica, k.o. Gornji Kraljevec, k.o. Križovec, k.o. Vratišinec, k.o. Selnica i k.o. Zebanec (lokacija - Mursko Središće, Peklenica, Gornji Kraljevec, Vratišinec i dio naselja Selnica), izdana je Lokacijska dozvola, KLASA: UP/I-350-05/16-01/000008,
URBROJ: 2109/1-09-1/01- 16-0008 od dana 04. kolovoza 2016. godine po Upravnom odjelu za prostorno uređenje, gradnju i zaštitu okoliša Međimurske županije, Rješenje o izmjeni i dopuni lokacijske dozvole, KLASA: UP/I-350-05/21-01/000003, URBROJ: 2109/1-09-1/01-21-0007 od dana 12.04.2021. godine po Upravnom odjelu za prostorno uređenje, gradnju i zaštitu okoliša Međimurske županije i Rješenje o II. izmjeni i dopuni lokacijske dozvole, KLASA: UP/I-350-05/22-






Kolarek iz Preloga i Dražen Srpak iz Murskog Središća te Vjeran Vrbanec, direktor iz HAMAG - BICRO, Tomislav Marković, koordinator područnih ureda HBOR-a i voditelj Područnog ureda za Sjeverozapadnu Hrvatsku. Mladen Križaić, predsjednik Županijske gospodarske komore Čakovec na svečanosti dodjele nagrada istaknuo je da je prošla poslovna godina po uspješnosti poslovanja za međimurske poduzetnike bila najbolja u posljednjih deset godina.
01/000012, URBROJ: 2109-09/01-23-0010 od dana 26.10.2023. godine po Upravnom odjelu za prostorno uređenje, gradnju i zaštitu okoliša Međimurske županije.
POZIVAJU SE VLASNICI I OSOBE KOJE IMAJU PRAVNI INTERES da sa MEĐIMURSKIM VODAMA d.o.o. kao korisnikom služnosti (nepotpuno izvlaštenje), zaključe ugovore o osnivanju prava služnosti temeljem procijenjene vrijednosti nekretnina i to kako slijedi:
KATASTARSKA OPĆINA GRAĐEVINSKO ZEMLJIŠTE (EUR/m2)
k.o. Mursko Središće
k.o. Selnica
k.o. Peklenica 9,84 EUR/m2 9,21 EUR/m2 9,84 EUR/m2
KATASTARSKA OPĆINA POLJOPRIVREDNO ZEMLJIŠTE (EUR/m2)
k.o. Mursko Središće k.o. Gornji Kraljevec 1,09 EUR/m2 0,83 EUR/m2
Rok isplate naknade radi ustanovljenja prava služnosti je 8 dana od dana sklapanja ugovora.
POZIVAJU SE VLASNICI I OSOBE KOJE IMAJU PRAVNI INTERES DA PRISTUPE, u roku od 8 dana od dana objave ovog oglasa, U PROSTORIJE MEĐIMURSKIH VODA d.o.o. Čakovec, Ulica Matice hrvatske 10 (5. kat – pravna služba), svakim radnim danom od 7,00 do 15,00 sati ili da se pismeno izjasne na ponudu sporazumnog rješavanja imovinsko-pravnih odnosa (osnivanje prava služnosti).
Za bilo kakva pitanja i informacije, molimo obratiti se na telefon 040/373-719. MEĐIMURSKE VODE d.o.o.
Napad Irana na Izrael najnovijim raketama koje su tek prošle godine uvrštene u arsenal, jasna je poruka Izraelu. Pitanje je što će učiniti Izrael, već je najavljeno da će odgovoriti na napad. Američki predsjednik Biden izjavio je još prije tjedan dana da je rat na Bliskom istoku moguć, ali i zaokret od rata.
Postavlja se klasično pitanje: kome ovaj rat najviše odgovora? Dakako, ekstremistima na Bliskom istoku te Izraelu. Čini se da odgovara i Americi do izvjesne razine konfrontacije i napetosti. Izraelski premijer Netanyahu je ovih dana rekao da je cilj Izraela u napadu na Hezbolah slabljenje vlasti Irana kako bi došlo do promjene režima u toj zemlji, što u najmanju ruku znači da nije „izvan kontrole“, kako su govorili pojedini analitičari.
U pozadini rata događa se mnogo toga izvan očiju javnosti. Cijene nafte su odmah nakon napada Irana porasle i vjerojatno će i dalje rasti. Rast cijena nafte najviše odgovara Americi zbog pritiska na Kinu, koja želi oživjeti svoj građevinski sektor koji je u dubokom ponoru. Porastom cijena nafte to je manje moguće. Međutim, indikativno je da se na tržištima kriptovaluta, koje najbrže reagiraju na političke promjene u svijetu, događa veliki pad nakon napada Irana, a to znači da su mnogi ulagači u kriptovalute računali i na kineski investicijski ciklus. Tako su još prije napada Irana na Izrael ulagači počeli strahovati za svoj novac. U utorak je Bitkoin (BTC) pao za dva posto, na 62.000 do-
Piše: Josip Šimunko josip.simunko@mnovine.hr

lara, a Ethereum (ETH) za 3,5 posto, na 2500 dolara, Solana (SOL) za pet posto, a Polkadot (DOT) za 7 posto. Kriptovalutama očito ne odgovara rat. Naime do sada je uvijek listopad bio sretan za Bitcoin, u zadnjih osam godina prosječno je u listopadu rastao 23 posto, a Ethereum ipak manje, samo 5 posto u prosjeku.
Sad zbog napetosti na Bliskom istoku mlađi kupci kripovaluta, što će reći nezavisniji, zatvaraju svoje pozicije, bez obzira na dobre dobre američke podatke o stanju ekonomije.
Zanimljivo je da je tema tržišta kriptovaluta postala i politički važna na izborima u Americi. Kandidat za predsjednika Donald Trump već je najavio da će, ako bude izabran, ojačati zakone za podršku kriptovalutama i smijeniti odgovorne.
Aktualna potpredsjednica SAD-a i kandidatkinja na izborima Kamala Harris ovih je dana u govoru na Ekonomskom klubu u Pittsburghu rekla da će se SAD „ponovo obvezati“ na globalno vodstvo u sektorima u nastajanju. Ona je izjavila: - Ulagat ćemo u bioproizvodnju i zrakoplovstvo, ostat ćemo dominantni u umjetnoj inteligenciji i kvantnom računarstvu, blockchainu i drugim tehnologijama u nastajanju, te proširiti svoje vodstvo u inovacijama i proizvodnji čiste energije.






SIMON je četvrta generacija pčelara u obitelji Mlinarec iz Preloga




- Imao sam nekoliko svojih košnica kad sam bio mlađi i kad me otac htio pridobiti za pčelarstvo. Sada se aktivno bavim njegovim pčelama, kaže Simon
Piše: Vlasta Vugrinec
Mali šumarak, u preloškom području poznatom pod imenom Vudno, gotovo 100-tinjak godina krije svima znani voljnjak obitelji Mlinarec.
Voljnjak datira još iz vremena prije Drugog svjetskog rata i prema riječima članova obitelji, već je tada imao AŽ košnice i to poprilično za ondašnje prilike.
Teren oko košnica uvijek je bio pažljivo uređen, a ono što se pamti iz toga vremena je i bunar iz kojeg su pili vodu svi tamošnji poljoprivrednici ožednjeli nakon rada u polju. U njihovu medu uživali su rodbina, prijatelji i susjedi dok pak sva djeca iz njihove nekadašnje ulice, danas odrasli ljudi, i dalje rado u sjećanje prizivaju saće prepuno meda koji im se slijevao niz bradu.
I danas voljnjak stoji na istom mjestu. Jedina razlika

je u tome što posao preuzima praunuk Simon, četvrta generacija pčelara u obitelji Mlinarec i što ni jedan član obitelji više ne živi u Prelogu.
Otac me brzo pridobio u svijet pčela
- Aktivno se bavim pčelarstvom iako mi to nije glavna djelatnost, kaže Simon Mlinarec. To je prije svega naša obiteljska tradicija koju nastavljam s puno volje i želje.
Simon, koji inače s obitelji živi u Šenkovcu, ljubav spram pčela naslijedio od svog oca Vitomira i tete Tatjane Šardi, rođene Mlinarec. Vitomira pak je mednim životom zarazio otac Vinko koji je pčelarenje naslijedio od majke Julijane.
Upravo je Julijana, nakon smrti supruga, ostavši s trima sinovima, čvrstom rukom nastavila njegovo djelo i učila djecu poslu.
Simon je kaže, od ranog djetinjstva opčinjen slušao priče i pričice o povijesti pčelarstva u obitelji tim više što se njegov djed Vinko bavio i fotogra�ijom pa je dosta toga ostalo zabilježeno. I ne samo to, dio starih fotogra�ijama nalazi se u voljnjaku kao podsjetnik na stara vremena. Osim toga, voljnjak je idealno mjesto za opuštanje duše i tijela. Gustom šumom zaštićen je od sjevernih vjetrova tako da je ugodno i čovjeku i pčelama. Kroz godine u njemu su se sadile i njegovale razne medonosne biljke. Ipak brojni Priločanci pamte ogromnu trešnju s krupnim plodovima s kojima su se bez problema
Današnji pčelari odlaze u pčelinjake, samo Priločanci u voljnjake. Istina, riječ “voljnjak” upotrebljava se još tu i tamo i u pojedinim mjestima donjeg Međimurja. Tražeći značenje te riječi, pronašli smo dva izvora i dva tumačenja, otprilike ista.
znali častiti. - Pčelarstvo je u obitelji prolazilo kroz nekoliko povijesno važnih faza, ali je uspjelo preživjeti, dodaje Simon. Isto tako, prenosilo se s koljeno na koljeno. Naravno, kaže kako svaka promjena “vlasnika” nije bila jednostavna pa je dolazilo i do pada posla. Naročito, nakon iznenadne smrti djeda Vinka.
Međutim, volja, trud i strpljenje članova obitelji nadvladali su početni šok i pčele su opet nastavile veselo letjeti i puniti košnice medom. Naravno, ne bilo kakvim već onim kvalitetnim o čemu svjedoče i brojne medalje i priznanja s različitih natjecanja.
Otac mu još “čuva” leđa
- Malo literature i još više prakse čovjeka dovede do potrebnog znanja za suživot s pčelama, kaže.
Trenutno nema svoje košnice, već se aktivno bavi očevim pčelama. To mu je lakše i jednostavnije jer je, kaže, otac uvijek tu negdje u pozadini i zna da se može osloniti na njega kad zaškripi ili nastane nekakva krizna situacija.
Voljnjak [vọlj'ọk vọlj'ọka] m uljnjak, pčelinjak, od staroslavenskoga šuplje drvo, deblo, koš ~ (Međimorski tolnačnik)
Voljnjak-pčelinjak u voćnjaku (Razlikovni rječnik Školskog područja Osnovne škole Hodošan).
- Ako nešto zaškripi, saziva se u obitelji krizni sastanak kako bi se problem riješio, sa smiješkom dodaje. Vitomir je naime cijeli svoj radni vijek odradio u Sloveniji, a povremeno radi i danas tako da je veći dio vremena na relaciji Slovenija – Šenkovec. Uz posao, Vito pčelari i u Sloveniji gdje je sklopio brojna poznanstva i prijateljstva. Svoje slovenske prijatelje rado dovodi u Međimurje i za njih organizira cjelodnevne izlete, poput ovih u posljednjim dvama vikendima.
- Imao sam nekoliko svojih košnica kad sam bio mlađi i kad me otac htio pridobiti za pčelarstvo, naglašava Simon. Kaže kako je posao, ustvari više hobi, obiteljska je strast, sve se dijeli i međusobni si pomažu. Međutim, koliko god to bio hobi, ipak je riječ o aktivnosti s kojom se treba aktivno baviti. Dakle, nema kašnjenja s poslovima oko košnica, vrcanja meda, selidbe, liječenju pčela i slično. Treba reći kako i Simon ima svog potomka, no rano je reći je li ona peta generacija pčelara obitelji Mlinarec. Jedno je sigurno, s tatom Simonom. često je u voljnjaku.

I POŽAR do temelja uništili dom 39-godišnjaka koji je teško ozlijeđen
- To je tako grunulo, Isuse Bože, nisam mogla doći k sebi. Ne znaš što bi rekao. To je sve bacalo van. Nemoćan si i Boga prosiš da neće dalje, ispričala nam je majka ozlijeđenog 39-godišnjaka
Piše: Sanja Heric
Gornji kat objekta koji je bio preuređen u stan u potpunosti je uništen nakon eksplozije i požara koji se dogodio u nedjelju, 29. rujna, nešto prije 16 sati u Dunjkovcu, u dvorištu obiteljske kuće u Ulici Ljudevita Gaja, odmah u neposrednoj blizini Vatrogasnog doma Dunjkovec. U trenutku eksplozije u spomenutom stambenom prostoru nalazio se 39-godišnjak te je pritom zadobio teške ozljede. Vozilom hitne prevezen je u čakovečku bolnicu, gdje je zadržan na liječenju na intenzivnoj. Eksplozija pa požar - Mislila sam u prvi mah da se dogodila nekakva nesreća. Poluknula sam van, i vidjela kako pada staklena vuna od gore. Onda sam pomislila, pa to je sigurno kod nas. Došla sam van i imala sam što vidjeti. Prvo mi je trebala minuta, dvije, tri da sam došla k sebi. Onda sam se pokrenula, i zvala službe, ispričala nam je majka 39-godišnjaka, koja se u tom trenu nalazila u kući pored objekta. Vatrogasci su vrlo brzo stigli na mjesto eksplozije i požara. Osim JVP-a Čakovec, u gašenje su se uključili i dragovoljci iz DVD-a
Nedelišće, Dunjkovec i Pretetinec. U požaru je u potpunosti izgorjelo krovište i unutrašnjost stambenog prostora, dok su na zgradi DVD-a Dunjkovec uslijed siline eksplozije popucala stakla na prozorima te su neki od prozora izbačeni iz ležišta.
- To je tako grunulo, Isuse Bože, nisam mogla doći k sebi. Ne znaš što bi rekao. To je sve bacalo van. Nemoćan si i Boga prosiš da neće dalje. Samo dragi Bog, sreća v nesreći, kaj gore nije bilo deke i da to nije udarilo i u ovu našu kuću pored, ispričala nam je tužno majka dan nakon ove nesreće.
Njezin suprug i otac ozlijeđenog 39-godišnjaka u trenutku kada smo posjetili mjesto događaja čistio je zajedno sa svojim bratom ono što se dalo. Uz garažu su skupili i komadiće crijepova koji su posvuda bili razasuti.
- Ne znam zašto su neki mediji pisali da se zapalila plinska boca. To uopće nije točno, unutra plinske boce nije ni bilo, rekao nam je otac 39-godišnjaka i nastavio dalje.
- Valjda se nakupio plin. Samo mala koncentracija plina je dovoljna za eksploziju. Unutra kondenzacijski bojler je, najnoviji, to nije u kvaru, a sin si je valjda





U LOPATINCU cvjetao ilegalni posao Kućni laboratorij droge pronađen kod 33-godišnjaka
U lovu na drogu, policija je upala u pravu riznicu u Lopatincu. Sve se odigralo protekle nedjelje, kada su u kući 33-godišnjaka naišli na pravu "farmu" droge. Osim većih količina marihuane u različitim oblicima, pronađeni su i hašiš, amfetamin, MDMA i LSD, kao i oprema za pakiranje i uzgoj droge.
cigaretu upalio, ispričao nam je otac.
Što je dovelo do eksplozije?
Očevidom na mjestu događaja, uz stručnu pomoć inspektorice za zaštitu od požara i eksploziva, utvrđeno je kako je uzrok eksplozije i požara, poduzeta ljudska radnja, konkretno skidanje brtvenog ventila na plinskoj cijevi u kuhinji, izvijestili su nakon svega iz PU međimurske.
O događaju će se izvijestiti nadležno državno odvjetništvo, dok se kriminalistička istraživanja nastavljaju kako bi se utvrdile sve relevantne okolnosti ovog događaja.

Crijep je popadao svuda oko objekta na čijem se prvom katu nalazio stan, a u prizemlju su smještene garaže
A sve se odigralo ovako. Na temelju naloga Županijskog suda u Varaždinu policajci iz Službe kriminalističke policije PU međimurske pretražili su dvorište i prostorije obiteljske kuće kojima se koristi 33-godišnjak. No, najveće iznenađenje bilo je to što je osumnjičenik, bez ikakvog otpora, dragovoljno predao svoju "robu". Riječ je o 36 svježih biljaka marihuane, gotovo 2,5 kilograma osušenih cvjetova marihuane, 7 grama hašiša te brojnim PVC vrećicama napunjenim marihuanom, ukupne te-
žine preko 4,8 kilograma. Osim toga, u posebno pripremljenom prostoru pronađeno je i sedam većih biljaka marihuane visokih preko metra, koje su bile u fazi intenzivnog rasta. Ali ni to nije sve. Bilo je tu i PVC vrećica ispunjenih drogom amfetamin, ukupne mase osam grama, osam tableta droge MDMA te aluminijski smotuljak ispunjen s četirima komada papirnatih listića droge LSD.
Osumnjičenik, očito spreman na sve, imao je i digitalnu vagu za precizno mjerenje i uređaj za vakumiranje te digitalni mjerač vlage i temperature.
Protiv 33-godišnjaka zbog sumnje u počinjenje kaznenog djela neovlaštene proizvodnje i prometa drogama, podnijet će se kaznena prijava nadležnom državnom odvjetništvu. (sh)
Zbog neprilagođene brzine i nepažnje, dva maloljetnika bez vozačke dozvole sudarila su se u petak, 27. rujna oko 13:40, u Selnici u Ulici Zrinskih. Prvi maloljetnik je, krećući se Ulicom Zrinskih, prilikom dolaska na raskrižje s prilaznom cestom, zbog neprilagođene brzine i nepažnje izgubio kontro-
lu nad motociklom. U namjeri da skrene ulijevo, udario je u bočni dio drugog motocikla kojim je upravljao drugi maloljetnik koji je također skretao ulijevo. Nakon sudara, oba motocikla su se odbila, a drugi motocikl je završio u dvorišnoj ogradi. Svi sudionici nesreće prošli su bez ozljeda. (sh)
U utorak, 1. listopada, u prijepodnevnim satima u Nedelišću, u Čakovečkoj ulici, nepoznati počinitelj kroz otvorena balkonska vrata ušao je u obiteljsku kuću, odakle je ukrao novac. Materijalnu
štetu 69-godišnja vlasnica procijenila je na više tisuća eura. Protiv počinitelja zbog počinjenja kaznenog djela krađe, podnijet će se kaznena prijava nadležnom državnom odvjetništvu. (sh)
Iz nezaključane kuće drpio nakit
Između 1. i 29. rujna u Vukanovcu, nepoznati počinitelj ušao je u nezaključanu kuću te je potom iz raznih prostorija ukrao nakit.
Materijalnu štetu 78-godišnji vlasnik procijenio je na
nekoliko stotina eura. Protiv počinitelja zbog počinjenja kaznenog djela krađe, podnijet će se kaznena prijava nadležnom državnom odvjetništvu. (sh)
DODJELA novčanih potpora studentima
Grad Čakovec priprema raspisivanje natječaja za dodjelu novčanih potpora za tekuću akademsku godinu redovnim studentima na preddiplomskim, integriranim i diplomskim studijima. Natječaj se otvara 14. listopada 2024. godine i traje do 29. listopada 2024. godine, a bit će objavljen na službenim internetskim stranicama Grada Čakovca. Studenti koji imaju potpisane ugovore ne javljaju se. Studentima koji ostvare pravo na natječaju za dodjelu novčane potpore isplata započinje od siječnja 2025. godine. A ona za studij u Čakovcu 65 eura, u Varaždinu 80 eura, za Zagreb i ostale gradove u Hrvatskoj 150 eura, koliko iznosi i za studij u inozemstvu.
Natječaj se temelji na trima kriterijima. Tako stipendiju, odnosno bespovratnu novčanu potporu, dobivaju studenti de�icitarnih zanimanja na području Grada Čakovca i Međimurske županije.
Prije svega to su sveučilišni studiji: elektrotehnika ili elektrotehnika i informacijska tehnologija, farmacija, �izika-nastavnički smjer, građevinarstvo, logopedija, matematika-nastavnički smjer, medicina, psihologija, računarstvo, rehabilitacija, rani predškolski odgoj i obrazovanje, strojarstvo, socijalni rad, socijalna pedagogija, učiteljski studij, stručne studije: radna terapija, strojarstvo i sestrinstvo.
Beskamatnu novčanu potporu dobivaju studenti na svim ostalim studijima u zemlji i inozemstvu koji zadovoljavaju formalne kriterije za dodjelu potpore. I u treću kategoriju spadaju studenti koji će dobivati zajedničku stipendiju s trgovačkim društvima i visokoškolskim ustanovama. Drugim riječima to su studenti koji imaju osigurane stipendije vezane uz rad trgovačkih društava ili visokoškolskih ustanova, a koje jamče njihovo zapošljavanje. (vv)
AKADEMSKA godina na Međimurskom veleučilištu
Na prvi dan nove akademske godine u klupe Međimurskog veleučilišta u Čakovcu sjela je nova generacija MEV-ovaca, njih nešto više od 100. Na uvodnom satu, održanom u velikoj dvorani Centra održivog razvoja, sve studente prvih godina prijediplomskih studija pozdravili su dekan izv. prof. dr. sc. Igor Klopotan, prodekanica za nastavu i studentska pitanja Magdalena Zeko, v. pred., te pročelnici odjela Veleučilišta. Novoj generaciji studenata predstavili su se i pojedini profesori koji su ih upoznali s kolegijima koje će slušati na ovom Veleučilištu, a ujedno su im predstavili i Centar održivog razvoja gdje su smješteni kabineti i laboratoriji koje će koristiti u praktičnoj nastavi. Osim toga, studentima Međimurskog veleučilišta u istom su dvorištu dostupni gotovo svi sadržaji potrebni za cjelodnevni boravak – tu su studentski dom, knjižnica, pa čak i teretana, te je po tom pitanju Međimursko veleučilište jedna od rijetkih visokoškolskih ustanova u Hrvatskoj. Kako je tom prilikom istaknuo dekan Igor Klopotan, s ovim je danom nova generacija studenata zakoračila u novo životno



Brucošima je dobrodošlicu zaželio Igor Klopotan, dekan Međimurskog veleučilišta
poglavlje te im je pritom poželio srdačnu dobrodošlicu.
– Svim studentima, a posebno onima koji su danas prvi puta sjeli u studentske klupe, želimo dobrodošlicu na Međimursko veleučilište u Čakovcu. Drago mi je da su za nastavak svog obrazovnog puta odabrali upravo MEV. Želim naglasiti da ćemo i nadalje intenzivno raditi na stvaranju što boljih i kvalitetnijih uvjeta za rad i učenje te nam je cilj, kao i dosad, pružiti našim studentima nova teorijska i praktična znanja i pripremiti ih za realne potrebe na tržištu rada. – naglasio je dekan Klopotan te svim studentima poželio uspješan početak nove akademske godine. (vv)

DOĐITE U PETAK na Sajam sigurnosti i prevencije 2024.
Posjetitelji će moći testirati kako je to prevrnuti se u automobilu ili se zaletjeti s vezanim pojasom, saznati o dresuri pasa, sigurnosti na internetu i još mnogo toga...
I ove godine, povodom obilježavanja Dana policije, međimurska policija poziva sve građane, a naročito mlađe, da posjete u petak 4. listopada Sajam sigurnosti i prevencije na kojem će biti prikazano obilje tehnika i tehnologije.
Detalje nam je otkrio Danijel Mikulić, zamjenik načelnika Policijske uprave međimurske te idejni začetnik ovog jedinstvenog sajma u Hrvatskoj, koji se održava jubilarni, deveti put po redu. Trebao bi biti deseti po redu, jer je prvi put održan 2014. godine, ali je jedne godine održavanje bilo preskočeno zbog korone.
- Ako nas vrijeme posluži, sajam će se održati na području SRC-a Čakovec te Učeničkom domu i Dvorani Graditeljske škole od 10 do 16 sati, u slučaju kiše vanjski dio se seli u dvoranu GŠ-a. No, prije toga će se, s početkom u 10 sati, održati misa u čakovečkoj crkvi sv. Nikole
Biskupa koju će predvoditi vojni ordinarij msgr. Jure Bogdan. A zatim slijedi otvaranje Sajma i obilježavanje Dana policije uz svečanu akademiju s početkom u 11:30 u velikoj dvorani Srednje škole Čakovec. Raduje nas što nam kao gosti dolaze delegacije mađarske i slovenske policije, a iz Ravnateljstava policije očekuje se ravnatelj Nikola Milina i drugi visoki gosti, najavljuje Mikulić.
- Moram naglasiti zahvalnost Vijeću za prevenciju Međimurske županije i Vijeću za prevenciju grada Čakovca na podršci i suradnji u organizaciji sajma, kao i ostalim partnerima u provedbi iz Policijske uprave osječko-baranjske, zagrebačke, koprivničko-križevačke i varaždinske te naše odgojno-obrazovne ustanove, institucije te organizacije i udruge iz naše županije i šire.
O bogatom sadržaju ovogodišnjeg sajma Mikulić ne krije zadovoljstvo. No na naše zanimanje o tome što
OBILJEŽEN Dan starijih osoba u čakovečkom Domu za starije i nemoćne
Jesen života treba samo malo ljudske topline
Pod motom “Dostojanstveno starenje: važnost jačanja sustava skrbi i podrške za starije osobe diljem svijeta“ i u čakovečkom Domu za starije i nemoćne obilježen je Međunarodni dan starijih osoba.
Točnije, taj se Dan nizom aktivnosti obilježavao gotovo cijeli tjedan s time da je središnja proslava ipak bila 1. listopada kada se taj dan obilježava na međunarodnoj razini.
Štićenike Doma tog su dana posjetili učenici čakovečke Srednje škole koji se obrazuju za zvanje medicinske sestre, odnosno tehničara. Učenici su im najprije mjerili tlak i šećer
u krvi, a potom je uslijedio prigodni program u kojem je, između ostaloga, nastupila glazbena sekcije Škole. Koliko malo je toga potrebno ljudima u jeseni života svjedočila je živost koja se pojavila u njihovim očima uz prve taktove popularnih međimurskih pjesama. Cupkanje nogama te prstima bio pak je znak da su školarci pogodili “žicu”.
Biranim riječima, svima se zahvalila jedna od štićenica, umirovljena učiteljica Agneza Šipoš koja je u svoje riječi utkala i opis života čovjeka kojemu je trenutno najveći autoritet obiteljski liječnik. (vv)




se isplati vidjeti, nije mu lako izdvojiti.
- Doista ne bih htio zakinuti nekog od organizatora vrijednih aktivnosti, a to je ovdje teško. Bit će puno informativnih punktova za djecu – od toga kako je biti policajac, sigurnosti djece na internetu, Centra za obuku vodiča i dresuru službenih pasa, prevenciji nasilja, toleranciji, predškolcima u cestovnom prometu… Auto klub Čakovec dovest će simulator prevrtanja, Centar za vozila Hrvatske prezentirat će Mobilnu stanicu za tehnički pregled vozila, bit će postavljeni poligon za djecu za vježbanje sigurnosti na cestama… Bit će tu još i edukativnih predavanja te
predstava za djecu, prezentacija udruga… Od 13 sati nadalje bit će nekoliko pokaznih vježbi koje će vjerojatno zanimati širu publiku. Interventna jedinica PU međimurske pokazat će elemente borilačkih vještina te rukovanja dugim i kratkim oružjem kao i potjeru službenim vozilom za naoružanim počiniteljima, psi iz Centra za obuku pasa Policijske akademije detektirat će oružje, zapaljive tekućine, drogu, vježbe legitimiranja s napadom; Civilna zaštita pokazat će vježbu evakuacije i zbrinjavanje učenika i zaposlenika GOC-a, a kulminacija će biti spuštanje, dizanje i prelet helikoptera Antiterorističke jedinice Lučko. (tn, foto: jt)





JESEN u Maloj Subotici u znaku kolača s jabukom



Domaći sirevi, medovi, pekmezi, rakije i medice pa langoši i obilje kolači, označili su Jesenski sajam u Maloj Subotici koji je održan minulog vikenda.
Kao i uvijek do sada, središnji se trg ispred Doma kulture orio dječjim smijehom, razgovorom i pjesmom dok se sa svih strana širio miris domaćih, friško pripremljenih kolača. Istina, tu i tamo, njihov miris u drugi su plan bacili mirisi tek pečenih langoša.
Natjecanje u pripremi kolača od jabuke
Ovogodišnji Jesenski sajam nije nudio samo dječje igre i domaće proizvode, već je po prvi put organizirano i natjecanje u pripremi najboljeg kolača od jabuke.


Martina Bedić s nagradom za najbolji kolač od jabuke










Recept za svoj kolač pronašla je na internetu i dodala mu tajne sastojke. Pojednostavljeno rečeno, riječ je o svojevrsnoj piti s jabukama obogaćenoj s kremom od vanilije










sami autori krasnoslovili na priredbi.




- Bilo nas je malo strah kako će sve to skupa izgledati, naglasila je Jadranka Sermek, predsjednica ocjenjivačke komisije. Moram priznati da smo ugodno iznenađeni jer je pristiglo čak 16 kolača na ocjenjivanje. Bilo je tu svega, od torti, pogača, pita, do biskvita s kremom. Drugim riječima, udruge su se svojski potrudile i prezentirale kolače dostojne natjecanja. Tročlani žiri, uz Jadranku, Milan Zadravec i Elena Hajdarović imali su dosta težak i zahtjevan zadatak. Trebalo je sve te slastice probati i odlučiti koja je najbolja. Da je bilo teško, svjedoči i podatak da su dva kolača na kraju imala podjednaki broj bodova. - Onda smo odlučili da je okus jabuke kao glavni kriterij, bio jače naglašen u kolaču






Minulog vikenda u Zlataru, u tamošnjoj OŠ Ante Kovačić, održani su Dani kajkavske riječi. Riječ je o manifestaciji na kojoj redovno sudjeluju i učenici međimurskih osnovnih škola. Jedna od njih je i Osnovna škola Tomaša Goričanca iz Male Subotice.



Martine Bedić i time je on proglašen pobjedničkim, istakla je predsjednica komisije.



Međutim, kako to biva, pobjeda, odnosno poraz, ako se to tako može nazvati jer su svi sudionici dobili priznanje, nije svima dobro sjela. Naime, Martina Bedić dolazi iz Puhačkog orkestra







Tako je na Zboru malih pjesnika svoju pjesmu krasnoslovio autor Igor Puklek, 5. a razred. Za nastup ga je pripremila mentorica Ljiljana Rinkovec.
Na natječaj je stiglo 290 pjesama iz 48 škola, a odabrano je 60 pjesama koje su
Učenici malosubotičke škole sudjelovali su i na likovnoj izložbi „Čovjek čovjeku“. Izloženi su bili radovi Dore Medvedec (2.a), Nika Križaića (2.a), Istoka Jekića (2.a) (voditeljica: Slavica Švec), Arie Smojver (2.b) (voditeljica: Jasminka Drabić), Mie Sečan (4.b) (voditeljica: Nada Črep), Mare Strnad (5.a), Noela Lukačića (5.a) (voditeljica: Ljiljana Rinkovec). Posebno je istaknut i nagrađen likovni rad Mije Sečan (4.b). (vv)
daje studentske stipendije
Male Subotice pa su odmah krenule priče o “sukobu interesa”. O kakvom sukobu interesa je riječ, nije se čulo objašnjenje jer koliko su


Puhači općinski toliko su i sve ostale udruge.
Pobjeda rezervne kuharice


Članovi ocjenjivačke komisije: Elena Hajdarović, Milan Zadravec i Jadranka Sermek
ŠTO STOJI iza nagle promjene na čelu Općine Šenkovec?

Diplomirani pravnik Tomica Vranović, koji je u studenom prošle godine preuzeo dužnost pročelnika Općine Šenkovec, napustio je svoju poziciju nakon manje od godinu dana, kako saznajemo. Podsjetimo, u Općinu Šenkovec došao je 13. studenog prošle godine umjesto Nine Hrena. - Istina je pročelnik je
otišao. Riječ je o sporazumnom raskidu ugovora o radu. Pročelnik je radio do 30. rujna, odgovorio nam je na naš upit kratko tamošnji načelnik Robert Meglić. Odmah sljedećeg dana, u utorak 1. listopada, načelnik Meglić raspisao je javni natječaj za imenovanje novog pročelnika Jedinstvenog upravnog odjela na neodre-


- Presretna sam, rekla je Martina Bedić koja je dobila nagradu za najbolji kolač. Tim više što je “glavna kuharica” odustala pa sam ja uskočila kao rezerva.
Recept za svoj pobjednički kolač pronašla je na internetu i malo ga je modi�icirala s tajnim sastojcima. Pojednostavljeno rečeno, riječ je o svojevrsnoj piti s jabukama obogaćenoj kremom od vanilije. Speci�ičnost kolača je u tome što kore nisu bile izvaljane već naribane.
S obzirom na ovogodišnji odaziv sigurno je da će se natjecanje organizirati i iduće godine s time da se razmišlja i o biranju najdeblje, odnosno najteže jabuke.
Općina Pribislavec raspisala je natječaj za dodjelu studentskih stipendija redovnim studentima sa svog područja za akademsku godinu 2024./2025. godinu. Mjesečni iznosi variraju, ovisno o mjestu studiranja. Tako za studij u Čakovcu iznosi 50 eura, za Varaždin 65, Zagreb 80 eura dok je iznos za ostale gradove i inozemstvo 95 eura. Mladima će se stipendije isplaćivati za vrijeme trajanja statusa redovnog studenta i to za 10 mjeseci u akademskoj godini. Studenti koji već primaju stipendiju Općine Pribislavec trebaju samo u Općinu poslati potvrdu o upisu akademske godine. (vv)
VRTIĆ Orehovica dobio još milijun eura Novi vrtić zvat će se Reheki
đeno vrijeme uz probni rad od tri mjeseca. Zbog ove situacije je najvjerojatnije bila i odgođena sjednica Općinskog vijeća Šenkovec koja je morala biti održana 26. rujna. Bit će zanimljivo vidjeti rasplet situacije s obzirom na posljednja delikatna događanja u Općini i na samom Općinskom vijeću. (sh)
Izgradnja novog objekta dječjeg vrtića koji je smješten uz zgradu Osnovne škole Orehovica trenutno je u tom naselju najveći i najpriželjkivaniji projekt. Naime, u toj Općini vrtić ne postoji, već djeca idu u jaslice i vrtiće na području čitave Županije. No, treba još samo malo strpljenja jer bi upisi u novi vrtić, ako će sve ići planiranim tempom, mogli biti u svibnju iduće godine. Naime, država je putem Ministarstva znanosti, obrazovanja i mladih, osigurala više od milijun eura dodatnih sredstava za izgradnju dječjeg vrtića. Tako će udio države, uz korištenje novca iz europskih fondova, iznositi 2 milijuna eura. - Time je značajno smanjeno opterećenje općinskog proračuna iz kojeg će sada izdvojiti tristotinjak tisuća


eura, poručuje načelnica Općine Dijana Čurin. Zna se kako će vrtić nositi ime, a kako drukčije nego Reheki. U prvo će vrijeme načelnica Čurin obavljati dužnost privremene ravnateljice dok se ne uredi sva potrebna papirologija oko osnivanja vrtića, a potom će se raspisati i natječaj za ravnatelja/cu. (vv)






KONCERT

u CZK-u Rudar
Izlio je svoju narodnu filozofiju u pjesmu na radost publike
Zoran Predin, poznati slovenski kantautor i nekadašnji frontman grupe Lačni Franz, ispunio je očekivanja svojih fanova na koncertu u Centru za kulturu Rudar u Murskom Središću. Izuzetno je šaljiv, pri čemu ne štedi ni sebe, što je odlika ljudi vrhunske duhovitosti. Zoran Predin je i izniman pjesnik u čiju je glazbu utkana pro�injena satira u stihovima. Svoje pjesme on skromno zove narodnom �ilozo�ijom, ali dubina njegova stiha i misli čini ga dugovječnim i prvorazrednim kantautorom ovih prostora.
Zoran Predin, kantautor s gitarom, pjevao je i svirao uz glazbeno pojačanje Igo-
ra Polaka na gitari. Izveo je pjesme iz različitih faza svoje karijere, uključujući hitove iz doba Lačnog Franza, kao i solo projekte, ali i hitove Arsena Dedića, Gorana Bregovića i Leonarda Cohena. Publika je posebno uživala u klasicima poput Praslovan, Ne mi dihat za ovratnik te novim pjesmama koje su pokazale njegovu umjetničku evoluciju. Posebno zanimljiv dio koncerta su Predinove interakcije s publikom, pri čemu se prostor Centra za kulturu Rudar pokazao optimalnim prostorom za tu razmjenu emocija i interakcije Zorana Predina s publikom. (BMO)
VJEŽBA EVAKUACIJE i spašavanja na skeli Fusek po drugi put se premješta na drugi termin Što ako na skeli pukne
čelična sajla?
Operativne snage sustava civilne zaštite u Murskom
Središću u subotu, 12. listopada, vježbat će spašavanje ljudi sa skele Fusek. Vježba se će odigrati prema sljedećem scenariju: - U 10 sati dolazi do zaustavljanja skele na rijeci Muri na lokaciji “Fusek“ zbog puknuća čeličnog užeta. Skelar o tom događaju obavještava Službu civilne zaštite Čakovec – Centar 112 i zaustavlja skelu bacanjem sidra u rijeku Muru. Centar 112 uzbunjuje operativne snage sustava civilne zaštite i žurne službe. Na „skeli Fusek“ se u trenutku zaustavljanja na rijeci Muri nalazi nekoliko osoba. Prilikom puknuća čeličnog užeta dolazi do ozljede glave jedne osobe.
Na lokaciju “Fusek“ dolaze djelatnici Ministarstva unutarnjih poslova – Policijska postaja Mursko Središće, Vatrogasci DVD-a Mursko Središće koji skelu osiguravaju čeličnim užetom, vatrogasci Javne vatrogasne postrojbe Čakovec, Hrvatska gorska služba spašavanja stanica Čakovec, Zavod za hitnu medicinu – Ispostava Mursko Središće i Gradsko
društvo crvenog križa Čakovec.
Pripadnici HGSS-a –Stanica Čakovec uz pomoć vatrogasaca DVD-a Mursko Središće vrše evakuaciju osoba, ronioci Javne vatrogasne postrojbe Čakovec osiguravaju evakuaciju.
Prilikom evakuacije dolazi do pada jedne osobe u vodu te je ronioci JVP-a Čakovec izvlače i dopremaju do desne obale rijeke Mure i predaju djelatnicima Hitne – Ispostava Mursko Središće. Medicinsku trijažu evakuiranih osobe vrše djelatnici Zavoda za hitnu medicinu Međimurske županije – ispostava Mursko Središće. Lakše ozlijeđene zbrinjavaju pripadnici Gradskog društva Crvenog križa Čakovec, a teže ozlijeđenu osobu vozilo Hitne odvozi na zbrinjavanje u bolnicu u Čakovec. Pripadnici vatrogasne postrojbe dovlače skelu čeličnim užetom (vitlom) do desne obale Mure na “pristanište“ skele na lokaciji „ “Fusek“. Vježbu mogu promatrati i građani kako bi se uvjerili u operativne sposobnosti snaga civilne zaštite. (BMO)
OPĆINA VRATIŠINEC u velikoj pripremi za početak rada svojeg vrtića

Izgradnja novog dječjeg vrtića u Vratišincu je dovršena. Montirana je kuhinja i namještaj u vrtiću. Samo je još potrebno namjestiti sitni inventar. - Ovaj tjedan obavljen je tehnički pregled i do kraja tjedna očekujemo izdavanje uporabne dozvole, kazao je načelnik Mihael Grbavec. Dodao je da je obavljen i sanitarni pregled prostorija vrtića. No osim toga u tijeku je i dio priprema usmjerenih


Vr�ć je izgrađen od kontejnerskih modula
na osiguranje zaposlenika u vrtiću.
Na javnom natječaju za ravnateljicu vrtića izabrana je Barbara Horvat, koja ima 15 godina iskustva u radu s djecom. Na mjestu ravnateljice počela je raditi 21. rujna. Prije toga radila je u vrtiću u Podturnu, a rodom je iz Vratišinca, premda u njemu ne živi. Od ostalog osoblja zaposlili smo kuharicu, spremačicu i zdravstvenog voditelja, višu



medicinsku sestru, budući da će Dječji vrtić Srčeko imati i jasličku skupinu, pojasnio je načelnik Grbavec.
- Ono što je problem je zapošljavanje odgojiteljica. Njih nedostaje na tržištu i na prvi natječaj nismo dobili ni jednu pravovaljanu prijavu, jer se za rad javljaju nestručne osobe, naglasio je načelnik. Dodaje: - Nadamo se da ćemo na novom natječaju koji se zatvara krajem ovog tjedna dobiti barem jednu stručnu osobu. Za početak ravnateljica može uz nju na određeno vrijeme zaposliti i nestručne osobe, koje nemaju završni studij predškolskog odgoja.
Naglašava: - S radom vrtića počet ćemo svakako od 1. studenog. U tom smislu smo donijeli i odluku da od toga datuma nećemo više financirati boravak djece u drugim


predškolskim ustanovama, jer imamo dovoljno mjesta za djecu jasličke i vrtićke dobi s našeg područja u svom vrtiću. Ekonomska cijena 10-satnog boravka za dijete u vrtiću stoji 330 eura, a u jaslicama 390 eura. Pri tome općina sufinancira boravak djece u vrtiću sa 65 posto. Drugo dijete općina sufinancira s dodatnih 10 posto, a za treće dijete s područja općine vrtić ili jaslice su besplatni. Službeno otvorenje Dječjeg vrtića planiraju sredinom listopada, a početak rada vrtića ovisi i o pronalaženju odgojiteljica od milja zvanih teta, koje će preuzeti brigu o djeci u vrtiću. (BMO)
SPOMEN DOM rudarstva Cimper i Međimurski ugljenokopi tema na najvećem nacionalnom kongresu povjesničara
Piše: Božena Malekoci-Oletić
Zoran Turk, povjesničar i ravnatelj Centra za kulturu Rudar te jedan od autora monografije Črni i beli rudari i postava Spomen-doma rudarstva vinuo je rudarsku povijest grada Mursko Središće na nacionalnu razinu. Dogodilo se to u Osijeku na 7. Kongresu hrvatskih povjesničara, koji je bio najveći nacionalni skup povjesničara. - Tema ovog kongresa bila je zemlja, pa se problematika ugljenokopa uklopila u to, kazao Zoran Turk, premda je moje područje interesa srednji vijek, dodao je. Na izlaganje o rudarskoj povijesti našeg kraja potaknuo me profesor s fakulteta.
Nastavlja: - Spomen-park rudarstva može se sagledati s više dimenzija: znanstvene, kulturne i turističke, a ja želim povezati sve tri u jednu cjelinu. Na nacionalnom kongresu su bili profesori sa svih sveučilišta u Hrvatskoj, a ja sam tamo izlagao o međimurskim ugljenokopima iz znanstvenog aspekta, ali to za sobom povlači ova druga dva. Samim izlaganjem tema međimurske rudarske povijesti probila se na nacionalnu razinu. Neki od profesora povijesti već su posjetili i razgledali Spomen-dom rudarstva i svidio im se. Zbog toga se nadam se da će do-





voditi i svoje studente, jer se kroz interaktivni muzej najlakše stvore slike određenog povijesnog razdoblja. Time se dobije turistički aspekt i ujedno zatvori cijeli krug – od znanstvenog preko kulturnog do turističkog aspekta u jednu cjelinu.
Srećom, i osobno sam uključen u sve tri uloge: znanstvenu, kulturnu i turističku, pa to povezujem kao povjesničar, ravnatelj Centra za kulturu pod čijom ingerencijom je i Spomen-dom rudarstva i direktor sam Turističke zajednice područja. Tim ulogama nastojim zaokružiti znanstvenu,
kulturnu i turističku dimenziju Spomen-doma rudarstva i rudarske povijesti ovog kraja. Na nacionalnom kongresu održao sam predavanje “Aspekti sukoba unutar radničkog kolektiva Međimurskih ugljenokopa šezdesetih godina 20. stoljeća“. Time je tematika vezana uz Međimurske ugljenokope i kompleksne odnose unutar poduzeća, kako kod velikih nesreća, tako i malverzacija i zlouporabe bolovanja, stigla na nacionalnu znanstvenu pozornicu. Upozorio sam da odgovori na neka pitanja nisu dani ni nakon šest desetljeća, a
istraživanje svakako otežava činjenica da je većina arhiva Međimurskih ugljenokopa uništena, naglasio je. Uz znanstveni aspekt razvija se i onaj turistički, naglasio je Zoran Turk, pa je tako u završnoj fazi i uvođenje virtualne stvarnosti u postav Cimpera, čime će posjetitelji i sami moći doživjeti nesreću koja se dogodila u noći s 8. na 9. studenoga 1961. godine. Otvaranje tog segmenta postava posjetitelji bi mogli doživjeti već na sljedećoj Noći muzeja, posljednjeg petka u siječnju 2025. godine, otkrio nam je novu atrakciju za posjetitelje.






OPĆINSKO VIJEĆE Štrigova






VRATIŠINEC DOBIO
dodatna sredstva za vrtić Lakše se diše uz 626.637 eura iz državnog proračuna
Vijećnik Antun Zadravec komentirao je izgradnju vodovodne mreže

Novoizgrađeni Dječji vrtić Srčeko koštao je Vratišinec oko 1,6 milijuna eura, od čega su na početku gradnje dobili nešto više od 600.000 eura iz Nacionalnog programa za otpornost i oporavak, a ostatak su morali osigurati sami.
a mi nek širimo vodovodnu mrežu?


Piše: Sanja
Najvažnija vijest o kojoj je vijećnike izvijestio načelnik Stanislav Rebernik na posljednjoj održanoj sjednici bio je početak izgradnje kanalizacije za koju je građevinska dozvola dobivena još 2017. godine. Kako je naglasio, svi radovi trebali bi završiti do kraja 2025. godine.
Kanalizacija u ostatku općine?
- Bio sam na sastanku s izvođačem radova u Tegri. U studenom bi se trebala priključiti još jedna ekipa.

Situaciju je u zadnji čas olakšala odluka Ministarstva obrazovanja kojom je Općini Vratišinec odobreno dodatnih 626.637,47 eura za vrtić.
Vijećnici su izrazili zabrinutost zbog visokih troškova proširenja vodovodne mreže te ukazali na problem dotrajalih cijevi u naseljima





Jedna od opcija prije tog odobrenja bilo je i kreditno
zaduženje od milijun eura za što su zatražili suglasnost Ministarstva �inancija. Kako su uspjeli ishoditi dodatna bespovratna sredstva iz Ministarstva obrazovanja, preostao im je iznos od oko 400.000 eura koji će morati izdvojiti iz svojeg proračuna za vrtić. Odobri li im Ministarstvo �inancija kreditno zaduženje , koristit će ga za zatvaranje �inancijske konstrukcije vrtića i za druge projekte koji su na čekanju. (BMO)
Rebernik jest da INA na području općine provodi seizmička mjerenja. Trenutno se provode istražne mjere vezane uz pitanje dodatnog kapaciteta nafte i plina. - Govori se i o vodi koja bi se mogla iskoristiti. U dogovoru s vlasnicima parcela na kojima se vrše mjerenja, obavijestio je štrigovski načelnik. Problemi po vodovodnoj mreži
ju u �inanciranju produženja vodovodne mreže, s čime su se svi na vijeću složili s obzirom na to da je to njihova infrastruktura.











koji način doći do novaca za kanalizaciju u Jalšovcu, naglasio je načelnik Stanislav Rebernik, dodajući da je u tijeku izrada projektne dokumentacije za izgradnju kanalizacije za dijelove općine koji imaju prirodni pad. Riječ je o naseljima Ban�i, Leskovec i dio Železne Gore. U ostalim dijelovima općine, koji nisu trenutno obuhvaćeni kanalizacijskom mrežom, izrađivat će se zasebni kanalizacijski sistemi. Kada će i ostali dijelovi općine dobiti svoj komadić ovog infrastrukturnog kolača? To je pitanje na koje nitko ne zna točan odgovor, a svaka prognoza je samo nagađanje. Naime, treba imati na umu da su ovakvi projekti dugotrajni i zahtijevaju puno planiranja i ulaganja. Druga važna stvar koju je vijećnicima napomenuo






U nastavku je ukazao i na problem sa širenjem vodovodne mreže naglašavajući kako su to izuzetno veliki troškovi za jednu općinu. Primjerice, 350 metara košta ih oko 60.000 eura. Trenutno na općini imaju tri zahtjeva za proširenje vodovodne mreže. Naknadno je vijećnik Damir Kovačić upitao zašto Međimurske vode na participira-
U raspravu na tu temu uključio se i vijećnik Antun Zadravec. - Međimurske vode kasiraju, a mi nek plaćamo proširenje vodovodne mreže?, upitao je vijećnik, dodavši u nastavku da nije logično da općina mora plaćati proširenje njihove mreže. Uz to dodao je da već godinama upozoravaju na dotrajale cijevi u Orehovčaku i Robadju, ali one još uvijek nisu zamijenje. Naime, u tim naseljima svako malo pukne cijev pa ju popravljaju i tako u krug. Svjetski centar pušipela i uređenje centra Štrigove
Općina Sveti Juraj na Bregu donijela je odluku o isplati jednokratne novčane potpore za sve mlade koji su završili srednju školu i upisali de�icitarno obrtničko zanimanje. Ova mjera vrijedi i za one koji su već završili školovanje, ali su položili majstorski ispit u de�icitarnom zanimanju u roku od 10 godina od završetka svog srednjoškolskog obrazovanja. Novčana na-

knada od 300 eura dodjeljuje se kako bi se potaknuli mladi na upis de�icitarnih zanimanja koja su trenutno tražena na tržištu rada. Na taj način, općina želi osigurati kvali�iciranu radnu snagu i ojačati lokalnu ekonomiju. Ova mjera obuhvaća sve osobe koje su završile srednjoškolsko obrazovanje nakon 1. siječnja 2024. godine. (sh)










KNJIGA o vinskoj pajdašiji i običajima Hrvati, vino i kultura
Kako se stvari samo brzo zaborave. Ako to netko ne zapiše! Isto kao i kad lažljivac 100 puta ponovi svoju laž. Tada ona nakon nekog vremena postane istinita! Uvjeravam se u to svako malo u svom novinarskom poslu, nažalost.
Posebno se to vidi kada najedanput iznjedri neka nova ekipa. Sve prije što se događalo na nekom području kao da to više ne postoji.

Vijećnik Damir Kovačić upitao je što se događa s općinskim vrtićem i u kojoj je fazi trenutno projekt. Načelnik rebernik odgovorio mu je da sve ide prema planu. Rok za završetak vrtića je sredina 2026. godine. Dobili su za vrtić oko 700.000



Pa tako ministar ne zna ni da su Međimurci svojim doprinosom sami izgradili čakovečku bolnicu. Pa ako se to ne ponavlja, vjerujem da će za nekoliko godina otići u zaborav. Nažalost! Političke elite često instrumentaliziraju povijest u svoje svrhe, prepisujući je i izmišljajući nove narative. Tako se stvarju atmosfera nepovjerenja i podjela u
eura, što je tek ¼ cijelog projekta. Iz kojih će izvora financiranja nabaviti ostatak novca za projekt, razgovarat će kada za to dođe vrijeme. - Štrigova i ljudi koji tu živi zaslužuju da se ide u ovaj projekt, naglasio je Rebernik, zvani Rebus.
Načelnik je najavio raspisivanje natječaja za uređenje centra Štrigove s naglaskom na turistički potencijal. Pred kraj sjednice vijećnicima je prikazan i budući izgled Svjetskog centra pušipela, koji će se uklopiti u postojeću zgradu Doma kulture, dok je na samom kraju sjednice vijećnik Filip Tkalčec sve prisutne počastio ićem i pićem povodom rođenja drugog djeteta.
Knjiga Hrvatska vinska kultura autorice Tanje Baran predstavljena je u Domu kulture u Štrigovi u sklopu Dana svetog Jeronima. Uvodne su pozdrave u ime organizatora održali štrigovski župnik Kristijan Kuhar, načelnik Stanislav
Rebernik i predsjednik Društva Hortus Croatiae Robert Horvat. Knjigu su uz autoricu predstavljali recenzenti Stipe Botica i Đuro Horvat, u glazbenom dijelu programa nastupile su Stridonne, dok je kroz program vodio Dominik Padarić. (sh)
društvu, a istina postaje žrtva ideologije. Elitama to posebno ide u korist. Posebno dok se glas slabijih ne čuje. I ne samo to. Gube se i naši stari običaji. Polako iščezavaju, kao da nikada nisu ni postojali. Dolaze neka nova vremena, nove prakse, nove fore, a one stare padaju u zaborav. I zato treba o svemu tome ostaviti traga. Tehnologija sva moguća koju imamo, i hvala Bogu da ju
imamo, ipak može u sekundi nestati, a samim time nestat će sve što smo digitalno zapisali ako nismo spremni na disk. Knjiga je ipak knjiga. I zato dok vam stariji govore o tome kako se nekada živjelo, poslušajte ih. Vremena od njihove mladosti pa do danas drastično, ali stvarno drastično su se promijenila. I ne slušajte ih samo, zapišite i to što vam govore. Jer
s vremenom ćete to sve zaboraviti. A kada umro, više nećete imati koga pitati da vam priča o prošlosti. Zato, zapišimo svoje priče, sačuvajmo fotografije, snimimo intervjue sa starijima. Stvorimo arhive našeg vremena, kako bismo budućim generacijama ostavili vjerodostojan zapis o našem životu. Jer, ako ne budemo mi čuvari svoje povijesti, tko će biti?






Piše Josip Šimunko
Ovogodišnji Festival autorske tamburaške i narodne glazbe kajkavskog govornog područja Kre Mure i Drove u organizaciji Radija Studio M, održan u petak 27. rujna u Domu kulture Grada Preloga, donio je neke nove naglaske te upotpunio svoju kajkavsku škrinjicu s novih jedanaest skladbi, tako da ih je sad više od 400.
Festival su kao i obično otvorili Mirjana Švenda i Željko Sokač tematskom rečenicom: Grličice mile, klinčeki črleni, vrijeme je za festival Kre Mure i Drave, što je već tradicija.
Spoj tamburaške
glazbe i poezije
Ovogodišnji festival pamtit ćemo po uspješnom spoju tamburaških skladbi i poezije, gošće festivala bile su pjesnikinje Petrana Sabolek i Magdalena Vlah Hranjec te pjesnik Vinko Rojko i pjevačka skupina KUD-a Podturen s međimurskim popevkama.
S novim skladbama nastupili su: Martin Srpak s vlastitom skladbom „Međimurje moje“ (Martin Srpak, prof. Juraj Kolarić, Branko Krušec), Tino Jelenić skladbom „Kaj god jesi“ (autor Branko Krušec), Božidar Brajković vlastitom skladbom „Draga moja prelublena“, Josip Sanjković-Mitrica „Međimurje, daj se zbudi“ (Branko Krušec / Branko Mihovil Rakijašić), Anja Zagorka „Kaj se kaj“ (Anja Zagorka, arr. Branko Krušec), KUU Zasadbreg – „Smeh“ (Miroslav Novak, Rajka Trokter, Miroslav Novak), TS Kumovi – „Međimurje se zlati“ (Ivo Kovač-Kaj, arr. Branko Krušec), Robert Svetlačić „I nikaj su cajti“ (Robert Svetlačić, arr. Branko Krušec),TS Frikovi – „Međimurje i ti v srcu“ (Denis Hajdarović, Damir Pilko, Denis Hajdarović), Denis Kos „Puca z groda“ (Denis Kos, arr. Branko Krušec) i Mario Mustač sa skladbom „Oženil se nigdar ne budem“ (Mario Mustač, arr. Josip Herman) uz pomoć TS-a Frikovi
CENTAR DR. Rudolf Steiner
i skupine Puhačkog orkestra Donji Kraljevec.
Nagrade dugogodišnjim suradnicima
Odmah po izvođenju te skladbe Mario Mustač je od organizatora dobio poseban poklon, čestitke za – rođendan i sretan brak njemu i supruzi, što je izazvalo salve smijeha u dvorani. Radio Studio M nagradio je i Josipa Sanjkovića Mitricu te Magdalenu Vlah Hranjec za dugogodišnju suradnju prigodnim poklonima na valovima radija. Prema podacima radija Studio M,. najslušanija pjesma s prošlog festivala bila je „Sega bode samo ne bo nas“ koju je izveo Mario Mustač.
Gradonačelnik Grada Preloga Ljubomir Kolarek zahvalio je svim izvođačima te publici, kao i obitelji Švenda, te obećao punu podršku festivalu, koji već preko dvadeset godina pronosi ime Preloga. U drugom dijelu programa Josip Sanjković Mitrica je uz festivalski orkestar TS USPJEŠAN 21. FESTIVAL
U organizaciji ustanove Centar dr. Rudolfa Steinera, povodom obilježavanja EU Organic Day-a i Dana biodinamike – jesen 2024., održat će se Radionica izrade biodinamičkih preparata koja pruža jedinstvenu priliku za stjecanje praktičnih znanja i vještina u području biodinamičke agrikulture. Ova radionica pruža sudionicima priliku da se upoznaju s metodama održive agrikulture, usmjerenim na očuvanje prirodne ravnoteže tla i biljaka.
Radionica će se održati 5. listopada 2024. godine, s početkom u 14 sati, na lokaciji Holiday Home Lina (Pleškovec 154a), a namijenjena je svima koji su zainteresirani za bi-
odinamičku poljoprivrednu praksu. Posebno zanimljiv dio radionice bit će zakapanje preparata 500, poznatog i kao “gnoj iz roga”, koji se smatra temeljnim biodinamičkim pripravkom.
Preparat 500 ima ključnu ulogu u poboljšanju strukture tla jer potiče stvaranje snažnijeg korijenskog sustava biljaka, potiče formiranje humusa, aktivira mikroorganizme i donosi brojne prednosti za održivost tla i ekosustava. Ovaj preparat također povećava sposobnost tla da zadrži vlagu i hranjive tvari, te poboljšava prozračnost i omogućava biljci bolji pristup hranjivim tvarima, što doprinosi zdravijem i jačem rastu. Sudionici radio-
nice imat će priliku ne samo steći praktične vještine u izradi biodinamičkih preparata, već i saznati više o načelima biodinamičke poljoprivrede. Edukaciju će voditi dr. sc. Dijana Posavec, ravnateljica ustanove Centar dr. Rudolfa Steinera, te Majda Hriberšek, iskusna predavačica iz Slovenije. Radionica je besplatna za sve sudionike, a sudionici će moći ponijeti biodinamičke pripravke koje izrade tijekom edukacije, uz napomenu da sa sobom ponesu čiste boce i staklenke za pohranu preparata.
Za prijave i više informacija kontaktirajte nas na e-mail adresu info@centar-rudolf-steiner. com
Frikovi otpjevao pregršt međimurskih popevki na radost publike koja je ispunila dvoranu Doma kulture.
Gotovo sve soliste je pratio festivalski bend koji čine vrsni tamburaši Tamburaškog orkestra KUU-a Zvon i TS-a Frikovi, pod voditeljskom palicom dirigenta Valentina Škvorca. Festival je održan u organizaciji Radija Studio M te pod generalnim pokroviteljstvom Grada Preloga i generalnim sponzorstvom Međimurske županije, uz mnoštvo sponzora te prenošen uživo.





MEĐIMURCI na državnom prvenstvu u oranju
Minulog vikend u Velikoj Gorici održano je jubilarno 20. Državno natjecanje u oranju. Manifestacija je okupila najbolje orače iz 13 županija i to 13 u kategoriji premetnjaka i 12 u kategoriji ravnjaka. Među njima bili su i Međimurci - Valentino Šalković iz Preloga s plugom premetnjakom te Fran Andrej Jalušić iz Ivanovca s plugom



Valen�no Šalković zauzeo je sedmo mjesto
Fran Andrej Jalušić osvojio je treće mjesto
Naši dečki bili su odlični pa je Fran, inače veteran po broju sudjelovanja na državnim smotrama, osvojio treće mjesto, a Valentino sedmo.
- Moglo je biti bolje, poručio je Valentino kojemu je to bilo drugo sudjelovanje na državnom natjecanju. Naime, uvjeti natjecanja bili su dosta teški jer je kišilo, zemlja je bila gnjecava i puna vode. (vv)

IZLOŽBA malih životinja u Nedelišću Kupite ili razmijenite
Udruga uzgajivača malih životinja iz Nedelišće i ove prve nedjelje u mjesecu, dakle 6. listopada, organizira prodajno-pokaznu izložbu. Mjesto sastanka je vanjski prostor MESAP-a i to od 7 do 12, odnosno 13 sati. Organizatori ponovno najavljuju velik broj izlagača iz svih krajeva zemlje.
A svi koji žele pokazati, prodati ili razmijeniti svoje male životinje mogu slobodno doći na Sajam. Dakle, ne moraju biti članovi Udruge, prijaviti se za sudjelovanje niti pak platiti mjesto, odnosno prodajno-izložbeni prostor. Moraju jedino platiti ulaz, kao i svaki drugi pojedinac, te doći sa zdravom životinjom. (vv)
GRAD PRELOG daje u zakup poljoprivredno zemljište u svojemu vlasništvu
Na ponudi je 20 livada i oranica
Grad Prelog raspisao je javni natječaj za zakup poljoprivrednog zemljišta u svojem vlasništvu na području k.o. Draškovec, k.o. Hemuševec i k.o. Čukovec. Ponuditelji mogu dati ponudu za jednu ili više čestica. Minimalni ponuđeni iznos godišnje zakupnine ne smije biti manji od početnog iznosa godišnje zakupnine. Poljoprivredno zemljište daje se u za-
kup na vrijeme od 5 godina, s mogućnošću produljenja na zahtjev odabranog ponuditelja. Pisane ponude predaju se osobno u zatvorenoj omotnici do 11. listopada 2024. godine, zaključno do 12 sati. Riječ je o 20 parcela, livada i oranica različite površine. Najmanja je od 109 kvadratnih metara u Čukovca, a najveća 4233 kvadrata u Draškovcu. (vv)





IZLOŽBA GLJIVA gljivarskog društva Smrčak


- Vrlo je ukusna kad se poha i odlična je zamjena za meso. Tim više što bojom i okusom podsjeća na piletinu ili pohani kruh. Zato je i zovu žuti kruh te šumsko pile
Piše: Vlasta Vugrinec
Članovi gljivarskog društva Smrčak iz Čakovca, izložbom gljiva na neki način označili su i jesensku sezonu lova na “šumsko meso”. Zna se, naime, kako gljive rastu tijekom cijele godine, no nekako se kraj ljeta i prve kiše povezuju s branjem pečurki, sunčanica i vrganjakralja gljiva.
A upravo su gljivari minule subote na čakovečkom Franjevačkom trgu izložili najviše primjeraka tih vrsta gljiva. Možda pak su te gljive, među 100-tinjak izloženih, bile i posebno zapažene jer ih i najviše ljudi poznaje. Drugim riječima, mogle su se vidjeti brojne jestive i nejestive gljive kao i naravno, one koje se jedu samo jednom u životu poput zelene pupavke.
Gljive su bile ubrane kako u Međimurju tako i okolnim krajevima, a neki su berači potegli čak do Gorskog kotara.
Kako smo doznali, sve izložene gljive inače mogu se ubrati i u Međimurju.
Šumsko pile
U moru izloženih gljiva, prvo što je promatraču zapalo za oko je bila žuta lepeza gljiva na “panju”. Vrlo intenzivna boja na tamnoj podlozi, jednostavno nije mogla proći nezapaženo. A riječ je vrlo jednostavnoj i rasprostranjenoj gljivi, pravoj gastronomskoj


deliciji pod imenom Žuti kruh, žuto pile, sumporni grm...
- Žuti kruh jedna je od najsigurnijih gljiva, naglašava Goran Kolarić iz Čakovca, determinator gljiva i član GDa Smrčak. Spada u porodicu bukovača koje kod ljudi ne izazivaju nikakve nuspojave, eventualno kod onih koji su alergični na njih, što je vrlo rijetka pojava.
Naime, i jestive gljive mogu kod pojedinaca izazvati probleme poput mučnine i povraćanja, a razlog je glikoprotein.
- Vrlo je ukusna kad se poha i odlična je zamjena za meso, dodaje. Tim više što okusom podsjeća na piletinu ili pohani kruh. Zato je i dobila ime žuti kruh te šumsko pile. Gljiva je inače parazit i voli parazitirati na stablu bjelogorice poput vrbe, hrasta... Na jednom stablu, kaže naš determinator, može izrasti i do 50 kilograma gljive iz jednog plodišta. Uglavnom, godinama raste na istom stablu dok ga potpuno ne iscrpi.
Šume Međimurja također su plodno tlo za rast Žutog kruha.
- Može se naći u šumi kod Macinca, pa kod Pleškovca, pa na potezu uz Muru i Dravu.69 Ima ga jako puno i kaže kako na jednom stablu može izrasti i do 50 kilograma te gljive.Beru se mladi primjerci, koji moraju biti jarko žuto-

narančaste boje. Starije gljive odrvene te nisu prikladne za jelo.Prije pripreme mora se prokuhati barem desetak minuta u slanoj vodi. Pogodna je za kiseljenje, gulaše, a i u slatkoj varijanti.
Šume su prepune vrganja
- Ima vrganja i ustvari tek sada počinje njihovo vrijeme, ističe Goran Kolarić. Nakon kiše, prije dva do tri tjedna krenule su pečurke i to livadama.
S livada, kako svjetlost prodire u šumu, berači se zaustavljaju najprije na njenim rubovima gdje pronalaze sunčanice i onda tek stižu do vrganja u šumi. Ljubitelji gljiva ne mogu se odlučiti što im je najbolje kod “kralja gljiva”. Njegov jedinstven klobuk s cjevčicama, opojni miris, puni okus ili pak mogućnosti njegove pripreme. Vrganj paše u gotova sva jela, od juha preko salata i umaka do gulaša i pečenja. Može se spremiti i za zimu bilo u svježem obliku u škrinju ili pak se osuši.
Zbog punoće okusa, čak ga je i šteta miješati s ostalim vrstama.
No, to ne znači da pečurka nije �ina te da se ne može pripremiti na brojne načine. Ista je stvar i s bukovačama, crnim trubama, sunčanicama, najčešćim gljivama koje se sada pronalaze. Dakle, gljiva

ima, naročito sada kada ima dosta vlage, a i nije prehladno. Naravno, mogu se pronaći i tartu�i.
- Ima crnih tartufa, no za njihovu “berbu” potreban je pas, ističe Goran. Dolaze ih tražiti tartufari i van naše županije, doduše više tijekom ljeta.
Oprezno u berbu
Gljive su ukusne i dobra su zamjena za meso. Međutim, u berbi treba ići s puno opreza i s mišlju kako su pojedine jestive samo jednom u životu. Ne postoji niti jedno univerzalno pravilo koje omogućava da razlikujemo jestive gljive od otrovnih. Jedini pravilan način razlikovanja je detaljno upoznavanje svih njihovih karakteristika, odnosno mogućnost prepoznavanja otrovnih dvojnika. U Hrvatskoj je trenutno ugroženo oko 350 vrsta gljiva te se one ne smiju brati, a preporučena količina jestivih gljiva koje možete ubrati u jednom danu je 2 kilograma. Obavezno prije kretanja u šumu treba izvaditi koja vrijedi za kalendarsku godinu jer u suprotnom prijeti kazna koja se penje do 1000 eura. Gljive se beru s posebnom pažnjom što znači da se ne čupaju, niti pak se igra nogomet s onima koje se ne poznaju. Željena gljiva reže se nožićem tik uz zemlju tako da se ostavi barem dio plodišta za novi rast i razmnožavanje.










CIJENE PLAC
Batat (kg): 2 €
Mahune (kg): 5 €
Zelje (kg): 2 €
Paprika (kg): 2 €
Rajčica (kg): 3 €
Krastavci (kg): 1-3 €
Patlidžan (kg): 2 €
Kelj (kg): 3 €
Rotkvice (pušlek): 1 €
Šljive (kg): 2 €
Kesteni (kg): 5 €
Maćuhice (kom): 0,8 €
Piše: Igor Moharić, dr.med.vet.
Batat (kg): 2 €
Mahune (kg): 4 €
Zelje (15 kg): 15 €
Paprika (vreća): 15 €
Rajčica (kg): 1,5 €
Krastavci (kg): 0,5-1,5 €
Salata (kg): 3 €
Maruni (kg): 7 €
Vrijesak: (komad): 3 €
Mrkva (kg) 1,5 €
Kesteni (kg): 5 €
Drva (metar): 65-75 €
čizmama, toplim čarapama i trenirkama.
Cijeli red kupaca stvorio se kod prodavača vrganja koji ih je samo nosio i nosio iz svog vozila. Primjetna je bila i potražnja za gumenim
Kiša je ove srijede desetkovala ponudu, ali i potražnju, kako na čakovečkom placu tako i na sajmu. Tek samo oni najuporniji i s robom koja podnosi takvo vrijeme, postavili su svoje štandove i klupe. Među njima, najbrojniji su bili prodavači/uzgajivači zelja. Ovisno kupuje li se na malo ili na veće, cijena se kretala od 1,5 do 2 eura. Drugim riječima, vreća od 20 kg varaždinskog zelja nudila se po 15 eura. Za vreću crvene rog paprike tražilo se također 15 eura, a za mladi grah u mahuni 20 eura. U ponudi cvijeća prevladavale su multi�lore čije su se cijene kretale od 5 eura na dalje, ovisno o veličini. Teglica vrijeska nudila se po 3 eura, a popularne maćuhice od 50 centi na dalje.



Slična je situacija bila na placu, s time da su se tamo nudile već i prve grančice špina i margareta. (vv)



isterije su maleni, slabo patogeni mikroorganizmi rasprostranjeni po čitavom svijetu u okolišu i crijevima sisavaca (izuzev ljudi), ptica, ljuskara i paučnjaka. Razlikujemo nekoliko vrsta listerija, no prevladavajući patogen upravo je Listeria monocytogenes koja dovodi do pojave listerioze. Njena karakteristična obilježja poput razmnožavanja unutar velikog raspona pH i temperature te izrazita otpornost na visoku koncentraciju natrijevog klorida omogućuju listeriji preživljavanje različitih postupaka koji se koriste pri obradi namirnica. Dodamo li tome sposobnost razmnožavanja na temperaturama skladištenja (+4 °C), ne čudi što ova bakterija predstavlja značajan problem za prehrambenu industriju te potencijalnu opasnost po ljudsko zdravlje. Premda je L. monocytogenes odavno prepoznata kao uzročnik bolesti u ljudi, tek je osamdesetih godina 20. stoljeća opaženo da je kontaminirana hrana glavni put prijenosa te bakterije iz okoliša u ljude. Listerioza u domaćih životinja značajan je gospodarski problem. Ona je u prvome redu bolest preživača, napose ovaca, ali obolijevaju i druge životinje; tako su na području sjeverozapadne Hrvatske zabilježene pojave listerioze na farmi krava i farmi činčila. Javnozdravstvena važnost listerioze nerijetko je podcijenjena zbog toga što je ona puno rjeđa u usporedbi s drugim akutnim infektivnim bolestima koje se prenose hranom, kao što je primjerice salmoneloza. Međutim, važno je znati da se među infekcijama koje se prenose hranom, listerioza svrstava među bolesti s najčešćim smrtnim ishodom. Njena incidencija u SAD-u bi-
lježi pad od 1990. godine, sve do nedavne, najsmrtonosnije epidemije 2011. godine koja se dovodi u vezu s dinjama uzgojenim na poljoprivrednim zemljištima u Coloradu - ukupni broj zaraženih tada je iznosio 72 osobe, od kojih je smrtno stradalo njih 13. Godišnja incidencija listerioze u većini zemalja unutar Europske unije prosječno se kreće od dva do deset prijavljenih slučajeva na milijun stanovnika.
U istraživanju provedenom na području Hrvatske L. monocytogenes izolirana je u nešto više od 4 posto uzoraka kolača iz ugostiteljskih objekata tijekom godine dana, a izolirani serotipovi i količina bakterija u pregledanim kolačima imali su visok potencijalni rizik za infekciju u ljudi. U našoj su zemlji isto tako provedena istraživanja na domaćim nepasteriziranim mliječnim proizvodima gdje je ovaj uzročnik također pronađen, a izoliran je i iz 3 posto uzoraka svježega
AMBULANTA ZA MALE ŽIVOTINJE
Radnim danom od 7 - 20 sa�, subotom 7 - 12 sa� i nedjeljom od 8 - 9 sa�
Tel: 390 - 859
AMBULANTA ZA VELIKE ŽIVOTINJE
radno vrijeme od 7 - 14 sa�
Tel: 390 - 896
dežurni veterinar: 098/ 463 - 464
AMBULANTA ZA VELIKE ŽIVOTINJE
radnim danom od 7 - 13 sa�
i smrznutoga mesa peradi. Dokaz bakterije iz smrznute hrane upozorava na činjenicu da L. monocytogenes može podnijeti i zamrzavanje. Glavni korak u prevenciji je pravilan pristup hrani, od rukovanja i kuhanja do konzumacije. Tu svakako valja obratiti pažnju na pravilno pranje sirovog povrća te temeljito kuhanje hrane, kao i na važnost zagrijavanja hrane na dovoljno visokoj temperaturi. Drugi značajan aspekt preventivnog djelovanja jest savjetovanje skupina pod visokim rizikom (kao što su trudnice i pacijenti s oslabljenim imunosnim sustavom) o izbjegavanju svih nepasteriziranih mliječnih proizvoda, što uključuje meke sireve poput fete, Brie i Camemberta. Sirni namazi i jogurti smatraju se sigurnim izborom. Rana dijagnoza i bolje razumijevanje patogeneze listerioze značajno pridonose prevenciji, unapređenju liječenja te smanjenju često teških posljedica ove bolesti.
HIGIJENIČARSKA SLUŽBA (DDD) dezinfekcija, dezinsekcija, dera�zacija dežurstvo: 098/ 465 - 485
LABORATORIJ radno vrijeme od 7 - 15 sa�, subotom od 7 - 12 sa�
Tel: 391 - 485 Mob: 098/ 465 - 475
ČAKOVEC
Tel: 543 - 151 dežurni veterinar: 098/ 465 - 473 MURSKO SREDIŠĆE
Tel: 899 - 101
dežurni veterinar: 098/ 465 - 470
Čišćenje i obrada papaka radnim danom od 7 - 9 sa� GORNJI MIHALJEVEC I ŠTRIGOVA






www.mnovine.hr • redakcija@mnovine.hr • 040 323 601

Veterinarska stanica Prelog d.o.o.
Ul. kralja Zvonimira 51
PRELOG - Ambulanta za male živo�nje, tel: 040/645-505
Šumski vrt ili šuma hrane je oblik uzgoja hrane u kojem se imitiraju prirodni biosustavi mlade šume i šumskog ruba. Iako relativno nepoznati pojam kod nas, šumski vrt je najstariji način ljudskog bavljenja poljoprivredom. Ovo su kompleksni sustavi koji se dizajniraju višedimenzionalno, čak u 7 slojeva, a obuhvaćaju stabla, voćke, grmlje, penjačice, zeljaste trajnice, ljekovito bilje, gomolje i samonikle biljke te povrće.
Šumski vrt se bazira na biljkama trajnicama ali ne isključuje i jednogodišnje povrće. Iako ne moraju sve biljke u šumskom vrtu biti jestive, biramo biljke koje imaju korisne funkcije u biosustavu npr. �iksacija dušika, zaštita od vjetra, hrana, lijek itd.
Šumski vrt možemo dizajnirati ispočetka, ali i postojeći vrt ili voćnjak možemo preraditi u takav oblik uzgoja hrane. Ako se sve dobro odradi, za 15-tak godina, jedini posao će vam biti berba plodova.
Na radionici ćete naučiti osnove kreiranja šumskog vrta te imati prilike napraviti plan vašeg budućeg šumskog
vrta odnosno šume hrane. Sama radionica održat će se u šumskom vrtu voditeljice edukacije Silvije Kolar-Fodor, tako da imate jedinstvenu priliku učiti o ovom obliku uzgoja hrane na stvarnom primjeru šumskog vrta koji je bio formirani 2012. godine.
VODITELJICA
EDUKACIJE
Silvija Kolar–Fodor je autorica, biovrtlarka i aktivistica. Kao velika zaljubljenica u prirodu posvećena je edukaciji o životu u skladu s prirodom. Autorica je knjige „Vrtlarenje u skladu s prirodom« i edukativnog portala www.biovrt.com, a surađivala je kao kolumnistica s brojnim časopisima i portalima.
Predsjednica je udruge “Biovrt – u skladu s prirodom” u sklopu koje diljem Republike Hrvatske provodi edukacije, osmišljava i vodi razne projekte kojima pokreće školske vrtove u Međimurju i uvodi edukacijske programe o biovrtlarenju, održivom razvoju i životu u skladu s prirodom u osnovne škole. Čuvarica je brojnih sorti starinskog sjemenja i
KIVANO ili rogata dinja Krune Raina
čuva ih od izumiranja za buduće generacije. Na svom imanju stalno isprobava nove ideje i tehnike biološkog uzgoja te redovito piše i inspirira brojne pratitelje na društvenim mrežama. Biovrtlarenjem se bavi od 2006. godine. Dobitnica je prestižne nagrade Hrvatske utjecajne žene 2020. na području vodstva i inovacija, te nagrade Žuti okvir za održivi razvoj, znanost i obrazovanje za 2020. u kategoriji 2: Iskorjenjivanje gladi.
KADA
ODRŽAVAMO
EDUKACIJU
Radionicu održavamo 12.10.2024. (subota) 10:00-14:00 na imanju Biovrt u Novom Selu Rok. Broj mjesta je ograničen, prijave su obavezne putem online prijavnice koju možete naći na naslovnici www.biovrt.com.
- Okus mu je negdje između krastavca i banane, kaže Kruno Rain koji u svom vrtu uzgaja kivano. Riječ je o egzotičnoj tropskoj jednogodišnjoj voćki. Naš vrtlar otkriva kako ju sadi svake godine. Kako je riječ o biljci penjačici, najbolje joj je osigurati potporanj. Naime, stabljika može narastii do 3 metra.
Radno vrijeme: radnim danom od 7:30 - 19 sati, subotom od 7:30 - 12 i nedjeljom od 7:30 - 10 sati.
Dežurni za hitne slučajeve izvan radnog vremena nazva� na telefon: 040/645-505
PRELOG - Ambulanta za velike živo�nje, tel: 040/645-422
Radno vrijeme: radnim danom od 7 - 14:30 sati, subotom od 7-12
Dežurni za hitne slučajeve izvan radnog vremena nazva� na telefon: 040/645-422
DONJA DUBRAVA - tel: 040/688-936 Radno vrijeme: radnim danom od 7-14,30 sati, subotom od 7-12 i nedjeljom zatvoreno.
VETERINARSKA AMBULANTA JUG ČAKOVEC, N. PAVIĆA 1, TEL: 363-801 Radno vrijeme dvokratno od 8-12 i od 16-19 sa�, subota 8-12, nedjelja i praznik 8-9 sa�.
VETERINARSKA AMBULANTA MR. KVAKAN ČAKOVEC, V. Lisinskog bb, tel: 040/365-277 Radno vrijeme dvokratno od 8-12 i od 16-19 sa�, subotom od 8-12 i nedjeljom zatvoreno.
VAŠ NAJPOUZDANIJI PARTNER U OPSKRBI PRIRODNIM PLINOM


OPSKRBA PRIRODNIM PLINOM U MEĐIMURJU
OPSKRBA PRIRODNIM PLINOM U REPUBLICI HRVATSKOJ HR 40000 Čakovec, Obrtnička 4 TEL 040 396 279 I FAX 040 396 282 ww w.medjimurje-plin.hr I medjimurje-plin@medjimurje-plin.hr 0800 202 033

UČINKOVITA POTROŠNJA PRIRODNOG PLINA
Sadi ga na sunčano i toplo mjesto u drugoj polovici svibnja. Počinje zreti u kolovozu i plodovi su mu tada zeleni i kiselkasti s mekanom korom. Bere se tek dok poprimi karakterističnu narančasto-žutu boju i tada postaje sladak poput dinje i banane, s dozom kiselosti citrusa. Kora zrelog kivana je bodljikava i tvrda.


- Kivano najviše volim jesti sirov, dodaje. Prerežem ga i jednostavno jedem žličicom, slično kao što ljudi jedu kivi. Unutrašnjost ploda i podsjeća na kivi, samo što

Kivano sasvim lijepo uspijeva i kod nas na kon�
je kod kivana želatinast s košticama nalik na onima u krastavcima. (vv)

UŠTEDITE KOD POTROŠNJE PRIRODNOG PLINA: -SMANJENJEM TEMPERATURE U PROSTORIJI ZA BAREM 1oC, ČIME SE ŠTEDI ENERGIJA - ZAGRIJAVANJEM PROSTORIJA DO 19oC - REDOVITIM SERVISIRANJEM PLINSKIH TROŠILA (UREĐAJA) -REDOVITIM PRAĆENJEM POTROŠNJE PRIRODNOG PLINA NA SIGURAN I POUZDAN NAČIN
komercijala@medjimurje-plin.hr
komercijala2@medjimurje-plin.hr
komercijala3@medjimurje-plin.hr
dijana@medjimurje-plin.hr



35. OBLJETNICA od zavešetka osnovne škole
Mnogo je onih koji s nostalgijom gledaju na dane provedene u osnovnoj školi prisjećajući se prijateljstava koja su se stvarala tijekom djetinjstva.


Na temelju članka 20.stavka 6. Zakona o knjižnicama i knjižničnoj djelatnosti (NN 17/19, 98/19, 114/22 i 36/24) i članka 14. Statuta Knjižnice i čitaonice Goričan, Povjerenstvo za provođenje javnog natječaja za imenovanje ravnatelja Knjižnice i čitaonice Goričan raspisuje
za imenovanje ravnatelja/ravnateljice Knjižnice i čitaonice Goričan - 1 izvršitelj u polovici radnog vremena; 20 sati tjedno
Ravnateljem/icom može biti imenovana osoba koja ima: • završen sveučilišni diplomski studij ili sveučilišni integrirani prijediplomski i diplomski studij ili stručni diplomski studij ili s njima izjednačeni studij,
• položen stručni ispit za zvanje knjižničara,
• najmanje pet godina rada u knjižnici,
• stručne, radne i organizacijske sposobnosti temeljem kojih se može očekivati da će s uspjehom voditi Knjižnicu
Uz smijeh, priče iz prošlosti i mnoštvo emocija, pedesetogodišnjaci su ispunili prostor veseljem.
Prisjetili su se dana u školskim klupama, izleta, školskih nestašluka i prvih ljubavi. Bilo je to kao da se nikada nisu rastali.
Nažalost, život nas često odvodi na različite putove, zbog čega neka prijateljstva nestanu, no to nije slučaj s veselom generacijom bivših učenika Osnovne škole Donja Dubrava rođenih 1974./1975. Oni su pravi primjer kako prava prijateljstva, usprkos vremenu i obavezama, mogu trajati zauvijek.Ova posebna generacija okupila se u Lovačkom domu u Donjoj Dubravi kako bi proslavila 35. obljetnicu završetka osnovne škole.
Njihova generacija broji čak 75 učenika te je posljednja generacija koja je pohađala osnovnu školu u trima razredima – a, b i c. Nakon njih, sve nove generacije bile su organizirane u dvama razredima – a i b. Jedna od posebnosti ove generacije je upravo njihova posvećenost održavanju prijateljstva. Oni se često okupljaju i to je njihova mala tradicija te se trude redovito održavati kontakte i dolaziti na zajednička druženja. Nema tog po-
sla ili obaveze koja ih može spriječiti da nađu vremena jedni za druge jer, kako sami kažu, takve veze i prijateljstva treba njegovati i cijeniti. Ova generacija pedesetogodišnjaka iz Donje Dubrave i Donjeg Vidovca, usprkos vremenu koje je prošlo, ostala je jednako povezana kao i prije 35 godina. Proslava je završila tek u ranim jutarnjim satima, uz obećanje da će se ponovno okupiti, kako bi nastavili tradiciju koja ih sve veže. (Sania Bižupić)
ODRŽAN 33. SUSRET OSOBA S INVALIDITETOM “JESEN V MEĐIMORJO“
Prošle subote Društvo osoba s tjelesnim invaliditetom MŽ-a (DOSTI) s ponosom je organiziralo 33. Susret osoba s invaliditetom “Jesen v Međimorjo“. Događaj se održao u prostorima Centra DOSTI u Podturenu, a okupio je naše članove i goste iz raznih dijelova Hrvatske, susjedne Slovenije i Bosne i Hercegovine.
Nakon uvodnog govora predsjednice Miljenke Radović i započela su natjecanja u pikadu, bacanju lopte u koš, belotu, šahu i stolnom tenisu. Igre su prošle u prijateljskoj, ali natjecateljskoj atmosferi, a natjecatelji su pokazali velik sportski duh i želju za druženjem.
Gostima su pokazali novouređene prostore Centra DOSTI, gdje su prezentirali sva postignuća tijekom proteklih godina te kako se trude osigurati što bolje uvjete za sve svoje članove. Domjenak su skuhali učenici i profesori Srednje škole Prelog, i kako su nam rekli, njihova nesebična podrška našim događanjima uvijek ih iznova oduševljava. Na druženju su osim članova društva bili i brojni uzvanici i gosti, među kojima su bili Udruga tjelesnih inva-

lida Bjelovar, Udruga Susret Čitluk, Društvo tjelesnih invalida grada Rijeke, Udruga invalida Koprivničko-križevačke županije, Društvo paraplegikov Prekmurja in Prlekije Murska Sobota, Udruga osoba s invaliditetom Križevci, Društvo osoba s invaliditetom Varaždin (DOSI Varaždin), UDCDPNO Udruga distro�ičara, cerebralne i dječje paralize i ostalih neuromuskularnih oboljenja Daruvar, Udruga osoba s invaliditetom Daruvar, Udruga osoba s invaliditetom Sinergija Samobor i Udruga tjelesnih invalida ILO Ivanec. Susret je bio prilika za povezivanje, razmjenu iskustava te jačanje prijateljstva među udru-
gama i pojedincima i vesele se budućim susretima. Po broju osvojenih medalja najuspješnija je bila ekipa UOSI Daruvar, dok su Međimurci su postigli sljedeće uspjehe:
3. mjesto u pikadu osvojila je Ljubica Dragović, Vlado Vabec i Antun Vlahek bili su treći u belotu, a Ivan Srnec također je osvojio treće mjesto u šahu. Čestitamo! (SZ)

Smatra se da položen stručni knjižničarski ispit ima i osoba koja je oslobođena polaganja stručnog knjižničarskog ispita na temelju zakona kojima je uređivana knjižnična djelatnost, te je kao dokaz prijavi na natječaj potrebno priložiti kopiju rješenja ili drugog odgovarajućeg akta.
Ravnatelja/ravnateljicu imenuje Općinsko vijeće Općine Goričan, na prijedlog Povjerenstva za provođenje javnog natječaja za imenovanje ravnatelja.
Ravnatelj/ravnateljica se imenuje na četiri godine. Ista osoba može ponovno biti imenovana.
Uz prijavu na natječaj potrebno je priložiti:
• životopis
• plan rada za četverogodišnje razdoblje
• presliku dokaza o završenom stupnju obrazovanja (diploma)
• presliku dokaza o položenom stručnom knjižničarskom ispitu
• presliku dokaza o godinama rada u skladu s uvjetima iz ovog natječaja (ugovor ili rješenje ili potvrda poslodavca)
• presliku potvrde ili elektronički zapis o podacima evidentiranim u matičnoj evidenciji Hrvatskog zavoda za mirovinsko osiguranje
• potvrdu da nije pokrenut kazneni postupak (ne starija od 6 mjeseci)
Osobe koje prema posebnim propisima ostvaruju pravo prednosti pri zapošljavanju i imaju prednost u odnosu na ostale osobe samo pod jednakim uvjetima, moraju se u prijavi na javni natječaj pozvati na to pravo. Osoba koja se u prijavi pozove na to pravo obvezna je priložiti odgovarajuće isprave kao dokaz o statusu te druge dokaze sukladno posebnom zakonu kojim je uređeno to pravo. Osoba koja se pozvala na pravo prednosti na temelju Zakona o hrvatskim braniteljima iz Domovinskog rata i članovima njihovih obitelji (Narodne novine broj 121/17) dužna je dostaviti sve dokaze iz članka 103. navedenog zakona. Dokazi potrebni za ostvarivanje prava prednosti prilikom zapošljavanja objavljeni su na internetskoj stranici Ministarstva hrvatskih branitelja Republike Hrvatske https://branitelji.gov.hr/zaposljavanje-843/843.
Prijave s navedenim prilozima podnose se u roku od 20 dana od objave natječaja na adresu: KNJIŽNICA I ČITAONICA GORIČAN, Trg sv. Leonarda 22, Goričan, s naznakom „Natječaj za imenovanje ravnatelja/ ravnateljice Knjižnice i čitaonice Goričan“ zaključno do 24. listopada 2024.g. do 12,00 sati.
Prijavom na natječaj kandidati su izričito suglasni da Knjižnica i čitaonica Goričan može prikupljati, koristiti i obrađivati njihove podatke u svrhu provedbe natječajnog postupka, a sukladno propisima koji uređuju područje zaštite podataka.
Nepravovremene i nepotpune prijave neće biti razmatrane.
Općina Goričan zadržava pravo poništenja javnog natječaja.
O rezultatima natječaja kandidati će biti obaviješteni u zakonskom roku.
Povjerenstvo za provođenje javnog natječaja
Plesni studio Marti svetomartinske ažoretkinje svečano obilježile 20 godina svog djelovanja organizacijom odlične smotre mažoretkinja. Više od 400 uzvanika uživalo je u nezaboravnoj atmosferi, dok su svojim nastupima večer uveličale mažoretkinje iz

Nedelišća, Selnice, Kotoribe, Murskog Središća, Čakovca i Domašinca. Veliko hvala ide i svim roditeljima koji su trenericu Stanku Kutnjak iznenadili zajedničkim darom i poklonivši joj dugo željeni JBL 320 zvučnik. - Ovaj poseban po-





Svetomar�nske mažoretkinje s trenericom Stankom Kutnjak
klon olakšat će organizaciju treninga i dodatno pridonijeti kvaliteti rada, čineći svaki budući trening još boljim i



Tihana, Ivana, Mirjana i Marina odmah su se složile da u našim novinama najprije pogledaju i komen�raju špicu
Trgovina KRK U DUNJKOVCU


S našim crvenim vrećicama ovog tjedna posjetili smo Dunjkovec gdje nas je dočekala vesela ekipa prodavačica u Trgovini Krk. Tihana Matjašec iz Nedelišća, zajedno s kolegicama Mirjanom Kovač iz Strahoninca, Ivanom Novak iz Dunjkovca i Marinom Mesarek iz Čakovca, odmah su nam se pohvalile da s velikim zanimanjem prate našu špicu. Uvijek vole vidjeti lijepo dotjerane žene i pronaći inspiraciju za vlastite modne kombinacije. Kako kažu, na špi-
ci se uvijek može naći pregršt dobrih ideja i stilski dotjeranih gospođa. Osim što uživaju u špici, podijelile su s nama i što još vole čitati u novinama. Tihana uglavnom prati vijesti putem portala i društvenih mreža, a kada ulovi slobodan trenutak, rado čita recepte i horoskop. Mirjana, s druge strane, najčešće provjerava novosti iz našeg kraja, tko se rodio, tko se vjenčao, a tko nas je, nažalost, napustio. Marina se najviše zanima za događaje
u Čakovcu, posebno za lokalne fešte i sportske vijesti. Ivana je priznala da novine pregledava od korica do korica, no najčešće je privuku slike ili naslovi, pa ako joj se to dopadne tada pročita i cijeli tekst.
Uz ove srdačne prodavačice, u trgovini u Dunjkovcu rade još i Brigita Vibovec iz Nedelišća te Lara Črnčec iz Strahoninca, koje su također dio vrijedne ekipe koja svakodnevno uljepšava dan svojim kupcima.
(SZ)

Ime i prezime:
Adresa:
Broj telefona:



učinkovitijim, istaknula je trenerica Stanka. Završetak događanja obilježen je zajedničkim druže-

NAKLADNIK
MEDIA NOVINE d.o.o. Čakovec, Kralja Tomislava 2 OIB: 37268927073 tel: 040/323-600, fax: 040/493-305, mail: redakcija@mnovine.hr


njem uz dvije veličanstvene torte – jednu su s ljubavlju sponzorirali roditelji u čast mažoretkinja, dok je druga


o dobivanju uporabne dozvole za rad Uređaja za pročišćavanje otpadnih voda Aglomeracije Mursko Središće i Aglomeracije Donja Dubrava
Međimurske vode d.o.o. obavještavaju cijenjene korisnike vodnih usluga s područja naselja koja pripadaju u Aglomeraciju Mursko Središće te Aglomeraciju Donja Dubrava, da su izdane uporabne dozvole za redovan rad Uređaja za pročišćavanje otpadnih voda Mursko Središće (dana 24.09.2024.) i Uređaja za pročišćavanje otpadnih voda Donja Dubrava (dana 12.09.2024.)
Redovan rad Uređaja za pročišćavanje otpadnih voda znači sigurnu i kvalitetnu uslugu pročišćavanja otpadnih voda za sve korisnike vodne usluge javne odvodnje, čime se štiti zdravlje ljudi, okoliš i sprječava zagađenje podzemnih voda.
Ovakvo unaprjeđenje usluge javne odvodnje dobrobit je za sve korisnike s područja naselja Aglomeracije Mursko Središće i Aglomeracije Donja Dubrava u kojima je izgrađen javni sustav odvodnje te u naseljima gdje je odvodnja i pročišćavanje organizirana pražnjenjem septičkih i sabirnih jama fekalnim vozilima jer će se sada sve otpadne vode pročišćavati na navedenim Uređajima za pročišćavanje otpadnih voda.

S danom 01.10.2024. započeti će naplata usluge pročišćavanja otpadnih voda, putem računa za vodne usluge. Korisnici će račune za listopad 2024. primiti sredinom studenoga 2024.
Obzirom na završnu fazu projekata Aglomeracije Mursko Središće i Aglomeracije Donja Dubrava, Međimurske vode će provoditi kontrolne preglede priključenja te za objekte koji i nadalje nisu priključeni, vodni redar će postupiti u skladu sa svojim ovlastima.
Stoga ponovo pozivamo korisnike koji nisu priključili svoje objekte na javni sustav odvodnje da isto izvrše. Također, pozivamo korisnike s područja gdje je odvodnja i pročišćavanje organizirana pražnjenjem septičkih i sabirnih jama fekalnim vozilima, da vrše redovno pražnjenje septičkih jama radi pravilnog zbrinjavanja otpadnih voda. Cjenik vodnih usluga sa iznosima koji će se obračunavati kada se uz odvodnju počne naplaćivati pročišćavanje otpadnih voda, nalazi se na https://medjimurske-vode.hr/ cjenik-vodnih-usluga-za-vasu-opcinu-grad/
NAGRADNI NATJEČAJ “Tri kupona skupi i naočale pokupi” Briljanta i naših novina
Novo, 114. kolo našeg nagradnog natječaja “Tri kupona skupi i naočale pokupi” započinje u ovom broju. I u listopadu, u suradnji s Optikom Briljant, nagrađujemo Vas dioptrijskim naočalama u vrijednosti od 70 eura. Podsjećamo, kako biste sudjelovali u nagradnoj igri, trebate skupiti tri kupona koje objavljujemo u sljedećem i narednim trima brojevima. Džoker-kuponom, koji izlazi nakon triju redovnih, mijenja se jedan od propuštenih. Skupljene kupone od 11. listopada možete donijeti osobno u kuverti u naše sjedište u centru Čakovca, Kralja Tomislava 2 (haustor pokraj Bipe)
ili poslati poštom s naznakom “Za nagradni natječaj – Tri kupona skupi i naočale pokupi”, na adresu Media novine, K. Tomislava 2, Čakovec najkasnije do utorka, 22. listopada. Sretnog dobitnika 114. kola objavljujemo u Međimurskim novinama 25. listopada. (mk)
GLAVNI UREDNIK: Tomislav Novak (mail: tnovak@mnovine.hr); NOVINARI I SURADNICI: Sanja Heric - izvršna urednica (sanja@mnovine.hr), Božena Malekoci-Oletić (bozena.malekoci@mnovine.hr), Josip Šimunko (josip.simunko@mnovine.hr), Roberto Dežđek (roberto@mnovine.hr), Roberta Radović (roberta@mnovine.hr), Vlasta Vugrinec (vlasta@mnovine.hr); Lektura: Kristina Knezović; FOTOGRAF: Zlatko Vrzan (zlatko.vrzan@mnovine.hr); Marketing i prodaja oglasnog prostora: marketing@mnovine.hr Martina Korent (mob: 095 4323 603, martina@mnovine.hr), Snježana Zorković (mob: 095 4323 600, snjezana@mnovine.hr); Mali oglasi, natječaji, osmrtnice, pretplata i distribucija: Dijana Deban (mob: 097 7087 246, mail: oglasnik@ mnovine.hr, dijana@mnovine.hr); GRAFIKA: Matija Klekar, Anamarija Pranjić; UPRAVA: Tomislav Novak, Dejan Horvat; TISAK: Tiskara Zagreb d.o.o.
Web portal: mnovine.hr; Facebook stranica: MedimurskeNovine; Instagram pro�il: medimurskenovine
Žiroračun: Privredna banka Zagreb d.d., IBAN: HR5523400091110556216, SWIFT: PBZGHR2X, mail: info@mnovine.hr Sadržaj i vizualni identitet zabranjeno je mijenjati; objavljivati, prenositi, prodavati, prikazivati, prerađivati, kopirati ili na bilo koji drugi način iskorištavati bez odobrenja Media Novina d.o o.



















Paula Levačić prva pratilja, a Laura Dasović Miss Međimurja
Paula Levačić iz Čakovca naša je nova prva pratilja Miss Međimurja. Njena motivacija proizašla je iz ljubavi prema modi i želje za ostvarenjem snova iz djetinjstva. S naglaskom na borbu protiv nasilja nad ženama, planira iskoristiti svoju novu titulu kako bi promovirala važnost unutarnje ljepote i samopouzdanja. Njezina upornost i ambicija služit će kao inspiracija mnogim mladim djevojkama. Paura Levačić na slici pozira s Miss Međimurja Laurom Dasović iz Zagreba. (Jelena Tomašić)


Petak,
4. listopada
10:00 - 16:00
Dan policije i svečana akademija SRC, u slučaju kiše
dvorana GOC
16:30
Otvorenje fes�vala Murski cimeri
Centar za kulturu Rudar, Mursko Središće
16:45
Dramska sekcija KUD-a "Nikola Tesla" - Zagreb: "Kaj sme?
Centar za kulturu Rudar, Mursko Središće
18:00
KUU LIPA Gornji Mihaljevec: "Ljubav s dva lica"
Centar za kulturu Rudar, Mursko Središće
18:00
Jedanaes� strip fes�val
Mul�medijalna dvorana
Riznice Međimurja
5. listopada
8:00
Dani kruha i zahvale Trg Slobode, ispred Doma kulture u Prelogu
9:00
Dan ružičaste vrpce Trg republike Čakovec
11:00
Kazalište Županja - Županja: "Tamo gdje tuga spava"
Centar za kulturu Rudar, Mursko Središće
14:00
Oktoberfest Središče ob Dravi Grabe 7, Središče ob Dravi
16:00
Mažoret show
Sportska dvorana
OŠ Jože Horvata Kotoriba
Nastavak vikend vodiča na desnom stupcu.



KUU Lipa Gornji Mihaljevec nastupit će s predstavom
Ljubav s dva lica
MURSKI CIMERI u Murskom Središću u tri dana
Grad Mursko Središće nadolazećeg će vikenda ponovo biti kazališno središte Hrvatske i bit će domaćin Trećeg festivala hrvatske pučke drame Murski cimeri. Dvanaest najboljih pučkih drama izvest će se na kazališnim daskama Centra za kulturu Rudar, a kazalištarci
će se tri dana družiti na sjeveru Hrvatske i upoznavati vrijednosti Murskog Središća i Međimurja. Otvorenje festivala je u petak, 4. listopada u 16:30, a proglašenje pobjednika u nedjelju, 6. listopada u 18:00. Ulaz na sve predstave je besplatan. (sh)
11. FESTIVAL STRIPA u Čakovcu
U Multimedijalnoj dvorani Riznice Međimurja, od 4. do 27. listopada 2024., održat će se izložba "Hrvatski strip i reklame" koja predstavlja treće izdanje ovogodišnjeg 11. Festivala stripa udruge STRIPoblaČAK. Autor izložbe, Veljko Krulčić, istražuje povezanost između stripa i reklamne industrije, otkrivajući kako je ovaj oblik umjetnosti onaj koji spaja likovnost i književnost. Među tridesetak istaknutih crtača, kao što su Žarko
Beker i Andrija Maurović, posjetitelji će imati priliku vidjeti raznolike strip-reklame koje su inspirirale mnoge umjetnike. Krulčićeva monogra�ija "Maurović: od Mula do Mula" dodatno obogaćuje kontekst izložbe, ističući značaj Andrije Maurovića kao pionira hrvatskog stripa. Na otvorenju izložbe, prisutni će moći uživati u diskusijama s autorom i drugim istaknutim osobama iz svijeta stripa.
(Jelena Tomašić)
Dobitnik knjige Što je s mojom mačkom? objavljene u prošlom broju je Marina Zorković iz Šenkovca. Molimo da knjigu podignete u redakciji Međimurskih novina u roku od deset dana od dana objave imena dobitnika. kupon br. 1516

Ime i prezime: Ulica i kućni broj:
Mjesto i poštanski broj:
Broj telefona:
Yoav Blum: Vodič za dane koji dolaze

Međimurske novine poklanjaju knjigu jednom čitatelju. Ispunite nagradni kupon i pošaljite na adresu: Međimurske novine, Kralja Tomislava 2, 40000 Čakovec ili na mail : oglasnik@mnovine.hr ili donesite osobno u redakciju NAJKASNIJE SRIJEDA DO 15 SATI

Ispunjavanjem kupona pošiljatelj daje privolu da njegove podatke Media novine d.o.o. smiju koristiti za unos u zbirku osobnih podataka i njihovo obrađivanje, a sa svrhom sudjelovanja u nagradnom natječaju. Rok za podizanje knjige 10 dana od objave dobitnika.
Bivši knjižničar, a sada “obogaćivač tekstova na portalima”, Ben Schwartzman sasvim je običan mladić koji vodi prilično jednoličan život.
Jednoga dana doznaje da mu je Haim Wolff, starac s kojim se sprijateljio u domu za starije osobe, nakon smr� ostavio bocu skupog viskija.
A Ben čak ni ne pije alkohol! Sasvim slučajno na naljepnici na boci otkriva poruku koja ga zaintrigira i upu� u jedan neobičan pub.
Ondje upoznaje dvije žene, Osnat i Venture, koje mu otkrivaju nevjerojatnu priču i svijet prepun fantas�čnih mogućnos� koje mu je Haim ostavio u nasljeđe…

Program Murskih cimera u tri dana Petak, 4. listopada
• 16:45 - Dramska sekcija KUD-a Nikola Tesla, Zagreb: "Kaj sme" - 30 min
• 18:00 - KUU Lipa Gornji Mihaljevec: "Ljubav s dva lica" - 60 min
• 19:30 - Bjelovarski slavuji Fakini Bjelovar: "Pretakanje vina" - 45 min
• 20:45 - Kazališno-dramska udruga Drski Viljevo: "čaruga putuje" - 45 min
• 21:45 - Okrugli stol
Subota, 5. listopada
• 11:00 - HKU Vlaznice, Županja: "Ubava" - 55 min
• 14:00 - Kazalište Županja: "Tamo gdje tuga spava" - 65 min
• 15:45 - Dramska sekcija Odande Donde HKUD-a Peruča: "Ukazanje" - 70 min
• 17:30 - KUD Družina - Dramska sekcija, Robinja: "Paška robinjica" - 35 min
• 18:45 - Zelinsko amatersko kazalište ZAmKa: "Svakog gosta tri dana dosta" - 60 min
• 20:15 - Okrugli stol
Nedjelja, 6. listopada
• 11:30 - Kazališna skupina A je to Češka Beseda: "Na vesnici hladu nebude" - 45 min
• 13:00 - Glumišna družina Virje & Književno-medijski kutak KUD-a Ivan Trnski Novigrad Podravski: "V(ina) doo" - 60 min
• 15:00 - Dramska sekcija Videki KUD-a Marof - Novi Marof: "Zora" - 45 min
• 16:00 - Okrugli stol
• 18:00 - Proglašenje nominacija i nagrada, zatvaranje fes�vala
DAN RUŽIČASTE VRPCE u Čakovcu
Listopad je posvećen borbi protiv raka dojke, a vrhunac tog mjeseca predstavlja Dan ružičaste vrpce, koji se obilježava svake prve subote u listopadu. Povodom Dana ružičaste vrpce članice kluba Nova Nada, kao i drugi članovi klubova Lige uz brojne podupiratelje, okupit će se kod svog štanda na Trgu Republike u Čakovcu u subotu, 5. listopada 2024., od 9 do 12 sati te će dijeliti promotivno-edukativne materijale i izložiti svoje radove, pa pozivamo građane da nam
se pridruže i daju podršku svim ženama koje se bore s ovom bolešću i nastoje je pobijediti. Budući da se dugi niz godina u povodu Dana ružičaste vrpce u Hrvatskoj i Međimurju organizirala i šetnja gradom, ove godine će u suradnji sa Zavodom za javno zdravstvo Međimurske županije ponovno organizirati “Ružičastu turu hodanja“ kroz centar grada i po Perivoju Zrinski. Dužina ture je oko 1,5 kilometar. Hodanje će započeti u 9:30 na Trgu Republike u Čakovcu. (Jelena Tomašić)

Briljantan, originalan i duhovit roman svakom novom stranicom osvaja čitatelja, a na samome kraju otkriva svu svoju izvanrednost. Potiče nas na razmišljanje o smislu života i onome što je, na kraju svega, doista jedino važno
...nastavak vikend vodiča Nedjelja, 6. listopada
15:00
Dramska sekcija "Videki" KUD-a "Marof" - Novi Marof: "Zora" Centar za kulturu Rudar, Mursko Središće
Utorak, 8. listopada
18:00
Kulinarska radionica: Lumpije, filipinska verzija prolejtnih rolica Pučko otvoreno učilište Čakovec
Četvrtak, 10. listopada 19:00
Otvorenje izložbe Međimurski gasterbajteri Metalska jezgra Čakovec Subota, 12. listopada 09:00
Fes�val okusa - Taste Fest Ulica Ma�ce hrvatske (između zgrade Scheier i Doma sindikata) 10:00
Dani zahvalnos� za plodove zemlje MESAP, Nedelišće Utorak, 15. listopada
Mjesec hrvatske knjige Gradska knjižnica "Nikola Zrinski" u Čakovcu Subota, 19. listopada 11:00 3. Otvoreni “Dragon boat“ Marina Prelog
Najavite događaj! Sve informacije šaljite na e-mail: vikend@mnovine.hr


































CENTAR ZA KULTURU Čakovec prestavio program za jesen / zimu 2024.
Jesensko-zimski program CZK-a Čakovec nudi bogatstvo glazbe, plesa i kazališta
Piše: Jelena Tomašić
Ljubitelji kulture, obratite pozornost! Centar za kulturu Čakovec sprema nezaboravnu jesen punu kazališnih užitaka, �ilmskih projekcija i glazbenih doživljaja. Bogat jesensko-zimski program koji će zadovoljiti i najzahtjevnije ukuse predstavljen je na konferenciji za novinare u utorak, 1. listopada. Detalje programa koji će obogatiti kulturnu scenu Međimurja otkrili su nam voditeljica marketinga Lana Androić Šarić, ravnateljica Helga Lajtman, uz svoje suradnike Romana Bogdana, Marinu Kukolić i Tamaru Korunek Lesar. U narednoj sezoni, kazalište donosi niz uzbudljivih predstava koje će oduševiti mlade gledatelje i njihove obitelji. Posebno se ističe 27. Susret profesionalnih kazališta za djecu i mlade, pod okriljem HC-a Assitej, koji će se održati u listopadu. Očekuje vas deset sasvim različitih predstava koje pokazuju da kazalište za djecu i mlade mora progovarati o velikim i važnim te samo naizgled nevažnim mladenačkim i dječjim temama, i to na sve moguće izvedbene načine.
Što vas čeka na Tribini ČČ?
Bit će zanimljivo i na Tribini Čakovec četvrtkom i to već 10. listopada s početkom u 20 sati s predstavom Sutra to možeš biti ti, u izvedbi Kazališta Virovitica. Potom je 17. listopada na redu predstava Krivi Bily s Inishmaana u izvedbi Gavelle iz Zagreba u koprodukciji s Kazalištem Virovitica. No ni to nije sve. Tjedan kasnije, 24. listopada, čeka vas premijera predstave Grad složenog stanja domaćina Kazališne skupine Pinklec. Kazalište Moruzgva iz Zagreba pak u tjednu iza toga, 14. listopada, dolazi u goste s predstavom Prekid preko veze. Peti prosinac rezerviran je
za Dane satire Kerekeš teatra iz Varaždina.
Što se tiče �ilma na tribini ČČ, čekaju vas �ilmovi redatelja Danila Šerberdžije pod nazivom Dražen 31. listopada, potom Proslava redatelja Brune Ankovića 7. studenog i na kraju 12. prosinca dokumentarni �ilm Naša djeca Silvestra Kolbasa. Jedan od najzanimljivijih bit će svakako �ilm Dražen, koji prati prosljavljenog hrvatskog košarkaša Dražena Petrovića i prati Dražena od njegovih mladih dana koje je proveo u Zagrebu pa sve do odlaska u Sjedinjene Američke Države gdje je igrao u NBA ligi. U povodu 30 godina Udruženja arhitekata Međimurja očekuje vas otvorenje izložbe pod nazivom Izložba 30 godina UAM-a koja će biti otvorena od 8. studenog do 1. prosinca. Nakon toga na pozornicu stupa Lucija Berdin koja će se javnosti predstaviti izložbom Transformacije sjećanja. Otvorenje izložbe zakazano je za 5. prosinac, a razgledat će se moći do 15. siječnja 2025.
30. Jazz fair u tri dana
CZK će ove godine biti domaćin jubilarnog 30. Jazz Faira, koji će trajati tri dana, od 21. do 23. studenoga. Program započinje s Kelly Green/ Jean John Triom 21. studenog, koji će izvesti jazz standarde i autorsku glazbu. Sljedeći dan, 22. studenog, na scenu stupa Clemens Christian Pötzsch,


Marko Tolja podarit će nam koncert Dear Mr. Sinatra u sklopu Jazz Faira (Foto: Pixsell/ Sanjin Strukic)
njemački suvremeni pijanist poznat po kombinaciji klasične, jazz i elektronske glazbe. Posljednjeg dana festivala, 23. studenog, nastupit će Marko Tolja sa svojim septetom u koncertu "Dear Mr. Sinatra", gdje će oživjeti legendarne hitove Franka Sinatre.
Zvuk klasike u dvorani Zrinski/ Scheier Prve subote u mjesecu, 5. listopada u 20 sati, u Dvorani Scheier/Zrinski očekuje nas prvi koncert sezone u našem ciklusu Zvuk klasike na kojem ćemo slušati Ansambl Responsorium.
Na kraju Mjeseca međimurske popevke Centar za kulturu organizira koncert koji je ujedno zamišljen kao završnica svih događanja u našoj županiji, vezanih uz temu međimurske popevke. Koncert će otvoriti jedna od naših ponajboljih
izvođačica izvorne međimurske popevke Cecilija Merkač Hudopisk, dok će u ostatku glazbene večeri nastupiti popularni Cinkuši te jedna od izvođačica međimurske popevke mlađe generacije, Patricija Juračić, članica KUD-a Belica.
U petak, 25. listopada, u 19 sati u Dvorani Scheier/ Zrinski zasvirat će ansambl Glazbene staze. Ovaj kvintet je tzv. Pierrot ansambl koji uključuje �lautu, klarinet, violinu, violončelo i klavir. Članovi ansambla su vrsni komorni glazbenici i solisti, kao i glazbeni pedagozi, obrazovani na muzičkim akademijama u Hrvatskoj i inozemstvu.
Na samo Nikolinje Dvorana Scheier ugostit će domaćeg akademskog pijanista Davida Vukovića, koji će održati recital donoseći sa sobom bogato iskustvo i brojne nagrade s natjecanja.
Orašar, najomiljeniji božićni balet, ponovno će oživjeti u Čakovcu 20. prosinca
U međuvremenu, projekt "Moje malo kino" nastavlja poticati �ilmsku pismenost među mladima kroz europske �ilmske naslove i edukativne materijale. Od 5. do 8. prosinca, Kerekesh Teatar priređuje 7. Dane smijeha, s raznovrsnim komedijama koje će nas podsjetiti na snagu humora. Orašar za kraj godine Orašar, najomiljeniji božićni balet, ponovno će oživjeti u Čakovcu 20. prosinca, s izvedbom Ukrajinskog klasičnog baleta. S više od 200 predstava u posljednje dvije sezone i velikim brojem gledatelja, Orašar je istinski božićni klasik i obećava vizuale s raskošnim kostimima i dekoracijama koje će publiku očarati. Da ne kažete da vam nismo rekli, za karte se pobrinite na vrijeme.






scenarija Kristina Štebih i predsjednik
ŽIVOT NAJPOZNATIJEG SVECA uskoro na filmskom platnu
U Štrigovi započinje snimanje dokumentarnog �ilma o svetom Jeronimu. Tim je povodom održano predstavljanje scenarija dokumentarnog �ilma u prostorijama Ogranka Matice hrvatske u Čakovcu u sklopu Dana svetog Jeronima. Predsjednik Ogranka Matice hrvatske u Čakovcu naglasio je važnost popularizacije ovog sveca na nacionalnoj razini.
Autorica scenarija Kristina Štebih osvrnula se na dosadašnji rad na pripremanju �ilma u suradnji s Matkom Buvačem u ulozi budućeg redatelja. Film će trajati 45 minuta i uključivat će intervjue s domaćim i stranim
stručnjacima. Očekuje se da će promovirati turizam u Štrigovi i Međimurju te se koristiti u obrazovne svrhe. Premijera je planirana za 2025. godinu za Dane svetog Jeronima. Ovaj projekt �inancijski podržavaju Međimurska županija i Općina Štrigova, a Župa Štrigova na čelu sa župnikom Kristijanom Kuharom zajedno je s Ogrankom nositelj projekta snimanja �ilma. Župan Matija Posavec naglasio je važnost čuvanja spomena na svetog Jeronima za regionalni identitet te istaknuo napore za otvaranje interpretacijskog centra u Štrigovi. (sh)

spektakularni vatromet otvorili festival
Nastupili su Orquestra Barroca Casa da Musica, Zbor Hrvatske radio televizije, zajedno sa sopranisticom Sarom Braga Simões pod vodstvom dirigenta Laurence Cummingsa
Kako bismo oživjeli bogatu baroknu tradiciju, odlučili smo posjetiti prvi dan Varaždinskih baroknih večeri. Festival je započeo 20. rujna, a trajat će sve do 6. listopada. Svečano otvorenje održano je u ambijentu Varaždinske katedrale Uznesenja Blažene Djevice Marije, gdje je program započeo točno u 20 sati. Ove večeri nude bogat i raznolik glazbeni repertoar, obuhvaćajući djela poznatih kompozitora kao što su D. Perez, A. L. Moreira, L. Sorkočević, pa sve do majstora barokne glazbe, J. S. Bacha. Izvođači su bili Orquestra Barroca Casa da Musica i Zbor Hrvatske radio televizije, zajedno sa sopranisticom
Sarom Braga Simões, dok je umjetničko vodstvo preuzeo talentirani dirigent Laurence Cummings. Nakon što je koncert završio, uslijedilo je pravo iznenađenje koje je dodatno obogatilo večer. Iznad povijesnog središta Varaždina, gdje se nalazi gradski muzej, odjednom je izbio spektakularni glazbeni vatromet. Dok se vatromet prelijevao nebom, u pozadini se mogla čuti ‘’Oda radosti’’ Friedricha Schillera. Gosti su zatim imali priliku uživati u piću i jelu. Varaždinske barokne večeri pravo su mjesto za sve ljubitelje glazbe i kulture, a ove godine ih ne smijete propustiti. (Jelena Tomašić)

U CENTRU RUDOLFA STEINERA u Donjem Kraljevcu predstavljen roman Moč življenja književnice Petrane Sabolek iz Čakovca




Prvi roman u prozi na međimurskom kajkavskom jeziku „Moč življenja“ nakon dužeg vremena, književnice Petrane Sabolek iz Čakovca, predstavljen je prije par dana odnosno 25. rujna u Centru Rudolfa Steinera u Donjem Kraljevcu. Nakladnik je Ogranak Matice hrvatske u Čakovcu, kojemu je to 119. knjiga po redu, te je naš najveći nakladnik barem što se tiče Međimurja. Na novoj knjizi autorici su čestitali Zoran Turk, predsjednik Ogranka Matice hrvatske Čakovec, načelnik Općine Donji Kraljevec Miljenko Horvat, župan Matija Posavec i mještani Donjeg Kraljevca, odnosno prijateljice iz djetinjstva Petrane Sabolek koja je rođena u Donjem Kraljevcu.
O knjizi „Moč življenja“ su govorili recenzenti, dr. sc. Krunoslav Mikulan, dopredsjednik Ogranka matice u Čakovcu, i sam pisac, koji je postavljao pitanja autorici umjesto klasičnog govora o knjizi te književnik i nakladnik Robertino Bartolec iz Varaždina, a ulomak iz kniige pročitao je glumac iz Preloga Dejan Novak. Na kraju je ravnateljica Centra Rudolfa Steinera Dijana Posavec zahvalila u ime domaćina, a članice pjevačkog zbora udruge „Pjesma“ iz Donjeg Kraljevca otpjevale su nekoliko popevki. Autorici Petrani Sabolek to je 16. knjiga, najpoznatija je po knjigama za djecu i svojim zbirkama poezije.
Značaj višestruk
za identitet kraja
Značaj prvog romana na međimurskom kajkavskom














Izlaskom na svjetlo dana prvog romana nakon niza godina na međimurskom kajkavskom odnosno knjige „Moč življenja“ koja je neosporno umjetnički vrijedna, učinjen je paradigmatični korak k novom vrednovanju kajkavskog kao govornog jezika koji nije samo za povijest, što je dakako zasluga autorice Petrane Sabolek Piše: Josip Šimunko

jeziku nakon niza godina je višestruk, ponajprije za identitet kraja, ali i za ponovno otkrivanje kajkavskog jezika koji na taj način stiče pravo građanstva među svjetskim jezicima. Naime, kajkavski jezik kojemu se tepa da je maternji jezik, završavao je u rječnicima i zbirkama starih riječi, ili u poeziji mnogih nadarenih pjesnika, kako akademskih tako i iz naroda. Izlaskom prve proze na modernom međimurskom kajkavskom odnosno knjige „Moč življenja“ koja je neosporno umjetnički vrijedna, učinjen je paradigmatični korak k novom vrednovanju kajkavskog kao govornog jezika koji nije samo za povijest, što je dakako zasluga autorice Petrane Sabolek. To je posebno primijetio
dr. sc. Krunosloav Mikulan, koji je u napomenuo da smo na sreću svjedoci nove renesanse kajkavskog jezika i hrvatskih dijalekata, što potiče autore da pišu na kajkavskom, iako do danas ne postoji jedinstvena gramatika.
Auotrica u knjizi „Moč življenja“ zapravo progovora o svojem djetinjstvu u Donjem Kraljevcu, opisujući niz mještana Donjeg Kraljevca koje je poznavala, ponekad naivno iz dječje perspektive, a ponekad na način stvaranja vlastitog književnog svijeta ali i vlastitog čvrstog pravopisa govornog kajkavskog narječja iz Donjeg Kraljevca. Za sadržaj knjige zaslužni su i njeni prijatelji, ponajprije prijateljica iz djetinjstva Nada Zadravec kao i njen
suprug Ivo iz Donjeg Kraljevca koji danas žive u Varaždinu, te posebno Zvonko Košak, glazbenik koji danas živi u Zagrebu, koji je živa enciklopedija priča starih Kraljevčana, te prijateljice iz mladih dana s kojima se družila.
Roman se sastoji od osamnaest naizgled zasebnih priča o mještanima Donjeg Kraljevca i njihovu tešku životu, no punog duha. Riječ je o takozvanim „malim“ ljudima (sam izraz mali ljudi je zapravo sporan), koje je autorica svojim pomalo magijskim umjetničkim postupkom uzdigla do velikih ljudskih sudbina, podižući im literarni spomenik.
O čemu piše?
Naslovi pojedinih priča su: Slepi miši ili šišmiši, Pokopič
ezermešter Tomek, Lepetirčeki, tačke i gaženo zelje, Pejcek bez vuha, Fakini i bokci, Fačuk z sakramentom, „Jezuš“ stvar, Gradski štih, Raskriljena krila nečastivoga, Prokleta tombola, da nabrojimo same neke, iz kojih izvire život teške svakodnevnice, ali i autoričino emotivno i zahvalno sjećanje na baku Agatu i djeda Jožija Strahiju. Petrana Sabolek u Predreči (predgovoru) piše: - No, iz leta v leto, kak sam hodila k kraljevečki baki na ferje se bolje sam zapažala preteško življenje domaćega čovjeka. Bila je to stalna, jedna borba z preveč sakojačkoga dela: na polju, domaj, koli dece, marhe, starci, borba z siromaštvom, z vremenskim i drugim ka-
štigami kak su teški betegi ali drugo. Rođenja i smrti kak da su hodile roku pod roku, zato sam i gledala na te domače ljude z nekakvim drugim očima. Nezamislivo mi je biti na njivi koži, živeti samo za golo življenje i iz dena v den se veriti svoji zemljici z tem pokornim delom na nje i okoli nje.“
Gledajući već kao dijete kako ljudi teško žive od zemlje, Petrana Sabolek je na svoj fenomenološki način odnosno „drugim očima“ kako ona kaže, već kao dijete shvatila da nitko ne pomaže, nema pomoći odnekud, i da ljudi oko nje, a posebno žene, utjehu mogu naći samo u vjerovanju da će jednom biti bolje i u Bogu. U svemu tome, uvijek se nađu pojedinci puni duha, poput ezermeštra i veseljaka Tomeka, koji je svojim vragolijama i šalama znao nasmijati cijelo selo. Tako je kad mu je jednom župnik za jednog Božića prigovorio: “Toma, pa te nikaj ne vidim pre meši“ odmah uzvratio: “Je, veličasni, posel je posel, pak ni ja vas nikaj ne vidim v kinosali“.
Kajkavska proza Petrane Sabolek čita se lagano, razumljiva je i životna. Svakako će biti i edukativna mlađoj generaciji koja pomalo zaboravlja svoj maternji jezik, a starijima uspomena na sredinu i drugu polovicu dvadesetog stoljeća, te vrijedan doprinos univerzumu maternje kajkavske riječi, a mještanima Donjeg Kraljevca i Međimurja spomenik jednog vremena, ali i način čuvanja baštine i identiteta.












Đurkin d.o.o.
































Kroz pravilno planiranje i optimizaciju, možete osigurati udobnost, smanjiti troškove grijanja i poboljšati energetsku učinkovitost vašeg doma. Evo nekoliko savjeta:

Izolacija zidova i stropova povećava energetski učinak i smanjuje gubitak topline
Zamjena prozora kvalitetnijima s dvostrukim ili trostrukim staklom također značajno smanjuje gubitke topline
Korištenje pametnih termostata omogućuje automatsko podešavanje temperature prema vašim navikama i smanjuje potrošnju i kada niste kod kuće

Redovito održavanje sustava grijanja povećava učinkovitost i trajnost vašeg sustava
Analiziranje potrošnje energije i pronalaženje načina za optimizaciju troškova, kao što su �leksibilni tarifni sustavi
Sustavi grijanja su ključni za udobnost u našim domovima, a postoji nekoliko različitih tipova koji se koriste, ovisno o potrebama, dostupnosti energenata i ekološkim faktorima. Svaki sustav grijanja ima svoje prednosti i mane, a izbor će ovisiti o speci�ičnim potrebama, budžetu i dostupnosti energenata.
Odabir sustava grijanja uvijek bi trebao uključivati analizu lokalnih uvjeta i resursa kako bi se našlo najbolje rješenje za vašu speci�ičnu situaciju.
Evo pregleda različitih sustava grijanja s prednostima i nedostacima:
1. Kotlovi i bojleri na plin
Prednosti:
- Učinkoviti i brzo zagrijavaju prostore
- Manji troškovi rada u usporedbi s električnim sustavima
- Čista energija s niskim emisijama
Nedostaci:
- Ovisnost o fosilnim gorivima


Razumijevanje prednosti i nedostataka svakog sustava pomoći će vam u donošenju informirane odluke

- Potrebna infrastruktura za plin
- Moguće promjene cijena plina
2. Kotlovi i peći na drvo ili pelete
Prednosti:
- Obnovljivi izvor energije, ekološki prihvatljiv
- Mogu biti jeftiniji od drugih goriva
- Udoban i prirodan izvor topline
Nedostaci:
- Potrebno je više održavanja
- Zahtijevaju prostor za skladištenje goriva
- Emisije CO2 i čestica pri sagorijevanju


3. Toplinske pumpe
Prednosti:
- Visoka energetska učinkovitost i manji troškovi rada
- Koriste obnovljive izvore (zrak, voda, tlo)
- Mogu raditi kao sustavi grijanja i hlađenja
Nedostaci:
- Visoki početni troškovi instalacije
- Manja učinkovitost pri vrlo niskim temperaturama (zračne pumpe)
- Potrebna dodatna oprema za geotermalne sustave


4. Električni radijatori
Prednosti:
- Jednostavna instalacija i minimalno održavanje
- Brzo grijanje prostora
- Mogu se koristiti s obnovljivim izvorima (npr. solarna energija)
Nedostaci:
- Visoki troškovi rada, posebno u područjima s visokim cijenama struje
- Ovisnost o električnoj mreži
- Mogu stvoriti neujednačenu temperaturu





5. Solarni sustavi grijanja
Prednosti:
- Niski troškovi rada nakon instalacije

- Koriste obnovljivu energiju i smanjuju emisije
- Dugoročno smanjenje troškova grijanja
Nedostaci:
- Visoki početni troškovi instalacije
- Ovisnost o vremenskim uvjetima (manja učinkovitost tijekom oblačnih dana)
- Potrebna dodatna oprema za skladištenje

6. Hibridni sustavi
Prednosti:
- Fleksibilnost u odabiru izvora energije
- Optimizacija troškova grijanja ovisno o sezoni i cijenama energenata
- Mogu kombinirati prednosti različitih sustava
Nedostaci:
- Složena instalacija i veći početni troškovi
- Potrebna dodatna održavanja zbog više komponenti
- Moguće poteškoće u upravljanju sustavom


Svi naši potrošači mogu biti sigurni da su osigurane dovoljne količine plina za predstojeću sezonu uz povoljne uvjete koji nas stavljaju u prednost pred drugim dobavljačima
Preko noći snizile su se temperature, i prektički s plus 35 i više, pa smo iz sezone hlađenja naglo ušli smo u sezonu grijanja, koja traje već od sredine rujna. U Međimurju, grijanje na plin i dalje se pokazuje kao najisplativiji izbor. Prelazak na obnovljive izvore energije tek se razvija i trebat će mnogo vremena da postane široko primjenjiv, pa plin i dalje ostaje ostaje ključan energent. Njegova dostupnost u gotovo svakom domaćinstvu u regiji, zahvaljujući razgranatoj mreži i sigurnoj opskrbi, osigurava ga kao primarni izvor grijanja. Tvrtku Međimurje-plin možemo opisati kao najdugovječnijeg i najpouzdanijeg oskrbljivača plinom u Međimurju zbog svoje bogate povijesti, kontinuiranog ulaganja u infrastrukturu i nepokolebljive predanosti sigurnoj i stabilnoj opskrbi. Kao vodeća energetska kompanija u regiji, Međimurje-plin pruža
plin kućanstvima i poslovnim korisnicima desetljećima, gradeći pritom snažnu mrežu distribucije koja pokriva svaki kutak Međimurske županije. Kroz godine su se dokazali kao partner od povjerenja, čak i u vremenima energetske krize, osiguravajući neprekidnu opskrbu plinom i stabilne cijene. Njihova sposobnost prilagodbe tržišnim izazovima, transparentnost prema korisnicima i stalna nastojanja da unaprijede usluge, učinili su ih temeljem energetske sigurnosti u regiji. Uz dugogodišnje iskustvo i vodeću ulogu u sektoru, Međimurje-plin nije
"U Međimurju grijanje na plin i dalje je najisplativiji izbor.



samo opskrbljivač plinom, već i ključni akter u održivom razvoju energetike, pružajući svojim korisnicima pouzdanu i pristupačnu energiju kroz generacije. S obzirom na rastuće troškove života, važno je razmisliti kako e�ikasno koristiti plin i smanjiti potrošnju. Pitali smo Nenada Hranilovića, direktora Međimurje plina što možemo očekivati tijekom ove sezone grijanja i hoće li doći do promjena cijena plina ili problema s opskrbom. Kako se Međimurje plin pripremilo za nadolazeću ložnu sezonu i koga sve opskrbljujete?
Međimurje plin je kao i pred svaku dosadašnju ložnu sezonu spremno, što podrazumijeva da su zadovoljeni svi preduvjeti da naši građani koji se griju na prirodni plin budu sigurni. Za razliku od prethodnih godina kada smo u kategoriji kućanstva opskrbljivali u javnoj usluzi na distribucijskom području Međimurja i grada Krapine te okolnih mjesta, to od 01.10.listopada 2024. opskrbljujemo temeljem tržišnih ugovora koji su za 90
Nenad Hranilović, direktor Međimurje plina kaže da je cijena plina iz Ugovora o opskrbi plinom za 90 centi niža od cijena javne usluge
centi niži od cijena u javnoj usluzi. Novost je ove godine usluga opskrbe plinom na području Grada Zagreba, Velike Gorice i Zaprešića gdje smo sukladno Odluci HERA-e, nakon provedenog natječaja od strane HERA-e, kao najpovoljniji ponuditelj određen za opskrbljivača plinom u obvezi javne usluge od 01.listopada 2024. do 30. rujna 2027. godine. Mogu li stanovnici Međimurja biti sigurni da neće biti nestašice plina? Osigurane se u dovoljne količine plina, zakupljen je transport, osigurani su i dodatni paketa kapaciteta u skladištima plina te time Međimurci kao i građani i poduzeća ostalog dijela Republike Hrvatske mogu biti sigurni. Hoće li biti promjena u cijenama plina za kućanstva i poslovne korisnike ove sezone?
Cijena plina je iz Ugovora o opskrbi plinom koja je za 90 centi niža od cijena javne usluge a cijene za poduzetništva određene su sukladno tržišnim uvjetima i kretanjima cijene plina na burzama.
Međimurje-plin d.o.o. Obrtnička 4, Čakovec T: +385 40 395 199 prijava kvara E: medjimurje-plin@medjimurje-plin.hr www.medjimurje-plin.hr INFO
Sjedište Međimurje plina u Čakovcu






Stalno se ulaže i provjerava oprema, kako bi distribucija tekla nesmetano
"Međimurje-plin je osigurao dovoljne količine plina za cijelu zimsku sezonu
Kakvi su Međimurci potrošači?
Jesu li i kod toga štedljivi kao kod svega i primjenjuju li korake za štednju energije?
- Međimurci su zahvalni potrošači i za to im zahvaljujemo. Naravno da vode računa o optimalnoj potrošnji držeći se naših savjeta kao što su: održavanje optimalne temperature u pojedinim prostorijama, njihovo kratko provjetravanje, redovito održavanje svojih trošila i bojlere, a nisu ni zanemariva ulaganja u izolaciju objekata.



1. Ne spuštati temperaturu ispod 15 stupnjeva, a zimi provjetravati dva puta dnevno po tri minute
Za optimalnu potrošnju plina moramo uzeti u obzir više elemenata koji presudno utječu na potrošnju plina, a to su: željena temperatura životnog prostora, duljina boravka u prostoru, vlažnost zraka i, prije svega, stanje i vrsta građevinskog objekta. Temperatura prostora uvelike utječe na potrošnju plina. Optimalna temperatura u prostoru u kojemu se duže boravi je 20 °C (u rasponu od 18 do 22 °C). Za svaki stupanj povećanja prosječne temperature prostora u ovom rasponu povećava se potrošnja energenta za oko 5 %. Jako je važno ne spuštati temperaturu ispod 15 °C jer se ispod te temperature značajno ohlade zidovi i pod pa se kod ponovnog dizanja temperature na optimalnih 20 °C troši značajno više energije nego kad se prostor samo dogrijava za od 2 do 3 °C. Značajno se više energije troši za zagrijavanje prostora sa smanjenim udjelom kisika u zraku i povećanom vlagom pa je potrebno provjetravati prostor najmanje dva puta dnevno po tri minute. Toliko je potrebno da se zrak zamijeni svježim, a zidovi se ne ohlade. Za optimalnu potrošnju važno je plinska trošila održavati ispravnim i paziti da trošilo ima dovoljnu količinu zraka za izgaranje i ispravan odvod dimnih plinova kako bi iskoristivost energenta bila što je moguće viša. To se prije svega odnosi na starija trošila (ne na kondenzacijska), kojih je još uvijek većina. Dobra izolacija zidova, fasada i kvalitetni prozori mogu donijeti uštede i do 40 posto.
2. Akontacijski način plaćanja manje narušava kućni budžet
Akontacijski način plaćanja potrošnje plina ima prednost jer se plaćanje u takozvanom zimskom polugodištu obavlja u jednakim ratama pa se izbjegavaju veliki računi za mjesec ili dva s izrazito niskim temperaturama. Tako se ne narušava kućni budžet, ali se mogu pojaviti pozitivne ili negativne razlike na kraju obračun-
skog razdoblja, ovisno o tome je li zima značajno toplija ili hladnija od prethodne. Plaćanje prema mjesečnoj potrošnji usluga je koju u Republici Hrvatskoj, od opskrbljivača plinom, pruža jedino Međimurje-plin, a time naši potrošači mogu intervenirati – kod velikih računa smanji se grijanje za koji stupanj (smanjenje prosječne temperature u stanu za 1 °C može donijeti i smanjenje potrošnje plina i do 6 % zimi). Hoće li plaćati akontacijski ili mjesečno, odlučuje svaki građanin.
3. Prirodni je plin najisplativiji za kućanstva Sagledavajući sve prednosti i nedostatke pojedinih energenata kojima se koristimo za zagrijavanje prostora u kućanstvu, prirodni je plin najisplativiji energent i to zbog više razloga: konkurentan je cijenom svim drugim energentima, pogotovo ako uzmemo u obzir jednostavnost uporabe, dostupan je u svako doba te se njime koristimo samo kad ga trebamo, plaćamo ga nakon potrošnje i to točno onoliko koliko smo ga potrošili, dakle, ne moraju se stvarati zalihe koje se plaćaju unaprijed kao kod svih drugih energenata osim el. energije. Ne trebaju nam skladišta ni posude, planiranje potrošnje unaprijed, a ni osiguranje značajnih sredstava za kupnju energenta odjednom za ložnu sezonu. Uporaba prirodnog plina vrlo je jednostavna i započinje regulacijom termostata na željenu temperaturu ili čak daljinskom regulacijom (pametne kuće). Prirodni plin je i ekološki najprihvatljiviji fosilni energent jer metan sagorijeva gotovo u potpunosti, a da pri tome na nastaje pepeo i ima manju emisiju CO2 od drugih energenata i gotovo stopostotnu iskoristivost kod novih kondenzacijskih uređaja.
4. Kondenzacijska trošila najbolja su opcija za budućnost Europskim, pa tako i našim hrvatskim zakonima, regulirano je da se kod novih, kao i u rekonstruiranim građevinskim objektima, mogu ugrađivati samo kondenzacijska plinska trošila
koja imaju i do 97 % iskoristivosti utrošenog plina i neusporedivo su sigurnija jer ne uzimaju potreban zrak za izgaranje iz prostora, već se isti zatvorenim sustavom dovodi izvana. Uz značajnu povećanu e�ikasnost iskoristivosti prirodnog plina jednako je važna, pogotovo za budućnost, i ekološka komponenta uporabe takvih trošila koja su pogodna za sve načine grijanja: klasično radijatorsko, podno, kombinirano kao i u kombinaciji sa solarnom tehnologijom ili energetskim pumpama.
5. Ne treba grijati sve sobe jednako. Optimalne temperature grijanja ovise o namjeni prostora
Optimalna temperatura u prostoru u kojem boravimo različita je, ovisi o namjeni prostora. Za dnevni boravak i dječje sobe optimalna je temperatura 20 – 23 °C, u kupaonici 23 °C, u kuhinji 18 – 20 °C, a u spavaćoj sobi 15 – 18 °C. Takozvana noćna temperatura ne bi se trebala spuštati ispod 18 °C, osim u spavaćoj sobi. Prostori se moraju provjetravati jer se u prostorijama u kojima boravimo smanjuje koncentracija kisika i povećava vlažnost zraka, a takav se zrak puno teže zagrijava, a i zbog osjećaja ugode i zdravlja. Uobičajeno je dovoljno provjetravati prostore od tri do četiri puta dnevno, zimi do 5 ili 10 minuta, ovisi o potrebi, a u prijelaznom ili proljetno-jesenskom vremenu 10 – 15 minuta. Važno je naglasiti da se prostor mora provjetriti kratko i intenzivno kako se zidovi i podovi ne bi ohladili, a za njihovo ponovno zagrijavanje potrebno je više energije nego za samo održavanje dostignute temperature. 6. Dugotrajno provjetravanje „na kip“ zimi se ne preporučuje Dugotrajno provjetravanje ‘na kip’ zimi nije e�ikasno, odnosno postiže se suprotan učinak jer se zrak u prostoru mijenja sporo, a hlade se stakla i okolni dijelovi zida pa ga treba ponovno zagrijati. Kad se sve sagleda, grijanje na plin je i ekološki prihvatljivo zbog vrlo čistog izgaranja. Prirodni je plin najčišće fosilno gorivo s malom emisijom stakleničkih plinova.
akon velikog razvojnog zamašnjaka Međimurske županije, kojim su uložena dosad najveća �inancijska sredstva u energetsku obnovu javnih zgrada, poput Županijske bolnice Čakovec, Zavoda za javno zdravstvo Međimurske županije, Doma za starije i nemoćne osobe Čakovec, sportske dvorane Graditeljske škole te mnogih osnovnih i srednjih škola, Županija nastavlja slijediti zacrtanu strategiju, otvarajući novi projektni ciklus usmjeren povećanju otpornosti na klimatske promjene. Župan Međimurske županija Matija Posavec podsjeća da je riječ o višemilijunskim ulaganjima u krajobrazna uređenja koji će potpuno promijeniti vizuru čak 30 lokacija diljem Međimurja. - Započeli smo novi investicijski ciklus koji će promijeniti lice Međimurja te otvorene prostore uz naše javne ustanove učiniti ugodnijim za boravak ljudi. U ovom ciklusu iz domene zelene tranzicije, odnosno projekata vezanih uz otpornosti na klimatske promjene, kvalitetnim projektnim konceptima osigurali smo sredstava za 30 lokacija diljem Međimurja koje ćemo ozeleniti, obnoviti i urediti te im dati nove namjene. Upravo započinje uređenje parka u krugu naših zdravstvenih ustanova te parka kod Ekonomske i trgovačke škole i Gimnazije Josipa Slavenskog te nastavljamo s parkom u Centru znanja Međimurske županije, zatim kod Tehničke i Graditeljske škole, kao i na prilazu Starom gradu iz pravca Trga Republike. Također, uredit će se park kod Matulovog grunta u Frkanovcu te površine ispred ambulanti u Murskom Središću, Goričanu i Svetoj Mariji, kao i kod Doma za odrasle osobe u Orehovici, dok se parkovi kod Doma za starije i nemoćne u Čakovcu te pripadajuće depandanse već uređuju. Novo, zeleno ruho dobit će i okoliš 13 naših škola – u Pribislavcu, Donjem Kraljevcu, Prelogu, Donjoj Dubravi, Draškovcu, Hodošanu, Kotoribi, Orehovici, Selnici, Goričanu, Svetom Jurju na Bregu, te Podturnu i Štrigovi, rekao je župan, dodavši: - Javnosti je poznato da je u pripremi i projekt formiranja najvećeg parka u ovom dijelu Europe – Zelena oaze Čakovca – u kojem će krajobrazno urediti 15 hektara zemljišta, na području bivšeg

Zavod za javno zdravstvo

vojnog kompleksa, a cjelina koju ćemo dobiti svim navedenim projektima još će snažnije opravdati epitet Međimurja kao zelene oaze u srcu Europe, kaže župan Međimurske županije Matija Posavec, istaknuvši da krajobrazne projekte prate i projekti daljnje energetske obnove javnih zgrada, prije svega, naših škola te redoviti ciklusi potpora građanima za prelazak na obnovljive izvore energije u kućanstvima.
Veliki interes građana prati javne pozive Međimurske županije za sufinanciranje korištenja obnovljivih izvora energije u obiteljskim kućama, što je županijskom rukovodstvu jasan putokaz da su potpore dobro usmjerene
Proteklih dana potpisan je ugovor o postavljanju solarnih panela na renoviranoj zgradi Zavoda za javno zdravstvo Međimurske županije, u čiju je rekonstrukciju, dogradnju i energetsku učinkovitost Županija prošle godine uložila 1,269.340

eura. Ukupna površina rekonstruiranog i dograđenog prostora doseže gotovo 2572 kvadratna metra. Kada je riječ o energetskoj obnovi paviljona IV, u kojem djeluje Zavod, prošle godine postavljena je fotonaponska elektrana i dizalica topline s priključkom za solarne panele i samostalnim priključkom na vodoopskrbni sustav, čime se u konačnici postiže i energetska neovisnost objekta. Zavod ovu veliku investiciju Međimurske županije zaokružuje postavljanjem solarnih ćelija čime će i uštede na energentima biti još veće. Ugradnja fotonaponskih ćelija na zgradi Zavoda za javno zdravstvo Međimurske županije, vrijednih 51.175 eura, pridonijet će i smanjenju onečišćenja okoliša.
Veliki interes građana
Velik interes građana prati javne pozive Međimurske županije za su�inanciranje korištenja obnovljivih izvora energije u obiteljskim kućama, što je rukovodstvu Županije jasan putokaz da su potpore dobro usmjerene. Iznos �inancijske podrške građanima raste svake godine, a raspoloživa sredstva bivaju sve brže iskorištena. Javni poziv za 2024., kojim je osigurano 100.000 eura za potpore građanima, dvostruko više nego lani, vrlo brzo je i zatvoren zbog velikog odaziva. Od ukupno 150 prijava, 129 ih je odobreno, što čini čak 86 posto zaprimljenih prijava. Zadnji javni poziv podrazumijeva instaliranje 573.06 kW fotonapona na 77 obiteljskih kuća, što će donijeti godišnju proizvodnju električne energije od 659.02 MWh koji se neće morati kupovati od opskrbljivača na tržištu. Ukupna godišnja
ušteda s tim parametrima doseže 100.000 eura, a smanjenje emisije ugljičnog dioksida za 105.000 kg. Početkom rujna Međimurska županija predstavila je rezultate tog javnog poziva za građane te je tada istaknuto da je poziv raspisan u travnju, no zatvoren je već u svibnju zbog velikog broja prijava, odnosno dosezanja planirane svote su�inanciranja. Maksimalni iznos županijske potpore iznosio je 1200 eura, a građani su mogli prijaviti su�inanciranje izrade energetskog certi�ikata i izvješća o energetskom pregledu u obiteljskim kućama, zatim su�inanciranje izrade glavnog elektrotehničkog projekta fotonaponske elektrane za proizvodnju električne energije u svojim domovima, te za su�inanciranje ugradnje sustava za korištenje obnovljivih izvora energije. Navedenim modelom potpore građanima Međimurska županija nastavlja biti primjer ostalim regijama u Hrvatskoj, ukazujući na načine kojima lokalna zajednica može aktivno pridonijeti globalnim ciljevima zaštite okoliša i održivog razvoja, a istovremeno nove tehnologije učiniti dostupnima građanima te na taj način život učiniti ugodnijim i sigurnijim. Župan Matija Posavec ističe da ovi rezultati svjedoče i o odlučnosti Međimurske županije da predvodi energetsku tranziciju Hrvatske prema održivoj budućnosti: - U okviru strategije Međimurske županije vezane uz zelenu tranziciju, izuzetno nam je važno motivirati građane na ulaganje u obnovljive izvore energije. Rezultati javnog poziva svjedoče da smo u tome uspjeli, što nam je poticaj da nastavimo nizati nove cikluse potpore i u narednim razdobljima, s još većom �inancijskom snagom, naglasio je župan. Novi ciklus ulaganja u škole U novom ciklusu energetske obnove škola kojima je osnivač Međimurska županija novo ruho, te suvremene sustave grijanja i hlađenja dobit će Gospodarska škola Čakovec, te Osnovna škola Strahoninec, kao i područni školski odjeli u Donjem Vidovcu i Dunjkovcu. U ukupnoj vrijednosti ovog investicijskog ciklusa Međimurska županija snosi 1.844.164,93 eura. Za radove u Gospodarskoj školi, ukupne vrijednosti 2.920.099,50 eura, Županija će iz proračuna izdvojiti 1.439.100,50 eura, a energetsku obnovu OŠ Strahoninec, vrijednu 944.594,56 eura, su�inancirat će sa 195.449,39 eura. Vrijednost projekta obnove područnog školskog odjela


u Donjem Vidovcu doseže 272.302,88 eura, od čega Županija su�inancira čak 41 posto, odnosno 111.958,37 eura. Radovi u Područnoj školi Dunjkovec vrijedni su 412.652,02 eura, a Međimurska županija ovu investiciju podupire s 24 posto, odnosno 97.656,67 eura. Uz izradu glavnog projekta energetske obnove, radovi na spomenutim školskim objektima podrazumijevaju stručni i projektantski nadzor građenja te koordinaciju zaštite na radu, izradu energetskog certi�ikata po obnovi, te troškove promidžbe i vidljivosti, kao i uslugu vođenja projekta i administracije. Navedene škole bit će u potpunosti obnovljene uz uvođenje suvremenih sustava koji će omogućiti značajnu uštedu energije te stvoriti znatno bolje uvjete izvođenje nastave i ugodniji boravak u školi.
Vlastitim snagama
Iako je projekt energetske obnove sportske dvorane Osnovne škole Prelog Međimurska županija uspješno prijavila za su�inanciranje, nestalo je sredstava i nije došlo do realizacije. Zato je Županija energetsku obnovu i ove dvorane, pored izgradnje sportske dvorane Osnovne škole
Župan Ma�ja Posavec is�če odlučnost Međimurske županije da predvodi energetsku tranziciju Hrvatske prema održivoj budućnos�
u Svetoj Mariji koja je pred završetkom, uzela na vlastita leđa te projekt �inancira iz vlastitih sredstava. U Prelogu je nedavno potpisan ugovor o energetskoj obnovi ovog sportskog objekta koji koriste učenici Osnovne, ali i Srednje škole Prelog, kao i brojni klubovi i građani. Stručno vodstvo nad projektom vrijednim 749.745,49 eura, povjereno je Međimurskoj energetskoj agenciji MENEA-i, a nadzor poduzeću MIN. Zahvaljujući kvalitetnoj komunikaciji i želji da ovoj vrlo korištenoj dvorani damo novi sjaj, te težnji da ulažemo u ovaj kraj, prihvatili smo izazov i započeli energetsku obnovu školske sportske dvorane u Prelogu vlastitim sredstvima“, ističe je župan, te dodaje: „I Srednju školu u Prelogu prijavili smo za su�inanciranje iz europskih fondova te se nadamo da ćemo uz su�inanciranje i ovu našu školu pretvoriti u centar izvrsnosti i kompetentnosti, pri čemu nas osobito motivira činjenica je da je ove godine povećan broj učenika u toj ustanovi te da je pohađaju i učenici iz susjednih županija, dodao je župan. Međimurska županija kontinuirano priprema projekte obnove škola i školskih sportskih dvorana kako bi se u svim obrazovnim ustanovama stvorili uvjeti za prelazak na nastavu u jednoj smjeni, te energetskim obnovama postigli bolji uvjeti i uštede. No, u tom investicijskom zamašnjaku svjedočimo predugom čekanju odobrenja iz resornog Ministarstva što koči napredne regije poput naše. Pripremljena je dokumenta-
cija za niz budućih projekata, a ranijim investicijskim ciklusima rekonstruirana je kotlovnica u Gimnaziji Josipa Slavenskog Čakovec, te obimnim zahvatom postignuto odvajanje sustava koji su ranije, desetljećima, koristile dvije škole – Gimnazija i Ekonomska i trgovačka škola. Moderni sustavi koji koriste obnovljive
"U novom ciklusu energetske obnove, škole kojima je osnivač Međimurska županija dobivaju novo ruho, a suvremene sustave grijanja i hlađenja dobit će i Gospodarska škola Čakovec te Osnovna škola Strahoninec i područni školski odjeli u Donjem Vidovcu i Dunjkovcu
izvore energije uvedeni su i u Osnovnoj školi Štrigova te područnim školskim odjelima u Prekopi, Peklenici i Zebancu. U svakoj od navedenih školskih zgrada postavljene su fotonaponske elektrane i dizalice topline. Na krovovima zgrada instalirane su fotonaponske elektrane za proizvodnju električne energije za vlastite potrebe. Projekte energetske obnove provodi Međimurska energet-
ska agencija MENEA, gdje ističu da je svaki takav zahvat na javnim zgradama višestruko pridonio dobrobiti korisnika: uz povećanu udobnost boravka u objektima, značajno su smanjeni troškovi za energente te povećan stupanj energetske samodostatnosti objekata. Na horizontu je i zelena tranzicija u Osnovnoj školi Nedelišće, projekt koji podrazumijeva izgradnju nove, energetski učinkovite školske zgrade. Međimurska županija i Općina Nedelišće �inancirale su izradu projektno-tehničke dokumentacije, vrijedne 99.650 eura.
Memorijalna zbirka
U tijeku je i realizacija novog projekta kojim će se upravo energetskom obnovom zaštititi važan objekt kulture u našem kraju – Memorijalna zbirka Ladislava Kralja Međimurca. O dragocjenoj baštini našega najvećeg slikara već 45 godina skrbi Muzej Međimurja Čakovec, a projektom energetske obnove vrijednim 226.402 eura, uz 95 posto su�inanciranja, ambijent kuće, u kojoj je slikar živio i stvarao, postat će ugodniji te će se znatno poboljšati mikroklimatski uvjeti važni za očuvanje eksponata. Projekt će biti okončan početkom 2026. godine, te će se u prostoru zamijeniti podovi, stolarija, elektroinstalacije i ugraditi suvremeni sustavi grijanja, uz obnovu fasade. Kraljeva kuća, prizemnica s klasicističkim obilježjima, izgrađena je koncem 19. stoljeća te je dio zaštićene kulturno-povijesne cjeline Čakovca.
Budućnost već živimo U Međimurju prema mnogim razvojnim dosezima budućnost već traje. U mnogim sferama ljudskog djelovanja i stvaranja, Međimurska županija je korak ispred ostalih regija u Hrvatskoj, a ima i područja koja nas pozicioniraju na svjetsku kartu najrazvijenijih, poput održivog turizma. U toj smo domeni jedina regija u Hrvatskoj i četvrta u svijetu ovjenčana prestižnom oznakom Green Destination za održivi turizam, a održivost je moto kojim Međimurje kroči u budućnost. Podsjetimo, Međimurska županija po osvajanju oznake Green Destination, krenula je u novo, zahtjevno certi�iciranje za stjecanje statusa bioregije. Kada dosegnemo i taj status, naša visokokvalitetna hrana imat će daleko veće šanse za plasman na svjetskom tržištu, a poljoprivredni proizvođači novi razvojni impuls. Sve je to dio zelene tranzicije Međimurja. U tom su smislu i sva ulaganja u energetsku obnovu javnih zgrada, kao i podizanje svijesti te pomoć građanima u prelasku na održive oblike energije dio našega putovanja na još višu razvojnu razinu u skladu s izazovima koje pred nas stavljaju klimatske promjene te zaštita okoliša.
Solarni paneli prekrivaju sve više javih zgrada u našem kraju


Međimurska energetska agencija d.o.o. posluje još od 2008. godine kada je osnovana na inicijativu Međimurske županije i ondašnje Regionalne razvojne agencije Međimurje REDEA d.o.o. (današnje Javne ustanove za razvoj Međimurske županije REDEA) kao centralna organizacija specijalizirala za obavljanje širokog spektra aktivnosti iz područja energetike te je kroz godine zahvaljujući motiviranom, marljivom i predanom radu mladog tima visokoobrazovnih stručnjaka postala središnje mjesto za pružanje potpore i informacija javnom i privatnom sektoru te široj javnosti o potencijalima korištenja obnovljivih izvora energije (OIE) i povećanju energetske učinkovitosti u svim sektorima potrošnje energije na razini županije, a nerijetko i šire. Zbog stalnog povećanja obujma posla kontinuirano zapošljavamo te pozivamo zainteresirane kandidate da nam se jave i steknu znanje i iskustvo upravo u zelenim i održivim temama. Agencija je osnovana uz potporu programa Intelligent Energy Europe (IEE) koji podupire politike EU-a u području energetske učinkovitosti i obnovljive energije. S obzirom na to da su sredstva programa bila dovoljna samo za funkcioniranje Agencije u prve tri godine njezinog poslovanja, Agencija se osim uobičajenih aktivnosti pružanja stručne i tehničke podrške Međimurskoj županiji, ostalim dionicima iz javnog i privatnog sektora počela aktivno uključivati u pripremu i prijavu prekograničnih i transnacionalnih projekata �inanciranih iz različitih EU fondova koji pokrivaju širok spektar tema i bave se ključnim problemima današnjice, a to su energetsko siromaštvo, energetska učinkovitost u svim sektorima potrošnje (zgrade, promet, ostala energetska infrastruktura), korištenje obnovljivih izvora energije i prilagodba štetnim utjecajima trenutne energetske i klimatske krize. U tijeku sedam EU projekata Samo u 2024. godini, Agencija provodi sedam projekata �inanciranih iz EU fondova, i to redom iz Interreg programa Slovenija – Hrvatska 2021. – 2027., programa transnacionalne suradnje dunavske regije 2021. - 2027., programa transnacionalne suradnje Središnja Europa i programa LIFE: 2021. - 2027.. Na dva projekta Agencija ima ulogu vodećeg partnera što znači da ima ključnu ulogu u osmišljavanju i koordinaciji cijelog projekta te usmjerava projektno partnerstvo prema postizanju de�iniranih projektnih ciljeva, dok je na preostalih pet projekata projektni partner i aktivno sudjeluje u implementaciji projektnih aktivnosti sukladno svojoj


Alen Višnjić, direktor Međimurske energetske agencije
stručnosti. Ukupan proračun svih sedam projekata iznosi 9.171.856,16 eura, od čega proračun Agencije iznosi 953.511,40 eura i zauzima većinski dio u ukupnom poslovanju i �inanciranju rada Agencije. Značaj navedenih projekata u pogledu povećanja energetske učinkovitosti, ali i korištenja obnovljivih izvora energije na razini Međimurske županije je zavidan prvenstveno zato jer dio projekata za sobom povlači konkretne investicije u postojeću infrastrukturu (obiteljske kuće, višestambene zgrade, javne zgrade, elektroenergetska mreža, itd.), dok se drugi dio projekata bavi energetskim i klimatskim planiranjem na regionalnoj i lokalnoj razini s posebnim fokusom na pravednu energetsku tranziciju i načelo
energetska učinkovitost na prvom mjestu te suzbijanjem energetskog siromaštva.
Od prijave do provedbe projekata za energetsku obnovu
Iako je za Agenciju sudjelovanje na EU projektima najveći izvor prihoda, Agencija je aktivno uključena i u aktivnosti izrade analiza i predlaganja objekata za energetsku obnovu i ugradnju sustava obnovljivih izvora energije, zatim u aktivnosti prijave i provedbe navedenih projekata do trenutka isplate sredstava korisnicima projekata za osnivača – Međimursku županiju i ostale zainteresirane korisnike iz javnog i privatnog sektora. Uz to, Agencija provodi i aktivnosti educiranja i informiranja šire javnosti, poduzetnika i građana o važnosti energetske učinkovitosti i korištenju obnovljivih izvora energije. Agencija to ostvaruje kroz kontinuiranu organizaciju javnih tribina, edukativnih radionica i informativnih kampanji, okruglih stolova te kroz individualna savjetovanja. S obzirom na tendenciju porasta cijena energije i na kontinuirane promjene u energetskom sektoru s aspekta zakonodavne regulative, naprednih tehnoloških rješenja i budućih energetskih potreba, predviđeno je povećanje opsega poslovanja Agencije, a time i proširenje postojećih poslovnih prostora. Na tom tragu predviđeno je otvaranje Klimatskog i energetskog centra (KEC) Međimurske energetske agencije d.o.o. u kompleksu Centra znanja Međimurske županije u jednom od četiri preostala neobnovljena objekta. Klimatski i energetski centar će prije svega biti fokusiran na područje obnovljivih izvora energije, energetske učinkovitosti, održivog razvoja te prilagodbe klimatskim promjenama. U zgradi KEC-a su predviđeni poslovni uredi različitih veličina za djelatnike Agencije, coworking prostor, showroom, soba za sa-
"Predviđeno je otvaranje Klimatskog i energetskog centra (KEC) Međimurske energetske agencije d.o.o. koji će prije svega biti fokusiran na područje obnovljivih izvora energije, energetske učinkovitosti, održivog razvoja te prilagodbe klimatskim promjenama.
stanke te ostali zajednički prostori poput kuhinje. Posebno je zanimljiv showroom prostor koji je osmišljen kao funkcionalni i prezentacijski prostor površine 110 m2, u kojem će biti izloženi najsuvremeniji sustavi iz područja energetske učinkovitosti i obnovljivih izvora energije trenutno prisutni na tržištu. Osim navedenog, u zgradi je planirana i manja konferencija dvorana za organizacijske i promotivne svrhe, čime će se dodatno otvoriti mogućnost za edukativne aktivnosti usmjerene građanima, poduzetnicima i ostalim regionalnim i lokalnim dionicima. Agencija se može pohvaliti kako su već poduzeti početni koraci kako bi Klimatski i energetski centar zaživio te je već izrađen i predan idejni projekt rekonstrukcije/sanacije zgrade budućeg KEC-a te se uskoro očekuje izrada preostale projektno-tehničke dokumentacije: glavnih i izvedbenih projekata kao i projekt unutarnjeg uređenja s 3D vizualizacijom objekta.
Može li energetska tranzicija biti pravedna prema socijalno ugroženim kućanstvima?
O utjecaju energetske tranzicije na društveni život socijalno ugroženih kućanstava i pojavu energetskog siromaštva, Međimurska energetska agencija d.o.o. se bavi u okviru projekta CEESEU-DIGIT –Dizajn i provedba regionalnih javnih ini-

cijativa za pravednu energetsku tranziciju održive energetske unije Srednje i Istočne Europe �inanciranog u okviru programa LIFE namijenjenog �inanciranju projekata na području energije, zaštite okoliša i klime. Glavni cilj projekta je između ostaloga potaknuti (socijalno) pravednu energetsku tranziciju te osigurati da ni jedan pojedinac ni regija ne budu izostavljeni u tom procesu. Koncept pravedne energetske tranzicije usko je vezan uz problem energetskog siromaštva koji se pojavljuje kada kućanstvo ne može osigurati minimalnu razinu potrošnje energije potrebne za zadovoljenje osnovnih životnih potreba i učinkovito sudjelovanje u zajednici. Energetsko siromaštvo jedan je od velikih i rastućih društvenih problema kako na nacionalnoj, tako i na regionalnoj razini te kućanstva koja su u riziku ili jesu energetski siromašna zapravo nemaju jednake mogućnosti i prilike sudjelovati u aktivnostima zajednice kao i kućanstva koja to nisu. Uz to, takva kućanstva osim što se suočavaju s visokim troškovima energije nastalim kao posljedica porasta cijena energenata imaju otežan pristup osnovnim energetskim uslugama potrebnim za normalan život (rasvjeta, grijanje, hlađenje, kuhanje i dr.). S obzirom na to da si kućanstva pogođena energetskim siromaštvom ne mogu priuštiti rekonstrukciju domova u energetskom smislu uz primjenu adekvatnih mjera povećanja energetske učinkovitosti i korištenja obnovljivih izvora energije kao i zamjenu dotrajalih i energetski neučinkovitih kućanskih aparata i uređaja, primorana su koristiti neadekvatne sustave grijanja (na ugljen, na lož ulje, stare dotrajale peći, bojleri i el. grijalice) koji su vrlo često štetni po zdravlje i okolinu.
Socijalno ugrožene kategorije stanovništva na području Međimurske županije, u koje spadaju umirovljenici, domaćinstva s niskim primanjima, samohrani roditelji s više djece, osobe s invaliditetom te primatelji socijalnih naknada su posebno podložni energetskom siromaštvu, posebice ako žive u energetski neučinkovitim objektima. Navedene kategorije stanovništva, osim korištenja postojećih mjera pomoći (primanje direktnih socijalnih naknada ili paketa pomoći, savjetovanje od strane energetskih stručnjaka, energetska obnova �inancirana iz nacionalnih fondova, itd.) mogu i samostalno implementirati male korake koji vode ka

energetski učinkovitijem svakodnevnom životu i to kroz racionalno korištenje energije te provedbom sitnih intervencija u kući kao što su zamjena postojećih žarulja LED rasvjetom, ugradnja štednih perlatora na slavine, ugradnja brtvi na prozore i vrata, korištenje re�lektirajućih folija za radijatore, itd. S obzirom da je cilj projekta CEESEU-DIGIT povećati svijest te osigurati podršku socijalno ugroženim skupinama građana, osobito onima koji su pogođeni energetskim siromaštvom, Međimurska energetska agencija d.o.o. u nastavku savjetuje građane kako promijeniti životne navike i kako na jednostavan način uštedjeti energiju u svakodnevnom životu sada kada dolazi hladnije vrijeme popraćeno većim računima za grijanje. Dio tih preporučenih mjera zahtijeva dodatna, manja ili veća ulaganja, dok je dio potpuno besplatan i primjenjiv već od danas. Na ovaj način energetski siromašna kućanstva mogu postati aktivni sudionici u energetskoj tranziciji te kroz vlastite investicije i intervencije u energetsku učinkovitost potaknuti i druge da se uključe u proces.
GRIJANJE
1. Prilikom održavanja viših temperatura zraka u prostorijama za vrijeme sezone grijanja izbjegavajte otvaranje prozora radi spuštanja temperature prostora. Toplinska ugodnost je stvar navike i osobne percepcije ugodnosti, stoga koristite obične radijatorske ventile za ručno reguliranje temperature u prostoru, a termostatske radijatorske ventile za automatsku regulaciju temperature u prostorijama. Optimalna temperatura u stambenom prostoru je 21 °C.
2. Ako smanjite temperaturu koja se održava u prostoru za samo 1 °C, godišnje
možete uštedjeti približno 5 % energije za grijanje.
3. Ako otvarate prozor na duže vrijeme potrebno je isključiti sustav grijanja ili hlađenja.
4. Redovito čistite radijatore kako bi osigurali da nečistoće ne sprečavaju prijelaz topline.
5. Redovito odzračujte radijatore i cijele instalacije kako bi se ispustio zarobljeni zrak koji se stvara nakon ljeta prilikom pražnjenja i punjenja instalacije centralnog grijanja. Ovaj postupak ćete možda morati ponoviti više puta početkom sezone grijanja.
6. Ugradnjom termostatskih radijatorskih ventila možete uštedjeti energiju čak i do 20 % (što ovisi o vrsti termostata i brzini reakcije).
7. Ugradnjom sobnog termostata mogu se smanjiti troškovi za grijanje od 7 do 15 %. Termostat se programira tako da se za vrijeme noći ili dok se ne boravi u kući temperaturu postavi na najnižu vrijednost. Sobni termostat regulira temperaturu u prostoru tako da uključuje centralno grijanje kad temperatura u prostoru padne ispod određene zadane vrijednosti.
8. Prije početka sezone grijanja, potrebno je pozvati servisera da provjeri vaše plinske ili uljne instalacije i plamenik.
9. Prije početka sezone grijanja, potrebno je pozvati ovlaštenu osobu da provjeri stanje izmjenjivača topline. Da bi se toplina proizvedena u uređaju iskoristila, potrebno je očistiti izmjenjivače topline od kamenca.
1. Za potrebe rasvjetljavanja prostorija koristite LED žarulje koje smanjuju potrošnju energije i do 90 % u odnosu na klasična rasvjetna rješenja.


Agencija se aktivno uključuje u pripremu i prijavu prekograničnih i transnacionalnih projekata financiranih iz različitih EU fondova
2. Isključite svjetlo u sobama u kojima ne boravite, a kad god je to moguće koristite prirodno svjetlo.
3. Ugradnjom senzora pokreta i uređaja za podešavanje vremena osvjetljenja u hodnicima i stubištima kojima prolazi manji broj osoba potrošnja električne energije može se smanjiti i do 50 %.
4. Smanjite korištenje dekorativne rasvjete gdje je to moguće jer ona ne pridonosi značajno povećanju osvijetljenosti prostorije, a dodatno troši električnu energiju.
1. Koristite perilicu rublja ili posuđa u razdoblju niže tarife.
2. Kod perilica posuđa budite energetski učinkoviti i birajte kratke programe pranja s niskom temperaturom.
3. Hladnjake i ledenice postavljajte na što hladnijem mjestu u kući (nikako u blizini štednjaka, pećnice, radijatora ili bojlera). Izbjegavajte izloženost ovih uređaja sunčevom zračenju. Hladniji prostor znači veću uštedu energije – u ovom slučaju svaki stupanj može smanjiti potrošnju električne energije i do 5 %.
Savjetujemo građane kako promijeniti životne navike i kako na jednostavan način uštedjeti energiju u svakodnevnom životu sada kada dolazi hladnije vrijeme popraćeno većim računima za grijanje.
4. Standardna temperatura za čuvanje zamrznute hrane je -18 °C, a ako podesite temperaturu za 1 °C niže može se povećati potrošnja energije i do 5 %. Optimalna temperatura hladnjaka iznosi oko 6 °C.
5. Redovito čistite kućanske uređaje jer time također smanjujete potrošnju energije (npr. sloj leda od 3 mm u zamrzivaču povećava potrošnju električne energije za oko 30%) te ih uključite u trenutku kada vam trebaju.
6. Uređaje koji su u radu poput pećnica ili hladnjaka otvarajte što kraće jer ćete time uštedjeti energiju, a uređaji će dulje trajati.
7. Električne uređaje poput televizora, radija i računala ugasite kad ih ne koristite, jer navedeni uređaji troše energiju i u tzv. stand-by načinu rada. Također, isključite punjač za mobitel ili tablet iz utičnice nakon punjenja.
Eduka�vne radionice o energetskoj obnovi kuća i kako ju proves� zanimaju građane
8. Isključite elektroničke zaslone računala čim vam nisu nužni jer obično troše oko 50 % energije potrebne za rad računala. To možete postići i postavkama na samom računalu.
9. Postavite temperaturu električnog bojlera na 55 – 60 °C, a ako se iz prostorije boravi više od 24 sata potrebno ga je isključiti.








Tvrtka Elzeb pruža visokokvalitetne solarne elektrane koje, ne samo da smanjuju troškove struje, već pružaju i dugoročnu energetsku neovisnost, što je posebno važno u ovim izazovnim vremenima rasta cijena električne energije. U idealnim uvjetima, povrat ulaganja u solarnu elektranu može se očekivati već za tri do pet godina. U manje optimalnim uvjetima, povrat može trajati do osam godina, a nakon tog perioda, električna energija koju proizvodi sustav je praktički besplatna, čime se ostvaruju dugoročne uštede. Razgovarali smo s Emilom Zebecom, vlasnikom tvrtke Elzeb iz Dubrave Križovljanske, koja se već više od tri desetljeća bavi tehnološkim inovacijama na području elektronike i elektrotehnike, a zadnjih deset godina su velik dio poslovanja usmjerili na ugradnju solara te izgradili više od 750 elektrana na privatne kuće kao i na poslovne prostore. Ovo poduzeće uvršteno je među 99 najuspješnijih poduzeća u Hrvatskoj, prema portalu Financije.hr.
"Solarne elektrane nisu jedina opcija, ali su najefikasnija i najdugoročnija kada govorimo o troškovnoj isplativosti
- Najava iz Vlade o ukidanju subvencija za struju uznemirila je mnoge građane. Kako to komentirate i što to znači za kućanstva u budućnosti?
- Najava ukidanja mjera su�inanciranja električne energije znači ozbiljan udar na kućne budžete. Mjere koje su do sada bile na snazi omogućile su građanima da lakše prebrode rast cijena uzrokovan energetskom krizom, no njihovim ukidanjem, domaćinstva će se suočiti s
Emil Zebec, vlasnik i direktor tvrtke Elzeb
Spajanje priključnog ormara solarne elektrane





tržišnim cijenama električne energije. Prema prvim procjenama, cijena struje mogla bi rasti za 10 posto, a dugoročno i više, ovisno o stanju na svjetskom tržištu energije. To znači da bi kućanstva mogla očekivati povećanje troškova struje i do 30 posto, što će zahtijevati pametne investicije i prilagodbu potrošnje.
- Što predlažete kao najbolju opciju za smanjenje troškova struje?
- Solarne elektrane su bez sumnje jedno od najboljih rješenja. U zemlji poput Hrvatske, s mnogo sunčanih dana, solarna energija može znatno smanjiti ovisnost kućanstava o tržištu energije. Time smanjujete svoju izloženost rastu cijena struje. Solarne elektrane nisu jedina opcija, ali su naje�ikasnija i najdugoročnija kada govorimo o troškovnoj isplativosti. Jednom kad ih instalirate, sunčeva energija je praktički besplatna, a troškovi održavanja su vrlo niski. Solarne elektrane najbolje su rješenje za domaćinstvo koje imaju mnogobrojne prednosti. Prvo, neovisnost o tržištu energije – više ne ovisite o �luktuacijama cijena nafte, plina ili struje. Drugo, dugoročne uštede – iako su početni troškovi instalacije veći, kroz 7 do 10 godina ta investicija se isplati. Nakon toga, struja koju proizvedete je praktički besplatna. Tu je i mogućnost prodaje viška energije nazad u mrežu, što dodatno smanjuje troškove ili čak donosi pro�it. Ekološka komponenta je također važna – smanjenjem emisije CO2 pridonosite očuvanju okoliša i borbi protiv klimatskih promjena. Ako domaćinstvo ima dovoljno velik solarni sustav, može pokriti između 70 i 100 posto svojih potreba za električnom
energijom. U idealnim uvjetima, računi za struju mogu pasti i do 100 posto, s time da ostaju jedino osnovni troškovi održavanja priključka na mrežu. Naravno, smanjenje ovisi o mnogim faktorima, kao što su veličina solarnog sustava, lokalni klimatski uvjeti te potrošnja kućanstva. Veći sustavi mogu omogućiti pokrivanje većeg dijela potreba, pa tako i značajnije uštede.
"U deset godina izgradili smo više od 750 elektrana na privatne kuće kao i na poslovne prostore od Dalmacije do sjevera Hrvatske
Je li i u Hrvatskoj počela ubrzano rasti svijest o prednostima solarnih elektrana?
- Svijest raste, ali polako. Još uvijek mnogi nisu dovoljno informirani o prednostima solara. Ne radi se samo o uštedama na računima za struju, nego i o doprinosu očuvanju okoliša. Ulaganje u solarnu energiju dugoročno znači smanjenje emisije stakleničkih plinova i manje ovisnosti o fosilnim gorivima. No, vidimo pozitivan trend – sve više ljudi shvaća da im solarne elektrane donose ne samo �inancijske, nego i ekološke bene�ite.
- Koliko ste solarnih elektrana do sada postavili i gdje?
- Tvrtka Elzeb posluje više od 30 godina, a zadnjih 10 godina fokusirali



Novi trend: Mogu li solari na balkon?
Solari na balkonima, točnije na njihovim ogradama, su hit u Njemačkoj. Solarni paneli na balkonima još nisu regulirani zakonom kao u Njemačkoj, gdje su već postali standard, iako interes za njih raste. Uz podršku države i rastuću svijest o važnosti održivosti, očekuje se da će njihova primjena u Hrvatskoj u budućnosti značajno rasti.
smo se na solarne elektrane. Do sada smo postavili više od 750 solarnih sustava, kako na obiteljske kuće tako i na poslovne zgrade diljem Hrvatske. Ugradili smo solare u svim krajevima zemlje, od Dalmacije do sjevera Hrvatske. Postavljamo najkvalitetnije solarne panele, poput Canadian Solar, Solvis i Trina Solar. Što se tiče invertera, najčešće preporučujemo SolarEdge s optimizatorima, Huawei i SMA. Pružamo samo vrhunske komponente jer želimo osigurati maksimalnu učinkovitost i dugovječnost sustava. Nakon koliko vremena se investicija u solarnu elektranu počinje vračati?
- Povrat investicije obično traje između 6 i 8 godina, no to ovisi o nekoliko faktora. Veličina i cijena sustava igraju veliku ulogu, kao i potrošnja domaćinstva – veća potrošnja znači brži povrat. Državne subvencije mogu značajno skratiti taj period, pa u nekim slučajevima povrat može biti već za 3 do 5 godina. Također, prodaja viška energije natrag u mrežu ubrzava povrat ulaganja.
- Je li bitno da krov bude okrenut prema jugu?
- Nije nužno, ali krovovi okrenuti prema jugu omogućuju najbolju učinkovitost jer su tijekom dana najviše izloženi sunčevoj svjetlosti. Idealno je da kut nagiba bude između 30° i 35°. Ako je krov orijentiran prema jugoistoku ili jugozapadu, sustav će i dalje raditi dobro, ali uz blago smanjenje učinkovitosti od 5 % do 10 %. Krovovi okrenuti prema istoku ili zapadu također mogu biti e�ikasni, iako će proizvodnja energije biti nešto niža, oko 15 do 20 posto u odnosu na južnu orijentaciju. Naša usluga je "ključ u ruke". Na početku svakog projekta dolazimo na teren, gdje analiziramo položaj krova i preporučujemo najbolje rješenje za klijenta. Nakon što projektiramo sustav, u ime klijenta predajemo zahtjev za suglasnost. Nakon postavljanja elektrane nudimo besplatan monitoring sustava, a klijenti mogu putem aplikacije pratiti sve parametre svoje elektrane. (SZ)
Udanašnje vrijeme nekontrolirane promjene cijena fosilnog goriva te povremene nestašice pojedinih izvora topline, traže se kotlovi koji na jednostavan način mogu koristiti više različitih vrsta goriva, bez narušavanja komfora grijanja i potrošne tople vode.
Novo na tržištu –
PelTec II Lambda
PelTec II Lambda, snaga 12 – 96kW, kompaktni je kotao koji koristi snagu drvenih peleta kako bi pružio iznimnu učinkovitost grijanja stambenih prostora. Ugrađeni plamenik s funkcijama automatske potpale i samočišćenja rešetke i dimovodnih prolaza osigurava kontinuirani rad bez potrebe za čestim održavanjem. Ovaj kotao je savršen za sve koji traže visoku učinkovitost i jednostavnost korištenja.
Funkcija automatskog čišćenja dimovodnih cijevi omogućuje ujednačenu izmjenu topline i visok stupanj iskoristivosti kotla. S multifunkcionalnom digitalnom regulacijom i 7” ekranom osjetljivim na dodir, PelTec II Lambda nudi modulirajući rad s jednim krugom miješanja grijanja i jednim krugom PTV s recirkulacijom.
Integrirani WiFi omogućuje kontrolu kotla i kruga grijanja putem mobitela ili
računala, dok ugrađena zaštita povratnog voda osigurava ispravan rad kotla i na nižim temperaturama. Spremnik peleta sa senzorom razine peleta dio je standardne opreme, a kotao se isporučuje u dijelovima radi lakšeg unosa u kotlovnicu.
PelTec II Lambda kotao također nudi mogućnost spajanja dodatne opreme kao što je CM2K upravljanje dodatnim krugovima grijanja, analogni sobni kolektor CSK koji omogućuje korekciju zadane temperature u prostoriji prema zadanoj temperaturi na kotlovskoj regulaciji, digitalni sobni korektor CSK-Touch, kaskadno spajanje kotlova CMNET, rotacijska zaštita povrata od plamena (RSE), nastavak za spremnik kao i kutija za pepeo. Ove opcije omogućuju vam prilagodbu sustava grijanja vašim speci�ičnim potrebama i preferencijama.
Kotao je dizajniran s naglaskom na sigurnost i ekološku prihvatljivost. Niske emisije štetnih spojeva u dimnim plinovima čine ga ekološki prihvatljivim izborom, dok visoka iskoristivost osigurava ekonomičnu potrošnju peleta. PelTec II Lambda kotao zadovoljava najviše standarde kvalitete i sigurnosti, što ga čini pouzdanim izborom za vaš dom.
Kombinacija drva i peleta: fleksibilnost i ušteda
Jedan takav kotao je i kombinirani kotao BioTec Plus (cijepano drvo + drveni peleti). Kada se ima vremena, kotao se loži cijepanim drvetom koje u njemu izgara procesom pirolize, a kada je vremena manje ili kad nismo kod kuće, automatski se pali pelet strana kotla te zagrijava sustav grijanja ili sanitarnu vodu. Kako bi povećali komfor korištenja kotla, na kotao je moguće spojiti automatsku dobavu peleta te komunikaciju kotla s web-portalom preko WiFi box-a.
Održavanje kotla vrlo je jednostavno jer drvo skoro potpuno izgara postupkom pirolize pa u kotlu ostaje vrlo malo pepela, dok pelet strana kotla ima ugrađeno automatsko čišćenje pa korisnik jedino treba povremeno iznositi pepeo iz pepe-
"Kada se ima vremena, kotao se loži cijepanim drvetom koje u njemu izgara procesom pirolize, a kada je vremena manje ili kad nismo kod kuće, automatski se pali pelet strana kotla te zagrijava sustav grijanja ili sanitarnu vodu.

ljare. Ako se koristimo suhim cijepanim drvima i drvenim peletima klase Enplus A1, e�ikasnost je kotla iznad 93 %, a kotao ima energetsku klasu A+.
Korištenje energijom Sunca
Sunčeva energija je “besplatna“, ima je svugdje i najčešće se koristi za zagrijavanje potrošne tople vode ili dogrijavanje sustava grijanja. S obzirom na to da je s kombiniranim kotlom obavezna ugradnja akumulacijskog spremnika, solarni sustav se jednostavno može spojiti i upotrebljavati se za ljetno zagrijavanje potrošne tople vode ili pak za dogrijavanje nekog niskotemperaturnog sustava grijanja. Moderna solarna regulacija (CM-SOL) može se spojiti na web-portal čime se omogućuje aktivno praćenje solarnog sustava i jednostavna detekcija grešaka.
Za više informacija o opremi za grijanje obnovljivim izvorima energije slobodno posjetite Centrometal web stranicu www.centrometal.hr
TEHNIKA GRIJANJA









HALLO NEKRETNINE savjetuju o novim porezima
Odgovori na pitanja: Možete li ga izbjeći? Koliko će vas koštati? Tko ga mora plaćati? Kako će to utjecati na cijene nekretnina?
Nema tko u proteklih nekoliko godina nije ostao šokiran rekordnim rastom cijena nekretnina u Hrvatskoj. Čak su i cijene u Čakovcu iznad svih projekcija, što cijena kvadrata za kupnju, što cijena dugoročnog i kratkoročnog najma stanova. Stoga ne čudi što je Vlada Republike Hrvatske odlučila uvesti određene mjere koje za cilj imaju potaknuti korekciju cijena ili jednostavno pomoći mladima i tek zaposlenim osobama da se stambeno zbrinu što je prije moguće. No, mnogi su zbunjeni novim zakonima i promje-
Više od 600.000 stambenih nekretnina u Hrvatskoj ne koristi se i u njima nitko ne živi

• po sistemu „ključ u ruke“, a to uključuje:
- vanjsku fasadu, vanjsku stolariju (protuprovalna ulazna vrata, prozori, rolete, prozorske klupčice),
- odvojeni priključci za svaki stan: struje, vode, plina i kanalizacije u stanu s pripadajućim brojilima
- podno grijanje, klima uređaj, plinski bojler, rekuperator zraka, unutarnje instalacije struje provedene, utičnice i prekidači, s ugrađenim elektro ormarićem u zgradi
- unutarnje instalacije vode i kanalizacije do priključaka predviđenih projektom te kupaonske sanitarije
- pregradni zidovi, unutarnja sobna vrata i štokovi u bijeloj boji
- označeno i asfaltirano vanjsko parkirno mjesto
Želite li više detaljnih informacija o novom oporezivanju, stanju nekretnina u Međimurju ili tražite stan ili kući za kupnju ili najam, obratiti se Hallo nekretninama i dobijte stručan savjet iz prve ruke. Javite im se na mob: +385 91 3323 270 ili posjetite web adresu www.hallonekretnine.eu
nama u oporezivanju, stoga smo pitali agenta za nekretnine Lovru Hamera iz Hallo nekretnina što to točno u praksi znači.
Apsurd u kojem se trenutno nalazimo govori da brojne obitelji ne mogu riješiti stambeno pitanje, a istodobno se više od 600.000 stambenih nekretnina ne koristi i u njima nitko ne živi. Samim time javila se prekomjerna neravnoteža na tržištu nekretnina i stambenog najma što se iznimno negativno odražava na stanovanje, demografiju, turizam i gospodarstvo u cjelini. Stanova je premalo, prodaju se starije i trošne kuće, a građevinska zemljišta za gradnju kuća također su preskupa za obitelj koja tek počinje živjeti. Kako će oporezivanje doskočiti toj situaciji?


INFORMACIJE: MATIJA JESENOVIĆ AC Jesenović d.o.o. Obrtnička ulica 3, Čakovec T: +385 98 844 154 E: matija.jesenovic@gmail.com


Što trebate znati
Od 1. siječnja 2025. godine bit ćemo suočeni novim poreznim opterećenjima koje je Vlada odlučila uvesti kako bi unijela ravnotežu u nestabilno tržište nekretnina.
Tko će biti obveznici novog poreza na nekretnine?
Obveznici novog poreza prije svega će biti stambene zgrade. Izuzete će biti nekretnine koje služe za poljoprivredu i proizvodne i neproizvodne djelatnosti. Porez će se plaćati od dana početka stvarnog korištenja.
Kako izbjeći plaćanje poreza?
Da bi netko bio oslobođen plaćanja, potrebno je da objekt bude u dugoročnom najmu barem 10 mjeseci godišnje. Porez se neće plaćati za nekretnine koje onemogućavaju funkcionalno stanovanje u njima. Također, izuzete će biti nekretnine koje ne mogu služiti stanovanju.
Koliko će taj porez iznositi?
Visina poreza bit će od 0,6 do 8 eura po četvornom metru, prema odluci općine ili grada, a za naplatu poreza jedinice lokalne samouprave moći će odrediti zoniranje svojih područja.
Što taj porez znači za turističke kapacitete?
Što se tiče kratkoročnog turističkog najma, on će se određivati prema indeksu turističke razvijenosti i iznosit će između 150 i 300 eura za najrazvijenije, za one u drugoj skupini od 100 do 200, trećoj od 30 do 150, a u najnerazvijenijim turističkim područjima od 20 do 100 eura po krevetu.
Što će biti s cijenama nekretnina?
Uvođenje poreza na nekretnine neće imati jako značajan utjecaj na tržište nekretnina osim što će dijelu vlasnika trošak biti veći nego što je bio do sad. Ponuda će se sigurno povećati i bit će veći izbor na tržištu za kupce i one koji traže najam. Zajednički učinak veće ponude, poreza na nekretnine, poreza na dohodak od iznajmljivanja mogli bi se u narednom periodu odraziti na cijene. No, nije to baš izgledno.
Hoće li se nešto drastično promijeniti?
Svi čimbenici na tržištu nekretnina gledaju što će se dogoditi. Kupci možda ovom trenu razmišljaju: “Uvodi se porez, to će utjecati na to da cijene padnu.” Prodavatelji kažu: “Pa nije to tako strašno, neće se tu ništa značajno dogoditi, nemam razloga spustiti cijenu.” Sve je stvar perspektive s koje gledate.













KUĆE DLB D.O.O. IZ VARAŽDINA
Svakodnevica je da se u svijetu suočavamo s klimatskim promjenama i inicijativama za smanjenjem potrošnje energije okoliš, ali i osigurali dugoročnu isplativost. Upravo je niskoenergetska gradnja ključna komponenta održivog razvoja. Ovaj na principima energetske učinkovitosti, ekološke prihvatljivosti i ekonomske isplativosti, pružajući rješenja koja smanjuju plinova i troškove života za krajnje korisnike.

Niskoenergetske kuće štede i više vrijede
Suočeni s rastućom potrebom za održivom gradnjom i energetski učinkovitim rješenjima, prije devet godina na tim su temeljima svoju poslovnu priču započeli u Montažne kuće DLB d.o.o. Vođeni željom da ponude inovativna rješenja koja kombiniraju visoku kvalitetu izrade, ekološku prihvatljivost i energetsku učinkovitost, DLB se specijalizirao za gradnju niskoenergetskih montažnih kuća koje odgovaraju potrebama modernog stanovanja. Njihova proizvodnja je vlastita te se temelji na korištenju naprednih materijala, odnosno osnovne konstrukcije izrađene od KVH drveta dok su zidovi tipizirani. Vanjski zidovi debljine su 36 centimetara ispunjeni vatrootpornim i vodootpornim materijalima suvremenih tehnologija te ljudske ruke dok unutarnji iznose 20 i 15 cm. Za izgradnju jedne takve niskoenergetske kuće potrebno je do 120 dana, što uključuje sve faze gradnje od montaže do �inalizacije, a trenutno je naša proizvodnja popunjena za sljedeće dvije godine unaprijed, što potvrđuje rastući interes i povjerenje kupaca u kvalitetu i učinkovitost naših rješenja. Ovaj dugoročni raspored proizvodnje omogućava nam da se posvetimo svakom projektu s posebnom pažnjom i osiguramo da naši klijenti dobiju domove koji ispunjavaju njihove potrebe i očekivanja, izjavio je direktor tvrtke, Dražen Brlek.
Poboljšava kvalitetu života
Razvoj niskoenergetskih građevinskih standarda ne donosi samo ekološke prednosti, već i značajno poboljšava kvalitetu života. Stanari ovih objekata uživaju u udobnim unutarnjim prostorima s konstantnom temperaturom i svježim zrakom, dok istovremeno sma-
"S obzirom na rastuće cijene energenata i sve veći pritisak na okoliš, niskoenergetske kuće postaju sve privlačnije.
energije kako bismo sačuvali Ovaj tip gradnje temelji se smanjuju emisiju stakleničkih
njuju svoj utjecaj na okoliš, izjavio je direktor tvrtke, Dražen Brlek. Montažne kuće DLB ponosno posjeduju certi�ikate za kvalitetu ISO 9001, zaštitu okoliša ISO 14001 te zaštitu ljudi i imovine ISO 45001, što dodatno potvrđuje našu predanost visokim standardima u gradnji i održivosti, kao i brigu o sigurnosti naših klijenata i zaposlenika.
Gradimo budućnost s vama U Hrvatskoj, kao i u mnogim zemljama Europske unije, niskoenergetska gradnja sve više dobiva na značaju, uz poticaje za energetsku obnovu zgrada i subvencije za implementaciju ekološki prihvatljivih tehnologija. Našim klijentima nudimo prilagodljiva rješenja koja se mogu oblikovati prema njihovim potrebama i željama. Uz naš slogan ”Gradimo budućnost s vama” posvećeni smo stvaranju održivih prostora koji će zadovoljiti zahtjeve današnjice i budućih generacija, osiguravajući istovremeno kvalitetu, e�ikasnost, brigu o okolišu te �inancijsku isplativost, istaknuo je direktor tvrtke, Dražen Brlek.
S obzirom na rastuće cijene energenata i sve veći pritisak na okoliš, niskoenergetske kuće postaju sve privlačnije. One ne samo da smanjuju troškove komunalnih usluga, već također pružaju dugoročnu sigurnost u vremenima ekonomskih neizvjesnosti. Ove kuće omogućuju vlasnicima veću kontrolu nad potrošnjom energije, smanjujući njihovu ovisnost o vanjskim izvorima energije i potencijalnim oscilacijama cijena.
Niskoenergetske kuće financijski su isplative
Financijska isplativost niskoenergetske gradnje drugi je od ključnih razloga za njezinu sve veću popularnost. Iako je početno ulaganje nešto veće nego kod klasične gradnje, povrat investicije ostvaruje se kroz znatno smanjene troškove grijanja i hlađenja, niže račune za energiju te duži vijek trajanja objekta. Uz to, vlasnici ovakvih objekata često mogu računati na povoljnije uvjete �inanciranja i subvencije za korištenje obnovljivih izvora energije, što dodatno smanjuje troškove izgradnje i održavanja, iznio je direktor tvrtke Dražen Brlek. Put prema održivom načinu života
Niskoenergetska gradnja kuća predstavlja put prema održivom načinu živo-


Iako se čeka na isporuku, naše su montažne kuće popularne zbog energetske učinkovitos� i brzine gradnje, kaže Dražen Brlek, direktor tvrtke Montažne kuće DLB iz Varaždina

Za izgradnju jedne takve niskoenergetske kuće potrebno je do 120 dana, što uključuje sve faze gradnje od montaže do finalizacije.


ta, nudeći brojne prednosti za vlasnike i okoliš. Kako se svijest o klimatskim promjenama povećava, očekuje se da će ovaj pristup postati sve popularniji, oblikujući budućnost stanovanja na način koji je ekološki prihvatljiv, ekonomičan i udoban.
Odluka za niskoenergetsku kuću nije samo investicija u nekretninu, već i korak prema boljoj i održivoj budućnosti.
Doprinos izgradnji boljeg sutra
U konačnici, niskoenergetska gradnja kuća predstavlja ne samo trend, već nužnost u suvremenom građevinarstvu. Kao odgovor na globalne izazove, ovaj pristup omogućuje pojedincima da postanu aktivni sudionici u stvaranju održivijeg svijeta. Odabir niskoenergetske kuće može biti osobni izbor, ali utjecaj koji taj izbor ima na zajednicu i planet dugoročno je neprocjenjiv. Razvijanjem svijesti i podrškom ovim inicijativama, svi možemo doprinijeti izgradnji boljeg sutra.
DLB montažne kuće Kučanska 1, Varaždin
T: +385 42 421 355
E: info@dlb.hr
E: montazne.kuce@dlb.hr www.dlb.hr INFO


OSNOVNA ŠKOLA STRAHONINEC ide u energetsku obnovu
Potpisan je ugovor s izvođačem radova, domaćom tvrtkom Đurkin, vrijedan 897.065,11 eura. Ukupna vrijednost projekta je 944.594,56 eura, a od toga iznosa 749.145,17 eura su bespovratna sredstva po projektu
Osnovna škola Strahoninec kreće u energetsku obnovu te je potpisan ugovor s izvođačem radova, domaćom tvrtkom Đurkin, vrijedan 897.065,11 eura. Ukupna vrijednost projekta je 944.594,56 eura, a od toga iznosa 749.145,17 eura su bespovratna sredstva po projektu.
Implementacijom projekta „Energetska obnova zgrade Osnovne škole Strahoninec na adresi Čakovečka 55, Strahoninec - NPOO.C6.1.R1-I1.04.0378“ uz obnovu fasade, zamijeniti će se stolarija u objektu,


i investicije Anita Perišin, pročelnica odjela za obrazovanje, kulturu i sport Nives Kolarić Strah, načelnik Franjo Lehkec, direktor MENEA-e Alen Višnjić, predstavnica izvođača radova Maja Đurkin Međimurec, ravnatelj Josip Šipek i župan Matija Posavec
rasvjeta će se zamijeniti štedljivim (LED) rasvjetnim tijelima.
- Radovi će se izvesti na 1.921,8 kvadratnih metara bruto građevinske površine te će se postići projektni cilj koji podrazumijeva uštede od 93,22 posto u primarnoj energiji, 61,93 posto u toplinskoj energiji za grijanje te smanjenje emisije CO2 za

PODRUČNA ŠKOLA DUNJKOVEC
MEÐIMURSKA ŽUPANIJA
MEÐIMURSKA ŽUPANIJA
MEÐIMURSKA ŽUPANIJA
94,64 posto, uz povećanje udjela obnovljive energije za 77,17 posto ugradnjom dva sustava koji koriste obnovljive izvore energije, rekao je direktor Međimurske energetske agencije MENEA Alen Višnjić. Projekt su�inancira iz Nacionalnog plana oporavka i otpornosti 2021. - 2026. u iznosu od 80 do 85 % ovisno o vrsti troška.
- Riječ je o jednoj od većih škola, s 420 učenika, među kojima je u ovoj školskoj godini i čak 49 prvašića. Ciklus smo podijelili na tri segmenta, od kojih smo prvi - izgradnju školske sportske dvorane - uspješno izveli u suradnji s Općinom te nam ostaje energetska obnova i dogradnja škole, istaknuo je župan Matija Posavec, dodavši da je u energetsku obnovu Županija ulaže oko 200.000 eura. Uz to, za dogradnju škole u tijeku je izmjena glavnog projekta, nakon čega slijedi i kandidatura te raspisivanje javne nabave i realizacija.
- Novi sustav grijanja omogućit će ustanovi, uz udobnosti i značajne uštede. Zahvalni smo osnivaču Međimurskoj županiji koja nam je kvalitetnim projektom omogućila napredak, rekao je ravnatelj OŠ Strahoninec Josip Šipek, dodajući da nakon energetske obnove, slijedi dogradnja škole, što ih također raduje jer će time zaokružiti uvjete neophodne za jednosmjensku nastavu. (sh)
„Financira Europska unija – NextGenerationEU. Izneseni stavovi i mišljenja samo su autorova i ne odražavaju nužno službena stajališta Europske unije ili Europske komisije. Ni Europska unija ni Europska komisija ne mogu se smatrati odgovornima za njih.”
Energetskom obnovom zgrade PŠ Dunjkovec smanjit će se emisija CO2 za 87 posto, godišnja potrošnja primarne energije za gotovo 91 posto, a uštede na toplinskoj energiji premašit će 54 posto. Također, povećat će se udio obnovljivih izvora energije za 78 posto.
Potrošnja energije i negativan utjecaj na okoliš smanjit će se u područnom odjelu Osnovne škole Nedelišće u Dunjkovcu, koji pohađa 76 učenika te ove godine čak 14 prvašića. Škola ulazi u projekt energetske obnove ukupne vrijedonosti 412.652,02 eura. Projekt se provodi u okviru Poziva „Energetska obnova zgrada javnog sektora“ (referentni broj: NPOO. C6.1.R1-I1.04) u sklopu kojeg mu je dodijeljeno 314.995,35 eura bespovratnih sredstava iz Nacionalnog plana oporavka i otpornosti 2021.-2026.
Projekt „Energetska obnova zgrade Područne škole Dunjkovec na adresi Glavna


Započinju radovi na PŠ Dunjkovec u vrijednosti od 412.995 eura
ulica 51A, Dunjkovec, Osnovne škole Nedelišće, Nedelišće - NPOO.C6.1.R1-I1.04.0400” obuhvaća građevinsko-obrtničke, strojarske, elektrotehničke te horizontalne mjere, kojima će se postići smanjenje emisije
MEÐIMURSKA ŽUPANIJA

MEÐIMURSKA ŽUPANIJA
MEÐIMURSKA ŽUPANIJA
CO₂ za 87 posto, te smanjenje godišnje potrošnje primarne energije za gotovo 91 posto, dok će uštede na toplinskoj energiji premašiti 54 posto. Ugradnjom dizalice topline te fotonaponske elektrane povećat će se i udio obnovljivih izvora energije za 78 posto. Direktor MENEA-e Alen Višnjić dodaje da će se energetski obnoviti 795 m2 građevinske bruto površine zgrade javne namjene. Provođenje mjera će obuhvaćati: povećanje toplinske zaštite vanjskog zida, stropa prema negrijanom tavanu te kosog krova; ugradnju dizalice topline zrak-voda, ventilokonvektora, fotonaponske elektrane snage 40,5 kWp, rekonstrukciju sustava rasvjete, implementaciju sustava daljinskog očitanja potrošnje energenata i vode, izvedbu parkirališta za bicikle te rekonstrukciju postojeće rampe za osobe smanjene pokretljivosti. Radove će, po uvođenju u posao, izvesti djelatnici tvrtke Project Management, s čijim je direktorom
Kristijanom Kropekom potpisan ugovor koji de�inira uvjete i rokove izvođenja. - Zahvaljujem što je područni odjel Dunjkovec ušao u ovaj projekt, rokovi su kratki te bismo do svibnja trebali imati neusporedivo bolje uvjete nego ikad prije, rekao je ravnatelj OŠ Nedelišće Ivica Paić. - Osnovna škola Strahoninec i OŠ Nedelišće zajedno imaju više od 1000 učenika te čine velik udio u obrazovanju Međimurja. Vodeći računa o potrebama u obrazovanju, više od 100.000 eura, po omjeru su�inanciranja, osigurat ćemo i za ovaj projekt u Dunjkovcu, kaže župan, podsjetivši da će Međimurska županija s Općinom Nedelišće ući i u projekt izgradnje jednodjelne sportske dvorane u Nedelišću kao i u dugo očekivani projekt izgradnje nove zgrade OŠ Nedelišće za koje je stigla suglasnost, no nažalost samo na 58 posto, što neće zaustaviti Županiju na putu i prema tom cilju. (sh)
„Financira Europska unija – NextGenerationEU. Izneseni stavovi i mišljenja samo su autorova i ne odražavaju nužno službena stajališta Europske unije ili Europske komisije. Ni Europska unija ni Europska komisija ne mogu se smatrati odgovornima za njih.”

Općina Nedelišće obavještava sve zainteresirane da je započela s mjerom su�inanciranja kamata na stambene kredite kako bi mladima i mladim obiteljima olakšala rješavanje stambenog pitanja.
Su�inanciranje će pokrivati do 50 % kamate na odobrene stambene kredite, tj. do maksimalnog iznosa od 2400 eura
godišnje, odnosno 200 eura mjesečno, i to za razdoblje do pet godina otplate kredita. Javnim pozivom omogućeno je podnošenje zahtjeva od dana objave pa sve do iskorištenja sredstava ili najkasnije do 15. prosinca 2024. godine. U 2024. godini za ovu namjenu planirana su sredstva u iznosu od 10.000 eura.
Pravo na su�inanciranje ostvaruju osobe s odobrenim stambenim kreditom ili dijelom kredita koji ne prelazi 120.000 eura, uz uvjet da imaju zaključen ugovor s kreditnom institucijom. Javni poziv, svi uvjeti i popratni dokumenti mogu se pronaći na službenoj web stranici Općine Nedelišće, na adresi www.nedelisce.hr. (sh)

Načelnik
Općine Nedelišće
Nikola Novak






Marko Tomašić, direktor GP-a Stanorad sa zadovoljstvom konsta�ra da Međimurci misle o budućnos� svojih zgrada
Međimurci su svjesni da moraju uložiti u zgrade u kojima stanuju jer takve zgrade štede i uvijek više vrijede. Ulaganjem u energetsku obnovu smanjuju se režijski troškovi, a dobiva se lijep, uređen i kvalitetan prostor. Kakvo je stanje s energetskom obnovom zgrada pitali smo Marka Tomašića, direktora GP-a Stanorad, najvećeg upravitelja zgradama u sjeverozapadnoj Hrvatskoj koji je prisutan i u Međimurju, ali i na području Varaždina i Varaždinske županije, koji nam je rekao: GP STANORAD d.o.o. i u 2024. godini nastavlja s energetskom obnovom zgrada. Tako je pri kraju obnova višestambene zgrade s 45 stanova na adresi Vladimira Nazora 32, Čakovec (nasuprot Ekonomske škole Čakovec), ukupne vrijednosti radova 509.652,92 EUR, od čega su bespovratna sredstva iz nacionalnog plana oporavka
Već neko vrijeme u pripremi je novi Zakon o upravljanju i održavanju zgrada koji za cilj ima ukloniti postojeću zakonsku prazninu i omogućiti kvalitetno upravljanje i održavanje zgrada, a njime bi trebalo biti omogućeno i su�inanciranje dizala od strane države, ali i jedinica lokalne samouprave. Novim zakonom bit će propisan i novi minimalni iznos pričuve. Važno je da svi naši stanari se nemaju čega bojati, jer nova propisana minimalna pričuva je 0,36 eura po kvadratu, dok naši stanari izdvajaju 0,44 eura po kvadratu.
U periodu kada je teško pronaći izvođače radova i kad dobijemo novce od države, velika prednost je što imamo vlastiti tim koji se pokazao kao stručan i pouzdan.
i otpornosti 46 posto. Također, uskoro započinje i obnova dviju manjih višestambenih zgrada s četiri stana, na adresi Vladimira Nazora 8A i Ivana Mažuranića 9. Na Pozivu na dodjelu bespovratnih sredstava - energetska obnova višestambenih zgrada u ovoj godini prijavili smo dvanaest zgrada, od čega sedam zgrada u Čakovcu, tri zgrade u Varaždinu, jednu zgradu u Donjem Kraljevcu te jednu zgradu u Ivancu. Rezultati Poziva se prema najavi Ministarstva prostornoga uređenja, graditeljstva i državne imovine očekuju u listopadu. Od prijavljenih zgrada posebno valja istaknuti višestambene zgrade u Vukovarskoj ulici 4, 4a, 4b (1 blok zgrada “solidarnosti’’), u Travniku 11 – 17 (prvi blok zgrada Travnik na ulazu u jug Čakovca) te u Ulici kralja Tomislava 14 (centar Čakovca, nasuprot crkve - “Borovo’’).
Što sve obuhvaća obnova?

"Kreditno zaduženje zgrade je vezano na račun stambene pričuve, pa ne umanjuje vašu kreditnu sposobnost.
Stanorad: Obnova višestambene zgrade s 45 stanova na adresi Vladimira Nazora 32 u Čakovcu
Energetskom obnovom je predviđena toplinska izolacija vanjske ovojnice zgrade, prvenstveno izvedba toplinske fasade, izolacija stropa podruma, izolacija ravnog krova ili stropa tavana, zamjena vanjske stolarije (radovi se razlikuju ovisno o zgradi) te svi radovi na zgradi za koje su suvlasnici odlučili da ih je potrebno izvesti. U zgradi solidarnosti je predviđena i ugradnja dizala u svaki od tri ulaza, na nekim zgradama se i mijenjaju tehnički sustavi grijanja (stari bojleri se mijenjaju kondenzacijskim). Natječaj za energetsku obnovu zgrada je najavljen i

za iduću godinu te apeliramo na suvlasnike da se jave na vrijeme kako bi se izradila potrebna dokumentacija, poglavito glavni projekt. Energetska obnova zgrade koja u pravilu povlači i kreditno zaduženje zgrade je dobra prilika da se u zgradi izvedu i ostali radovi koji nisu su�inancirani, no potrebno ih je izvesti zbog dotrajalosti i sl., kao npr. zamjena kanalizacijskih, vodovodnih cijevi u zajedničkim dijelovima zgrade, sanacija kosog krova i zamjena pokrova na zgradama s provjetravanim tavanom i sl. Kreditno se zadužuje pričuva Prvo pitanje koje se postavlja kod svake obnove zgrade je koliko to ko-
T:
E: info@gpstanorad.hr www.gpstanorad.hr INFO



šta? Sljedeće: kako ćemo to platili? Postoje povoljne kreditne linije i �iksne kamatne stope, no najvažnije je da ovo kreditno zaduženje zgrade vezano na račun stambene pričuve, pa ne umanjuje kreditnu sposobnost pojedinog suvlasnika. Kamatne stope su �iksne na rokove otplata i do 20 godina te je jednostavna procedura ishođenja kredita. Stoga potičemo suvlasnike u zgradama da u dogovoru sa svojim upraviteljem razmisle o potrebnim radovima na zgradi, a mi ćemo vrlo rado izaći u susret s konstruktivnim prijedlozima i svim informacijama vezano uz provedbu radova i način �inanciranja.



Čakovec, Globetka, ul. Planinarski put


• u pripremi izgradnja stambeno-poslovne zgrade: podrum, prizemlje, 2 kata, potkrovlje
• stanovi od 50 m² do 120 m²
• parkirna mjesta vanjska i u podrumu, spremišta
• vrhunska gradnja, visoka kvaliteta materijala ugradnje, mogućnost odabira materijala završne obrade i interijera
• visoka energetska učinkovitost, podno grijanje, klima, rekuperatori zraka
• poseban naglasak na sigurnost - video portafon, protuprovalna vrata
INTERMEGRAD d.o.o., Josipa Bedekovića 1, 40000 ČAKOVEC E:office@ intermegrad.hr | M: +385 98 241 084, +385 98 426 370

U potrazi ste za iskusnim i učinkovitim partnerom za zbrinjavanja otpada?
Uz zavidno iskustvo u pružanju usluga u građevinskom sektoru, Reciklaža Mišić nudi vam stručno i učinkovito gospodarenje otpadom kroz postupak reciklaže sukladno zakonskim propisima.
U Reciklažnom dvorištu Mišić nastaju reciklirani agregati kao što su drobljeni asfalt, beton i opeka, koju udovoljavaju važećim propisima te su ispitani od strane nadležnih laboratorija.
Sdolaskom hladnijih mjeseci i neprekidnim porastom cijena energenata, mnogi od nas suočavaju se s pitanjem: kako smanjiti troškove grijanja? Kvalitetna gradnja i odgovarajući građevinski materijali ključni su za postizanje energetske učinkovitosti, što dugoročno znači niže račune i ugodniji životni prostor.
Pametna gradnjadugoročna ušteda
Pri gradnji ili renovaciji kuće, jedna od najvažnijih odluka koju donosite jest izbor materijala. Iako je često primamljivo birati jeftinije opcije, dugoročno, takve odluke mogu donijeti više štete nego koristi. Jeftiniji materijali često zahtijevaju skupe sanacije ili uzrokuju veće troškove grijanja zbog loših izolacijskih svojstava.
Kvalitetna izolacija je temelj svakog energetski učinkovitog doma – ona sprječava gubitak topline i smanjuje potrebu za dodatnim zagrijavanjem prostora. Dobar izolacijski sustav može značajno smanjiti potrošnju energije. Posebnu pažnju treba obratiti na izolaciju krova, fasade i stolarije jer su to najkritičniji dijelovi kuće kroz koje se gubi toplina. Fasada, osim što ima estetsku funkciju, mora biti opremljena izolacijom odgovarajuće debljine i kvalitetom, čime se osigurava ugodan

i zdrav boravak u kući te niži troškovi grijanja. Gubitak topline kroz krov može biti iznimno velik – u neizoliranim kućama četvrtina topline odlazi upravo na ovaj
Kvalitetan pokrov i termoizolacija osigurat će da vaš dom zimi ostane topao, a ljeti ugodno hladan
način. Zbog toga je iznimno važno izolirati potkrovlje i tavan kako bi se spriječili ti nepotrebni gubici. Kvalitetan pokrov i termoizolacija osigurat će da vaš dom zimi ostane topao, a ljeti ugodno hladan.
Sistem MEP – vaš partner za kvalitetnu gradnju Tvrtka Sistem MEP iz Male Subotice, s dugogodišnjom tradicijom u prodaji građevinskih materijala, nudi širok asortiman proizvoda za sve faze gradnje – od
temelja do krova. Naša četiri prodajna mjesta u Čakovcu, Maloj Subotici, Murskom Središću i Dekanovcu pružaju sve što vam je potrebno, bilo da gradite novu kuću ili renovirate postojeću. Ponosimo se suradnjom s renomiranim svjetskim proizvođačima kao što su **Wienerberger, Unitherm, Baumit, Velux, Ursa, Rockwool, Knauf insulation, Nexe, BMI Bramac –samo su neka od tih renomiranih imena. Pokrovi svih vrsta, kamena vuna, staklena vuna, stiropor, XPS, gips ploče za suhu gradnju, krovni prozori, završne fasade – samo je dio roba koje možete naći kod nas. Ako gradite novu kuću ili renovirate i dograđujete postojeću, obratite nam se s povjerenjem – bilo na nekom od prodajnih mjesta, bilo u komercijali. Naše stručno osoblje pomoći će vam u odabiru materijala i ponuditi vam ono na čemu ćete dugoročno uštedjeti i smanjiti troškove grijanja zimi ili hlađenja ljeti.























Montažna kuća Chasma iz Pribislavca kao inspiracija za gradnju
Montažna kuća u Pribislavcu je inspiracija i prilika za sve koji žele moderan, učinkovit i tehnološki napredan dom
Tvrtka Chasma iz Pribislavca, poznata po gradnji montažnih kuća, izgradila je izložbenu montažnu kuću napravljenu po svim najnovijim trendovima. Kuća se nalazi u Pribislavcu i izgrađena je kao prototip za razgledavanje. Ova najmodernija kuća pruža potencijalnim kupcima jedinstvenu priliku da uživo dožive sve najnovije tehnologije gradnje i opremanja montažnih kuća.
Kuća je pažljivo dizajnirana kako bi pokazala vrhunske standarde energetske učinkovitosti, održivosti i modernog dizajna. Posjetitelji imaju priliku iz prve ruke vidjeti primjenu naprednih materijala, ekoloških rješenja i pametnih kućnih sustava koji doprinose većoj udobnosti i smanjenju troškova života. Sve niskoenergetske montažne kuće Chasma zadovoljavaju energetske kriterije A kategorije, što je najviše što se može postići u našem
Do svog doma u samo 4 mjeseca
Kontaktirajte tvrtku Chasma na broj 098/181-3163 ili e-mail info@ chasma.hr te dogovorite sastanak s direktorom Danijelom Žoharom koji će vam otvoriti vrata nove montažne kuće gdje ćete moći vidjeti sve uvjete gradnje i života montažne niskoenergetske kuće. Nalaze se u Pribislavcu, u Radničkoj ulici, a možete posjetiti i njihovu web-stranicu www.chasma.hr
podneblju. Ovakva će kuća minimalizirati vaše mjesečne račune ugradnjom dizalica topline i fotonaponskih ćelija. U prototipu Chasma kuće u Pribislavcu korištena je vrhunska toplinska izolacija zidova, krova, poda i najkvalitetnija stolarija. Upravo zbog toga ne dolazi do velikih toplinskih gubitaka zimi ni pregrijavanja ljeti, a takve kuće štede do 30 % energije.
"Kuća može biti spremna za useljenje u vrlo kratkom vremenskom roku od samo 4 mjeseca
Montažna kuća opremljena je najnovijim sustavima grijanja, hlađenja i ventilacije te inteligentnim sustavima upravljanja koji omogućuju maksimalnu kontrolu nad uvjetima u domu putem aplikacija na pametnim uređajima. Sve ove tehnologije prezentirane su kako bi potencijalni kupci dobili cjelovit uvid u prednosti koje pružaju moderne montažne kuće.
Tvrtka Chasma svojim klijentima želi pružiti transparentan uvid u sve aspekte gradnje i opremanja, omogućujući im da vizualiziraju svoj budući dom te se upoznaju sa svim mogućnostima prilagodbe i individualizacije prostora.
Najjeftinija i najpraktičnija opcija gradnje vlastite kuće
Tvrtka Chasma vas vodi cijelim procesom gradnje, što znači da nema brige s radnicima i dokumentacijom. U cijenu izvedbe uključena je kompletna projektna i završna dokumentacija, a jedino što morate učiniti je predati zahtjev za dobivanje građevinske dozvole. Nabava i koordinacija radnika također je usluga tvrtke Chasma, stoga kupci nemaju dodatnih opterećenja oko izvedbe radova. Ključ u ruke i jasni troškovi Vođena gradnja kuće uključuje cjenik koji je transparentan i bez skrivenih








Danijel Žohar provest će vas kroz kuću i predstavi� njene posebnos�

Po čemu su montažne kuće bolje od klasične gradnje?
Montažne kuće posljednjih godina sve više dobivaju na popularnosti zahvaljujući brojnim prednostima koje nude u usporedbi s klasičnom gradnjom. Radi se o kućama koje se proizvode u kontroliranim uvjetima u tvornici, a potom se transportiraju na gradilište gdje se brzo i precizno montiraju. Ovakav način gradnje omogućuje veću kontrolu nad kvalitetom materijala i smanjuje rizik od vremenskih uvjeta koji mogu usporiti ili otežati klasičnu gradnju. Jedna od ključnih prednosti montažnih kuća je njihova brzina izgradnje. Budući da se veliki dio procesa odvija u tvornici, kuća može biti gotova za useljenje u vrlo kratkom vremenskom roku od čak 4 mjeseca. Montažne kuće su energetski učinkovitije, jer se prilikom izrade koriste

najmoderniji izolacijski materijali koji smanjuju gubitke energije i značajno smanjuju troškove grijanja i hlađenja. Važna značajka montažnih kuća je i njihova �leksibilnost u dizajnu. Klijenti mogu birati između različitih modela, veličina i rasporeda prostora te dodatno prilagoditi kuću svojim željama i potrebama. Ovakav pristup omogućuje personalizaciju doma, bilo da se radi o odabiru speci�ičnih materijala, završne obrade ili modernih tehničkih rješenja poput pametnih kućnih sustava.b Montažne kuće su otporne na potrese i druge prirodne nepogode, zahvaljujući pažljivo projektiranoj konstrukciji. Uz sve navedeno, cijena montažnih kuća često je povoljnija u usporedbi s tradicionalnim kućama, jer je proces gradnje optimiziran i troškovi su predvidljiviji.
Montažna kuća u Pribislavcu posljednji je krik tehnologije u gradnji i opremanju doma
troškova. Najčešće klijenti biraju opciju extra visoki roh-bau što uključuje kompletnu dokumentaciju, nadzor, izvješće za dobivanje uporabne dozvole, dostavu materijala, montažu objekta, elektroinstalacije, dovodne i odvodne vodovodne instalacije, pregradne zidove, fasadu, prohodan tavanski prostor, krov, limarske radove, terasu, vanjsku PVC stolariju, ulazna vrata, unutarnje i vanjske klupčice. U opciji extra visoki roh-bau plus uključeni su i podovi, grijanje i unutarnja stolarija, a u opciji ključ u ruke završni radovi kao što su keramika, sanitarije, završni soboslikarski radovi i laminat odnosno parket.


Tvrtka David Beton d.o.o.
Tvrtka David Beton d.o.o. s više od 40 godina iskustva, specijalizirala se za pružanje vrhunskih usluga u ovom području, postavši vodeći izbor u Međimurskoj i Varaždinskoj županiji.
S ponosom vam nudimo sve vrste svježeg betona za građevinske potrebe, uz brzu i sigurnu dostavu te profesionalnu ugradnju na lokaciji po vašem izboru. Ponuda obuhvaća širok spektar betona prilagođenih vašim potrebama, uključujući:
• Betoni za građevinarstvo
• Vodonepropusni betoni
• Betoni otporni na habanje
• Aerirani betoni
• Laki betoni s okipor granulama
David Beton d.o.o Katarine Zrinski 1, 450318 Dekanovec +385 99 242 7001 +385 98 242 866 david.beton@ck.t-com.hr
• Mikrobetoni i mikroarmirani betoni
• Cementne glazure
• Betoni s aditivima protiv smrzavanja
Uz vrhunske proizvode, nudimo i siguran, brz i pouzdan prijevoz, omogućujući vam da beton stigne na vašu gradilišnu lokaciju u najkraćem mogućem


Ne prepuštajte ništa slučaju kada je u pitanju kvaliteta i dugotrajnost vašeg građevinskog projekta. David Beton d.o.o. osigurava beton koji traje i uslugu kojoj možete vjerovati.
roku. Naš stručni tim s dugogodišnjim iskustvom uvijek je na raspolaganju kako bi osigurao da vaši projekti budu realizirani učinkovito, kvalitetno i unutar dogovorenih rokova.
Zašto odabrati David Beton d.o.o.?
• Kvaliteta i pouzdanost – Naši proizvodi su certi�icirani prema najvišim standardima upravljanja kvalitetom.
• Skoro 40 godina iskustva – Tradicija i znanje koje smo stekli kroz desetljeća



- 5 godina jamstva

omogućuju nam pružanje najkvalitetnijih usluga.
• Široka ponuda – Imamo rješenje za svaki vaš projekt, bilo da je riječ o standardnom betonu ili specijalnim vrstama betona prilagođenim speci�ičnim potrebama.
• Brza dostava i ugradnja – Naša moderna vozila i tim stručnjaka jamče pravovremenu i sigurnu dostavu, kao i profesionalnu ugradnju.
se s povjerenjem!






Tvrtka Alpro-Šardi iz Selnice

Alpro-Šardi d.o.o. obitelji Šardi iz Selnice već je 30 godina lider u izradi i ugradnji aluminijske i PVC stolarije
Osnovana među prvima u Hrvatskoj u domeni poslovanja izrade i ugradnje aluminijske i PVC stolarije, tvrtka Alpro-Šardi ove godine obilježava 30 godina poslovanja. Pod vodstvom osnivača, već punih 30 godina neumornim i predanim radom promiču ugled struke. Danas, 30 godina po osnivanju, njihovi su osnivači u zasluženoj mirovini, ali priča se nastavlja kroz drugi i treći naraštaj.
Početak razvoja tvrtke
Alpro - Šardi
Uspjeh tvrtke Alpro-Šardi započinje njezinim osnutkom 1994. godine u Selnici. Skromne početke prvih godina obilježio je rad u malom proizvodnom pogonu obiteljske kuće s čestim putovanjima osobnim automobilom jednog zaposlenog djelatnika. Iako u skromnim uvjetima rada, entuzijazma im nije nedostajalo, pa će idućih nekoliko godina tvrtka intenzivno razvijati usluge prodaje, ugradnje i servisa aluminijske i PVC stolarije. Nakon petogodišnjeg iskustva rada u obrtničkoj radionici, odlučili su krenuti u novom smjeru i povesti tvrtku u
neizvjesne i ozbiljne poduzetničke izazove.
Preseljenje u 3000 m² novih proizvodnih pogona
Strelovit razvoj tvrtke dogodio se godine 2011. kada sele u 3000 m² novih proizvodnih pogona. Uz rad na najsuvremenijim strojevima, uz informatičku podršku u svim fazama pripreme i proizvodnje, stalno se usavršavaju i prate najnovija tehnološka dostignuća. U proizvodnji stolarije koriste PVC profile marke KOMMERLING koji jamče najbolju energetsku učinkovitost, otpornost na sve vremenske uvjete i mehaničke utjecaje. Na polju aluminijske stolarije
Tvrtka Alpro-Šardi zastupljena je po cijeloj Hrvatskoj, a velik dio svojih proizvoda plasira i na zahtjevno EU tržište te jamči vrhunsku kvalitetu po najnovijim standardima.
Od male radionice u sklopu obiteljske kuće do 3000 m² proizvodnog pogona
također slijede najnovije trendove u arhitekturi s naglaskom na velike ostakljene površine prema zahtjevima njihovih klijenata.
Ključ uspjeha je upornost i jasni ciljevi
Iza njih je 30 godina uspješnog poslovanja tvrtke tijekom kojih su rasli kao pojedinci i kao kolektiv. Odupirali su se izazovima tržišta, nestabilnostima koje svako vrijeme sa sobom donosi i hrabro koračali u nove pothvate. Njihov uspjeh rezultat je vizije njihovih osnivača, zajedničke upornosti i puno htijenja. Usluge održivih, inovativnih i učinkovitih rješenja iz područja građevinske aluminijske i PVC stolarije odraz su sinergije neumornog stjecanja znanja, vještina i iskustva. Brinu o kvalitetnom i stručnom usavršavanju
svojih djelatnika, a usmjerenošću na podizanje usluga rada s korisnicima doprinose i služe sveopćoj dobrobiti lokalne zajednice.
Snage tvrtke je u zaposlenicima
Snaga njihove tvrtke je u potencijalu, iskustvu i zaposlenicima, od kojih mnogi doprinose s više od deset, dvadeset i više godina rada. Svima njima zahvaljuju na vjernosti i doprinosu koji su utkali u ovu tvrtku. Zajedno su je učinili pouzdanim partnerom prepoznatljivog imidža na domaćem i regionalnom tržištu. Razvijaju se i dalje, prate trendove i inovacije koje će u budućnosti donijeti boljitak za tvrtku i za njihove kupce koji prepoznaju kvalitetu proizvoda i usluga tvrtke Alpro-Šardi.


Dan Küchen salon u Čakovcu, na izvrsnoj lokaciji, jedan je od naljepših salona kuhinja na sjeveru Hrvatske
Izrada nove kuhinje ozbiljan je proces koji zahtijeva pomno planiranje i razmišljanje o iskoristivnosti prostora. Cilj dobre kuhinje je da izdrži potrebe vas i vaše obitelji nekoliko desetaka godina, što funkcionalno, što dizajnom. Upravo Dan Kűchen kuhinje zadovoljavaju ove kriterije, zbog čega su prvi izbor mnogih obitelji koje rade prvu ili renoviraju postojeću kuhinju. Dan Kűchen kuhinje spoj su vrhunskog dizajna, funkcionalnosti i besprijekorne kvalitete o kojoj ne morate brinuti godinama. No, ovaj austrijski brend ne staje tu, već neprestano pomiče granicu kvalitete i inovacija, s ciljem održavanja dugogodišnje tradicije i ekologije svijest. Dan Kűchen u vašem susjedstvu
Jedan od najljepših salona visokokvalitetnih kuhinja nalazi se u Čakovcu u Japa centru, na odličnoj lokaciji. Dođite i razgledajte kuhinje koje kombiniraju sofisticirani dizajn, funkcionalnost i dugotrajnost. S više od 50 godina iskustva, ovaj brend sinonim je za preciznost, inovacije i beskompromisnu kvalitetu, a vašem domu će pružiti rješenja koja odgovara-
Novi Dan Kűchen studio u Čakovcu, na adresi Ulica Zrinskih i Frankopana 2A, idealno je mjesto za sve koji žele transformirati svoj kuhinjski prostor. Za više informacija, kontaktirajte nas na broj +385 40 321 358 ili putem e-maila na dankuchen.cakovec@gmail.com.
Inspiraciju za kuhinju pronađite u salonu u Čakovcu
U salonu u Čakovcu vas čeka prostor prepun inspiracije, gdje ćete iz prve ruke moći vidjeti najnovije modele, isprobati različite materijale i završne obrade te uz stručne savjete kreirati svoju savršenu kuhinju. Uz besplatno 3D planiranje i personalizirano savjetovanje, dizajn vaše kuhinje nikada nije bio lakši i zabavniji.
ju najvišim estetskim i funkcionalnim zahtjevima.
Vječne boje i dizajn
Jedna od prepoznatljivih karakteristika Dan Kűchen kuhinja je elegantan dizajn u kombinaciji s funkcionalnošću. Svaka kuhinja pažljivo je osmišljena kako bi maksimalno iskoristila prostor i omogućila ugodno korištenje, s naglaskom na ergonomiju i prilagodbu potrebama svakodnevnog života. S fuzijom modernih i klasičnih stilova, Dan Kűchen nudi bezbroj opcija koje se mogu prilagoditi svakom ukusu. Paleta boja i materijala u ponudi omogućava potpunu personalizaciju – od visokog sjaja do mat završnih obrada, te od prirodnog drveta do industrijskog metala. Bilo da tražite suptilnu eleganciju ili izražajan dizajn, Dan Kűchen osigurava da svaka kuhinja bude jedinstvena.
Kuhinju nećete morati mijenjati desetljećima
Kada je riječ o dugovječnosti, Dan Kűchen je lider. Kada jednom odaberete Dan Kűchen kuhinju, budite sigurni da

je nećete morati mijenjati desetljećima. Vrhunski materijali osiguravaju da kuhinje izdrže intenzivnu svakodnevnu upotrebu, dok kvalitetni mehanizmi i jednostavne površine za održavanje olakšavaju život. Svaki proizvod prolazi rigorozne kontrole kvalitete, što jamči zadovoljstvo i povjerenje svakog kupca.
Potpuno personalizirana usluga
Jedan od najvećih benefita kupnje Dan Kűchen kuhinje je mogućnost potpune personalizacije uz savjetovanje s iskusnim stručnjacima. Svaka kuhinja kreira se prema specifičnim željama i potrebama kupca. Uz stručne dizajnere i montažere, vaša kuhinja neće biti samo vizualno atraktivna, već i besprijekorno funkcionalna, osmišljena da odgovara vašem načinu života.
Kuhinje su moderne i praktične
Radno vrijeme: Ponedjeljak – Petak:
Besplatno 3D planiranje i individualizirano savjetovanje
Posjetom Dan Kűchen studiju u Čakovcu, imate priliku konzultirati se s timom stručnjaka koji su tu da slušaju vaše želje i kreiraju rješenja po vašoj mjeri. Uz detaljnu analizu vaših potreba, kreirat će kuhinju koja će savršeno odgovarati vašem domu i stilu života. Sve to uz mogućnost besplatnog 3D planiranja, kako biste mogli vizualizirati vašu kuhinju prije nego što postane stvarnost.
Posjetite Dan Kűchen studio u Čakovcu i uživajte u:

Kuhinje će maksimalno iskoristiti vaš prostor
Oduševit ćete se funkcionalnošću Dan kuhinja
• Direktnom kontaktu s proizvodima: Osjetite različite modele, isprobajte materijale i donesite informiranu odluku.
• Personaliziranom savjetovanju: Stručni tim će vam pomoći kreirati kuhinju prema vašim specifičnim željama.
• Inspiraciji i idejama: Otkrijte inovativna dizajnerska rješenja koja možete implementirati u svoj dom.
• Vrhunskoj kvaliteti i jamstvu: Uvjerite se u kvalitetu izrade, materijala te saznajte više o garancijama, montaži i postprodajnoj podršci. DAN KÜCHEN u Čakovcu: Vaša savršena kuhinja na dohvat ruke




























PAULA LEVAČIĆ ostvarila svoju želju iz djetinjstva
- Najvažnije mi je da sam sigurna sama u sebe, rekla nam je prva pratilja Miss Međimurja, Paula Levačić iz Čakovca
Piše:
Jelena Tomašić
U svijetu mode i ljepote, natjecanja poput Miss Međimurja donose brojne prilike, ali i izazove. Paula Levačić, nova prva pratilja, nedavno je osvojila titulu koja je ispunila njezine snove iz djetinjstva. S ponosom i zahvalnošću, Paula dijeli svoje iskustvo i motivaciju koja ju je potaknula da se prijavi na ovo natjecanje.
Podrška obitelji i prijatelja bila je ključna, iako je istaknula kako je najvažnije od svega vjerovati u sebe. Ideal ljepote za našu Paulu nije samo fizički izgled, već i unutarnja ljepota koja dolazi do izražaja kroz emocionalno zdravlje. Kao uzore ističe svoju majku i kumu Silviju, žene koje su joj bile podrška kroz sve izazove. U razgovoru otkriva kako se nosi s pritiscima javnog života, ističući da uživa u svakom trenutku.
- Kako se osjećate sada kada ste osvojili titulu prve pratilje za Miss Međimurja?
- Još sam uvijek pod emocijama. U meni su osjećaji ponosa, sreće i zahvalnosti za ovaj trenutak o kojem sanja većina curica u djetinjstvu. I moja želja iz djetinjstva je sada ostvarena. Velika mi je čast biti prva pratilja za Miss Međimurja.
- Što vas je motiviralo da se prijavite na natjecanje?
- Motivacija za ovim natjecanjem krenula je prije 5 godina kada sam zakoračila u svijet mode. Moje prvo iskustvo bilo je u jednoj od najpoznatijih svjetskih agencija – IMG MODELS. Ipak sam za prioritet postavila završetak školovanja i sada kada je to poglavlje mojeg života završeno, došlo je vrijeme za nove izazove.
- Kako ste se pripremali za natjecanje?
- Smijat ćete se kada Vam kažem haha... Hodala sam hodnikom svoje zgrade i vježbala „model walk“. Pokušala sam sama sebi biti žiri, postavljati si pitanja i sama sebe ocjenjivati. Što se tiče njege tijela i kože moj fokus je bio uglavnom na “skincare“. Pazim naravno i na prehranu i redovito vježbam.
- Koje su vaše najdraže uspomene s ovog natjecanja?

- Kao najdraže uspomene ostat će mi nova prijateljstva s djevojkama. Tijekom priprema funkcionirale smo kao prava mala ženska obitelj. Ostat će mi u sjećanju i ponos u očima mojih najbližih iz publike u trenutku proglašenja. Suze radosnice u očima mojeg dečka Patrika.
- Kakvu ulogu igra podrška obitelji i prijatelja u vašem životu?
- Podrška obitelji i prijatelja mi je važna, ali ne i presudna. Slušam svoj unutarnji glas i vodim se njime. Najvažnije mi je da sam sigurna sama u sebe, tad znam da ću uspjeti.
- Kako planirate iskoristiti ovu titulu da biste doprinijeli zajednici?
- Ova titula zasigurno će mi pomoći da upoznam nove
ljude, a kroz nova poznanstva i javne nastupe želim svjedočiti da nikad nije kasno da ostvarimo svoje snove, da idemo prema svojim ciljevima. Nekad je taj put težak i trnovit, ali na kraju se ipak isplati.
- Koje društveni ili humanitarni projekti vas najviše zanimaju?
- Želim se više posvetiti promicanju borbe protiv nasilja nad ženama. Iskoristit ću ovu titulu upravo za taj cilj. I sama sam svjedočila različitim vrstama nasilja, nadam se da će se moj glas sada jače čuti. Svim ženama želim poručiti: nemojte trpjeti nasilje! Mi žene možemo sve!
- Kako biste opisali idealnu ljepotu?
- Idealna ljepota je za mene kombinacija unutarnjeg i vanjskog. Danas, kada je uglavnom fokus na fizičkom, potrebno je isticati važnost unutarnje ljepote. Da biste bili iznutra lijepi morate njegovati duhovnu i emocionalnu komponentu. Kada je to iznutra posloženo kako treba, tad ni fizičko ne izostaje. Naravno, smatram da je izuzetno bitno voditi računa o svojem tijelu. Preferiram prirodnu ljepotu. Volim kod žene vidjeti da ima njegovano lice i ruke sukladno svojoj dobi.
- Koji su vaši omiljeni hobiji ili interesi izvan svijeta mode?
- Moji interesi su uglavnom vezani za trendove u svijetu mode i ljepote. Ako moram nešto izdvojiti izvan
toga, onda bi to bila organska proizvodnja. To je nešto što pratim i što me posebno zanima. Tu je naglasak na ekološkim BIO proizvodima koje i sama koristim u svakodnevnoj prehrani. Od hobija bih istaknula uživanje u adrenalinskim sportovima, posebno volim voziti quad.
- Koga smatrate svojim uzorom i zašto?
- Moj uzor je moja majka. Žena koja je u mojim godinama počela raditi poslove koje danas rade muškarci. Imala je težak život, puno se odricala zbog mene i brata, izgubila je osobe koje je izuzetno voljela, a ipak i dalje korača uzdignute glave i s osmijehom na licu. Uvijek je bila ustrajna, prava podrška, zaštitnica obitelji, ponosna na nas i odgojila me
u osobu kakva na kraju krajeva i jesam danas. Nikad nije razmišljala o odustajanju i njezina inspiracija bili smo mi – djeca. Ostavila je za sobom brojne vrijednosti i meni pokazala kakva osoba ja želim biti. Drugu osobu koju želim spomenuti je moja kuma Silvija Šiljeg, moj oslonac u svemu što sam prolazila, osoba s kojom dijelim i lijepe i tužne trenutke. Sretna sam što su ove dvije žene dio mojeg života.
- Kako se nosite s izazovima i pritiscima javnog života?
- Uživam u svemu što mi se trenutno događa i veselim se izazovima ove vrste. Ne ometa me pritisak ili izazovi javnog života. Kao i za sve ostalo, svladam i organiziram se. Podijelim svoje obaveze na tri kategorije i prema tome odrađujem sve ostalo. Također, volim svoj život prikazivati javnosti putem društvenih mreža snimajući vlogove. Većinom sve objavljujem na svojem Instagram profilu: @itspaulla79.
- Koji su vaši planovi za budućnost nakon osvajanja titule?
- I dalje ću nastaviti marljivo raditi posao koji radim. Ako bude prilike, rado ću sudjelovati u aktivnostima vezanim za svijet mode i ljepote. Želja mi je u budućnosti otvoriti svoj beauty salon.
- Kako biste opisali svoju osobnost u tri riječi?
- Ambiciozna, uporna i energična.
- Koje osobine smatrate najvažnijima za uspjeh u ovom natjecanju?
- Samopouzdanje, karizma i inteligencija. Potrebno je vjerovati u sebe, imati ono nešto i biti pametan da se ostane na pravom putu.
- Što biste poručili djevojkama koje razmišljaju o sudjelovanju u natjecanju poput ovog?
- Ne odustajte od svojih želja. Čak i ako ne postanete vlasnica lente ili krune, bogatije ste za jedno predivno iskustvo i za nove ljude u vašim životima.




9. FESTIVAL međimurskih slastica Bakini kolači







Na ovogodišnjem festivalu sudjelovalo je čak 20 udruga, a ocjenjivalo se 27 različitih gibanica
Piše: Aleksandra Sklepić
U subotu, 28. rujna 2024. u vremenu od 11 do 14 sati, u atriju Starog grada u Čakovcu održan je 9. Festival međimurskih slastica pod nazivom “Bakini kolači”. Festival svake godine organizira Udruga za očuvanje kulturne baštine “Međimurska gruda” iz Dunjkovca. Ova manifestacija održava se u sklopu “Jeseni u gradu Zrinskih” te povodom Svjetskog dana turizma. Svake je godine zadan kolač koji će se ocjenjivati, a ovogodišnji kolač za ocjenjivanje bila je međimurska gibanica. Povjerenstvo za ocjenjivanje imalo je, kao i svake godine, težak zadatak odabrati koja je gibanica najbolja, s obzirom na to da je na festivalu sudjelovalo čak dvadeset udruga, a ocjenjivalo se čak 27 gibanica. Bodovalo se bogatstvo okusa, autentičnost i vjernost tradicionalnom receptu po kojem je gibanica pripremljena. Festival je bio natjecateljskog, izložbenog i prodajnog karaktera, pa je uz gibanicu, bilo svakakvih vrsta domaćih kolača: štruce,




kiflice, pogače, zlevanke, torte, cvirkači, linzeri, keksi, kokosovi kolači, klipići, te brojne druge vrste kolača pečenih po receptima naših baka. Manifestaciju su posjetili župan Međimurske županije Matija Posavec, gradonačelnica Čakovca Ljerka Cividini, gradonačelnik Murskog Središća Dražen Srpak, načelnik Općine Belica Zvonimir

iz Pretetinca osvojile posjetitelje velikim izborom kolača i torti: Zdenka Leček, Blaženka Kukolić, Štefica Ganzer, Dragica Trupković, Senka Strah, Jelena Ganzer
Taradi te načelnik Općine Nedelišće Nikola Novak i na taj su način pružili podršku svim sudionicima ovogodišnjeg festivala. Čaroliji tradicijskog doživljaja doprinijeli su i predivno uređeni ukrašeni stolovi, na kojima su se mogli naći ručni radovi i cvijeće, kako su to u davnim vremenima ukrašavale naše bake.

Prvo mjesto sa svojom međimurskom gibanicom osvojila je Nada Farkaš iz Krištanovca, članica Udruge žena Krištanovec, drugo Trstenjak Stanislav iz Marofa sa svojim OPG-om, a treće Maja Nikolić iz Čakovca, članica Udruge Zlatne ruke iz Čakovca. Nagradu za “izvorno međimursko” osvojile su autentično odjevene članice Udruge žena Belica.
Za sve natjecatelje bio je, kao i svake godine, priređen prigodan poklon koji su osigurali višegodišnji sponzori. Festival Bakini kolači svake godine okuplja sve više posjetitelja te je to pokazatelj da se kulturna baština našeg Međimurja i dalje vrijedno njeguje, kako među starijim, tako i među mladim sudionicima i posjetiteljima.

Članice Udruge žena Belica osvojile nagradu za “izvorno međimursko”: Marija Magdalenić, Rada Taradi, Katarina Sabol, Štefica Dodlek, Darinka Hajdarović i Marija Mesarić






pobjedničku međimursku
gibanicu:
Sastojci za tijesto:
- 75 dag glatkog brašna
- 75 ml ulja
- malo soli
- mlaka voda
Sastojci za nadjeve:
- 1,5 kg šećera
- 1,5 kg ribanih jabuka
- 1 kg svježeg sira
- 0,5 kg oraha
- 0,5 kg maka
- 3 komada jaja
- mlijeko po potrebi za orahe i mak
- malo cimeta
- vanilin šećer
- limunova korica
- malo ruma za kolače
- mast Za premazivanje:
- 3 dl kiselog vrhnja

Priprema međimurske gibanice: Zamijesiti tijesto od gore navedenih sastojaka. Podijeliti ga na pet jednakih kuglica, premazati uljem i ostaviti da odstoje jedan sat. Što više ulja premažemo, tijesto je bolje. Priprema nadjeva: Nadjev od jabuka: naribane jabuke, šećer, cimet i vanilin šećer zajedno prodinstati. Nadjev od sira: sir pomiješati s malo šećera, malo soli, naribanom limunovom koricom i jednim žumanjkom. Na kraju dodati snijeg od jednog bjelanjka.
Nadjev od oraha: orahe, šećer, vanilin šećer i malo ruma pomiješati i zaliti vrućim mlijekom i prokuhati. Na kraju dodati snijeg od jednog bjelanjka. Nadjev od maka: mak, šećer, vanilin šećer i malo ruma pomiješati i zaliti vrućim mlijekom i prokuhati. Na kraju dodati snijeg od jednog bjelanjka.
Tijesto razvući da se dobije pet jednakih kora, premazati prije nadjeva otopljenom masti i slagati gibanicu.
Redoslijed slaganja: tijesto, nadjev od oraha, tijesto, nadjev od sira, tijesto, nadjev od maka, tijesto, nadjev od jabuka i na kraju zadnji sloj tijesta. Prije pečenja gibanicu premazati kiselim vrhnjem i staviti peći u zagrijanu pećnicu na 180 stupnjeva (ovisi o pećnici), oko 1 sat. Prije rezanja ostaviti na sobnoj temperaturi da malo odstoji.
NEVJEROJATNA PRIČA NIKOLE BORIĆA, modernog Robinsona koji je svoj mir pronašao na planini
- Lokacija je Park prirode Papuk. Tražio sam je 7 godina i postavio sam 22 stavke. Rekao sam da neću kupovati zemlju dok ne ispunim sve 22 stavke. Bilo mi je bitno da ima izvor vode, ispričao nam je svoju nevjerojatnu priču Nikola Borić
Piše: Jelena Tomašić
U ovom užurbanom svijetu, ne razmišljamo koliko se lijepih stvari događa oko nas koje ni ne primjećujemo. Nikola Borić jedan je od primjera koji emotivno prikazuje i prepričava duboki dodir s prirodom. Imali smo prilike popričati s njim u Čarobnoj šumi, gdje je održao predavanje Život u skladu s prirodom te nam na kraju predavanja predstavio svoju knjigu Život u šumi. Nakon godina istraživanja i razmatranja, odabrao je Park prirode Papuk kao lokaciju za novi početak. Život u prirodi donio mu je brojne promjene – od ritma života koji se prilagođava godišnjim dobima do svakodnevnih obaveza vezanih uz brigu o životinjama i vrtu. U nastavku razgovaramo o njegovim motivima, izazovima i svakodnevnim rutinama.
- Što vas je potaknulo na promjenu iz urbanog u prirodni život?
- Potaknuo me besmisao urbanog života, gdje si ti ustvari rob. Delaš da bi si mogao napraviti kuću, da bi mogao jesti, da bi mogao odgajati djecu. Ustvari je to sve besplatno.
- Kako ste odabrali lokaciju za svoj novi dom u prirodi?
- Lokacija je Park prirode Papuk. Tražio sam je 7 godi-
na i postavio sam 22 stavke. Rekao sam da neću kupovati zemlju dok ne ispunim sve 22 stavke. Bilo mi je bitno da ima izvor vode, da ima potok koji prolazi kroz parcelu pitke vode, da je park prirode ili nacionalni park, da je šuma, da je južna padina, da je daleko od ljudi i da je jeftino naravno. Tražio sam po cijelom svijetu. Obišao sam srednju Ameriku, Kostarika mi je bila jako interesantna, Indija, sjeverna i istočna Afrika, Bali. Opcije su mi bile po cijelom svijetu. Otišao sam na Kostariku dva mjeseca gdje sam tražio zemljište. Ne veže me nikakvo mjesto ni daljina mi nije bila problem.
- Koje su neke od najvećih razlika koje ste primijetili između života u gradu i u prirodi?
- Nema stresa, sve ide polako. Nema rutine, svaki dan je drugačiji. Živite po sezonama - proljeće, ljeto, jesen, zima. Primjećujete jako puno stvari koje ne možete primjetiti dok ste u gradu.
- Kako izgleda vaš tipičan dan u prirodi?
- Nema tipičnog dana. Imamo jako puno životinja i imamo obaveze koje moramo odraditi. Nahraniti životinje, otići s njima van na ispašu, otvoriti kokice, zatvoriti kokice radi lisice. I tako, to su obaveze koje

moramo odraditi. Imamo i konje, ovce, koze, svinje, guske, patke, pse, mačke. Jako velika obitelj.
- Jeste li se suočili s nekim izazovima prilikom adaptacije na život u prirodi?
- Cijelo vrijeme je izazov. Izazov nikada nije ni prestao. Nisam došao na neku djedovinu. Nisam došao negdje gdje je sistem uhodan. Pošto nisam imao pojma o ničemu, nisam imao nikakvih prethodnih znanja. Rođen sam u Zagrebu i zadnjih 20 godina sam živio u Istanbulu s 20 milijuna stanovnika, Berlin, Amsterdam. Znači došao sam s asfalta. Svaki dan mi je novi izazov.
- Kako nabavljate hranu? Imate li vlastiti vrt ili koristite lokalne izvore?
- Imamo sve. Imamo svoje meso, sve vrste mesa. Imamo i svoje povrće, svoje voće. Jako puno skupljamo šumske plodove. U dućanu nismo bili proteklih 3 mjeseca. Treba mi tipa kava. Nije da mi treba, ali ne želim je se odreći. Nije to potreba, nemam potrebe, ali želim si ujutro popiti kavu! Mogao bih vjerojatno bez nje. Tipa ne možemo proizvoditi sol, tipa začine papar... Pošto imam jako svojih viškova, njih mijenjam s drugim OPG-ovima. Sol mijenjam s jednom solanom iz Makar-
NOVI KOZMETIČKI SALON
Precious time u Štrigovi
Rezervirajte svoj termin za opuštanje u novom kozmetičkom salonu
Štrigova je dobila novi kozmetički salon pod nazivom Precious Time. Kao
što samo ime salon govori, ovaj je salon otvoren za opuštanje i bijeg od svakodnevnice te posvećivanje samoj sebi. Salon je otvorila Danijela Nemec Baran, medicinski kozmetičar s bogatim

Svoju milijunsku tvrtku poklonio
Zanimljivo je u ovom slučaju to, kako pišu nacionalni mediji, da je Nikola Borić ranije posjedovao vlastitu tvrtku vrijednu nekoliko milijuna dolara u Kini, ali ju je poklonio prijatelju za rođendan i krenuo pronaći svoj mir u prirodi. Nikola je inače diplomira-
ske, koja radi najkvalitetniju sol – cvijet soli. Cvijet soli je esencija soli. Jednom u tri mjeseca mi njima pošaljemo paket s našim proizvodima, i tak isto sa suhim smokvama, mandarinama. Stvari koje mi ne možemo imati, mijenjamo. Nije to masovni uzgoj, to je uzgoj više za svoje potrebe. - Kako se nosite s vremenskim uvjetima i prirodnim nepogodama?
- Ove godine je bila užasna suša. Ne mogu reći da smo se dobro nosili. Nikad nije bila ovakva suša. Imali smo jako velikih problema za napajanje životinja. Vremenski uvjeti su postali,
Salon se nalazi na adresi Štrigova 22, u zgradi gdje je nekada bio kafić Čavlek, preko puta PBZ banke.
U Precious Time salonu nudi se širok spektar tretmana za njegu i opuštanje. Odaberite jednu od masaža i opus�te se te otklonite bol i napetost u leđima:
iskustvom stečenim izvan granica Hrvatske. Danijela je završila školu za medicinskog kozmetičara, a nakon rada u prestižnim hotelima u Austriji, odlučila se vratiti u rodni kraj te otvoriti vlastiti salon. Iskustvo i znanje stečeno u visokostandardiziranim salonima odlučila je prenijeti klijenticama iz Međimurja.
• Masaža �jela
• Parcijalna masaža
• Hot stone masaža
• Pinda Sweda masaža
• Limfna drenaža lica
• Masaža lica
Osim masaža, salon se specijalizira za kozme�čke tretmane


Osvojene kino ulaznice dobitnici mogu iskoris�� zaključno s datumom 16.10.2024. u CineStaru Varaždin.

ni kineziolog koji je radio s brojnim uspješnim sportskim facama, zahvaljujući čemu je vidio dijelove Zemlje o kojima mnogi samo sanjaju. Imao je sve, a sada je preokrenuo cijeli svoj život samo s jednim ciljem. Naći mir, a pronašao ga je u prirodi.
rekao bi, ekstremniji. I od jačine vjetra, i od padalina, puše, snijega uopće nema. Ne mogu opće reći i teško mi je odgovoriti kako se nosim jer ne znam što će me dočekati iduće godine. Nisam se na primjer mogao pripremiti na sušu ove godine jer nije mi bilo uopće na kraj pameti da svi potoci mogu presušiti.
- Koliko vam je važna �izička aktivnost u svakodnevnom životu?
- Inače sam sportaš. Bio sam 7 godina reprezentativac, ali sad toliko �izički radim da se ja jednostavno ne mogu više baviti sportom. Cijelo vrijeme se krećem.
koristeći visokokvalitetne proizvode Arkana iz Poljske i Thalion iz Francuske. U ponudi su i:
• Li�ing trepavica i obrva
• Klasično bojanje trepavica i obrva
• An�celulitni tretmani
• Maderoterapija lica i �jela
Precious Time stvoren je s ciljem pružanja vrhunskih usluga koje će zadovolji� potrebe svakog klijenta. Dođite u salon i uživajte u profesionalnim tretmanima u opuštajućem ambijentu!
Rezervacije termina moguće su na broj mobitela 099/2032559.
Dobitnik ulaznica za film: Mateo Juričan DIJELIMO 1 x 2 ULAZNICE za film Genijalna prevara
Svake srijede potražite najavu nagradnog filma na našem portalu www. mnovine.hr i facebook stranici. Sve što trebate napravi� je do srijede do 9 sa� napisa� zašto biste baš vi trebali osvoji� besplatne ulaznice. Nakon toga u petak nabavite novi �skani broj “Međimurskih novina” te na zadnjoj stranici rubrike “Media” potražite svoje ime. Sretno!
Ulaznice koje ste osvojili podižu se na blagajni kina uz predočenje osobne iskaznice. Čitatelj koji je jedanput osvojio ulaznice ne može više taj mjesec sudjelova� u našoj nagradnoj igri. Molimo vas da uvažite ovo pravilo.






















Piše: Jelena Tomašić
Foto: Mario Golenko









Kombinacija šarene šetnje Ines i Tanje po gradu




Žuta boja predstavlja sreću, a crvena ljubav









Smeđa boja odličan je izbor za prve jesenske dane




































Iz dućana zelenim ou�itom u grad



Dami u bijelom savršeno pristaju žute naušnice i cipele










Majka i kći savršeno su se uskladile, a kišni dan ne može im sta� na kraj







































Domaćin je sjajno otvorio utakmicu i poveo 5:1, ali su gosti brzo uhvatili priključak. Iako su se dobro držali desetak minuta, Čakovčani su pobjegli na 17:10. Do poluvremena Dubrava je smanjila zaostatak na 18:14. U drugom poluvremenu domaćini su čuvali prednost, a Dubrava je posljednju ozbiljnu prijetnju imala u 40. minuti kod 23:20. Serijom 3:0 Čakovčani su poveli 26:20 i osigurali pobjedu. Konačan rezultat bio je 34:30, uz 17 obrana Vita Horvata i po osam golova Tina Bakovića i Brune Levaka. Čakovec: Horvat V. (17 obrana), Marciuš, Baković L. 2, Zadravec 4, Tkalčec, Kranjec, Varošanec, Lukac, Ćuk

Nakon Bjelin Spačve i Varaždina 1930, rukometaši Čakovca pobijedili su i Dubravu 34:30 te ostali u vrhu Paket24 Premijer lige – Lige B.

3, Tompić 5, Levak 8, Baković T. 8, Đurčević, Goričanec , Malovic 1, Friščić 3. Trener: Josip Borković. Nakon treće pobjede izborene u četiri kola MRK Čakovec sa 6 bodova dijeli drugo mjesto s Goricom. Nadmoć Čakovčana priznao je i gostujući trener, legendarni Vlado Šola. – Prije svega bih čestitao protivničkoj ekipi na pobjedi i na fer igri te na dobroj atmosferi u dvorani. Možda da smo zabili koji zicer više, možda bi to bilo i dramatičnije na kraju. Samo ću još reći da mi je drago da postoji sredina kao što je Čakovec gdje je puna dvorana, gdje ljudi uživaju u rukometu, podržavaju svoju
- Prije svega čestitke igračima Dubrave na fer i korektnoj igri i čestitke našoj momčadi na pobjedi. Obrane vratara Vite Horvata bile su faktor koji nam je možda falio u prvih nekoliko kola, ali svako kolo netko drugi iskače pa je tako ovu utakmicu to bio golman. Navijači su nam NADMOĆ
ekipu i navijanjem i na način da kupe karte, kazao je Šola. Naravno da je zadovoljniji od njega bio domaći strateg Joža Borković. - Čestitam našim dečkima na borbenosti i zalaganju u cijeloj utakmici. Hvala navijačima i pozivam ih da i dalje dolaze u što većem broju, oni nam puno znače i naša su podrška. Vito je bio na razini, koliko su nam vratari bili skromni u prijašnjim utakmicama, toliko je to danas stvarno bilo odlično pa smo onda imali i neku sigurnost, kazao je poslije utakmice domaći strateg.
Sretan i zadovoljan je poslije utakmice bio i Fran Friščić, igrač Čakovca:

Čakovec trese prava euforija
UNAPRIJED ODIGRANI susret 4. kola 1. HRL za žene
Igračice Podravke Vegete lako su došle do nove pobjede u domaćoj ligi, a krajnji rezultat bio je 38:24. Nakon izjednačenih prvih petnaest minuta, od 14. do 20. minute stigle su do serije 7:1, čime su povele s osam golova razlike. Na poluvremenu je bilo 19:11, a sjajna Andrea Šimara bila je nezaustavljiva. U drugom dijelu Čakovčanke nisu mogle smanjiti razliku, a Zrinski je sredinom drugog poluvremena prvi put bio na minus deset (28:18). Najveća prednost domaće ekipe iznosila je
Druga ekipa Zrinskica u subotu je prvi put u novoj sezoni zaigrala kod kuće te upisala pobjedu protiv ŽRKa Pitomača 36:29 (16:11), uz 15 golova Rahele Varge.
plus 15 u završnici. S osam pogodaka iz osam pokušaja najbolja je kod Podravka Vegete bila Andrea Šimara. Kod Zrinskica četiri rukometašice
- Veterani MRK-a Čakovca osvojili su Međunarodni veteranski turnir u Slavonskom Brodu i tako obranili prošlogodišnju titulu, a Igor Krajner proglašen je najboljim strijelcem turnira
dali veliki vjetar u leđa, kao što sam rekao, osmi igrač, i hvala im još jednom i pozivam ih na sve sljedeće utakmice, kazao je Friščić.
U 5. kolu čakovečki rukometaši gostuju u Karlovcu, a utakmica se igra u subotu 5. listopada u 17:00. (md, foto: MRK Čakovec)
s po četiri pogotka – Gabrijela Gudelj, Bruna Zrnić, Una Ivančić i Magdalena Rumek. ŽRK Zrinski: Jerković (0), Makarova (6); Posavec (2), Novak, Gudelj (4), Golub (2), Janković (2), Varga (1), Zrnić (4), Potočnjak, Ivančić (4), Rumek (4), Ljubić, Robida (1). Trener: Vladimir Vujović. - Za ovu utakmicu nismo se niti spremali, kako god da se spremimo ne bi bilo dostatno. Mi smo odigrali ovo da se pripremimo za daljnji tijek prvenstva i jednostavno ja sam djelomično zadovoljan.
Nezadovoljan sam što nam se Bruna Zrnić ozlijedila, to nismo računali, a ostalo je u okvirima realnosti, rekao je Vladimir Vujović, trener ŽRK-a Zrinski.
- Znali smo što nas čeka, jedna teška utakmica, najbolja hrvatska ekipa s druge strane. Odigrali smo svoje, dobro nam je poslužilo kao uvertira za teške utakmice koje nas čekaju. Prva je Koka za 10 dana, a Podravki želim svu sreću u Europi i dalje, rekla je Gabriela Gudelj, igračica ŽRK-a Zrinski. (md)
VETERANSKO PRVENSTVO Hrvatske
Brončano
U subotu je na streljani Vrapčanski potok u Zagrebu održano je Prvenstvo Hrvatske za veterane u streljaštvu, gdje su uspješno nastupili i članovi Streljačkog društva Mihovil iz Čakovca. U disciplini pištolj/ revolver 15+15, ekipa u sastavu Antun Ladić, Antun Grošanić i Tomislav Jaranović osvojila je treće mjesto s ukupno 796 krugova. Zlato su donijeli strijelci Sv. Mihovila iz Lučkog s impresivnih 828 krugova, dok su srebro osvojili natjecatelji iz kluba Centar iz Splita, pogodivši 819 krugova.
Osim osvajača medalja, za SD Mihovil su nastupili
KOŠARKA
i Josip Srpak, Branko Sušec, Damir Novak, Roman Petrović te Slobodan Veinović, čime je klub imao značajnu zastupljenost na natjecanju. Ova brončana medalja ima poseban značaj za klub, budući da je to njihova prva medalja u ekipnoj konkurenciji s Prvenstva Hrvatske, čime se potvrđuje napredak u kvaliteti rada unutar kluba. Sve veći broj medalja, kako u pojedinačnim, tako i ekipnim natjecanjima, pokazuje kako klub raste i napreduje te da je njihov rad prepoznat i na nacionalnoj razini. (lp)
KUP KREŠIMIR ČOSIĆ
U subotu finale u Donjem Kraljevcu
U subotu 5. rujna s početkom u 18 sati u dvorani Osnovne škole Donji Kraljevec igra se �inalna utakmica Kupa Krešimir Čosić za Međimursku županiju. Igrat
LIGA DJEČAKA U-13
će domaćin Donji Kraljevec i čakovečki drugoligaš Međimurje koje je u polu�inalu s dvadesetak koševa razlike nadjačalo Čakovec. (bh)
Ovoga vikenda kreće se s odigravanjem utakmica
Liga dječaka za mlade igrače rođene 2012. i mlađe. Liga broji čak 10 klubova koji su podijeljeni u dvije skupine gdje će igrati svaki sa svakim. Onda će prva dva tima iz svake skupine igrati Final four (21./22. prosinca) po sistemu A1-B2 i A2-B1 u po-
lu�inalima, pa pobjednici u �inalu odlučuju o prvaku, a poraženi igraju za treće mjesto. Skupinu A sačinjavaju Dubravčan iz Donje Dubrave, Vinica, Gra�ičar iz Ludbrega, Varteks Varaždin i Čakovec. Skupinu B sačinjavaju Varteks 2, Rudar iz M. Središća, Varaždin, Donji Kraljevec i čakovečko Međimurje. (bh)




NOGOMETNI SEMAFOR međimurskih liga
Centrometalu susjedski derbi, Plavima derbi začelja, Sokol slavio u Novom Selu Rok, Borac PMP svladao Trnovec hat-trickom Ivana Drka.
Piše: Dino Jambrović
U Premier ligi, Draškovec je nakon tri uzastopna poraza stigao do pobjede protiv Podturna. Nakon prvog dijela vodstvo gostiju zgoditkom Josipa Lepena. Početkom drugog dijela za domaćine izjednačuje Diego Campos da Silva. Pobjedu domaćinu donosi Vedran Vinko u 65. minuti. Preokret Dinama. Lovro Rebrek zabija za vodstvo Dubravčana u 58. minuti. Domaćini izjednačuju desetak minuta kasnije preko Josipa Fažona. Joker s klupe Ladislav Nađ zabija za 2-1 u 77. minuti. Za Palovčane je u 84. minuti opravdano dosuđen kazneni udarac. Siguran realizator bio je Edi Lacković. “Vruće“ u Pretetincu. Međimurec dolazi u vodstvo zgoditkom Bojana Vručine u 43. minuti. Za domaćine je u 53. minuti opravdano dosuđen kazneni udarac. Siguran s 11 metara bio je Vručina. U posljednjoj minuti utakmice Slogi je isključen Nikola Ferlin, zbog držanja i hvatanja za vrat protivničkog igrača tijekom igre. Po završetku utakmice jedan gostujući navijač prilikom izlaska s terena izbija loptu iz ruku suca utakmice, nakon čega istog pokušava redar spriječiti u daljnjem postupku prema sucu te ga navijač udara preko ograde. Nakon toga dolazi do naguravanja više osoba, ali se sve u kratkom vremenu smiruje. U vrlo nervoznom susretu, kod obje momčadi po čak petorica požutjelih. Centrometalu susjedski derbi. Nakon prvih 45 minuta igre vodstvo gostiju zgoditkom Jure Kosa. Početkom drugog dijela mrežu vratara Jedinstva Alena Đurmana pogađa Vedran Kršlak. Isti igrač potvrđuje pobjedu Centrometala u 85. minuti. Minimalna pobjeda Spartaka. Mladost Komet i dalje ne zna za bod(ove) te su doživjeli šesti uzastopni prvenstveni poraz ove sezone. Odlučujući trenutak utakmice, dogodio se u 63. minuti. Pobjednički zgoditak domaćina djelo je Srećka Šegovića. Istim rezultatom Venera PMP slavila je u Svetom Martinu na Muri, gdje svoje domaće utakmice igra Bratstvo iz Jurovca. Gosti su stigli do sva tri boda zahvaljujući zgoditku domaćeg igrača Dominika Filipovića u vlastitu mrežu u 59. minuti. Ovo je Veneri PMP prva prvenstvena pobjeda ove sezone. Bez pobjednika u Donjem
Kraljevcu. BSK je poveo u 24. minuti zgoditkom Darija Šmita. Konačan rezultat utakmice postavlja David Mihoci u 36. minuti. U prvom dijelu domaćini pogađaju gredu, a u drugome gosti. Prema prikazanome na terenu za igru, to je i bio najrealniji ishod ovog susreta.
Rezultati: Draškovec –Podturen 2-1 (Diego, Vinko ; Lepen), Dinamo (P) – Dubravčan 3-1 (Fažon, Nađ, Lacković ; L.Rebrek), Međimurec – Sloga (Š) 2-0 (2x Vručina), Jedinstvo (GM) – Centrometal 0-3 (2x Kršlak, Kos), Spartak – Mladost Komet 1-0 (S.Šegović), Bratstvo (J) – Venera PMP 0-1 (Filipović ag), Kraljevčan 38 – BSK 1-1 (Mihoci ; Šmit)
U sljedećem kolu sastaju se:Subota: Venera PMP –Dinamo (P), Mladost Komet – Bratstvo (J), Centrometal – Spartak, Podturen – Međimurec, Nedjelja: BSK – Draškovec, Dubravčan – Kraljevčan 38, Sloga (Š) – Jedinstvo (GM). Utakmice se igraju s početkom u 16 sati.
I MEĐIMURSKA LIGA
U I. međimurskoj ligi, Plavima derbi začelja. Dvostruki strijelac za Pekleničane bio je igrač-trener Robert Jezernik, dok su po jedan zgoditak postigli Josip Žganec, Siniša Čeko i Yuya Morii. Za Croatiju su zabijali Henryque Duarte i Niko Jančec. Bez pobjednika u Hodošanu. Dominik Gašparić dovodi Mladost u prednost zgoditkom u 53. minuti. Za domaćine izjednačuje Zoran Strahija u 68. minuti. Gosti ponovno vode u 82. minuti, strijelac Marko Ivković. Bod Hodošanu donosi Vito Strahija u petoj minuti sudačke nadoknade vremena. Pušćinama derbi kola. Nakon stopostnog učinka do ovog susreta, Čakovčani su poraženi. U 4. minuti momčad Pušćina ne uspijeva realizirati opravdano dosuđeni kazneni udarac, odnosno odlično je intervenirao gostujući vratar Karlo Kocijan. Ipak, domaćini su poveli zgoditkom Yuita Nakamure u 14. minuti. Početkom drugog dijela za Slogu izjednačuje Marin Tabaković. Pušćinama je u 58. minuti isključen Filip Pintarić, zbog dvije opomene. Robert Punčec zabija za 2-1 u 66. minuti. Slogaši po drugi puta na susretu izjednačuju u 75. minuti, strijelac Luka Marković. Samo tri minute kasnije gostujući kapetan Pero Oba-
dić, pogađa vlastitu mrežu te time domaćini dolaze do sva tri boda. Remi u Pribislavcu. U posljednjoj minuti prvog dijela susreta Marko Korošić zabija za Zasadbreg 77. Za gostujuću momčad je opravdano dosuđen kazneni udarac u 52. minuti. Siguran realizator bio je Bruno Šimunković. Petnaest minuta kasnije opravdano je dosuđen kazneni udarac i za domaćine. Precizan s bijele točke bio je kapetan Ivan Deglin. Igrač Poleta Mohamed Asli postavlja konačan rezultat u 74. minuti. Sokol slavio u Novom Selu Rok. Odlučujući trenutak utakmice dogodio se u 86. minuti. Tada, pobjednički zgoditak za Vratišinčane postiže Frano Mesarić. Za svakako najveće iznenađenje kola pobrinuo se Strahoninec, uvjerljivo slavivši u Cirkovljanu. Po dva zgoditka za goste postigli su Luka Lađević, Franjo Ladić i Fabricio Cruz. U 33. minuti isključen je gostujući trener Ivan Zobec temeljem dvije opomene koji je prigovarao sucu utakmice nakon jedne njegove odluke i po njegovom mišljenju nedosuđenog kaznenog udarca. Nakon isključenja trener je vulgarnim psovkama vrijeđao glavnog suca utakmice Gorana Tomičića. U spomenutoj situaciji delegat Marin Horvat smatra da je sudac utakmice pogriješio što nije dosudio kazneni udarac za gostujuću ekipu nakon što je u kaznenom prostoru srušen njihov napadač pa je upravo ta situacija dovela do prosvjeda i isključenja. Bratstvo do boda u završnici susreta. Nakon prvog dijela vodstvo Trnave zgoditkom Lucasa Da Coste. U drugom dijelu, točnije u 77. minuti bod Savčanima donosi Dalibor Frančić. Prema prikazanoj igri, to je bio i najrealniji rezultat ovog susreta.
Rezultati: Plavi – Croatia 5-2 (2x Jezernik, Žganec, Čeko, Morii ; Duarte, Jančec), Hodošan – Mladost (SM) 2-2 (Z.Strahija, V.Strahija ; Gašparić, Ivković), Pušćine – Sloga (Č) 3-2 (Nakamura, Ro.Punčec, Obadić ag ; Tabaković, Marković), Polet (P) –Zasadbreg 77 2-2 (Deglin, Robillard ; Korošić, Šimunković), Trnava – Bratstvo (SV) 1-1 (Da Costa ; Frančić), Omladinac (NSR) – Sokol 0-1 (F.Mesarić), Naprijed – Strahoninec 0-6 (2x Lađević, 2x Ladić, 2x Fabricio) U sljedećem kolu sastaju
se: Subota: Bratstvo (SV) –Omladinac (NSR), Sloga (Č)
– Polet (P). Nedjelja: Sokol – Naprijed, Zasadbreg 77 – Trnava, Mladost (SM) – Pušćine, Croatia – Hodošan, Strahoninec – Plavi. Utakmice se igraju s početkom u 16 sati.
II
U II. međimurskoj ligi, Slakovec je doživio prvi poraz ove sezone. Jadran je poveo u 8. minuti preko Dominika Topleka, a Sloboda izjednačila golom Kristijana Fegeša. Ilija Gale vratio prednost Slobodi, no Josip Kranjčec je izjednačio u 50. minuti. Luka Jurović iz penala i Emanuel Hadžić potvrdili su pobjedu Štefančana. Borac PMP je svladao Trnovec hat-trickom Ivana Drka, dok je počasni gol za goste dao Danijel Košak. Mura je slavila u Donjem Vidovcu golom Marka Šoltića, a Patrik Kovač obranio je kazneni udarac. ČSK ostaje stopostotan, a derbi začelja pripao je Ivanovčanima.
Rezultati: Sloboda (S) – Jadran 2-4 (Fegeš, Gale ; Toplek, Kranjčec, Jurović, Hadžić), Borac PMP – Trnovec 3-1 (3x Drk ; D.Košak), Vidovčan – Mura 0-1 (M.Šoltić), ČSK – Mladost (D) 2-0 (Begović, Alves), Mladost (I) – Budućnost (M) 3-2 (A.Jelenić, Gajnik, L.Jelenić ; Kolundžić, Majerić), Mali Mihaljevec – Hajduk (B) 0-3 (2x D.Buhanec, Senčar), Pobjeda – Drava (K) 0-3 (L.Kregar, Da Silva, Vitorino) U sljedećem kolu sastaju se: Subota: Drava (K) – Borac PMP, Hajduk (B) – Pobjeda, Mura – Sloboda (S). Nedjelja: Budućnost (M) – Mali Mihaljevec, Mladost (D) – Mladost (I), Jadran – ČSK, Trnovec –Vidovčan u Slakovcu. Utakmice se igraju s početkom u 16 sati.
III. MEĐIMURSKA LIGA – A
U III. međimurskoj ligi skupina A, Omladinac je upisao prvi prvenstveni poraz ove sezone. Pobjednički zgoditak Jedinstva, djelo je Petra Krizmana u 63. minuti. Dvije minute prije završetka susreta zbog međusobnog udaranja isključeni su domaći igrač Saša Novak i gostujući Saša Škvorc. Bez zgoditaka u Donjem Hrašćanu. U 16. minuti, opravdano je dosuđen kazneni udarac za Borac. Međutim udarac Ivana Udovčića, brani vratar Radničkog Sebastijan Salaj. Preokret Otoka. Galeb
je poveo zgoditkom Davida Granatira da bi na kraju bili uvjerljivo poraženi s 4-1. Za domaćine su redom zabijali Dejan Kočiš, Dominik Klarić, Filip Reif i Josip Igrec. Graničar slavio u Podbrestu. Strijelac za Budućnost bio je Petar Vlašić, dok su se u listu strijelaca za Novakovčane upisali Josip Barbarić, Robert Zorić i Jožek Blagus. Rezultati: Jedinstvo (NSnD) – Omladinac (DS) 1-0 (Krizman), Borac (DH) – Radnički 0-0, Otok – Galeb 4-1 (Kočiš, Klarić, Reif, Igrec ; Granatir), Budućnost (P) – Graničar (N) 1-3 (Vlašić ; Barbarić, Zorić, Blagus) U sljedećem kolu sastaju se: Subota: Graničar (N) –Jedinstvo (NSnD). Nedjelja: Galeb – Budućnost (P), Radnički – Otok, Omladinac (DS) – Borac (DH). Utakmice se igraju s početkom u 16 sati.
III. MEĐIMURSKA
LIGA - B
U III. međimurskoj ligi skupina B, bez pobjednika u Štrukovcu. Kapetan Torpeda Alen Hatlek zabija za 0-1 u 78. minuti. Desetak minuta kasnije opravdano je dosuđen kazneni udarac za Hajduk. Siguran realizator bio je Karlo Šardi. Preokret Slobode u susjedskom derbiju. Nakon prvog dijela Omladinac je imao vodstvo 1-0 zgoditkom Roka Mađarića. Za domaćine u 74. minuti izjednačuje Deni Pečarko joker s klupe. U 88. minuti opravdano je dosuđen kazneni udarac za Mihovljančane. Pobjednički zgoditak postigao je Krešo Kovač. Bez zgoditaka u Preseki. Napretku je u 24. minuti isključen Sabin Koprivec zbog dvije opomene. U posljednjoj minuti utakmice, momčad Bratstva ne uspijeva realizirati kazneni udarac te susret završava rezultatom 0-0. U pravoj golijadi, Donji Koncovčak je bio bolji od Paraga rezultatom 7-4. Četverostruki strijelac za goste bio je Patrik Cerovec, dok su po zgoditak još dodali Sourayel Bennani, Andrija Flac i Davor Gojnik. Strijelci za domaćine bili su Dario Balog, Amadeos Horvat, Faik Pec i Goran Oršoš. Dubrava slomila otpor Šenkovca u drugom dijelu susreta. Dva zgoditka za Sivičane postigao je Dino Halabarec, a po jedan Mihael Bobičanec i Mark Bistrović. Poraz gostiju ublažio je Roko Zemljić.
Rezultati: Hajduk (Š) –Torpedo 1-1 (Šardi ; Al. Hatlek), Sloboda (M) – Omladinac (M) 2-1 (Pečarko, Kovač ; Mađarić), Bratstvo (P) – Napredak 0-0, Parag – Donji Koncovčak 4-7 (D.Balog, A.Horvat, Pec, G.Oršoš ; 4x Cerovec, Bennani, Flac, Gojnik), Dubrava – Šenkovec 4-1 (2x Halabarec, Bobičanec, Bistrović ; R.Zemljić) U sljedećem kolu sastaju se: Subota: Šenkovec – Hajduk (Š), Napredak – Dubrava, Donji Koncovčak – Bratstvo (P), Torpedo – Sloboda (M). Nedjelja: Omladinac (M) –Parag. Utakmice se igraju s početkom u 16 sati.
NOGOMET
5. KOLO Magenta 1. HNL za žene igra se ovog vikenda
Utakmica između ŽNK-a Međimurje i ŽNK-a Osijek će se odigrati u nedjelju 6. 10. 2024. s početkom u 15:30 na stadionu SRC-a Mladost (glavni teren)
ŽNK Međimurje ove nedjelje igra domaću utakmicu 5. kola Magenta 1. HNL za žene sezona 2024./2025. protiv ekipe ŽNK Osijek iz Osijeka, višestrukih prvakinja Hrvatske. Naše djevojke i stožer nestrpljivo očekuju susret protiv renomiranih protivnica koje su ove godine opet zastupale hrvatski ženski nogomet u europskom natjecanju, pokušavši kroz kvali�ikacije ući u grupnu fazu UEFA Women’s Champions League, no nažalost nisu uspjele proći zadnju stepenicu. Bez obzira na sve, bit će to lijepi nogometni praznik za naš grad i županiju, te se nadamo velikoj podršci s tribina, jer će ona zasigurno pomoći našim djevojkama u nastojanju da stignu do pozitivnog rezultata.






- Pozivamo gledatelje na prvenstvenu utakmicu 5. kola Magenta 1. HNL za žene da podrže seniorsku žensku nogometnu ekipu ŽNK-a Međimurje. Utakmica između ŽNKa-a Međimurje i ŽNK-a Osijek, višestrukih prvakinja Hrvatske, će se odigrati u nedjelju 6. 10. 2024. s početkom u 15:30 na stadionu SRC-a Mladost (glavni teren). Ulaz na stadion je besplatan, poručuju iz međimurskog prvoligaša. Također, utakmicu možete pogledati u izravnom prijenosu na MaxSport televiziji.
POWERLIFTING
Uvjerljive u Kupu Prvenstvenu pauzu nogometašice Međimurja iskoristile su za odigravanje osmine �inala Kupa HNS za žene. Kao apsolutni favorit krenule su u utakmicu u gostima kod drugoligaša Koprivnice i već u prvom
dijelu opravdale tu ulogu. Tada je utakmica praktički i riješena jer su Čakovčanke na odmor otišle rezultatom 0:5. U nastavku još toliko golova u mreži domaćina za konačnih i visokih 0:10. Naje�ikasnija je bila Škrlec koja se tri puta upisala u strijelkinje. Mazuchova i Jimenez su postigle po 2 gola, dok su jedanput mrežu zatresle Damjanović, Katalenić i Vujević. Ovom pobjedom naše cure plasirale su se u četvrt�inale.
DOMINACIJA POZOJA nastavlja se i ove jeseni Pozoji ponovno na tronu
U muškoj ekipnoj konkurenciji ovo im je bio najbolji nastup u povijesti, ali i povijesti bench natjecanja u Hrvatskoj te su uvjerljivo zasjeli na prvo mjesto
Piše: Nikola Lukman
Foto: PLK Pozoj
Prvi je nastupio Andrija Železnjak u kategoriji kadeta do 74 kg i s totalom 575,5 kg osvojio naslov najboljeg kadeta natjecanja. Andrija je imao svih devet uspješnih liftova od kojih su se u total zbrajali: čučanj 190kg, bench 130 kg i mrtvo dizanje od čak 255,5kg. Upravo je ovo impozantno mrtvo dizanje najvrijedniji rezultat natjecanja čime je Andrija oborio državni rekord i po kojem bi na predstojećem europskom kadetskom prvenstvu bio među tri najbolja liftera te uzeo europsku medalju.
U istoj težinskoj kategoriji, ali u konkurenciji seniora, svoj je drugi nastup za klub ostvario Nikola Puh i napret-
kom od skoro 30 kg od prvog natjecanja pokazao veliki talent te ostvario 2. mjesto. U konkurenciji djevojaka prve nastupe u juniorskoj konkurenciji ostvaruje Melisa Matulin koja nakon europske bronce u bench pressu uspješno potvrđuje svoje mjesto i na powerlifting sceni. Melisa je oborila čak dva državna rekorda: popravila je svoj dosadašnji rekord u benchu na 81 kg te je s čučnjem od 112,5 kg i mrtvim dizanjem od 140 kg ostvarila ukupni total od 333,5 kg što je također novi državni rekord. Melisa je ukupno bila najbolja juniorka natjecanja i sveukupno 2. u konkurenciji svih natjecateljica. U bench press only smo već navikli na dominaciju Pozoja pa je tako Sindy Bubek s podignutih 82,5 kg u
kategoriji do 52 kg bila apsolutno najbolja natjecateljica, a Melisa koja je nakon powerliftinga, u istom danu, ponovno dizala u benchu s istim rezultatom kao Sindy, ali u kategoriji do 57 kg, bila ukupno treća. Melisa je napadala i državni rekord u trećem pokušaju ali je za 87,5 kg falilo malo koncentracije i izdržljivosti nakon cjelodnevnog odrađenog powerlifting natjecanja.
U muškoj konkurenciji je prvo ime natjecanja Nikola Fic koji je u kategoriji do 105 kg s benchom 195 kg bio najbolji natjecatelj. Drugi u ukupnom poretku sbvih natjecatelja je bio Goran Karamarković s benchom od 167,5 kg. Marko Braniša je kao i Fic sa 195 kg bio ukupno drugi u poretku veterana, a ostaje
Pionirke i kadetkinje
Međimurja bolje od Gorice
Pionirke i kadetkinje prošle subote su na stadionu SRC-u Mladost u Čakovcu odigrale susrete 3. kola Prve HNLŽ Mladeži protiv vršnjakinja iz Velike Gorice. Najprije su pionirke odigrale jednu dobru i uzbudljivu utakmicu, gdje su gošće prve mogle doći do pogotka, no ipak mreže su ostale netaknute u prvom dijelu susreta. U dru-
gom dijelu, naše djevojke bile su odlučnije i s dva pogotka stigle do vrijedne pobjede od 2:0. Pogotke su postigle Ena Madić u 41. minuti i Nera Štrek u sudačkoj nadoknadi. Pionirke su igrale u sljedećem sastavu: Turk, Voćanec, Škrlec, Štrek, Stipan, Pokos, Tuksar, Madić, Novak, Vurušić, Raimund (Branilović, Žganec, Turk, Tkalčec, Leskovar, Horvat i Strahija)
Trener: Karlo Kovačević. Kod kadetkinja potpuna dominacija naše ekipe, koja je odličnom igrom stvorila mnogo prilika, od kojih je realizirano šest za konačan rezultat od 6:0. Pod vodstvom trenera Maria Šarića igrao je sljedeći sastav: Kukec, Cirkvenčić, Balaško, Horvat, Pleh, Katalenić, Brzuhalski, Radi, Mustač, Kosir, Jalšovec – igrale još: Presečki, Kraljić, Kolar, Kivač, Gotal. Zgoditke su postigle Vivian Mustač tri, dva Lea Horvat i jedan Tena Kosir. U idućem kolu mlade nogometašice Međimurja gostuju kod Istre u Puli. (md)

mala žal jer je Marku to bio tek prvi lift dok je u sljedeća 2 pokušaja glatko podigao 202,5 kg, ali mu zbog odizanja guzice od klupe, nisu priznati. Odličan nastup je imao i Branko Suzić, naš veteran koji se natječe u open kategoriji i benchom od 180 kg bio treći u ukupnom poretku seniora. Prvi nastup za Pozoje je ostvario Matej Bračko u konkurenciji
kadeta i s podignutih 117,5 kg bio ukupno drugi u svojoj kategoriji i treći kadet ukupno. Matej je, iako diže veće kilaže na treningu, osjetio čari natjecanja te iako malo razočaran najavio velike stvari u budućnosti. A da je sjajna budućnost Pozoja potvrdio je David Šlezak koji je u konkurenciji kadeta do 74 kg podigao respektabilnih 142,5 kg, uvjerljivo osvojio
svoju kategoriju te ukupno bio drugi kadet natjecanja. Pozojima je u muškoj ekipnoj konkurenciji ovo bio najbolji nastup u vlastitoj povijesti, ali i povijesti bench natjecanja u Hrvatskoj te su uvjerljivo zasjeli na prvo mjesto u poretku svih klubova. Uz vodstvo u ekipnoj ženskoj konkurenciji, Pozoji kroz godine potvrđuju Međimurce kao najbolje hrvatske benchere.
NOGOMET NOGOMET
Mladi i talentirani nogometni sudac, Roberto Dežđek, u rujnu je sudio više utakmica u 3. Nogometnoj ligi - Sjever gdje je jedini glavni sudac iz naše županije.
Također, pred kraj mjeseca Hrvatski nogometni savez pozvao ga je u Vinkovce kako bi sudio državnu završnicu veterana na kojoj se okupilo 32 momčadi iz cijele Hrvatske, između ostalih i Trnava Goričan te Mladost Komet Prelog.
Tamo je Dežđek sudio čak 13 utakmica zajedno s kolegama Ninom Vugrincom i Markom Stolnikom.
- Bilo je to lijepo iskustvo. Nikad do sada nisam
ODBOJKA
TURNIR u Nedelišću
sudio veteranski nogomet pa mi je ovo bila dobra prilika da se s njim upoznam. Neke utakmice bile su više seniorske nego veteranske, što me je iznenadilo. Bilo je tu puno igrača koji su nekada koračali HNL travnjacima. Ipak, većina utakmica bila je laganog tempa i shodno tome trebalo je uzeti malo lakši kriterij tijekom suđenja prekršaja. Sve u svemu, ovaj turnir bio je svojevrsni "odmor", a već ovog vikenda ponovno se vraćam suđenju seniorskih utakmica, kazao nam je Roberto Dežđek. Kao uspomenu na turnir nagrađen je peharom HNS-a. (nl)
U subotu je u Nedelišću održan 20. tradicionalni međunarodni turnir Trofej Međimurja u odbojci za seniore i seniorke.
U muškoj konkurenciji nastupile su ponajbolje hrvatske i slovenske momčadi. U prvom polufinalu domaći Međimurje Centrometal igrao je protiv slovenskog Fužinar SIJ Metal ravne iz Ravne na Koroškem. Slovenci su dobili prvi set, ali su Međimurci popravili igru i izjednačili u drugom. U napetom trećem setu Centrometal je pobijedio Fužinar i plasirao se u finale. Panvita Pomgrad iz Murske Sobote bila je bolja od Cratis Varaždina, a Varaždinci su poraženi i u borbi za treće mjesto od Fužinara. Finale je bilo dramatično, repriza
prošlogodišnjeg finala u kojem su slavili Slovenci. Pomgrad je vodio u oba seta sa 23:20, ali Međimurci su prvi set preokrenuli na 26:24. Drugi set pripao je Slovencima, a treći, nakon brojnih meč lopti, završio je 34:32 za Centrometal, koji je osvojio turnir. U ženskoj konkurenciji domaći Nedelišće Elting je u polufinalu igrao protiv slovenske Lendave. Gošće su bile bolje i izborile finale. U drugom polufinalu zagrebačka Dubrava bila je bolja od HOK Gorice. U utakmici za treće mjesto Nedelišćanke su pružile još bolju igru ali to nije bilo dovoljno za pobjedu protiv jako dobre ekipe Gorice. U finalu je Dubrava u neizvjesnoj završnici pobijedila Lendavu 2:1. (nl)

Kolo je bilo uspješno za međimurske klubove, Rudar i Međimurje su međusobno remizirali, a ostali klubovi upisali su pobjede
Piše: Miljenko Dovečer
Na vrhu se zgusnulo, od prvog do šestog mjesta razmak je samo od pet bodova. Kolonu predvodi Bilogora'91 s 18 bodova, dok posljednja Virovitica ima samo dva boda. Derbi kola je zasluženo pripao gostu iz Kotoribe za kojega je jako dobru utakmicu odigrao Nikola Golenja i s dva pogotka riješio pitanje pobjednika, a posebno je pamtljiv bio prvi kojega možete pogledati na FB stranici Graničara. Varteks je tako izgubio prvu poziciju i prepustio je ponovo Bilogori koja je na krilima Zunige stigla do nove pobjede vrativši se uspješno na pobjednički kolosijek. Zuniga je s dva uvodna pogotka usmjerio vodu na mlin svoje momčadi, a do odmora su gosti uspjeli zatresti svoju mrežu pa je pitanje pobjednika bilo odlučeno, gostu pripao tek utješni pogodak. Polet se polako šulja prema vrhu, ponovo je zablistao sjajni Nino Patafta koji je također dva puta poentirao pa je sada Šardijeva momčad samo bod iza lidera. a domaćinu ostaju problemi koje bi trebao što prije detektirati i korigirati novi trener Mario Vodanović. Pitomača je izgubila nakon loše predstave u Ludbregu gdje je domaćin odigrao čvrstu i sigurnu utakmicu te svoj trud naplatio s dva pogotka i nova tri boda pa je sada momčad Gorana Vincetića u sigurnom okruženju sredine ljestvice s dobrom formom i tendencijom napretka prema gore. Nedelišće je ostvarilo pobjedu u uzbudljivoj utakmici nakon što su mreže mirovale prvih 45 minuta. Domaćin je poveo, no gosti su preokrenuli rezultat. U 90. minuti, Thiago je izjednačio s penala, a tri minute kasnije postigao je i pobjednički gol. Dinamo iz Domašinca je, uz Novaka i Petaka, uzeo bodove iz Garešnice, dok su utakmice u Virovitici i Murskom Središću završile bez pobjednika. Krešimir Crvenka promašio je dva penala, a gostujući vratar Deni Redžić proglašen je igračem utakmice. Međimurje je osvojilo bod bez Brazilca Matheusa, a Drago Vabec bio je zadovoljan napretkom ekipe.
Golenja odlučio utakmicu
Graničar se s teškog gostovanja u Varaždinu vraća pobjedom. S dva gola Nikole Golenje skinuo je lidera Varteks s prvog mjesta. Posebno je bio upečatljiv prvi kada je s nekih tridesetak metara s lijeve strane iskosa Nikola Golenja skinuo paučinu s prvog gornjeg kuta Kirićevog gola. Ovom pobjedom 0:2 Graničar se popeo na 3. mjesto. Čestitke Kotoripčanima.
- Zasluženo smo danas izgubili, čestitam gostima na korektnoj igri. Mi smo danas pokušavali, ali sve je od početka išlo u krivo. Nemam puno toga zamjeriti mojim igračima, to je valjda odrastanje, moramo dići glavi gore i ići dalje, ističe Dražen Besek, trener Varteksa.
- Od prve minute smo se postavili u pravi gard i znali kako i na koji način doći do pobjede te smo kao ekipa odigrali odličnu utakmicu. Međutim, ključ ove pobjede kao i prijašnjih nalazi se u odnosu moje ekipe prema treningu. Čestitke i domaćoj ekipi na fer i sportskoj utakmici, Mario Piškor, Graničar.
Rudar i Međimurje podijelili bodove
Po dosta teškom terenu odigrana je jedna žustra, borbena utakmica no nažalost s malo prigoda za postizanje zgoditaka. U lokalnom međimurskom derbiju u Murskom Središću podjela bodova. Golovi su pali u prvom dijelu, poveo je Rudar u13. minuti kada nakon ubačaja Radikovića iz kuta visoko skače Patrik Nedeljko i glavom smješta loptu u mrežu gostujućeg vratara Hozjana. U 34. minuti Zvonimir Mrazović iz Međimurja izjednačio je na 1:1 preciznim udarcem s vrha šesnaesterca. Rudar je imao još dvije prilike preko Ivančića i Ratajeca, no bez rezultata. Konačan ishod odražava realnost utakmice, gdje su obje ekipe iskoristile po jednu šansu. Rudar je ostao peti na ljestvici, dok je Međimurje deseto. Rudar odlazi u potragu za bodovima protiv posljednje Virovitice, dok Međimurje igra protiv Podravine u utorak, 8. listopada u 18:30 sati.
- Tvrda i teška utakmica bez puno prilika. Podjela bodova je najrealniji rezultat , bio je kratak u svom komentaru Damir Lepen Jurak trener Rudara.
- Baš smo sretni, odigrali smo jednu od najboljih utakmica, bili smo malo bolji za nijansu, svi su zadovoljni i publika, a ja sam najsretniji. Jako lijepa utakmica, zanimljiva i napeta do zadnje minute i bitno mi je osobno kao starijem treneru da nižemo pozitivne rezultate. Slijedi utakmica protiv Podravine na kojoj moramo ovo potvrditi , zadovoljan je bio nakon susreta Drago Vabec trener Međimurja.
Polet bez problema u Đurđevcu
Polet je s lakoćom pobijedio Graničara u Đurđevcu, ostavši na drugom mjestu iza Bilogore kao jedina neporažena momčad s 42 utakmice bez poraza. Nino Patafta otvorio je golijadu u 5.
TABLICA 3. NL SJEVER
1. Bilogora 91 7 601 18-718
2. Polet (SMnM) 75 20 26-717
3. Varteks 75 02 13-515
4. Graničar (K) 75 02 14-1015
5. Rudar (MS) 7 421 14-914
6. Pitomača 7 412 18-713
7. Nedelišće 7 322 12-1411
8. Dinamo (D) 7 232 8-5 9
9. Podravina 7 223 15-13 8
10. Međimurje 7 223 7-15 8
11. Dinamo (P) 7 214 14-20 7
12. Koprivnica 7 133 9-17 6
13. Garić (G) 7 124 8-12 5 14. Graničar (Đ) 7 11 5 6-17 4 15. Virovitica 7 02 5 5-17 2 16. Slatina 7 11 5 4-16 0
Rezultati 7. kolo
Rudar – Međimurje 1:1
Virovitica – Koprivnica 1:1
Podravina – Pitomača 2:0
Graničar(Đ) – Polet 0:4
Varteks – Graničar(K) 0:2
Garić – Dinamo (D) 0:2
Bilogora 91 – Slatina 4:1
Nedelišće – Dinamo(P) 3:2
Raspored 8. kolo, 5. listopada u 16:00 sati: Koprivnica - Dinamo(P) (6.10.) Slatina – Nedelišće Dinamo(D) – Bilogora '91
Graničar(K) – Garić Polet – Varteks Pitomača - Graničar(Đ) Međimurje - Podravina (8.10. u 18:30) Virovitica - Rudar
minuti, a Mesarić je povisio na 0:2 u 27. U nastavku je Patafta ponovno zabio, a konačnih 0:4 postavio je Šarić. Polet se jasno profilira kao jedan od glavnih favorita za osvajanje naslova, a u sljedećem kolu dočekuju varaždinski Varteks. - Sigurna i uvjerljiva pobjeda, nakon što smo zadnjih nekoliko utakmica malo muku mučili u zadnjoj trećini. Danas smo od početka bili rastrčani, agresivni i razigrani, pritisnuli domaćina na njihovu polovicu i u potpunosti kontrolirali utakmicu. Veseli činjenica što smo utakmicu završili s tri juniora i jednim kadetom. Zahvaljujem domaćinima na gostoprimstvu te fer i korektnoj igri. Također, moram pohvaliti sudačku trojku koja nam je priuštila najbolje suđenje ove sezone. Okrećemo se prema Varteksu, susretu koji će zahtijevati puno veću angažiranost. nadam se da će navijači uživati, zadovoljno je komentirao učinak svoje ekipe Zoran Šardi trener Poleta.
Dinamo se pjesmom vraća s gostovanja u Garešnici
S gostujućim bodovima vraća se i domašinečki Dinamo. Krajem prvog poluvremena Filip Petak u 42. minuti dovodi iz penala u vodstvo svoju ekipu. Pred kraj
utakmice, točnije u 85. minuti domaći ne zabijaju iz kaznenog udarca, kada se obranom istaknuo vratar Dinama Ivan Prekupec.Za krajnjih 0:2 strijelac je Dominik Novak.
- Teško mi bilo šta komentirati, nevjerojatno da izgubiš na ovakav način utakmicu. Stvaraš šanse, dvije stative jedna prečka, kazneni udarac sve to nismo riješili u našu korist što iskusni gosti koriste i rješavaju utakmicu u njihovu korist. Čestitam im na pobjedi i mi se okrećemo idućem kolu i gostovanju u Kotoribi, pomalo razočaran je bio Dragan Vaclavek trener Garića.
- Čestitam svojoj momčadi na teško izborenoj pobjedi. Kroz pripremu utakmice znali smo da nas čeka protivnik kojemu nije mjesto u donjem dijelu tablice i da neće biti lako. Danas je ponovo do izražaja došla naša stabilnost, sposobnost igrati ” na nulu “, iako je protivnik imao nekoliko dobrih prilika. Sve u svemu, ispunili smo skoro pa sve planirano, skoro sve što smo kroz tjedan ciljano trenirali, vratilo nam se pobjedom. Sve veći optimist sam u cijeloj ovoj priči, vjerujem da ćemo se kroz ovu godinu veseliti, presretan je bio nakon utakmice Dalibor Gorupić trener Dinama.
Preokretom u sudačkoj nadoknadi Nedelišću tri boda Nakon dvostrukog preokreta bodovi ostaju u Nedelišću. Prvo za 1:0 pogađa Lončar u 52. minuti. Zatim preokret gostiju za 1:2 golovima Kuprešaka i Pranjića. U posljednjim minutama totalni preokret za Nedelišće s dva gola Tiaga. Prvo u 90. iz penala izjednačuje , da bi u 2. minuti sudačke nadoknade svojim drugim golom donio 3:2 pobjedu svojoj ekipi.
- Nevjerojatna utakmica kakva se viđa jednom u pet sezona. Međutim Dinamo iz Predavca nije bio dobar nego je bio odličan. U prvom poluvremenu mi smo bili u totalno podređenom položaju i gosti da su bili smireniji i konkretniji mogli su poentirati u nekoliko navrata. U pauzi poluvremena cilj nam je bio da se “probudimo”. Imamo dvije velike prigode u 5 minuta. Nastavljamo sa dobrom igrom i uspijevamo povesti. Protivnik se vraća sa pogotkom iskusnog Kuprešaka i odmah nakon toga zabija iz polukontre za 1:2. nismo se predali i kroz još 4 izmjene držali visok ritam i u završnici smo uspjeli preokrenuti i ostaviti bodove u Nedelišću. Čestitke jednoj i drugoj ekipi na zaista lijepoj utakmici, prezadovoljan je bio Davor Balent, trener Nedelišća.

Prošlogodišnji pobjednici našeg nagradnog natječaja bili su mališani iz Dječjeg vr�ća Dječja mašta iz Čakovca. Sa svojim odgajateljicama i roditeljima zasadili su biljke u dvorištu vr�ća Dječja mašta
VRTIONICA – nagradni natječaj Vrtnog centra Iva i Međimurskih novina
Nagradu od 1200 eura za uređenje dvorišta dobit će vrtić koji će napraviti najljepšu maketu svog željenog dvorišta
Vrtni centar Iva, Rasadnik Iva i Međimurske novine i ove godine organiziraju nagradni natječaj pod nazivom Vrtionica, uz koji će jedan vrtić dobiti uređenje dvorišta u ukupnoj vrijednosti od 1200 eura! Ono što se ove godine traži za dobivanje nagrade je izrada makete vlastitog željenog dvorišta.
Sve što trebate je izraditi maketu, poslati nam je na e-mail i opisati što vaša maketa prikazuje, odnosno što biste željeli u svom dvorištu učiniti s ovom nagradom. Predstavit ćemo vaš projekt u Međimurskim novinama.
Vrtić koji najviše oduševi svojom kreativnošću osvojit će ovu vrijednu nagradu.
Nagrada uključuje sve za uređenje vrtićkog dvorišta u iznosu od 1200 eura, a nagrađeni vrtić može računati i na pomoć ljubaznih djelatnica Vrtnog centra Iva pri odabiru biljki i savjete o sadnji.
Tko se može prijaviti?
Natječaj je otvoren za sve vrtiće na području Međimurske županije, koji žele novo uređenje dvorišta. Ako mališanima vašeg vrtića želite omogućiti što bogatiji i raznovrsniji sadržaj koji će im donijeti novo uređeno dvorište za vanjske
U utorak, 8. listopada 2024. u 18 sati, dođite u Multimedijalnu dvoranu Knjižnice “Nikola Zrinski” Čakovec na predavanje Kristijana Petrovića “Večer s Drakulom – povijest najutjecajnije gotičke novele”.
Abraham Bram Stoker, kada je napisao Drakulu, za što mu je trebalo sedam godina, nije ni znao kako će pokrenuti pravu lavinu ponovnog interesa naspram mračnog slavenskog folklora u kojem glavnu riječ imaju – vampiri.
aktivnosti koje ih vesele, nova znanja, avanture i proširiti vidike, javite se na natječaj i osvojite 1200 eura za opremanje vašeg okoliša.
Kako se prijaviti?
Prijave primamo do 31.12.2025. Svoje prijave pošaljite na e-mail marketing@mnovine.hr, a u prijavi nam pošaljite fotogra�iju vaše makete i opišite što sve želite promijeniti u vašem dvorištu te što biste time željeli postići. Napišite nam što trenutno nedostaje u vašem dvorištu, što biste željeli uzgajati, što će mališani time naučiti, kako ćete uljepšati okoliš, ali i svakodnevnicu vaše djece.

Stoker nije znao kako će njegov zlikovac tijekom vremena doživjeti više od 300 ekranizacija te mnogih interpretacija kako u stripu tako i u animiranom �ilmu. Nije znao ni da je uspio napisati roman koji će postati jedan od najprevođenijih u povijesti književnosti, s bezbroj izdanja diljem svijeta. Nije znao kako će upravo zbog Drakule neki autori podosta godina kasnije postati najpoznatiji svjetski pisci horora. (sh)
Možete nam poslati kako su klinci sudjelovali u izradi makete, kakve su želje imali, koliko su se uključili roditelji, čime ste izradili maketu. Prijavu pošaljite na e-mail marketing@mnovine Nakon prijave, svaki prijavljeni vrtić predstavit ćemo u novinama, a dobitnika objavljujemo na jesen. Nakon toga kreće sadnja u njegovu dvorištu, što će biti odlična prilika da se roditelji i tete zajedno s djecom uključe u sadnju i nauče od malih nogu o brizi o okolišu i biljkama. Napomena: Vrtići koji su poslali svoje prijave u lipnju, ostaju kandidati u ovom natječaju.
Uvijek u crnom
Kristijan Petrović Foto: Pixsell/ Mar�na Popovcic





Javili su lipo vrime za vikend. Kažu da će bit sunčano i toplo pa sam odma zasukala rukave i sve isplanirala. Odredila sam skinut zavjese pa oprat prozore, prominit posteljinu, a onda sve lipo pomaknut i pribrisat ćoškove, potriba je. Dan je kratak pa sam zarana krenula, tako da do mraka sve stignem. Računam, u pauzi ću skuvat ručak, a ako Bog da, popodne ću uspit i kavu popit. Odma sam ti lagano upalila glazbu, istrala dicu da se vani igraju pa opleti po kući. Taman negdi oko podne, u najvećem tutnju, zove Miro. I njemu javili da će lipo vrime, a neće radit za vikend pa su, kaže, njih trojica isplanirala skoknut do Zagreba. Pa ja, šta ima od Njemačke do Zagreba, moreš sve kamenom dobacit! Kum Jure tamo ima kuću, u kući bolesnu mater pa mu je sevap otić, a moj Miro i cimer im Petar pravit će mu društvo.
- Odlično, kažem ja, imate i pravo.
A onda spustim slušalicu.
Pogledam, odma do mene daska za peglanje, iza cila hrpa zgužvane posteljine, a isprid mene ogledalo. Mogu ti reć da me ona čupa u ogledalu svaki put lipo poplaši, vako kad je iznenada ugledam.
- E jadnice jadna, jesi sve lipo isplanirala – ja ću ti njoj.
- A jesi vidila kako ti čovik živi? Skoknut će do Zagreba. Ti, kad ćeš na pijacu tribaš sto dozvola od: dice, svekrve, matere i čovika, nisi mirna dok svi ne kažu da moreš ić. E, tek kad svi odobre, tek se onda pakuj. Pakuj sebe, pakuj dicu pa zateži po kući da kogod ne dođe a neuredno. Taman kad sve završiš, ne mili ti se ništa. A onaj tvoj ode s društvom u Zagreb, u minuti isplaniro i svima pošten. Bem ti pravdu kad je nema – pomislim u sebi i baš me tada uvati nekakav bis. Žuta minuta, šta li?
Točno me spopade potriba da uradim nešto samo za sebe. Da na primjer razavijem Zdravkovića pa da selo ori, da razbijem kakvu bilo čašu ili da se konačno odvažim pa Raspudiću pošaljem zahtjev za prijateljstvo. Svašta mi je padalo na pamet.
A onda se smirim.
-Skuliraj se ženo, udana si, imaš dicu – šapnem sama sebi. A bome se ni ovo veša neće samo ispeglat.
I eto, odma me popustilo. Sad sam dobro, samo šuti, ništa mi ne spominji!
Ivana Ćurić
Vrane – gradski „snajperisti“.
I Thompson je u pravu kad pjeva: „Nije ovo vrijeme dobro za nas…“
Izgleda da se samo za zanimanje političara ne zahtijeva nikakva odgovornost.
Iako često kišemo, nije istina sve što kažemo. Od kada je u �irmu došao novi kolega, tri kolegice su otišle na porodiljni.
Dražen Jergović


Čekajući bolje sutra, živimo od danas do sutra.
Danko Ivšinović
Split je zbog mega radova u priobalnom pojasu ostao zakinut za 70 % gradskih plaža. S druge strane dobili smo još jednu pasju plažu, što paše na ove pasje vrućine. Eto, mi Kupači u Splitu zavidimo psima, za njih svugdje mjesta ima. Čovik je čovik, a pas je pas.
AKTUALNICE
Nađan Dumanić
Ako je sinoptičarka zgodna smije prognozirati i oluju. Krpelji su agresivni pred izbore, a komarci poslije. Mami je važno da joj je kći lijepa, a tati da je i pametna. Najlakše i najljepše je vladati u domovima. Od komplikacije bolja je aplikacija. Mar�n Jakšić
TEST Nissan Juke N-Sport Hybrid 143


Nedavni blagi redizajn Jukea je donio djelomično novu unutrašnjost, no najveći novi aduti su mu žuta boja karoserije, kao na prvoj generaciji, te novi paket opreme N-Sport, baš ovakav kakav smo imali prilike i testirati.
Tekst i foto: Igor Rudež
Ono što je dobro ne treba mijenjati, složit će se mnogi, zato je i Nissan prilikom predstavljanja druge generacije modela Juke prikazao automobil koji je, posebice sprijeda, vrlo sličan prethodniku, a ni nakon redizajna nema promjena. Naime, druga je generacija Nissana Jukea predstavljena 2019. godine, a početkom ove godine je predstavljena i redizajnirana verzija koja izvana, osim boje, ne donosi ništa novoga. To znači kako su u Nissanu pogodili točno ono što kupci žele, a sada je pridodana i žuta boja karoserije, kao na prvoj generaciji, baš na zahtjev kupaca. Uz boju karoserije, izvana se mogu vidjeti i novi aluminijski naplatci kao i male razlike oko prednje maske motora i to je to. A Juke i dalje izgleda atraktivno iz svih kuteva, posebice

u novoj N-Sport opremi koja uključuje dvobojnu karoseriju i 19-inčne Akari aluminijske naplatke.
Tu su i sjajno-crni detalji na karoseriji koji se odlično nadopunjuju na ostatak dizajna. Sprijeda su naglašena velika okrugla svjetla te “obrve“ koje su ujedno i LED dnevna svjetla, odnosno pokazivači smjera. Iako je riječ o modelu koji u nazivu ima sport, straga se ne vide nikakvi lažni ispušni otvori, a nije napravljen ni veliki difuzor u donjem dijelu branika koji ničemu ne služi, pa nas veseli kako se Nissan nije pridružio ostalim proizvođačima. Jedino je naglašeniji krovni spojler, a ugrađen je i stražnji brisač, koji se pokazao odličnim za vrijeme kišnih dana, a koji izbacuje sve više proizvođača na SUV modelima.
Gledajući s boka, Juke ima kupeovske linije, iako nije službeno u toj klasi, a





dobrom izgledu pridonose i sakrivene stražnje ručice za otvaranje vrata, no kako su postavljene visoko, djeca će jako teško doći do njih. A pomalo kupeovske linije te ugradnja baterije hibridnog sustava rezultirali su nešto

manjim prtljažnim prostorom koji u osnovi ima obujam od 354 litre, dok s preklopljenim naslonima obujam raste na 1237 litara. No ostalo je mjesta za rezervni kotač smanjenih dimenzija i ostale sitnice ispod podnice.


Dimenzije (DxŠxV): 4210 x 1827 x 1593 mm
Osovinski razmak: 2636 mm
Masa vozila / dopuštena nosivost: 1325 kg/ 469 kg
Veličina prtljažnika 354/1237 litara
Vrsta motora/broj cilindara: Hibridni/4
Pogon: Prednji kotači
Mjenjač: Automatski, Mul�-Mode
Snaga: 105 kW / 143 KS
Okretni moment: 205 Nm
Najveća brzina / 0 - 100 km/h: 166 km/h / 10,1 s
Potrošnja (prosječna l/100 km) 5,9
CO2 emisija: 111 g/km
Cijena: 36.978 eur
Ulaskom u unutrašnjost odmah je vidljivo kako je došlo do mnogih promjena. Nov je dizajn kožnih sportskih sjedala s integriranim naslonima za glavu u koje su ugrađeni i Bose zvučnici koji odlično pridonose glazbenoj kulisi u vožnji i jako su nam se svidjeli. Doduše, fali nam malo basa, ali zato barem nema bučnih vibracija iz vrata. Ispred vozača je odličan maleni upravljač s �izičkim tipkama, a iza njega je smještena nova digitalna instrument ploča dijagonale 12,3 inča. Nudi nekoliko načina prikaza, a sve je prilično veliko i lako čitljivo. Novost je i čitav gornji dio središnjeg grebena koji donosi novi 12,3-inčni multimedijski zaslon visoke rezolucije ispod kojeg su se smjestile �izičke tipke multimedije i kamera, ali i okrugli gumb za podešavanje glasnoće. Izvrsno! Žuti detalj oko novog dijela također pridonosi odličnom ugođaju u kabini. Nisu se mijenjale komande klimatizacije koje su odvojene od zaslona i dolaze s �izičkim tipkama i gumbima i savršene su za podešavanje
Oprema: 12,3-inčni mul�medijski sustav, 12,3-inčni digitalni instrumen�, automatski klima-uređaj, sportska sjedala s integriranim Bose zvučnicima, kamere u 360 stupnjeva, ProPilot Assist, naslon za ruke sprijeda, inteligentni ključ, E-Pedal, dvobojna karoserija,19-inčni aluminijski naplatci...


Nova sportska sjedala su udobna i dovoljno velika, a i izgledaju atraktivno

bez micanja pogleda s ceste, a jedini problem mogu imati visoki vozači kojima će novi središnji ventilacijski otvori zaklanjati pogled na tipku za grijanje sjedala, pa će se morati sagnuti kako bi vidjeli
je li grijač uključen i na koju jačinu. Tu su i USB priključci te polica s bežičnim punjačem mobitela, a u nastavku je tipka za paljenje automobila i klasična ručica automatskog
tipke e-Pedal i EV prilično “sakrivene“, odnosno do njih je teško doći dok ste naslonjeni na središnji naslon. Naime e-Pedal vam omogućuje kočenje motorom, odnosno boljom regeneracijom pri kočenju, no šteta je što ne zaustavlja vozilo u potpunosti, već do brzine od par km/h. Također, naslon za ruke je udoban i prilično širok za ovu klasu automobila, no nije podesiv po dužini pa će nižim vozačima on biti postavljen previše otraga. Prostora na prednjim sjedalima je i više nego dovoljno u svim smjerovima, no straga je nešto skučenije, iako će prosječno visoki putnici imati sasvim dovoljno mjesta i za koljena i za glavu. Nažalost, ventilacijskih otvora nema, no tu je USB koji će omogućiti lako punjenje uređaja. Dobro poznati hibridni pogonski sustav je poznat iz mnogih modela Renault grupe, a riječ je o kombina-
ciji 1,6-litrenog atmosferskog benzinskog motora s četiri cilindra koji razvija maksimalnu snagu od 69 kW/94 KS i okretni moment od 118 Nm, elektromotor koji razvija snagu od 36 kW/49 KS i okretni moment od 205 Nm, a tu je i elektropokretač od 15 kW te vodom hlađena baterija koja ima kapacitet od 1,2 kWh. Ukupna snaga sustava je 105 kW/143 KS.
Naravno, riječ je o sustavu koji sam puni bateriju i to oduzimanjem gasa ili kočenjem, no za razliku od nekih konkurenata ipak se mrvicu više vozi na benzin nego na struju. No bez obzira na to, potrošnja je ostala niska – 5,9 litara na 100 km. Na autocesti troši najviše, u prosjeku 7 do 8 litara, ovisno koliko vam je “teška” noga na gasu, dok će u gradu potrošiti najmanje, i to između 5 i 6 litara, dok će na otvorenoj cesti trošiti između 6 i 7 litara. Čitav sustav radi bez ikakvih trzaja

mjenjača, što je danas također sve rjeđe vidjeti u novim automobilima s automatskim mjenjačem. Tu je i praktičan prekidač za odabir načina vožnje, kao i prekidač ručne kočnice. Šteta je samo što su Hibridni motor sa 143 KS je ujedno i najsnažniji motor koji je u ponudi
i cukanja, pa ćete samo po zvuku znati vozite li na struju ili benzin. Ovakav sustav je i dalje najbolja moguća alternativa za nekadašnje dizelaše jer troši malo, a istovremeno i ispušta manje CO2 nego sam benzinski motor. Uz to, nema potrebe za kablovima za punjenje i razmišljanja gdje ćete ga puniti.
Cijena testnog modela se popela na 36.978 eura što je popriličan novac za gradski SUV, no ovdje je riječ o izvedbi s gotovo svom opremom, najsnažnijim motorom u ponudi i automatskim mjenjačem. A svatko tko želi biti viđen u ovom automobilu će izabrati baš ovakvu izvedbu. No s redizajnom je dostupno i više paketa opreme s hibridnim motorom, pa je tako moguće naručiti i Juke Acenta, odnosno osnovni paket opreme kada mu cijena pada na 29.038 eura. Doduše, ta izvedba nema toliko opreme ni atraktivnosti, ali svejedno donosi 12,3-inčnu multimediju, stražnju kameru, sigurnosni paket, klimu i ostalu opremu. Par tisuća eura možete uštedjeti i odabirom benzinskog motora sa 114 KS i automatskim mjenjačem koji se može dobiti u N-Sport paketu opreme po cijeni od 32.218 eura, dok najpovoljniji Juke u Hrvatskoj košta 23.831 eur i dolazi sa slabijim motorom i ručnim mjenjačem.

Imendani i proštenja kroz tjedan
od 4. do 10. listopada 2024.
P 4 Franjo Asiški, Franka, Franciska, Kajo
S 5 Faustina K., Flavijan, Mauro, Placid, Miodrag
N 6 27. KROZ GODINU, Bruno, Fides, Vjera, Vjerica
P 7 BDM od Krunice, Ruža, Rozalija, Ernest
U 8 Šimun starac, Dimitrije Solunski, Zvonimir
S 9 Dionizije i dr., Abraham i Sara, Ivan Leonardi
Č 10 Danijel i dr., Danko, Darija, Franjo Borgia
Vam imendan!


Čakovec
DOKTORI KOJI RADE OVU SUBOTU 5. LISTOPADA
dr. Sven Jev�ć
I. G. Kovačića 1e, tel. 040/372-314
dr. Mirjana Dukić
I. G. Kovačića 1e, tel. 040/311-918
dr. Stella Hoblaj
I.G. Kovačića 1e, tel. 040/311-914
dr. Željka Smojver-Benko
I.G. Kovačića 1e, tel. 040/372-317
Dekanovec
dr. Zdenka IvanovićAzenić
M. Pušteka 22, tel. 040/863-013
Donji Kraljevec
dr. Ljiljana Fujs
Čakovečka 5, tel. 040/655-170
Nedelišće
dr. Anja Štefić
Varaždinska 23 a, tel. 040/821-200
dr. Jurica Vidović
M. Tita 1, tel. 040/313-216
Kotoriba
dr. Lela Grabant
Kralja Tomislava 119 a, tel. 040/682-119
Orehovica
dr. Petra Pongrac Nikole Tesle 23, tel: 040/635-130
Podturen
dr. Biserka Poje Jelenić Čakovečka 3, tel. 040/847-040
Prelog
dr. Diana Krešić
Kralja P. Krešimira IV 7, tel. 040/646-856
Selnica
dr. Monika Friščić
Jelačićev trg 1, tel. 040/861-014
Sve� Juraj na Bregu-Lopa�nec
dr. Sara Mudri Pleškovec 30, tel. 040/855-791
Vra�šinec
dr. Ivica Dukić
Dr. V. Žganca 1, tel. 040/867-347
ORDINACIJA POSEBNOG DEŽURSTVA OPĆE/OBITELJSKE MEDICINE Doma zdravlja Čakovec, I. G. Kovačića 1e, Čakovec, radi svake subote od 15 do 20 sati, a nedjeljom, praznikom i blagdanom u radnom vremenu od 8 do 20 sati uz OBAVEZNU PRETHODNU NAJAVU na telefon: 040/372-301.
DEŽURNA ORDINACIJA DENTALNE MEDICINE radi nedjeljom, praznikom i blagdanom od 9 do 16 sati, na adresi: Doma zdravlja Čakovec, I. G. Kovačića 1E (2. kat) Obavezno je prije dolaska telefonski se čuti s dežurnim liječnikom dentalne medicine na broj telefona: 040/372-311

Čakovec:
Rosa Bogdan, kći Josipe i Ivana
Lara Dodlek, kći Ane i Davida
Jan Čekunec, sin Katarine i Franje
Grga Opačak Sabol, sin Suzane i Marka
Emili Kovač, kći Monike i Davora
Lena Pačandi, kći Sare i Bernarda
Alex Ignac, sin Sandre i Danijela
Rita Sakač, kći Viktorije i Dominika
Alex Boj, sin Anje i Luke
Gita Grabar, kći Paule i Maria
Tijana Golubić, kći Tene i Jurice
Sara Horvat, kći Jelene i Alena
Eva Orehovec, kći Ive i Dejana
Eva Munđar, kći Samante i Davora
Rafael Gosarić, sin Petre i Krunoslava
Noel Ignac, sin Gabrijele i Tomice
Čakovec:
Stella Eleonora Soldat i Nikola Šol�ć
Matea Juras i Antonio Gužvinec
Jelena Sečan i Filip Farkaš
Kris�na Cirkvenčić i Ma�ja Novak
Sanela Nedeljko i Marko Flac
Mursko Središće:
Sara Sobočan i Mario Modlic
Anita Kovačić i Marinero Mar�njak
Maja Nedeljko i Sven Rede
Prelog:
Dorotea Matešić i Davor Vidović
Čakovec:
Danica Glavak r. Štefok r. 1939.
Margarita Bakač r. Pintarić r. 1941.
Zlatko Toplek r. 1955.
Biserka Marciuš r. Vabec r. 1947.
Marija Š�mac r. Čeh r. 1941.
Andrija Vrbančić r. 1931.
Antonija Lesjak r. Taradi r. 1945.
Miroslav Hradel r. 1956.
Lenard Mulković r. 1956.
Jelica Hranilović r. Strmac r. 1929.
Rozalija Logožar r. Leček r. 1933.
Marijan Tišlarić r. 1953.
Kotoriba:
Ana Labazan r. Belović r. 1948.
Mursko Središće:
Mladen Hatvalić r. 1943.
Katarina Kraljić r. Perčić r. 1932.
Prelog:
Ana Bengez r. Blažeka r. 1941.
Marija Baranašić r. Sabol r. 1937.
Ivan Horvat r. 1929.
Ako si u potrazi za uzbudljivim poslom i želiš da svaki dan bude drugačiji, ovo je savršena prilika za tebe!
Tražimo suradnike koji vole pisanje i kreiranje sadržaja, snalažljivi su i proaktivni te su spremni za rad u dinamičnim uvjetima. U potrazi smo za suradnicima koji se žele dokazati, kreativni su, motivirani i prodorni.
Želiš li se okušati u izazovima današnjeg novinarstva i biti dio novinarske ekipe čije tekstove svakodnevno čitaš, javi nam se. Uvjet je da uvjeta nema, bitno je da se razumiješ u digitalni svijet i želiš započeti novu avanturu u svom životu!
Svoj životopis i molbu pošalji na adresu urednik@mnovine.hr i očekuj naš poziv na sastanak.
JEDINSTVENI BROJ ZA HITNE SLUČAJEVE 112

besplatno možete bira� s fiksnog ili mobilnog telefona
Autobusni kolodvor Čakovec
Željeznički kolodvor Čakovec
Taxi Cammeo
EKO TAXI
Mura taxi
Policija Čakovec
Mirovinsko Čakovec (HZMO)
Zdravstveno Čakovec (HZZO)
HZZ Čakovec
CZSS Čakovec
MEĐIMURJE PLIN
Besplatni broj za hitne intervencije: Prijava stanja potrošnje:
MEĐIMURSKE VODE: Besplatni telefon za prijavu kvara (0-24 sata):
ELEKTRA ČAKOVEC
Besplatni info telefon: Prigovori i zahtjevi:
Ljekarna Čakovec dežurna (0-24)
CZK Čakovec (blagajna)
Knjižnica Čakovec
Veterinarska Čakovec
POŠTA Čakovec
tel. 060 310 222
tel. 060 333 444
tel. 040 212 212
tel. 040 330 033
tel. 099 36 60 304
tel. 040 373 111
tel. 040 311 755
tel. 040 372 900
tel. 040 396 800
tel. 040 391 920
tel. 0800 202 033
tel. 040 395 199
tel. 040 373 700 tel. 0800 313 111
tel. 0800 300 404 info.dpcakovec@hep.hr
tel. 040 310 651
tel. 040 323 100
tel: 040 310 595
tel. 040 390 859
tel. 040 804 007
Turis�čki ured Čakovec tel. 040 313 319
ČAKOM Pogrebne usluge (0-24)
Porezna Čakovec
tel. 040 372 400
tel. 098 211 662
tel. 040 371 200
Ma�čni ured Čakovec tel. 040 374 147
tel. 040 375 444
Bolnica Čakovec
Dom zdravlja Čakovec tel. 040 372 370
ZZJZ Čakovec tel: 040 372 370
Mikrobiološki laboratorij tel . 040 375 356
Međimurska županija tel. 040 374 111
Bubimir 3.10.. ČETVRTAK
17:00 200% VUK 20:00 Joker- prem. 4.10. PETAK
17:00 Transformers 20:00 Bubimir
5.10. SUBOTA
10:00 Panda u Africi
13:30 Transformers 17:00 Kao pas i mačka 20:00 Joker 6.10. NEDJELJA
10:00 Kao pas i mačka 13:30 Panda u Africi
17:00 Transformers 20:00 Bubimir Bubimir 7.10. PONEDJELJAK
17:00 Kao pas i mačka 20:00 Joker 8.10. UTORAK
17:00 Transformers 20:00 Bubimir Bubimir 9.10. SRIJEDA
17:00 Panda u Africi 20:00 Joker
Mirko Špicar
iz Nedelišća 04.11.1951. - 05.10.2022.
U tišini vječnog mira prate te naše misli.
Imamo uspomene i tvoj lik uvijek u našim srcima

Supruga Marija, sin Mario sa suprugom Suzanom, unuke Saša i Anamarija, kćerka Silvija i sestra Marija Horvat sa obitelji.
Zahvala svima koji posjećuju tvoj tihi dom
Slavica Krišto�ić rođ. Vargantolić iz Čakovca preminula 29. rujna u 97. godini života

Jelena Grubišić rođ. Baranić
iz Preloga preminula 29. rujna u 82. godini života
Veronika Jeđut rođ. Rogina iz Čakovca preminula 27. rujna u 91. godini života


Ana Lovrek
iz Donjeg Vidovca preminula u 89. godini života
Terezija Vodopija rođ. Korent
iz Strahoninca preminula 27. rujna u 90. godini života
Dragutin Masten
iz Ivanovca
preminuo 1. listopada nakon duge i teške bolesti u 69. godini života
Marija Kolar
rođ. Murakezi
iz Šenkovca
preminula 2. listopada u 88. godini života

Drago Rajh iz Martinuševca iznenada preminuo 27. rujna u 73. godini života
Franjo Miljančić
iz Dragoslavec Breg preminuo 29. rujna nakon duge i teške bolesti u 73. godini života
Ivanka Previšić rođ. Moharić iz Šandorovca preminula 28. rujna nakon duge i teške bolesti u 69. godini života

Stjepan Blagus
iz Hodošana preminuo u 75. godini života

Stjepan Jagec
iz Nedelišća preminuo 21. rujna u 70. godini života
OBAVIJEST O SMRTI
Zorka Pucko
rođ. Novak iz Pribislavca
preminula 2. listopada nakon duge i teške bolesti u 89. godini života

OBAVIJEST O SMRTI
Paulina Koraj
rođ. Lovrec iz Čakovca
preminula 2. listopada u 92. godini života
OBAVIJEST O SMRTI
Nada Petek
rođ. Novak iz Čakovca iznenada preminula 30. rujna u 75. godini života
OBAVIJEST O
Marija Vrbanec rođ. Kutnjak iz Šenkovca preminula u 76. godini života


OBAVIJEST O SMRTI
Marijan Matulin
iz Donjeg Vidovca preminuo u 72. godini života
Julija Škoda rođ. Jagarinec iz Sesveta preminula 27. rujna u 87. godini života
Anica Branilović iz Črečana preminula 26. rujna u 65. godini života

1. AB METAL PROMET d.o.o., Palovečka 1, Belica, traži 3 m/ž vozača kamiona s kranom i m/ž vozača kamiona, javi� se osobno na adresu ili na tel. 040/845-806 ili na mob. 099/271-4461 ili na email: robert.krajner@ab-metalpromet. hr do 31.10.
2. ACCREDO d.o.o., Zasadbreg, traži m/ž administratora u odjelu nabave, javi� se na email: info@ accredo.hr do 31.10.
3. ANGERONA d.o.o., Čakovec, traži m/ž logopeda, javiti se na mob. 091/6226-749 ili na email: erp.angerona@gmail.com do 21.10.
4. AUTO KLUB ČAKOVEC, Športska 8, Čakovec, traži m/ž radnika na zamjeni guma, javi� se osobno na adresu ili na tel. 040 328778 do 14.10.
5. AUTOSET TUREK d.o.o., Prelog, traži 1 m/ž prodavača alata i strojeva, javi� se emailom: info@ autoset-turek.hr do 31.10.
6. Autotranspor� Majnić vl. Marijan Majnić, Čakovec, J. Muraia 4, traži 2 m/ž vozača C+E kategorije, javi� se osobno na adresu ili na mob: 098/241-524 ili na email: kris�na@at-majnic.com do 30.10.
7. BIO GARANTIE d.o.o., I. Mažuranića 2, traži 2 m/ž administra�vna djelatnika za međunarodni odjel, javi� se osobno na adresu ili na mob. 099/306-2488 ili na email: petra. jurinic@ceres-cert.de do 11.10.
8. BRAVARIJA ŠTAMPAR d.o.o., Hrupine 13, Prelog, traži m/ž bravara, javi� se osobno na adresu ili na mob. 098/553-029 do 4.10.
9. CE GRUPA d.o.o., Čakovec, traži m/ž ekonomistu - knjigovođu - ljudski resursi - kadrovska služba, javiti se na email: danijela@ cegrupa.com do 10.10.
10. City projekt d.o.o., Čakovec, traži m/ž konobara i m/ž recepcionera, javi� se na email: humanresources@castellum-cakovec. com do 21.10.
11. CHRISTOF INDUSTRIES CRO d.o.o., traži 2 m/ž elektromontera, m/ž zavarivača i m/ž industrijskog mehaničara za rad u Njemačkoj i Austriji, javi� se na email: jobs.kr@ fmt.biz do 10.10.
12. CWS d.o.o., Republike Austrije 1, Čakovec, traži 2 m/ž skladišna radnika i 2 m/ž radnika na liniji tepiha, javi� se pismenom zamolbom na adresu ili na email: dajana. hlebec@cws.com do 31.10.
13. Čalopek strojarstvo d.o.o., Čakovečka 136, Pušćine, traži m/ž pomoćnog bravara i m/ž tokara, javiti se osobno na adresu ili na email: info@strojarstvo-calopek. hr do 26.10.
14. D.G. COMMERCE d.o.o., Prelog, traži m/ž skladištara i m/ž sobara, javiti se na mob. 099/7060-172 ili na email: dg-commerce@dg-commerce. hr do 10.10.
15. Dom za odrasle osobe Veselko, Vugrišinec, traži m/ž radnika na održavanju u domu (rok prijave 18.10.) i m/ž njegovatelja (rok prijave 21.10.), javiti se na mob. 098/284-312
16. Dom za psihički bolesne odrasle osobe Kotoriba, Kolodvorska 16, traži medicinsku sestru ili tehničara, m/ž njegovatelja, m/ž radnog terapeuta, m/ž socijalnog radnika i m/ž edukacijskog rehabilitatora, javi� se na tel. 040/682806 ili na mob. 098/377-304 ili pismenom zamolbom na adresu ili na email: ravnatelj.kotoriba@ dom-bistricak.hr do 31.10.
17. Dom za starije i nemoćne osobe Hodošan, Čakovečka 6, traži medicinsku sestru ili tehničara, m/ž njegovatelja, m/ž pomoćnog kuhara i m/ž stručnog suradnika, javi� se osobno na adresu ili na tel. 040/679-368 ili na mob. 098/242319 ili pismenom zamolbom na adresu ili na email: dom@strahija. com do 12.10.
18. Dom za starije i nemoćne osobe MESMAR, V. Žganca 3, Prelog, traži m/ž njegovatelja, m/ž kuhara, medicinsku sestru ili tehničara te m/ž fizioterapeuta, javi� se osobno na adresu ili na tel: 040/646788 ili na mob: 098/460-403 ili na email: dommesmar@gmail.com do 31.10.
19. Dom za starije i nemoćne osobe Slakovec, traži medicinsku sestru ili tehničara i m/ž njegovatelja, javi� se na tel. 040/829-181 ili na mob. 098/305-246 ili na email: info@ domzastarije-slakovec.hr do 19.10.
20. Dom zdravlja Čakovec, I. G. Kovačića Čakovec, traži m/ž doktora medicine za mjesto rada Selnica, Pleškovec, Macinec i Čakovec, javi� se pismenom zamolbom na adresu do 31.10.
21. Dom za starije i nemoćne Sivica, traži m/ž ravnatelja, m/ž njegovatelja, m/ž socijalnog radnika i m/ž fizioterapeutskog tehničara, javiti se na email:sivicadom@ gmail.com do 17.10.
22. Dom za starije i nemoćne osobe Sveta Magdalena, traži medicinsku sestru ili tehničara te m/ž njegovatelja, javi� se na mob. 099/8746-442 ili na email: domsvetamagdalena@gmail.com do 17.10.
23. DOMUS INTERIJERI d.o.o., Glavna 29a, Mala Subotica, traži m/ž soboslikara - fasadera, javiti se osobno na adresu ili na mob. 098/244-001 ili na email: info. domusinterijeri@gmail.com do 4.10.

Izvor podataka:
HRVATSKI ZAVOD ZA ZAPOŠLJAVANJE
ISPOSTAVA ČAKOVEC: 396-819
ISPOSTAVA PRELOG: 646-740
ISPOSTAVA M. SREDIŠĆE: 543-200
Za točnost podataka odgovara Hrvatski zavod za zapošljavanje. Više informacija o slobodnim radnim mjes�ma možete pronaći na internet stranici burzarada.hzz.hr
24. Društvo osoba s tjelesnim invaliditetom Međimurske županije, Dr. A. Starčevića 1, Čakovec, traži 11 m/ž pružatelja usluge potpore i podrške u svakodnevnom životu starijim osobama i osobama s invaliditetom i 5 m/ž osobnih asistenta za pomoć osobama s tjelesnim invaliditetom, javi� se osobno na adresu ili na tel. 040/390-070 ili 099/5286-515 ili pismenom zamolbom na adresu ili na email: info@dos�-mz.hr do 31.10.
25. ELIMEA d.o.o., Prelog, K. P. Krešimira IV 26, traži m/ž montera centralnog girjanja i m/ž montera solarnih elektrana, javi� se osobno na adresu ili na mob: 098/1687042 ili na email: drazenko@elimea.hr do 31.10.
26. EUROBETON, Prelog, traži 3 m/ž radnika u proizvodnji, javiti se emailom: eurobeton@eurobeton.hr do 31.10.
27. EUROLUX d.o.o., traži 2 m/ž izolatera za rad u Njemačkoj, javi� se na mob. 095/666-1234 ili na email: eurolux1.info@gmail.com do 31.10.
28. EUROMET export-import, Prelog, K. Zvonimira 38, traži m/ž radnika na cnc stroju i m/ž radnika na montaži drvenih ljestvi, javi� se osobno na adresu ili na tel. 040/646-460 ili na mob. 095/8309940 ili na email: novieuromet. prelog@gmail.com do 7.10.
29. FILO LOGIC d.o.o., Čakovec, traži 2 m/ž stolara-montera, javi� se na email: posao@filo.hr do 18.10.
30. Framos Technologies d.o.o., Čakovec, traži m/ž skladišnog radnika, m/ž financijskog kontrolora i m/ž voditelja skladište i logistike, javiti se putem linka: h�ps://framos.jobs.personio.de/ job/1633852?_pc=1792745#apply do 16.10.
31. Fodor ugos�teljstvo j.d.o.o., Čakovec, traži m/ž konobara u Mamas & Tapas baru, javi� se na mob. 091/2382-175 ili na email: drazen.fodor@gmail.com do 4.10.
32. GERMANIA SPORT d.o.o., Čakovec, traži 3 m/ž operatera u kladionici, javi� se na email: posao@ germaniasport.hr do 4.10.

33. GKP PRE-KOM, Hrupine 7B, Prelog, traži 2 m/ž dimnjačara i m/ž kv strojara, javiti se na tel. 040/645-458 ili pismenom zamolbom na adresu ili na email: mirela. stefok@pre-kom.hr do 25.10.
34. GP Ekom, Športska 2, Čakovec, traži m/ž osobu za tehničko održavanje bazena, javi� se pismenom zamolbom na adresu ili na email: gp-ekom@ekom.hr do 7.10.
35. GRADAX d.o.o., Gornji Kuršanec, traži m/ž rukovatelja samohodnim građ. strojevima, m/ž zidara, m/ž građ. inž. niskogradnje i m/ž građ. tehničara voditelja gradilišta, javi� se na mob. 098/1854568 ili na email: gradax@gradax. hr do 10.10.
36. GREGORINČIĆ d.o.o., Prhovec 17, traži m/ž vozača teretnog vozila C i E kat. u međunarodnom prometu, javi� se osobno na adresu ili na mob. 098/473-063 ili na email: info@gregorincic.com do 31.10.
37. HILDING Anders d.o.o., K. Zvonimira 38, Prelog, traži 5 m/ž tapetara, 2 m/ž radnika u skladištu, 2 m/ž krojača, 2 m/ž radnika u proizvodnji, 10 m/ž šivača, 5 m/ž radnika na cnc stroju za rezanje spužve i m/ž voditelja računovodstva, javiti se osobno na adresu ili na tel. 040/650-041 ili na mob. 091/619-8717 ili pismena zamolba na adresu ili na email: ana.tezacki@ hildinganders.com do 15.10.
38. INGOLAB d.o.o., Čakovec, traži m/ž suradnika ovlaštenom projektantu i nadzornom inženjeru te m/ž dipl.inž. građevine, javi� se na email: velimir.pavlic@ingolab. hr do 31.10.
39. IM-COMP d.o.o., A. Starčevića 63E, Pribislavec, traži 3 m/ž cnc operatera u obradi i preradi stakla, m/ž djelatnika na održavanju - bravara, m/ž djelatnika u otpremi, m/ž cnc operatera u obradi i preradi stakla, m/ž skladištara - rukovatelja mosnom dizalicom i m/ž djelatnika u obradi i preradi stakla, javi� se osobno na adresu ili pismenom zamolbom na adresu ili na email: im-comp@ck.t-com.hr do 20.10.
40. INPIRIO d.o.o., D. Kraljevec, traži 2 m/ž bravara-zavarivača i m/ž tehnologa - konstruktora, javi� se na tel. 040/360-888 ili na email: inpirio@inpirio.com do 20.10.
41. INTERGRADNJA d.o.o., Vularija, traži 2 m/ž radnika na izgradnji montažnih kuća, javi� se osobno na adresu ili na mob. 098/698-384 do 30.10.
42. KRIKA, Nedelišće, Varaždinska 25a, traži m/ž konobara i m/ž radnika na izradi tendi, ceradi i šatora, javi� se osobno na adresu ili na tel. 040/822-190 ili na mob. 098/632113 ili pismenom zamolbom na adresu ili na email: krika@krika.hr do 21.10.
43. KOMUNA TOPLEK d.o.o., Žiškovec, traži 2 m/ž vozača C i E kat. u međunarodnom transportu, javi� se na tel. 040/337-392 ili na mob. 098/235-990 do 31.10.
44. LE´SLASTICE d.o.o., traži m/ž prodavača u pekari i slastičarni, m/ž radnika na dostavi, nabavi i skladištenju za mjesto rada Pušćine, Prelog i Čakovec, m/ž prodavača za radno mjesto Donji Kraljevec, m/ž čistača, m/ž dostavljača za mjesto rada Pušćine, m/ž prehrambenog tehnologa - voditelja proizvodnje i 2 m/ž pomoćna radnika za mjesto rada Donji Vidovec, javi� se na mob. 099/456-7630 ili na email: leslas�ce@leslas�ce.hr do 24.10.
45. LIMOND limarski obrt, Mihovljan, traži 2 m/ž djelatnika u limarskoj radionici, javi� se na mob. 098/814-122 ili na email: Info@ Limond.hr do 31.10.
46. L&P Tehnologije d.o.o., Prelog , Hrupine 1, traži 5 m/ž radnika u proizvodnji žičanih jezgri, javi� se osobno na adresu ili na email: posao.lpt@legge�.com do 25.10.
47. L.K.S.COMPANY d.o.o., Novo Selo na Dravi, traži 2 m/ž soboslikara - voditelja smjene, m/ž montera instalatera - voditelja smjene i 3 m/ž zidara, javiti se na mob. 097/6133-6544 ili na email: lks. company2@gmail.com do 23.11.
48. LTH Alucast d.o.o., Republike Austrije 3, Čakovec, traži 3 m/ž operatera na ćeliji za lijevenje, m/ž radnika na održavanju strojeva, m/ž alatničara, m/ž operatera u topionici i m/ž operatera u strojnoj obradi, javi� se pismenom zamolbom na adresu ili na email: info.alucast@lthcas�ngs.com ili putem linka: h�ps://www.lthcas�ngs.com/ hr/karijera/slobodna-radna-mjesta?country=4&type=0 do 30.10.
49. MARKO - tesarski obrt, Prelog, S. Radića 14, traži 5 m/ž zidara, 5 m/ž građevinskih radnika i 5 m/ž tesara, javiti se na tel. 040/646256 ili na mob. 098/9386-382 do 17.10.
50. Marodi prijevoz, Domašinec, S. Mezge 1, traži m/ž vozača teretnog vozila, javiti se na mob. 099/833-5125 ili na email: stjepanmarodi@net.hr do 16.10.
51. MARTI d.o.o., Hrupine 5, Prelog, traži m/ž tehnologa na odjelu drva, m/ž radnika na montaži proizvoda, m/ž djelatnika - operatera na laseru i m/ž radnika na obradi drva, javi� se osobno na adresu ili na tel. 040/630-730 ili na email: info@mar�.hr do 30.10.
52. MEDICAL ONE d.o.o., Čakovec, traži 2 m/ž prodajna predstavnika, javi� se na email: karijera@medicalone.hr do 4.10.
53. MD&V d.o.o., Čakovec, traži 2 m/ž radnika za rad na lopati za utovar pijeska na stroju za cementni estrih i radnika na raspoređivanju i zbrinjavanju materijala za cementni estrih i 3 m/ž majstora za strojnu žbuku, javi� se na mob: 098/241-533 do 30.10.
54. MD AIR SYSTEM j.d.o.o., Goričan, traži 2 m/ž montera ventilacije, javiti se na mob. 091/1831-991 ili na email: info@ md-air-system.hr do 10.10.
55. MEGA-SS, Sivica, Duga ulica 11, traži m/ž čistača, javi� se na mob. 099/3677-566 do 16.10.
56. METAL SISTEM d.o.o., Kotoriba, traži 2 m/ž bravara-montera i m/ž kozme�čara, javi� se na mob. 098/608-964 ili na email: helena@metal-sistem.hr do 25.10.
57. METAL DEKOR d.o.o., P. Miškine 24, Ivanovec, traži m/ž kontrolora, javi� se osobno na adresu ili na email: info@metal-dekor. hr do 18.10.
58. MIKA d.o.o., Čakovec, traži m/ž instalatera centralnog grijanja i klimatizacije, javiti se na email: mika.servis@gmail.com do 31.10.
59. MOBENZ d.o.o., Svetojelenska cesta 18, Čakovec, traži m/ž prodavača na�nih derivata i m/ž konobara, javi� se osobno ili pismenom zamolbom na adresu ili na email: mobenz92@gmail. com do 31.10.
60. MODNI STUDIO LATEA, Glavna 26, D. Vidovec, traži m/ž mehaničara industrijskih strojeva i m/ž šivača, javi� se osobno na adresu ili na tel. 040/615-113 ili na mob. 098/553-140 ili na email: luksa.suzana@gmail.com do 15.10.
61. MW PRODUCT d.o.o., D. Kraljevec, traži m/ž zavarivača migmag, javi� se na mob. 091/1601013 ili na email: mwproduct@ mwproduct.hr do 31.10.
62. MULTI-ING d.o.o., traži 4 m/ž montera - pomoćna montera za rad u Njemačkoj, javi� se na tel. 040/655-007 ili na mob. 099/6655-006 ili na email: mul�. ing.hr@gmail.com do 31.10.
4. listopada 2024.
63. Narodni trgovački lanac d.o.o., traži m/ž prodavače za mjesto rada Donja Dubrava, Orehovica, Vrhovljan, Podturen, Kotoriba, Belica, Dekanovec, Sveti Juraj u Trnju, Palovec, Totovec, Mursko Središće i Štrigova te m/ž mesara za radno mjesto Vrhovljan, javiti se na email: mirjana.blazi@ntl.hr do 19.10.
64. OLUK Robotics d.o.o., Nedelišće, traži m/ž limara ili pomoćnog građevinskog limara, javiti se na mob. 095/912-1436 ili na email: oluk.nedelisce@gmail.com do 31.10.
65. PAVLIC-ASFALT-BETON d.o.o., Murska 48, Donji Kraljevec, traži m/ž voditelja gradilišta, m/ž prometnog tehničara - voditelja redovnog održavanja cesta, m/ž vozača kamiona kipera s prikolicom i m/ž operatera na asfaltnoj bazi, javiti se na tel. 040/655-2525 ili na mob. 091/6655-508 do 31.10.
66. PERADARSTVO - uzgoj, klanje i prodaja peradi, Donji Pustakovec, traži 2 m/ž vozača B i C kategorije za mjesto rada Donji Pustakovec i 5 m/ž prodavača svježeg mesa pilića za mjesto rada Zabok, Samobor, Zaprešić, Zagreb, javiti se na mob: 098/282-147 do 27.10.
67. PEKARA IN, Čakovečka 57, Nedelišće, traži m/ž prodavača pekarskih proizvoda, javiti se osobno na adresu ili na tel. 040/821-502 ili na mob. 091/613-4377 do 21.10.
68. PROKONA, Prelog, N. Tesle 19, traži 2 m/ž inž. strojarstva - cad konstruktora - autodesk inventor i solidworks, javiti se osobno na adresu Poduzetnički centar Prelog, Hrupine 7b, ili na tel. 040/295398 ili na mob. 098/426-457 ili na email: info@prokona.com ili na link: www.prokona.eu do 21.10.
69. PROMMING d.o.o., I. Novaka 48, Čakovec, traži m/ž radnika na pakiranju plastificiranih metalnih pozicija, m/ž radnika na robotu za zavarivanje i m/ž radnika na ručnom punktiranju, javiti se osobno na adresu ili na tel. 040/386-313 ili na mob. 099/380-7104 ili pismena zamolba na adresu ili na email: posao@promming.hr do 31.10.
70. PRIMA NAMJEŠTAJ d.o.o., Čakovec, traži m/ž prodajnog savjetnika, javiti se na email: ibarisic@ prima-namjestaj.hr ili putem linka: https://prima-karijere.talentlyft. com/o/59o/apply do 6.10.
71. PPK Karlovačka Mesna Industrija d.d., Čakovec, traži 3 m/ž vozača, javiti se na email: goran. sajatovic@ppk.hr do 31.10.
72. Poljoprivredni proizvođač vl. Zlatko Vinković, Belica, N. Š. Zrinskog 20, traži 5 m/ž rukovatelja pakirnim strojem, javiti se na mob. 095/396-2110 do 31.10.
73. RIVA SUNSET d.o.o., Čakovec, traži 2 m/ž kuhara, m/ž konobara i m/ž pomoćna kuhara javiti se na email: zamolbe@markov.hr do 15.10.
74. REINOX d.o.o., Brezje 81 a, Lopatinec, traži 2 m/ž tig zavarivača, m/ž radnika na završnoj obradi inox materijala i m/ž radnika u bajcaoni, javiti se osobno na adresu ili na tel. 040/855-845 ili na mob. 098/268700 ili pismenom zamolbom na adresu ili na email: reinox@reinox. hr do 31.10.
75. ROYAL OTPREMNIŠTVO d.o.o., Glavna 45, Prelog, traži m/ž kuhara, javiti se osobno na adresu ili na mob. 098/1925-939 ili na email: luka@royaltransport.hr do 25.10.
76. SIGURNOST d.o.o., P. Z. Dražića 3, Zagreb - mjesto Rada Prelog, traži m/ž zaštitara s licencom, javiti se osobno na adresu ili na tel: 031/283470 ili 099/273-1250 ili emailom: sigurnost@sigurnost.hr do 31.10.
77. SKUBACH - obrt za frizerske usluge, Prelog , Jug II 31, traži m/ž frizera, javiti se na email: ines. mozek@gmail.com do 31.10.
78. SMART ROOF d.o.o., Čakovec, traži 3 m/ž pomoćna građevinska radnika, javiti se na mob: 091/6042628 do 18.10.
79. S.P.E.C. d.o.o., Čakovec, traži m/ž specijalistu za održavanje prostora, javiti se na mob. 091/6014778 do 31.10.
80. SVAM-LIM d.o.o., I. L. Ribara 31, N. S. Rok, traži 2 m/ž limara - krovopokrivača i m/ž radnika na visini, javiti se osobno na adresu ili na tel. 040/853-813 ili na mob. 091/5722091 ili na email: svamlim1@gmail. com do 31.10.
81. ŠIŠ ŠIŠ j.d.o.o., Goričan, traži m/ž frizera, javiti se na mob. 099/671-8966 do 31.10.
82. TEAM GRAĐENJE d.o.o., Čakovec, traži m/ž radnika na poslovima tehničke pripreme, m/ž voditelja gradilišta i m/ž zidara, javiti se na email: ihoblaj@teamgradjenje.hr do 5.10.
83. Tesarski obrt vl. Ljubomir Ceilinger, Nedelišće, Žarkovice 12, traži 5 m/ž tesara - krovopokrivača, javiti se na mob. 098/426-080 ili na email: ljubomir.ceilinger@gmail.com do 23.11.
84. TRANS-KUKOVEC d.o.o., Dravska 59d, Strahoninec, traži m/ž djelatnika za održavanje strojeva i m/ž pomoćnog radnika u radioni, javiti se osobno na adresu ili na mob: 098/241-673 ili na mob: 091/3527030 ili na email: racunovodstvo@ trans-kukovec.hr do 31.10.
85. Trgovina KRK d.d., Ž. fašizma 2a, Čakovec, traži 2 m/ž vozača teretnog vozila, m/ž prodavača u građevini za mjesto rada Belica, Nedelišće, Šenkovec i Pribislavec, te m/ž prodavače za mjesto rada Čehovec, Prelog, Savska Ves, Čakovec, Domašinec, Krištanovec, Križovec, Lopatinec, Novo Selo Rok, Podturen, Pribislavec, Strahoninec, Šandorovec, Totovec, Vratišinec, Vularija i Zasadbreg, javiti se pismenom zamolbom na adresu ili na email: dijana.bujan@trgovina-krk. hr do 30.10.

86. Transporti Šafarić d.o.o., Trnovec, traži m/ž vozača teretnog vozila, javiti se na mob. 099/685-8497 ili na email: transportisafaric@ gmail.com do 31.10.
87. TVORNICA STOČNE HRANE d.d., I. Novaka 11, Čakovec, traži 2 m/ž poljoprivrednog tehničara, javiti se pismenom zamolbom na adresu ili na email: marko.krnjak@
tsh-cakovec.hr do 14.10.
88. UO COBRA, Podturen, Čakovečka 18, traži m/ž voditelja restorana, m/ž dostavljača pizze i m/ž konobara, javiti se osobno na adresu do 30.10.
89. Ustanova za zdravstvenu njegu Strahija, Hodošan, Čakovečka 6, traži m/ž fizioterapeuta, javiti se osobno na adresu ili na mob.
098/9354-328 ili na email: rahela. bregovic@gmail.com do 31.10.
90. West Alpine Arbeitnehmerüberlassung d.o.o, traži 6 m/ž autogena zavarivača, 6 m/ž montera centralnog grijanja, 6 m/ž industrijskih mehaničara, m/ž montera ventilacijskih sustava, m/ž vodoinstalatera i m/ž električara za rad u Njemačkoj, javiti se na email:
westalpineaug@gmail.com ili na mob. 091/4580-880 do 31.10.
91. ZT-zgradarska tehnika d.o.o., Novakova 7, Nedelišće, traži 5 m/ž samostalnih montera ventilacije, nazvatinamob:099/535-9717iliposlati pismenu zamolbu na adresu: Oliver Martinjaš, Novakova 7, Nedelišće ili na email: zgradarskatehnika@gmail. com do 31.10.
osobno ili poštom: na adresu Media novine, Kralja Tomislava 2, 40000 Čakovec
mailom na adresu: oglasnik@mnovine.hr
putem obrasca na web stranici: www.mnovine.hr
PRODAJEM ČETIRI ALU FELGE veličine 15 cola s razmakom rupa 5x114,3. Upitati na telefon 091/3960-505
PRODAJEM MERCEDES A klasa 150 cdi 2012. godište, auto je očuvan i u dobrom stanju, redovito servisiran te je registriran do 9.12.2024., Klima, grijana prednja sjedala, el. podizači stakla, samozatamnjujuće unutarnje ogledalo, maglenke, upravljačke komande na volanu... Na vozilu se nalaze alu felge s ljetnim gumama 195/55 R16, kao i dodatni set original mercedes alu felgi s gumama 215/45 R17. Cijena: 4.500 eura. Više informacija na broj: 099 677 67 29
PRODAJEM HYUNDAI TUCSON
2.0 benzin-plin (atest plina do 2032.), reg. do 05/2025., u super stanju, prijeđeno 249.000 km, ljetne i zimske gume, cijena 4.600 eura, info na mob. 098/9354-369
PRODAJE SE MERCEDES 280 SI 1978. god., oldtimer u ispravnom stanju, bez dodatnih ulaganja. Tel. 098/209-984
KUPUJEM automobil, traktor, kamion, neispravan, ispravan, karamboliran. Dolazak i isplata. Info na mob. 098/777-095
PRODAJEM za Mercedes W203 zatezač remena i papučicu gasa. info na mob. 095/4323-601
POLJOPRIVREDA
PRODAJU SE INOX BAČVE za vino od 250 l (2 kom). Upita� na tel. 040/364-354
TRITIKAL prodajem NOVO sjeme OS Tulus pakirano po 50 kg. Moguća dostava do vašeg kućnog praga. Tel: 091/539-2870
KUPUJEM ILI UZIMAM U NAJAM POLJOPRIVREDNO ZEMLJIŠTE I ŠUME na području Čakovca i okolice, te Preloga i okolice. Isplata odmah kod kupnje nakon potpisa ugovora, a najam po dogovoru. Ponude na mob: 091/4286-107
PRODAJU SE SADNICE agacije, javora, graba i bukve, cijena sadnica je od 0,20-0,27 EUR, popust za veću količinu kupljenih sadnica, info na mob: 099/683-9984 ili 099/808-7586
PRODAJEM TRIMER Makita
mod. EM 2600 U, snage 1.2 KS. Sve info na mob: 098/214-107
POKLANJAMO STABLA ORAHA u rastu. mob. 099/5182-484
PRODAJEM MOTOKULTIVATOR
Labin Progres s frezom širine 50 cm i dva dodatna noža, 8 KS, benzin, inverter, u radnom stanju i rabljenu kosilicu za travu T475 Prak�k Garden, povoljno. Informacije na mob: 098/539169.
PRODAJEM VEĆI TRUPAC ORAHA. Nazvati na tel. 099/7991086
PRODAJEM motokultivator
F360 s frezom (550 eur); vaga koja važe do 150 kg (150 eur); kompresor na kotačima (150 eur); inoks cijevi + klap ventili različitih dimenzija (cijena po dogovoru). Info na mob. 098/9422-821
PRODAJE SE čekičar - krunjačmlin (komb.). Tel. 040/682-175
KUPUJEM JABUKE sorte bobovec. Info: 095 505 2760
PRODAJEM 1-redni kombajn za kukuruz, u super stanju, prikolica za sijeno jednom korištena te sijačica za pšenicu. info na mob. 095/4323-601
PRODAJE SE ŠUMA Markovčina oko 660 m2. Info na mob. 098/9256-256
PRODAJEM HIDRAULIČNU PREŠU 400 lit. i bačve za vino drvene i ros�rei, te staklene flaše za vino, vodu i pivo sa sanducima. Info: 095 505 2760
PRODAJE SE MALA PRIKOLICA za traktor, dimenzije: D160xŠ108xV70 cm, cijena 400 eura, info na mob.: 099/6839984
ODŠTOPAVANJE ODVODNIH CIJEVI s posebnim strojem, rješavam probleme sep�čkih jama. Stručno i povoljno. Tino obrt, mob: 098/931-7570
INSTALACIJE I MONTAŽA - voda, grijanje, klima�zacija, sanitarije. WaterSystems j.d.o.o., mob. 098/948-1981
POZNANSTVA
TRAŽIM ŽENU za druženje, vitka, nižeg rasta, starosti 50 godina i više. info na mob. 095/3423-099
MOMAK (50 g) traži slobodnu žensku osobu, srodnu dušu za život u dvoje (brak). Nazva� na mob. 099-5166-780
NEKRETNINE
KUPUJEM VOĆNJAK/VINOGRAD sa ili bez vikendice u brežnom Međimurju. Info: 095 505 2760
PRODAJE SE OGRAĐENO GRADILIŠTE u Pušćinama vel. 22x55 m. Poslati sms na broj 099/7447-710
PRODAJEM POLJOPRIVREDNO ZEMLJIŠTE u Nedelišću od 6551 m2. Info na mob. 097/737-4451

DRAMALJ - prodajem dvojnu kuću s pogledom na more, ne�o površine 115 m2 i dvorište 154 m2, 150 m do mora, info na mob. 098/426-021
IZNAJMLJUJEM POTPUNO NAMJEŠTENI STAN od 68 m2, poseban ulaz i zasebna brojila, udaljenost 5 km od ČK, info na mob. 091/5000-707
PRODAJE SE GRAĐEVINSKO ZEMLJIŠTE od 3585 m2, cijena 40 eur/m2, lokacija blizu Fužina. Uključena građevinska i uporabna dozvola. Info na mob. 099/3815015
TRAŽIM STAN u kući s korištenjem kuhinje i kupaonice, info na mob. 095/3423-099
PRODAJE SE NAMJEŠTENA KUĆA od 110 m2 sa imanjem, udaljeno 15 km od ČK. Info na mob. 099/638-6073
PRODAJU SE NOVI STANOVI srednji roh bau u Pribislavcu od 82m2 (3 sobe, blag.+ dnevna + 2 wc-a i 2 kupaone) i u izgradnji stanovi od 40m2 mogućnost spajanja u veći, ulica F. Kuharića 14 i 16 Pribislavcu ugodna i mirna lokacija novi dio naselja, a poklanja se cca. 20-tak kamiona crne zemlje s gradilišta. Mob. 095 858 15 02
IZNAJMLJUJE SE manji stan u Čakovcu. Info na mob. 098/195-7448
DAJE SE U NAJAM dugogodišnji uhodani ugos�teljski objekt u Nedelišću uz glavnu cestu. Dostupno od 1.1.2025.god. Info: 092/1642556.

Čistokrvni krupni štenci njemačkog ovčara, crveno-crnog plašta, roditelji s rodovnicom, stari osam tjedana, cijepljeni, dva puta pročišćeni od parazita i nametnika.Sve info. na 0976006038.
AKVARIJ od 30 litara s ribicama, puževima čistačima, živo bilje koje daje kisik, kompletno uređen, 50 eura. Šaljem slike i video, 098/9084-675
KUPUJEM romane, stripove, Nintendo i Sega igre. Ponude na mob. 098/921-9092
udomljenje se NE naplaćuje, a
Amy je stigla iz romskog naselja polomljenih nogu. Operirali smo je i sad je potpuno oporavljena. Jako je draga, obožava se maziti, naučena na život u kući (nalazi se na privremenom smještaju) i jako bi voljela samo svoju obitelj. Cijepljena je, kastrirana, stara dvije godine. Označena mikročipom broj 191035000197651. Javite se na 099 4800 640.
PRODAJE SE ugradbena pećnica i ugradbena ploča štednjaka (3 plin, 1 struja). mob. 095/3423099
PRODAJE SE kinderbet na kotačima s novim madracem i bicikl bez pedala podesive visine 3642 cm. Info na mob. 098/1703321
PRODAJU SE CRVENE DIOPTRIJSKE NAOČALE Dolce&Gabbana, 2 etuia idu uz naočale, dioptrija stakla je daljina, D-2, L-2, naziv stakla: orma trio clean, info na mob.: 091/761-3467
PRODAJEM: dva kreveta 90/200 cm s podnicom, fotelje (dvije veće i dvije manje) i dvije komode (dim. 110x84,5x34,5 cm). Sve novo, u pola cijene. Sve info na mob: 098/214-107
PRODAJE SE ŽENSKA kožna bunda s krznom vel. 48/50, također još nekoliko ženskih jakni i stvari. Info na mob. 099/404-7517
PRODAJEM: vrlo povoljno očuvane nove francuske ležaje dim. 200, 210 x 90, 95, 140, 160 cm, tap. gar. 4x1, stolice, dvosjed, regal, predsoblje, novi bide s armaturom, gus. kadu, ivericu cca. 50 m2 za pod, šiv. mašinu Višnja bagat, tepihe, flex, bušilicu, sobni orbi-trex, rodlin za plin. boce, bicikl, samohodnu vrtnu ispravnu kosilicu i još ostalo iz kuće. Info na mob. 091/5727-670
PRODAJE SE stroj izmir za prženje kave od 15 kg, te mlinac i stroj za pakiranje. Info na mob. 099/287-2453
KUPUJEM DIONICE Agromeđimurja, Tehnomonta, Eko-Međimurja, Hotela Zadar, Ivančice Ivanec, TPK Orometala, Aminessa, Božjakovine i druge dionice. Mob. 098 905 1011
KONOPI RAZNI za sidrenje-privez brodica, vezanje tereta, debljine 2 cm, od 10 eura na više. Šaljem slike. Zagreb, 091/9240293

UMIVAONIK 55/45 cm sa pipom za toplu i hladnu vodu. Info na mob: 098/214-107
BAKRENI KOTLIĆ ZA GULAŠ s miješalicom na struju, tronožac s lancem, 150 eura. Šaljem slike i video. Zagreb, 091/9240-293
POVOLJNO PRODAJEM KLIMA UREĐAJE, korištene ali ispravne, marka Haier 5 KW. Info na mob. 091/543-9006
NAUTIČKI PRSLUCI, univerzalni, 2 komada, 30 eura/kom. Šaljem slike, šaljem poštom. Zagreb, 098/9084-675
PRODAJEM peć za centralno 30 KW s plamenikom, 4 drvene bačve cijena 40 eur/kom i sačuvani drveni kotači za kola. Info na mob. 098/9256-256
POVOLJNO PRODAJEM VINSKU hidrauličnu prešu od 200 lit., tačke i plinski štednjak s bocom dim. 60x40 cm. info na mob. 095/897-8843
ŠATOR ZA TRI OSOBE s madracima, plinsko svjetlo, korišten jednu sezonu, 150 eura. Šaljem slike, Zagreb, 091/9240-293
PRODAJEM ANTIKVITETE: noćni ormarići, komode (bidermajer, neobarok), ormari (kristaljera), razna ogledala, stolice, psiha (ormarići s ogledalom) i pianino iz 19. stoljeća (potrebna restauracija). Idealno za opremanje stanova, kuća, seoskih turizama i sl. Sve info na mob: 098/214107
PLOČICE ZA LOVAČKE TROFEJE, ukrasne, drvene, nove, 2 veličine, 4 komada, 30 eura/kom. Šaljem slike, šaljem poštom. Zagreb, 098/9084-675
PRODAJEM nova protupožarna vrata T30 dim. 200x75cm (150 eur); dvije el. pumpe za vodu (100 eur); aparat za varenje WIGI 150G s malom bocom argona (150 eur) i el. bojler Ariston od 80 lit. (10 eur). Tel. 858-424 ili 098/9422-821






Usvakom se od nas skriva mali kreativac, bez obzira na to koliko godina brojili. A tog malog buntovnika, tog umjetnika u nama treba pustiti van neka zablista, neka ga čuju.
Ako ga ostavimo da zakržlja u nama pretvorit će se u njegovu negativnu suprotnost, a onda jao si ga nama i svima oko nas! Zbog toga i imamo ovu našu Stvaraonicu za velike i male u kojoj prikazujemo pisane i likovne kreacije svih dobnih skupina i svih fela.
Naglašavamo, osim za mlađahne poletarce, poziv vrijedi i za starije te sve
one između. Znamo da mnogi pišu uglavnom za svoju dušu, samozatajno skrivajući svoj talent od očiju šire javnosti. Nema potrebe, javite se, ohrabrite i druge, a mi ćemo se potruditi da dobijete dostojnu prezentaciju. Pozivamo vas da nam svoje radove pošaljete bez zadrške na e-mail stvaraonica@mnovine.hr ili da ih pošaljete poštom ili da ih predate osobno u našu redakciju na adresi Kralja Tomislava 2, 40000 Čakovec.
Nama će biti drago da ih možemo prezentirati širokom krugu naših čitatelja.




























Međimurec
Međimurec sam ja z lepoga kraja i vrednih ljudi. Kak ti ga za dobroga čoveka Mara me v cirkvo tira. Fletno sam se znašel i rekel: -Dobro, idem i Štefa podoč poberem.-
-Aha! Vkanil sam te!-
K Štefo sam pobegel I jemo se malo jadal. -Čuj, Štef! Ta moja Mara navek neka zadira.
-Tirat me dela i još na me krči!-
Tak smo se z Štefom do polneva spominali, a na mešo i žene pozabili.

Žene su z meše srdite dimo došle pa smo se rajši �krej pobrali.
Pre Đureko smo se v krčmi zastavili pa si jene gemište v miru spili. Karte smo na stol hitili par rundi zmetali i za kraj zapopevali.
Vjutro smo dimo došli, a za mir v hiži svojim ženama sosedovo cvetje nabrali. Al to ve nej bode med nami ka namo još i toti ispali.
Lorena Kovač, 8.razred, OŠ Domašinec, učiteljica Sanja Vebarić


Jelena Klinčević, mr. spec., klinička psihologinja
Čakovec, A. Šenoe 2a
Posjete psihologu obavezno prethodno dogovori� na broj 098/700-932 ili na email: jelenaklincevic@gmail.com
Velika je mudrost roditeljstva biti s djecom u pravo vrijeme, prepoznati kad smo im stvarno potrebni, a naći pravu mjeru potrebne prisutnosti u pojedinim fazama djetetovog odrastanja
Većina odraslih ljudi na svojim osobnim rang listama životnih uloga na prvo mjesto stavlja ulogu majke ili oca. Ipak, objektivne analize vremena koje ljudi provode u pojedinim socijalnim ulogama pokazuju da muškarci i žene koji imaju djecu, bez obzira na to jesu li u radnom odnosu, većinu vremena �izički nisu posvećeni roditeljstvu. To je u redu, ne trebamo stalno biti uz svoju djecu da bi nam ona bila najvažnija. Ljubav i povezanost su psihološke kategorije, unutarnja stvarnost koju imamo i kada �izički nismo s nekim. Naglašavam to zbog onih roditelja koji sebe okrivljavaju zato što misle da nisu dovoljno sa svojom djecom. Važnija je kvaliteta nego kvantiteta naše prisutnosti u životima vlastite djece. Trebamo biti s djecom u pravo vrijeme, trebamo prepoznati kad smo im stvarno potrebni, a naći pravu mjeru potrebne prisutnosti u pojedinim fazama djetetovog odrastanja velika je mudrost roditeljstva. Jedan od zadataka majki i očeva je da razvijaju pozitivnu sliku o sebi i zdravu samosvijest, da brinu za vlastitu dobrobit i mentalno zdravlje, kako bi mogli takve psihičke procese poticati u svojoj djeci. Temelji koje roditelji trebaju ugraditi u svoju djecu i na kojima se može graditi zdrava ličnost su dobro samoprihvaćanje i samopoštovanje. Svijest o sebi i razvoj vlastitoga ja složeni je cjeloživotni pro-
ces koji se kroz razne životne faze ostvaruje u brojnim ulogama, a uloga roditelja jedna je od najvažnijih. Roditelji su čuvari mentalnog zdravlja i dobrobiti djece pa je dobro da znaju ponešto o psihologiji ličnosti i psihičkoj strukturi čovjeka, zato se toliko često i puno vraćam na te teme. Kada govorimo o psihološkoj ulozi roditelja dobro je spomenuti teoriju ličnosti i psihoterapijsku školu koja se zove transakcijska analiza, jer je, prema toj teoriji, roditelj dio ličnosti koji internaliziramo već u ranom djetinjstvu. Pošavši iz psihoanalize psihijatar Eric Berne je razvio vlastitu teoriju u kojoj je tri strukturalna elementa ličnosti, koja je Sigmund Freud nazvao idom, egom i superegom, nadogradio uvođenjem ego stanja: djeteta, odraslog i roditelja. Svako ego stanje je speci�ičan sustav misli, osjećaja i ponašanja iz kojih ulazimo u interakcije s drugim ljudima. Vrlo pojednostavljeno možemo reći da svatko od nas u svojoj ličnosti kao središnjoj psihičkoj strukturi ima „ugrađeno“ dijete, odraslog i roditelja. U ego stanju djeteta nalaze se izvori naše energije i zadovoljstva, u poziciji odrasloga objektivno analiziramo stvarnost i nalazimo se ovdje i sada, dok u ego stanju roditelja imamo svoju prošlost, savjest i moralne kriterije. Međuodnosi i međuutjecaji tih segmenata ličnosti stvaraju vrlo složenu priču koja se mijenja i razvija cijeloga života.



Diana Uvodić-Đurić, dr. med., specijalist školske medicine, subspecijalist alkoholizma i drugih ovisnos�-adiktologinja
lučenje želučanih sokova, što zapravo ubrzava resorpciju, te se brzo resorbira iz želuca i krvlju dolazi u sve dijelove tijela, pa tako i u mozak na kojeg djeluje opojno. Resorpcija alkohola moguća je i preko pluća i kože, ali radi se o neznatnim količinama ili je potrebna puno duža izloženost visokim koncentracijama. Resorpcija je brža:
• ako se piju koncentrirana pića
SAVJETOVALIŠTE ZA



ALKOHOLOM UZROKOVANE PROBLEME I ALKOHOLIZAM
Zavod za javno zdravstvo Međimurske županije
Čakovec, I. G. Kovačića 1e
RADNO VRIJEME:
UTO I SRI: 15-18 sa�
ČET: 09-12 sa�
Kontakt tel: 099/2221-888
Pijenje alkohola na ovim je prostorima društveno prihvatljivo ponašanje, ukorijenjeno u običaje i tradiciju i mnogi uopće ne razmišljaju o tome hoće li u nekoj prigodi piti ili ne, jer im se odluka nameće sama po sebi
Unatoč pojavi i dostupnosti brojnih novih psihoaktivnih tvari, alkoholom uzrokovani problemi i alkoholizam su još uvijek jedni od vodećih javnozdravstvenih problema današnjice. U gotovo svim zemljama svijeta raste potrošnja alkohola po glavi stanovnika, a problem je posebno izražen u Europskoj regiji. Prema rezultatima Europskog istraživanja o pušenju, pijenju alkohola i uzimanju droga među učenicima (European School Survey Project on Alcohol and Other Drugs – ESPAD) iz 2019. godine čak 79 % učenika u dobi od 15 do 16 godina pilo je alkohol barem jednom u životu. Taj podatak ne čudi jer mnoga djeca kušaju alkohol, često i na nagovor svojih roditelja ili nekog drugog člana obitelji. Međutim, podatak da je gotovo polovica (47 %) njih pila alkohol u posljednjih mjesec dana govori da se ne radi samo o znatiželji i isprobavanju okusa, nego o već usvojenom ponašanju. Značajna je i pojavnost ekscesivnog epizodičnog pijenja (35 %), uz sve manje razlike u zastupljenosti ovog načina pijenja među djevojkama (34 %) i mladićima (36 %). Pijenje alkohola na ovim je prostorima društveno prihvatljivo ponašanje, ukorijenjeno u običaje i tradiciju. Mnogi uopće ne razmišljaju o tome hoće li u nekoj prigodi piti ili ne, jer im se odluka nameće sama po sebi. Ono o čemu se eventualno razmišlja je koliko se smije popiti, a da se to ne pozna u alkotestu. O čemu to ovisi i kako djeluje alkohol na ljudski organizam?
Alkohol u želucu uzrokuje hiperemiju (pojačanu prokrvljenost sluznice) i pojačano

• ako se pije na prazan želudac (maksimalna koncentracija u krvi postigne se za 10 - 20 min.)
• ako se piju topla pića
• ako se pije brzo
• uz ugljični dioksid i bikarbonate (pjenušci)
• kod ljudi s težom ozljedom glave i oboljenjima jetre
• kod određenih genetskih poremećaja.
Kad jednom dospije u krv, alkohol se uvijek razgrađuje istom brzinom i na to se ne može utjecati. Zato su jako opasna brza ispijanja velikih količina alkohola i posljedično trovanje alkoholom. Oko 98% alkohola razgradi se u jetri, a ostatak se izlučuje mokraćom i izdahnutim zrakom, te znojenjem. Resorpcija alkohola u organizmu je jako brza, ali za razliku od resorpcije, za razgradnju treba puno više vremena.
Da bi uklonila alkohol iz krvi unesen samo jednom čašom piva jetri treba najmanje 1 sat!
Za dvije čaše piva potrebna su 3 sata. Za tri čaše piva potrebna su 4 sata. Za četiri čaše piva potrebno je 6 sati. Za razgradnju pet čaša piva potrebno je 8 sati!!!
Mnogi ljudi misle da je dovoljno malo odspavati ili popiti nekoliko kava da bi se otrijeznili. Zbog takvog pogrešnog stava vrlo su česte nesreće, pogotovo u prometu, jer vozač motornog vozila koji je bio u pripitom stanju i nakon toga samo kratko odspavao pa nastavio voziti, ima u krvi još uvijek visoku razinu alkohola i lako može uzrokovati prometnu nesreću nekom svojom krivom procjenom. Nakon resorpcije alkohol se nalazi u krvi u najvećoj koncentraciji oko jedan sat nakon uzimanja, a nakon toga se razgrađuje i koncentracija se smanjuje. Ne pomaže na žalost ni hladan tuš, ni kava, ni pojačana �izička aktivnost da bi razgradnja bila brža. Priče o čudesnim brzim otriježnjenjima, ostaju samo priče, a djelovanje prije spomenutih metoda u najboljem ćete slučaju osjetiti na svom novčaniku, ako vas u pripitom stanju zaustavi policija. Stoga je dobro upamtiti da niti sa, niti bez hladnog tuša, alkohol i promet nikako ne idu zajedno.

Za sudionike ovo nije bila tek obična utrka – ovo je bio susret s onime što simbolizira Vukovar
Piše: Sania Bižupić
Prošlog je vikenda održana treća utrka naziva Vukovarskih 198, jedinstveno sportsko događanje koje okuplja trkače iz cijele Hrvatske kako bi se popeli na sam vrh Vukovarskog vodotornja. Trkači su se suočili sa izazovom osvajanja 198 stepenica.
Trkači na putu do simbola Vukovara
Ove godine utrka je okupila mnoge sudionike, među kojima su Luka Povodnja, Mihael Gunc, Bernarda Polanec, Sandra Sovar, Neven Horvat, Marija Medved, Josipa Bratković, Dijana Bratković, Tihana Zak Tompoš i Luka Gunc. Svi su oni uložili nevjerojatan trud. Za sudionike ovo nije bila tek obična utrka – ovo je bio susret s onime što simbolizira Vukovar, grad koji je simbol hrabrosti i nepokolebljivosti.
Tihana Zak Tompoš, zapovjednica DVD-a Mihovljan, opisala nam je snažan emocionalni doživljaj koji se






Luka Povodnja, Mihael Gunc, Bernarda Polanec, Sandra Sovar, Neven Horvat, Marija Medved, Josipa Bratković, Dijana Bratković, Tihana Zak Tompoš i Luka Gunc s medaljama oko vrata
dogodio prije samog starta: - Ne znam kako opisati taj doživljaj tamo. Kada dođeš pred toranj i gledaš ga gore, misliš si – nema šanse. Prije početka utrke - himna, Vukovar, vodotoranj, suze u očima. Sam uspon nije bio ništa manje emocionalan. - I onda kreneš, juriš po stepenicama.
Na 145. misliš da je gotovo jer ti odjednom noge počinju klecati, ali tamo su volonteri koji te bodre i viču: „Ajde, idemo, još malo, nema stajanja“, ispričao je jedan od sudionika. Volonteri su igrali ključnu ulogu u održavanju entuzijazma trkača, podsjećajući ih da odustajanje nije opcija.












Nema prepreke koja se ne može svladati
Najteži dio trke bio je trčanje po rampama, kada su trkači prestali osjećati noge. Nakon izlaska iz vodotornja, dočekalo ih je još desetak stepenica do vrha – do medalje. - Vjetar u kosi, srce u grlu i ideš, jedva, ali ideš, opisali su trkači kako su
prolazili posljednje korake, te je postalo jasno da nema prepreke koja se ne može svladati uz dovoljno volje i podrške. Na vrhu vodotornja, osim što su trkače dočekale medalje, dočekao ih je i predivan pogled na Vukovar i okolicu. Taj trenutak bio je simboličan – kao da svaka stepenica koju su savladali predstavlja korak prema
ponosu koji Vukovar nosi. Ipak, bilo je i onih kojima je fizički napor bio previše. - Neki su na vrhu povratili, siroti, prepričali su trkači, aludirajući na težinu ovog podviga. Vukovarskih 198 je podsjetnik na snagu i zajedništvo koje je ovaj grad pokazao tijekom najtežih vremena, a trkači koji su se odvažili na ovaj izazov osjetili su tu snagu.
















































Grah s kobasicama klasik je koji jedemo u svim mogućim prigodama bez obzira na godišnja doba
Piše: Aleksandra Sklepić
Grah s kobasicom pravo je domaće jelo koje se jednostavno priprema, a sve je popularnije zbog prezasićenosti fast-foodom i pecivima kojima smo obasuti sa svih strana. Ovo je jelo poznato svima, a može se raditi u svakojakim kombinacijama. Umjesto kobasica, dovoljno je malo dimljenog mesa i postignut je željeni učinak punog okusa i snage kojom nas grah krijepi.
Grah s kobasicom klasik je koji jedemo u svim mogućim prigodama bez obzira na godišnja doba, a popularan je na okupljanjima oko kotlića u prirodi.
Priprema:
Luk očistiti i narezati na kockice. Popržiti ga na ulju i

kad je crvenkast, dodati kobasice narezane na kolutove te sve zajedno malo prodinstati. Dodati jednu žlicu mljevene slatke paprike, vegetu, sol, papar, prema vlastitom ukusu. Mrkvu očistiti i također narezati na kolutove. Dodati malo vode ili temeljca i lovorov list, te sve zajedno kuhati na laganoj vatri, oko pola sata, do četrdeset pet minuta. Dolijevati vodu ako je potrebno.
Na kraju u varivo dodati grah koji smo prethodno skuhali do pola ili kuhani grah iz limenke. Pripremiti zapršku od malo brašna (dvije do tri žlice) i ulja. U zapršku uliti malo vode i dodati u grah. Sve zajedno neka provri još desetak minuta. Nakon grah variva odlično je poslužiti ne-
Sastojci:
- ½ kg graha
- 3 do 4 suhe kobasice
- 2 glavice luka
- 1 češanj češnjaka
- 2 do 3 mrkve
- ulje
- slatka mljevena paprika
- začini: sol, papar, vegeta
- lovorov list
ki domaći kolač, pogaču ili štrucu, čime će se u potpunosti postići okus domaće kuhinje.
Stoljetna tradicija proizvodnje kvalitetnih i vrhunskih vina obitelji Belović iznjedrila je između ostalog i vrhunsko bijelo vino. Riječ je o sauvignonu (alk. 13 %). Ovo vino izvrsne kvalitete karakterizira svježina, intenzivan okus herbalnih
nota. Suh i mirisan sauvignon proizveden i odnjegovan u obiteljskoj vinariji Belović odlično će se sljubiti s bijelom slatkovodnom ribom, primjerice sa šaranom iz pećnice i povrćem kao prilogom. Svakako kušajte. Uzdravlje! (zv,rr)


Recept plus



Riba je uvijek zahvalna namirnica kada želimo pripremiti brzo i zdravo jelo. Za jelovnik ovog petka odabrali smo slatkovodnu riječnu ribu, šarana. Idealno je ako možete nabaviti divljeg šarana, ali dobro će poslužiti i onaj iz uzgoja. U našem receptu pripremali smo divljeg šarana iz pećnice. Očišćenu ribu dobro posolite. U lim za pečenje stavite korjenasto povrće
(mrkva, celer, peršin), svježu crvenu papriku narezanu na komade te krumpir i batat narezan na ploške. U tavi na malo ulja prodinstajte crveni luk također narezan na ploške te luk također stavite u lim za pečenje između povrća. Na povrće stavite šarana srednje veličine. Na ribu zatim stavite list kadulje i sve zalijte s malo bijelog ulja. Ribu i povrće pecite oko sat vremena na 210
Sastojci: - šaran - 2 krumpira - 2 veća batata - 2 svježe paprike
- 3 glavice luka
- 1 dcl bijelog ulja
- sol - list kadulje
U

Priprema: Suhi kvasac, žličicu šećera, žličicu brašna i malo toplog mlijeka dobro izmiješajte te ostavite na toplom mjestu da se kvasac digne. U većoj posudi prosijte brašno, dodajte soli i dobro izmiješajte. Zatim u brašno dodajte dignuti kvasac i mlaku vodu pa umijesite tijesto. Mijesite ga 10 minuta uz dodavanje brašna sve dok ne dobijete mekano tijesto koje se ne lijepi za ruke. Tijesto lagano nauljite
maslinovim uljem, vratite u zdjelu, prekrijte ga, a zatim ostavite da se diže barem 45 minuta. Preporučuje se čim duže odmaranje tijesta jer će biti prozračnije. Tijesto podijelite na dva dijela, svaku polovicu stavite na papir za pečenje, dobro razvucite, prebacite na pleh i nadjenite omiljenim sastojcima. Pecite u prethodno zagrijanoj pećnici na 250 stupnjeva Celzijevih (uz ventilaciju) na donjoj rešetki oko 10 minuta.
Sastojci:
Sastojci za dvije pizze:
- 500 g pšeničnog bijelog brašna za pizzu Čakovečki mlinovi
- 1 žličica soli
- 1 vrećica suhog kvasca
- 50 ml mlijeka
- 1 žličica šećera - 250-280 ml mlake vode
- 1 žlica maslinovog ulja


MARIJA MESARIĆ iz Belice



Iako je u mirovini, nikad joj nije dosadno, aktivna je na brojnim poljima, a posebno uživa u pečenju kolača
Piše: Aleksandra Sklepić
Zlevanka od kukuruznog brašna čest je kolač u našem malom dijelu svijeta, ali koliko god puta naiđemo na njezin recept, svaki se od njih po nečemu razlikuje. Zajednički im je jedino �ini, slatkast okus kukuruznog brašna i sočnost �inog tijesta posutog orasima i makom.
Svaka kuharica vjerna je svom domaćem receptu, a kako se kuruzna zlevanka peče u Belici, pokazala nam je Marija Mesarić (70). Mariju poznaju sve generacije jer je četrdeset i dvije godine radila

kao viša medicinska sestra u patronaži na području Male Subotice i Belice, ali za potrebe zamjena kolegica, ispričala nam je, prošla je cijelo područje uz Dravu i Muru – od Podbresta do Pušćina i od Turčišća do Peklenice. Sada je u mirovini već devet godina, ali to ne znači da miruje. Dapače, aktivna je na brojnim poljima, a jedna od većih ljubavi joj je pečenje kolača. - Kolače pečem po starim receptima, od mame i bake, kako to već ide u našem svijetu, rekla nam je. Recept koji koristim za kuruznu zlevanku najjednostavniji je od
Sastojci:
- 2 jaja
- 2 dl kukuruznog brašna
- 2 dl grisnog (oštrog) brašna
- ½ dl ulja
- 2 dl šećera
- 1 vanilin šećer
- 1 prašak za pecivo
- 1 kiselo vrhnje
- mljeveni orasi i mak
Priprema:
Jaja, brašno, šećer, ulje, vanilin šećer i prašak za pecivo dobro izmiksati. Uliti u posudu za pečenje, te posipati mljevenim orasima i
makom, po želji. Po cijeloj zlevanki žlicom rasporediti kiselo vrhnje koje smo prethodno razmutili s malo ulja. Zlevanka se peče na 180 stupnjeva tako dugo dok ne dobije koricu. Duljina pečenja ovisi o visini pleha u kojem se peče, a najbolje je probati čačkalicom. Tijesto je pečeno kad na čačkalici ne ostane trag tijesta. Ova zlevanka pečena je u zemljanoj posudi staroj sto godina koju Marija ima u obitelji i pažljivo je čuva. Pečenje u njoj, zbog njene debljine i materijala od kojeg je izrađena, traje malo duže.



Da bismo pomogli sugrađanima koji su tijekom pandemije koronavirusa ostali “zarobljeni” unutar svojih četiriju zidova i nisu svakodnevno išli u trgovinu po namirnice, krenuli smo s rubrikom u kojoj smo objavljivali tradicionalne međimurske recepte.


svih koje sam do sada vidjela i držim ga se, jer zlevanka ispadne �ina i sočna. Posebno je ukusna kad se peče u staroj zemljanoj posudi, koju je još koristila moja prabaka. Marija je članica brojnih udruga, Udruge umirovljenika Belica, Pjevačkog zbora umirovljenika Belica te Udruge žena Belica, i to od samog osnutka. Rado se odaziva i sudjeluje u organizaciji svih događanja, ide na sportske susrete gdje se natječe u bacanju kolutova, a jako voli ručne radove. Jednom
NAGRADNI NATJEČAJ Optike Briljant i Međimurskih novina
tjedno u Belici organiziraju radionice ručnih radova, a i kod kuće Marija rado hekla, veze i štrika. Sudjeluje na sportskim natjecanjima Sport za sve, gdje putuju po Međimurju, ali i po cijeloj Hrvatskoj, a bavi se i nordijskim hodanjem. Nikad joj nije dosadno, otkrila nam je. Uskoro će organizirati obilježavanje Dana starijih osoba, Dana kruha i Dana krumpira u Belici, gdje će se Udruga predstaviti svojim štandom s domaćim kolačima i ručnim radovima.
Marija ima kćer i sina te unuku koja ima sedamnaest godina. Rado se s njom druži i ponosna je na sve njezine uspjehe.
Kad ima slobodnog vremena, rado priprema domaća jela i kolače po starinskim receptima, a mnoge od njih brižno čuva kako bi ih spasila od zaborava. Preporuča svima da probaju pripremiti kolače u starim zemljanim posudama, ako ih imaju, jer se na taj način najljepše vratiti u doba kad su za nas kuhale i pekle naše prabake, bake i mame.
Recepti su to naših mama i baka koje su gotovo ni iz čega stvorile �ini ručak za svoju brojnu obitelji.
Budući da su recepti naišli na dobar odaziv vas čitatelja, nastavljamo i dalje s tom praksom. Drugim riječima, iz broja u broj slijede recepti �inih i ukusnih jela koje su isprobale i potvrdile generacije i generacije Međimuraca. Jela su pripremljena uz mnogo mašte i ljubavi od jednostavnih namirnica koje doma ima svaka obitelji. Tko kaže da se i od običnog krumpira, tjestenine, riže i ostalih namirnica ne mogu skuhati odlična jela?
S jedne strane imamo obrok, pripremili smo nešto novo i vraćamo se u djetinjstvo naših roditelja, a s druge strane, upotrebljavamo jednostavne domaće namirnice, često iz vlastitog vrta ili lokalnog OPG-a. Tako ne moramo svakodnevno u trgovinu čime na kraju krajeva čuvamo kućni budžet. (vv)
U suradnji Optika Briljant–Međimurske novine, u tijeku je još jedan nagradni natječaj. U narednim mjesecima svaki tjedan nagradit ćemo po jednog čitatelja vrijednim besplatnim očnim pregledom u Poliklinici Briljant Čakovec.
Kako konkurirati za nagradu?
Svaki tjedan u Međimurskim novinama donosimo kupon. Vaš zadatak je skupiti najmanje 3 različita kupona ne starija od mjesec dana označena brojem Novina te ih u zatvorenoj kuverti-omot-
nici donijeti ili poslati na našu adresu. Skupljene kupone treba donijeti osobno ili poslati poštom s naznakom “Za nagradni natječaj - Osvoji besplatan očni pregled” na adresu: Međimurske novine Čakovec, Kralja Tomislava 2. Rok za predaju kupona za besplatan pregled koji poklanjamo je utorak, 8. listopada do 12 sati. Novi sretni dobitnik pregleda bit će objavljen u izdanju od petka, 11. listopada. Napominjemo još jednom, šaljete tri različita kupona u kuverti. (mn)
Važna napomena: Dobitnik se treba najkasnije u roku od 7 dana (od dana objave) javiti telefonski u Polikliniku Briljant i dogovoriti termin pregleda. Na pregled obavezno uze� sa sobom ovaj izrezak iz naših
novina na kojem piše dobitnik i osobnu iskaznicu. Telefon Poliklinike: 040 391-240. Radno vrijeme: utorak i četvrtak 8 do 14 sa�, ponedjeljak, srijeda i petak od 13 do 19 sa�.

Ime i prezime:
Adresa:
Broj telefona:
Piše: Branka Marciuš, viša kustosica arheoloških zbirki
Zahvaljujući stabilnoj orbiti i jedinstvenom položaju u Sunčevu sustavu, Zemlju su tijekom 4,56 milijardi godina duge prošlosti raznoliki događaji i procesi, iz vrućega, stjenovitog tijela preobrazili u plavi planet s vodom ispunjenim oceanskim bazenima i morima nad čijim se površinama izdižu kopnene mase. Prvotan se život pojavio prije otprilike 3,8 milijardi godina u oceanima i otada se postupno razvijao od prvih jednostavnih oblika, postajući sve kompleksniji, no evolucijska mu je staza bila sve prije negoli glatka.
MUZEJ MEĐIMURJA ČAKOVEC
Trg Republike 5, 40 000 Čakovec
T/F: +385 (0)40 313 499 E: mmc@mmc.hr
RADNO VRIJEME: Ponedjeljak – Petak: od 8 do 18 sati
Subota – Nedjelja: od 10 do 16 sati
Blagdanima i državnim praznicima Muzej je zatvoren.
Pod utjecajem prijenosa topline u Zemljinoj unutrašnjosti, tektonske su ploče neprestano klizile preobražavajući Zemljine krajolike te stvarajući i razlamajući kontinente. Tektonika ploča i vulkanske aktivnosti uvjetovale su izmjenu smjera kretanja oceanskih struja, što je uzrokovalo promjene klimatskih obrazaca te izmjenu razine mora. Sveobuhvatna se Zemljina klima poput klatna mijenjala od stanja nalik onome u ledanama do onoga u staklenicima. Naš promjenjiv planet stvorio je mnoge izazove životu – od otrovnih mora, golemih ledenih pokrova i velikih pustinja do razdoblja gotovo neprestane kiše. Klimatske promjene i udari svemirskih tijela često su imali po život opasne, a ponekad i katastrofalne posljedice. U pet navrata planet je doveo život do samoga ruba postojanja i svaki su put oko tri četvrtine svih vrsta izgubljene u masovnim izumiranjima. Najveće izumiranje nakon kojeg je oporavak kralježnjaka trajao gotovo 30 milijuna godina dogodilo se na prijelazu perma u trijas prije 251 milijuna godina, dok je najpoznatije ono krajem krede, prije 66 milijuna godina kada su ne-
stankom dinosaura primat preuzeli sisavci.
Razvoj našega planeta popraćen je s iznimno mnogo događanja, a sagledamo li sadašnjost i pretpostavimo li budućnost, razvidno je da na spomenute mijene sve više utječe čovjekova aktivnost negoli geološka dinamika planeta. Od industrijske revolucije ljudi utječu na prirodu koristeći sirovine bez omogućavanja njezinoga oporavka. Gubitak prirodnih staništa doveo je do smanjenja bioraznolikosti što je prijetnja ekosustavima diljem svijeta. Prirodan proces izumiranja koji omogućava prirodi da postupno nadomjesti izgubljeno ubrzan je do opasne brzine. Trenutačna stopa izumiranja je između 100 do 1000 puta veća od one prije pojave čovjeka, a mišljenja su znanstvenika da svjedočimo šestom masovnom izumiranju. Unatoč nestabilnoj i dinamičnoj Zemljinoj prošlosti, Sunčeva energija, voda i savršena kemija stvorili su idealne uvjete za začetak života, odnosno, nastanak sićušne stanice nazvane LUCA (eng. Last Universal Common Ancestor) koja je posljednji zajednički predak svim živim bićima na našem planetu. Od tih skromnih početaka
trebale su milijarde godina da se razvije kompleksan i raznolik život koji je nastanio sve okoliše. Cjelokupno putovanje od začetaka života do beskrajne raznolikosti današnjice poticala je prilagodba životnim uvjetima. Spomenuta prirodna zakonitost podrazumijeva da organizam s razvijenim osobinama za preživljavanje, bolje rečeno, najprilagođeniji organizam, prenošenjem svojih genetskih karakteristika u nasljeđe, s vremenom rezultira nastankom posve nove vrste, različite od svojih predaka i bolje prilagođene okolišu – to je evolucija ili postupna promjena nasljednih osobina živih bića na Zemlji. Istražujući fosile ili ostatke prošloga života koje su geološki procesi zakopali u naslage, znanstvenici su tijekom posljednjih 200 godina prikupili mnoštvo fosilnih zapisa, odnosno, podataka o fosilima širom svijeta koji su osnovni izvor informacija o prošlosti života na Zemlji. Temeljem spomenutih istraživanja znamo da današnji živi svijet od oko 8 milijuna vrsta, čini samo jedan posto svih vrsta koje su ikad postojale, što znači da ih je otprilike 4 milijarde tijekom Zemljine geološke prošlosti izumrlo.

Jedna od izumrlih vrsta je vunasti mamut (Mammuthus primigenius) – srodnik slona koji je tijekom pleistocenskih ledenih doba te dijelom holocena živio na području Euroazije i Sjeverne Amerike. Fosilni nalazi kostiju i zuba ovih velikih biljojeda relativno su česti u gornjopleistocenskim naplavinama rijeka, a omeđenost Međimurja dvama velikim vodotocima uvjetovala je njihovo postojanje i na području međimurskoga međuriječja. Od svog osnutka do danas Muzej Međimurja Čakovec prikuplja, čuva i provodi zaštitu, među ostalim, i fosilnih nalaza sakupljenih u Zbirci paleontološke građe.
Iako malobrojni, u zbirci su pohranjeni značajni paleontološki ostatci gornjopleistocenskih vunastih mamuta, ali i fosilnih surlaša iz geološkoga perioda neogena. Prema načinu prikupljanja svi pripadaju slučajnim nalazima. Većina ih potječe iz naplavina rijeka Mure i Drave, dok su četiri primjerka prikupljena prilikom eksploatacije ugljena nedaleko Murskoga Središća. Spomenuta restaurirana i konzervirana te stručno determinirana paleontološka građa po prvi će put biti predstavljena javnosti izložbom Muzeja Međimurja Čakovec pod nazivom Vunasti mamuti – divovi ledenoga doba.
ZNAKOVI OVAJ TJEDAN: Ovan, Jarac, Vaga
LJUBAV: Pred vama je tjedan intenzivnih izlazaka i brojnih prilika za ljubav. Vaš društveni život će oživjeti i postati toliko bogat da se u prvi tren možda nećete ni snaći. Prihvatite pozive, dotjerajte se i idite među ljude. Oni vas očekuju s veseljem.
KARIJERA: Izađite u susret jednoj osobi koja nije sigurna kako obaviti posao. Budite otvoreni, jer se u krajnjoj liniji radi o zajedničkim rezultatima koji će kasnije doći. Zahvalnost koja će uslijediti bit će vam novi motiv za daljnji rad u budućnosti.
ZDRAVLJE&SAVJET: Čovjek je čovjeku lijek.
OCJENA: LJ 5, K 4, Z 5
LJUBAV: Voljena osoba zračit će više nego vi, pa joj slobodno prepustite neka vas vodi. Ona će ovih dana daleko bolje osmisliti vaše zajedničko vrijeme nego vi sami. Prepustite joj se s povjerenjem. Uživajte u životu.
KARIJERA: Čekate da drugi daju svoje mišljenje o onom što ste napravili zajedno sa svojim suradnicima. Oni će vas podržati, ali vi sami od sebe zahtijevat ćete još više. Ponekad će vaša očekivanja biti nerealno visoka.
ZDRAVLJE&SAVJET: Obratite pažnju na kvalitetu prehrane.
OCJENA: LJ 4, K 5, Z 4
LJUBAV: Povremena otuđenost koju ćete primjećivati u osobnim odnosima ponekad će vas zabrinjavati. Prihvatite je kao priliku da poradite na svojoj unutrašnjoj osobnoj inventuri. Ovo je prolazna faza kroz koju lakše prolazite s humorom.
KARIJERA: Posao će vam izgledati sve lakši. Ipak, to je samo vaš kut gledanja. Sada imate dovoljno razloga da radite bez briga, ali napori će vas sustizati. Zato se dobro organizirajte. Duh vodi tijelo, ali tijelu nekad treba stanka.
ZDRAVLJE&SAVJET: Vježbajte tehnike relaksacije.
OCJENA: LJ 4, K 5, Z 4
LJUBAV: Oni koji su već u vezama trudit će se što više učvrstiti svoj odnos s voljenom osobom. Proradit će još neka mala pravila i utemeljiti stabilnije kriterije međusobnog ponašanja.
KARIJERA: Vjerojatno ćete imati povećan obim poslova, no kako je karakter većine toga vama zanimljiv, neće vam biti teško raditi. Problem će biti u nedostatku energije, pa se pripremite kroz što bolji plan i štedite svoje snage.
ZDRAVLJE&SAVJET: Raste vaš interes za brigu o zdravlju.
OCJENA: LJ 4, K 5, Z 4
LJUBAV: Većinom ćete se snalaziti kako znate i umijete. Jedan dan bit će sjajno, a drugi nikako. Najbolje se da se ovaj drugi dan osamite. Ne ulazite u rasprave jer one neće dobro završiti. Ono dobrog vremena između vas i voljene osobe provedite u ljubavi.
KARIJERA: Trenutačno niste u najboljoj formi za rad. Ne samo da vam se ne radi, nego i okolnosti ne daju poticaje. Nedostatak motivacije bit će prirodna posljedica ovakvog stanja. Uglavnom ćete odrađivati zadano bez previše pitanja.
ZDRAVLJE&SAVJET: Boravak u prirodi bi vas osvježio.
OCJENA: LJ 4, K 4, Z 4
LJUBAV: Sve će se više ljudi skupljati oko vas. Jednostavno će voljeti biti u vašem društvu, ali će vas katkada i kritizirati. Ako već jeste u vezi, više ćete vremena provoditi s ekipom poznanika i partnerom, nego sami s partnerom. Nađite sredinu.
KARIJERA: Intenzivirat će se suradnja sa šefovima ili onima koji upravljaju u firmi u kojoj radite. Morat ćete se pokazati kao ozbiljan i profesionalan suradnik.
ZDRAVLJE&SAVJET: Nemojte se predati bez borbe.
OCJENA: LJ 5, K 4, Z 4
LJUBAV: Male brige u privatnom životu kompenzirat ćete dobrim utjecajima u drugim područjima života. Mnogi će pobjeći u svoj posao ili društvo prijatelja i tamo ostati dok ne naiđu na neku obećavajuću privatnu atrakciju. Puno ćete pričati sa svima.
KARIJERA: Zamislit ćete se nad svojom budućnošću, a posebno nad svojim talentima. Shvatit ćete da oni nisu do kraja izraženi i iskorišteni. Tražit ćete načine kako ih uklopiti u posao koji radite, a neki će se upustiti u novi posao sa strane.
ZDRAVLJE&SAVJET: Budite svjesni sebe.
OCJENA: LJ 4, K 4, Z 4
LJUBAV: Bit ćete spremni na mnoge ljubavne pustolovine. Oni koji već jesu u duljim vezama izlazit će na vrlo atraktivna mjesta. Zajedničko vrijeme će vam proletjeti, a povremeno ćete i kritizirati jedno drugo. Ne pretjerujte s tim.
KARIJERA: Pred vama su novi veliki izazovi. Nezgoda je u tome što su neminovno povezani sa suradnjom i maksimalnom uvažavanjem drugih, pa i onih s kojim se ne slažete uvijek.
ZDRAVLJE&SAVJET: Držite se zacrtanih planova.
OCJENA: LJ 5, K 4, Z 4
LJUBAV: Malo bolji vjetar u leđa nego dosad u ljubavnom životu osvježit će vašu vezu. Zato dajte sve od sebe da osigurate kvalitetan odnos s osobom do koje vam je stalo. Bit će malih nervoza i nesporazuma, ali nemojte im pridavati značaj.
KARIJERA: Pred vama su izazovi kreativnosti i hrabrosti. Samo uz primjenu takvih vještina možete uspjeti. Povučenost ili mehanička odrada stvari trenutačno vam nisu dobro postavljeni. Ključ uspjeha za vas nalazi se prihvaćanju izazova.
ZDRAVLJE&SAVJET: Nađite sadržaje koje volite.
OCJENA: LJ 5, K 4, Z 4
LJUBAV: Nezainteresiranost ili frustracije sve će više pratiti vaš ljubavni život. Važno je da se s tim nosite strpljivo i da imate na pameti da je sve prolaznog karaktera. Zato svoju vezu čuvajte, te mirom i tolerancijom održavajte status quo.
KARIJERA: Ako vam se učini da je pred vama dug put, prihvatite to s veseljem, jer je isti dobar. Ono što se pokrenulo, nastavit će se razvijati dalje i to na stabilan način. Na vama je da se prilagodite i uklopite.
ZDRAVLJE&SAVJET: Meditirajte.
OCJENA: LJ 4, K 4, Z 5
LJUBAV: Bez obzira na ne uvijek najpovoljnije ljubavne prilike, vi ćete biti optimist. Zato nećete samovati, nego ćete ići među ljude. Oni će vas rado prihvaćati zbog pozitivnog stava. Tako sami svojim ponašanjem poboljšati svoj privatni život.
KARIJERA: Sve što radite nekako će odlaziti u sjenu. Ipak, kako ćete biti potpuno svjesni svojih prethodnih uspjeha, to što niste u prvom planu neće vam smetati kao što bi to bilo inače. Ne mogu se sve kockice baš složiti u isto vrijeme.
ZDRAVLJE&SAVJET: Budite strpljivi u svemu.
OCJENA: LJ 4, K 4, Z 4
LJUBAV: Atrakcije na koje ćete svaki dan nailaziti budit će u vama uspavane snove o ljubavi iz bajke. Imat ćete toliko motivacije da biste mogli pretjerati s tulumima.
KARIJERA: Hvatat će vas nervoza kad će trebati surađivati s drugima. Najviše zato što s njihove strane neće sve teći profesionalno. Shvatite da nisu svi toliko okretni i spretni kao vi i da ponekad nekom treba progledati kroz prste.
ZDRAVLJE&SAVJET: Ublažite svoje kriterije.
OCJENA: LJ 5, K 4, Z 4
PROGNOZA VREMENA za sljedećih 7 dana
VREMENSKA SLIKA: Početak rujna je bio ljetni, zatim je stiglo jako i naglo pogoršanje, a potom opet ugodniji dani krajem mjeseca. Prvi listopadski tjedan počeo je ugodno, ali je neki dan stiglo novo pogoršanje uz jesensku kišu i zahlađenje. Sljedećih dana još će biti puno oblaka, ali ipak sve više suhog
vremena, tako da možemo najaviti polagani oporavak. Opširniju prognozu donosimo u nastavku.
VREMENSKA PROGNOZA: U petak malo povoljnije pa malo kišice može još biti uglavnom ujutro. Danju većinom suho uz puno oblaka, ali popodne se tu i tamo može pojaviti i koja minuta sunča-
nih razdoblja. Puhat će slab do umjeren sjeveroistočni vjetar. Noćna i jutarnja temperatura oko 10, a dnevna do 15 °C.
U subotu malo povoljnije, ali to još nije sasvim lijep dan. Bit će dosta oblaka, možda i kraćih sunčanih razdoblja. Još ponegdje može pasti malo kiše ili kraći pljusak, ali čini se da
bi oborine ipak bile u odlasku. Danju stupanj-dva ugodnije. Nedjelja izgleda kao povoljniji dan vikenda. Izmjena oblaka i kraćih sunčanih razdoblja te većinom suho. Ujutro stupanj-dva hladnije uz mjestimičnu maglu, a dnevna temperatura će malo narasti. Čini se da onda i početak sljedećeg tjedna donosi








Ako listopad velike vode vuče, u prosincu veliki vjetar huče
uglavnom suho vrijeme sa sunčanim razdobljima. Moglo bi zajužiti pa će i malo zatopliti u popodnevnim satima. Jutra će ipak biti prohladna uz moguću maglu pa pripazite u prometu, osobito u ponedjeljak. Najtopliji dan bi mogao biti utorak kad bi uz južinu i dosta sunca temperatura mogla narasti do 22 Celzijeva stupnja.
Izgleda da u srijedu možemo očekivati naoblačenje s mjestimičnom kišom i manjim osvježenjem, ali bi to trebalo


kratkotrajati pa bi već u četvrtak vrijeme ponovno trebalo biti ljepše. Podsjećamo da je dobro redovito pratiti prognozu na Twitteru i našoj Facebook stranici „Kad će Kiša“. (Prognozu napisao: Kristijan Božarov 3.10.2024.)
• 6. listopada 1936. godine najranije padanje snijega u Zagrebu
• 7. listopada 1956. godine kraj Vrsara u Istri zamijećeno 17 pijavica
• 9. listopada 1891. godine nakon nevremena povodanj pogodio Bol i Murvicu na Braču - dvoje poginulih







Na selu
Gospodin iz grada dolazi na seosko imanje i pita za gazdu. Na to će gazdarica:
- Muž upravo hrani svinje, ali možete ga prepoznati – on je onaj s jaknom.
GMO
Kupac: - Oprostite, jesu li ove jabuke genetski modi�icirane? Prodavač: - Ne, zašto pitate?
Jabuka: - Da, zašto pitate?
Benzinac i Dizelaš
- Prijatelju, popij rakiju sa mnom.
- Ma hvala, ne, ja sam ti pivski čovjek.
- Ajde, ajde, popij jednu, nemoj biti slabić!
- Ne pretjeruj, gdje si vidio da ide dizel u benzinca?



Je li bodo naši vnuki pak hodali vu vojsko?
Več se hadji dugo pripoveda o tomo kak naša deca i naši vnuki bodo morali znova iti vu vojsko jerbo naši sosedi so pak počeli ne sam gledati prek meje k nam v Lepo Našo nek i znova halosijo kaj bi mejo zrivali na ono negdašjo crto, štero so si sami narisali i štero od negda sejajo, Virovitica – Karlovac – Karlobag. Tak je bilo i negda, pred nekaj vejč od tridesti let i neso dugo zmagadili nek so se skompali z jugosoldateskom, z negdašjom "narodnom vojskom" seli so se v reoplane, samohotke, tenke i se drugo kaj jim je došlo pod roko i genuli so prema meji Lepe naše. Neje to tak zdavnja bilo pak se još dobro zmislimo kak so se nejpredi otpelali do Dežele, a unda so se vrnuli nazaj i ostali so štiri leti prinas v Lepoj našoj, ali so naši braniteli ne hitili puške v kuruzo nek so četnike i "narodno vojsko" sforšibali nazaj otkod so i došli. Kak sam rekel, minulo je tridesti let i pak se nekaj kuha pre našim sosedima, a čim je tam ne kak treba moramo se i mi prepravljati kaj se nej pak nekaj pripetilo kaj nečemo i kaj nam ne paše. Kaj peške kaj z traktorima. Poglečte sam, čim smo mi kupili šest reoplanov od Francozov mam se i naši sosedi spominajo kak i oni morajo nabajti nove reoplane, nove tenke, samohotke, zrakomlate kak da smo jiv z našimi Rafaleima v rit pehnoli. Mortik so jiv ne tuliko pehnoli naši novi reoplani nek naši spominki o tomo kak bodemo našo deco znova morali pošiljati vu vojsko i kaj bodo se tam prepravljali za „nedaj Božek“ posjeto na tenkima okinčenim z cvetjom. Bole da se prepravimo i nikaj ne bode nek da mirno spimo, a unda nas sirene zbudijo dok več sosedovi tenki i reoplani prejdejo prek naše meje.
Naši sosedi, ruon tak, kanijo kupiti nove reoplane, ali oni jiv nabavljajo od Rusije, a Rusi ve nemajo cajta delati za druge jerbo i oni jiv nucajo v Ukrajini. Štel bi reči sosedima četnikima šteri zunova halosijo prek meje na naš hatar nek si ne pozabijo nabaviti i jeno dvjesto novih traktorov. Kuliko se zmislimo traktori so jim bili od nejvekšega hasna pred nekaj vejč od tridesti let.
Si se "falijo" sam župan je stiha
Več hadji dugo se spominamo o novim vekšim plačama naših političarov. Nejglasneši o tomo so pajdaši za šankom jerbo dok si čovek vleje v sebe par kupici "kerozina" unda je nejspametneši i se nejbole zna. A i kuražen je. Za šankom so nejvečpot moški, a žene se o političkim, bračnim i vunbračnim problemima spominajo posle nedeljne meše, a črez tjeden na mlekari, čehari, na kavici ili pak po štacunima. Nejpredi smo natepli državne političare jerbo so jim i plače nejbole skočile, a unda smo se spustili niže v grade ili pak opčine. Kuliko vidimo sima so plače išle gori, očem reči, sima onima šteri praznijo sakefele račune (čitaj: proračune), a nikomo od onih šteri jiv punijo. No, neso ruon si bili na dnevnomo redo jerbo se o županima, kak našemo tak i drugima, nikaj preveč ne pripoveda? Ne verjem da so sima plače išle gori, a župani so ostali na starima? Zazvedili smo kak je ve čakoska gradonačelnica došla na to kaj saki mesec dobi kuvertlina z pet jezer ojeov tak da ne verjem da naš župan ima meje, a poznato nam je da je župan za štengo višeši od gradonačelnikov i načelnikov pak bi unda bilo nekak i red ak so sima išle plače gori da je unda i župan vu svojemo kuvertlino našel bar malo vekšega kupčeka penez nek je to do ve bilo. Najbrž je tak, ali smo mi to još ne zavedili.
I penziči štečijo…
Čim so se penziči pobunili mam je premijer, Drašek Plenkovičov, našel negdi rezervni kupček penez i obečal je penzičima da ne morajo zdigati halabuko jerbo kani zdiči i penzije. Nebrem reči, lepe peneze je AP obečal penzičima, a dok je to govoril čistam se ozbiljno držal tak verjem da kani i dati se ono kaj je obečal. Moremo reči da so cene sega odišle dosti gori pak da je državna kasa dosti več i kaserala prek pedevea tak da AP more i nekaj toga podeliti penzičima jerbo mo je čuda bole to nek se bode žnjimi svadil. Pak morajo i penziči od nečega živeti. Kaj ne bode AP posle rekel da sam ga ne spomenul: najme kaj, kuliko god bode AP zdigek penzije penziči bodo na precedničkim izborima svoje glase dali Zokijo Milanovičo. Znajo penziči kak to farizeji delajo!
Sveti Remoš se vrnul vu Štrigovo!
Dok je korona hercuvala po ovomo našemo sveto, a tak i po ovomo našemo "Falačko zemle med dvemi vodami" retko se je i jako stiha mogla čuti istina kak se je sveti Remoš (čitaj: Jeronim) rodil vu našoj Štrigovi, štera se je negda zvala Stridon. Kak da so naši Štrigovčanci, a i mi Međimorci fpešali i prestali se boriti za našega Remoša? Dok smo mi bili stiha Dalmoši so svetomo Jeronimo dali Splicko-dalmatinsko županijo, a i splickoga aerodroma tak da je zgledalo kak da smo mi Dalmošima priznali da je sveti Jeronim jiv. Pak nebremo si navijati ili pak zavijati za Hajduka makar sam on živi zanavek. Na tretji mesti. Ali ne, ovo leto na Remušovo, zadjega septembra, sveti Remuš se je vrnol nazaj vu svoje rodno mesto, vu svoj rodni Stridon, svojo Štrigovo. Nejpredi smo zafalili našim Dalmošima kaj so županijo i aerodroma nazvali po našemo Međimorco, a unda smo jiv zmislili kak je v četrtomo stoletjo, da se je sveti Jeronim narodil (347. leta), Dalmacija bila do Drave i Mure i zato je Jeronim bil Dalmatinec, a za ovo Remušovo godovno je profesor doktor i monsinjor Matija Berljak, međimorec z Cirkovljana, izdal knigico-vodiča za Štrigovo – mesto rođenja svetoga Jeronima, a naša Čakoska Matica, je skupa z naši međimorskim županom nakanila snimiti �ilma o svetomo Jeronima i to po scenario šteroga je napisala, naše čakosko zlatno naliv-pero, Kristina Štebih. To je još ne se, sosedi Janezi na čelo z murskosobočkim biškupom so priznali da je v Štrigovi (Stridono) rođen sveti Jeronim, a štrigoski župnik je jako lepo rekel kak je "sveti Remoš naše fare sin". Neje nikaj zaostal niti štrigoski opčinski načelnik, Rebernik, on je lepo rekel da je Štrigova dom vina i domovina svetog Jeronima. Bil bi on rekel svetoga Remoša, ali unda nej bila rima, a dok je proščeje v opčini i fari unda je čuda lepše dok je rima. Dok ve to znuomo kaj se je pripetilo vu Štrigovi vu ove Dneve svetoga Remoša unda moramo priznati da je za nas Međimorce, kaj se svetoga Remoša (čitaj: Jeronima) dotikavle korona ipak mela nekšega hasna.

Napomena: Stavovi izneseni u kolumnama i komentarima su osobni stavovi autora i ne odražavaju nužno stav redakcije Međimurskih novina.









Damijan Oršoš, bagerist iz Paraga, već šest godina radi u tvrtki Tegra. Susreli smo ga tijekom obilaska radova na izgradnji kanalizacije u Štrigovi. Iako rukuje teškom mehanizacijom, ne

skida osmijeh s lica i spreman je za suradnju. Sa zadovoljstvom je pozirao za našu rubriku Međimurec tjedna, ne skrivajući ponos zbog svoga rada. (sh)




